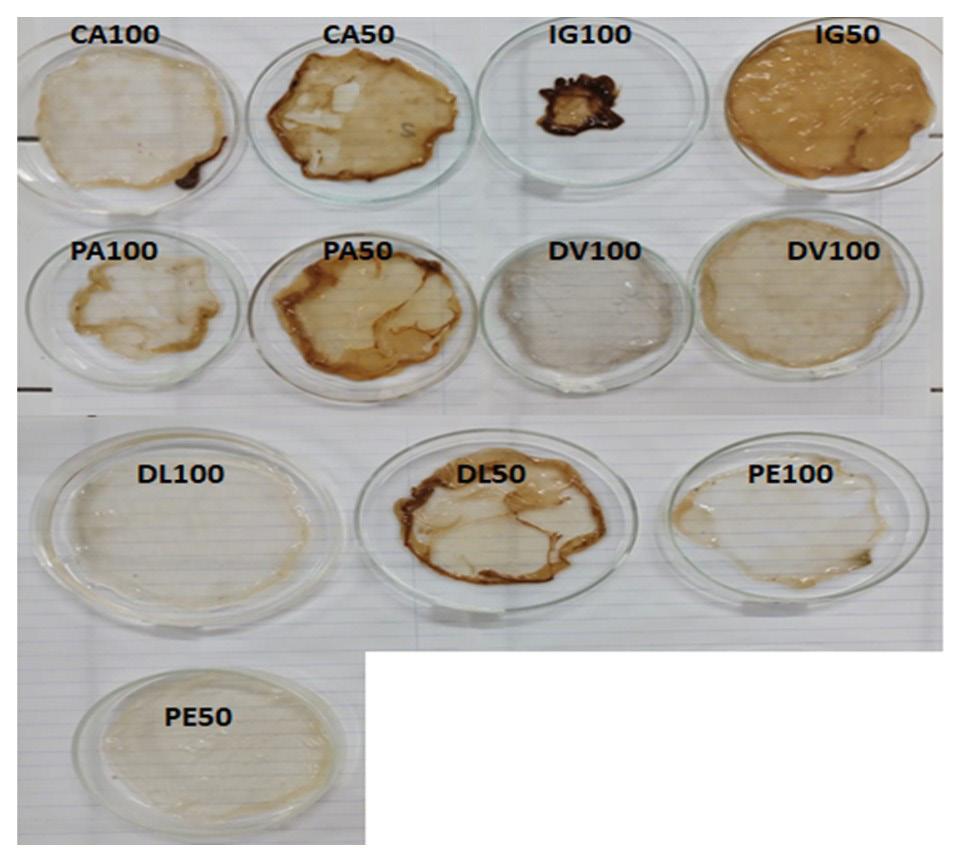
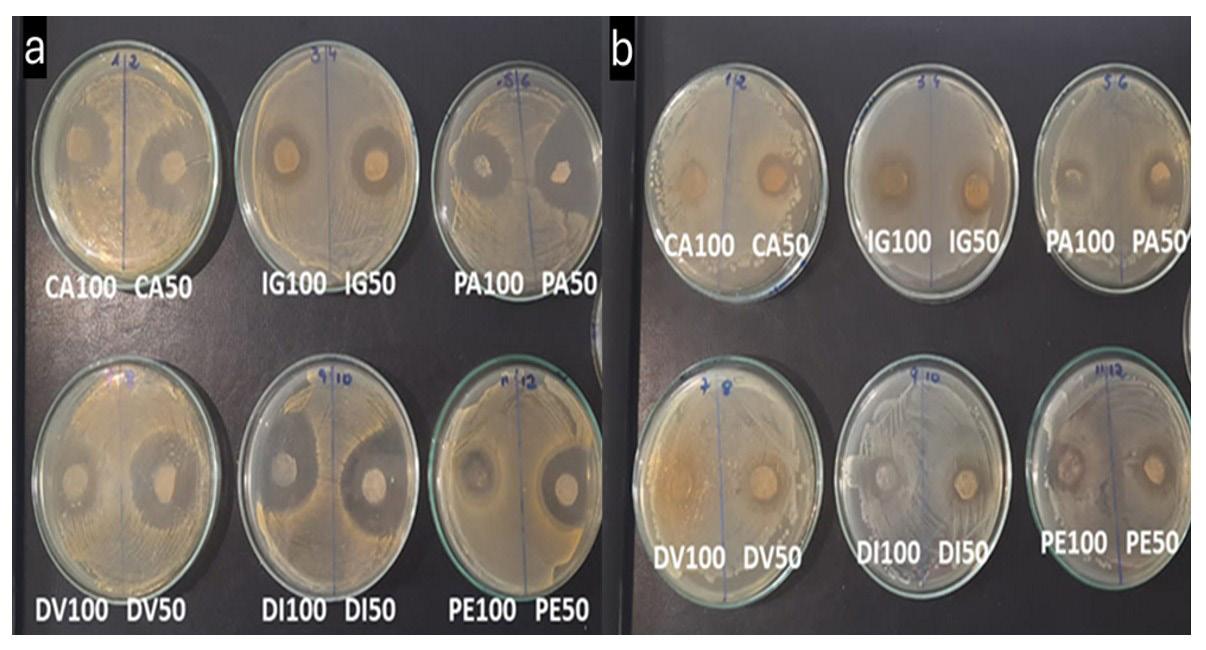

Volume XXXV - Issue IV - December.,2025



18th Brazilian Polymer Conference - 18th CBPol Campos do Jordão, SP, Brazil, October 19 to 23, 2025
e d I tor I al C ou NCI l

Volume XXXV - Issue IV - December.,2025



18th Brazilian Polymer Conference - 18th CBPol Campos do Jordão, SP, Brazil, October 19 to 23, 2025
e d I tor I al C ou NCI l
Edvani Curti Muniz (UFPI/DQUI; UEM/DQI)- President
m ember S
Alain Dufresne (Grenoble INP/Pagora)
Antonio Aprigio S. Curvelo (USP/IQSC)
Artur José Monteiro Valente (UC/DQ)
Bluma G. Soares (UFRJ/IMA)
César Liberato Petzhold (UFRGS/IQ)
Cristina T. Andrade (UFRJ/IQ)
Edson R. Simielli (Simielli - Soluções em Polímeros)
Elias Hage Jr. (Retired – UFSCar/DEMa)
José Alexandrino de Sousa (Retired – UFSCar/DEMa)
José António C. Gomes Covas (UMinho/IPC)
José Carlos C. S. Pinto (UFRJ/COPPE)
Júlio Harada (Harada Hajime Machado Consutoria Ltda)
Luiz Antonio Pessan (UFSCar/DEMa)
Luiz Henrique C. Mattoso (EMBRAPA)
Marco Aurelio De Paoli (UNICAMP/IQ)
Nikos Hadjikristidis (KAUST/ PSE)
Paula Moldenaers (KU Leuven/CIT)
Roberto Pantani, (UNISA/DIIn)
Rodrigo Lambert Oréfice (UFMG/DEMET)
Sebastião V. Canevarolo Jr. (Retired – UFSCar/DEMa)
Silvio Manrich (Retired – UFSCar/DEMa)
I N memor I am
Ailton S. Gomes (UFRJ/IMA)
Richard G. Weiss Washington (GU/DeptChemistry)
Cover: The opening ceremony of the 18th CBPol, October 19, 2025. From left to right: Profa. Mariana A. Moraes (Young Researcher Award 2023), Profa. Lidiane C. Costa (Director of Technical Committees), Prof. Otavio Biachi (Director of Events), Profa. Daniela Becker (Vice-President of ABPol), Prof. Guilhermino J. M. Fechine (Chair of the Conference), Prof. Leonardo B. Canto (President of ABPol), Prof. Denise F. S. Petri (Coordinator of the Scientific Committee), Prof. Ricardo J. E. Andrade (Vice-Chair of the Conference), Prof. Roselena Faez (Vice-Coordinator of the Scientific Committee), Prof. Cesar P. Liberato (Scientific Technical Director).
Below the ABPol Award Winners of 2026: Prof. Sebastião V. Canevarolo (DEMa/UFSCar), Prof. Roniérik P. Vieira (UNICAMP, SP), Thatiana C. P. Macedo, (SENAI-CIMATEC, BA).
Arts by Editora Cubo
Financial support:
e d I tor I al C omm I ttee
Sebastião V. Canevarolo Jr. – Editor-in-Chief a SS o CI ate e d I tor S Alain Dufresne
Artur José Monteiro Valente
Bluma G. Soares
César Liberato Petzhold
José António C. Gomes Covas
José Carlos C. S. Pinto
Marcelo Silveira Rabello
Paula Moldenaers
Richard G. Weiss (in memoriam)
Roberto Pantani
Rodrigo Lambert Oréfice
d e S kto P P ubl IS h IN g
www.editoracubo.com.br
“Polímeros” is a publication of the Associação Brasileira de Polímeros
São Paulo 994 St. São Carlos, SP, Brazil, 13560-340
Phone: +55 16 3374-3949
emails: abpol@abpol.org.br / revista@abpol.org.br http://www.abpol.org.br
Date of publication: December 2025

Available online at: www.scielo.br

Polímeros / Associação Brasileira de Polímeros. vol. 1, nº 1 (1991) -.-
São Carlos: ABPol, 1991-
Quarterly
v. 35, nº 4 (December 2025)
ISSN 0104-1428
ISSN 1678-5169 (electronic version)
1. Polímeros. l. Associação Brasileira de Polímeros.
Website of the “Polímeros”: www.revistapolimeros.org.br
18th Brazilian Polymer Conference - 18th CBPol
Institutions
o r I g IN al a rt
Advances and challenges in nanofiber production: techniques and applications in nanotechnology
Roberto da Silva Gusmão, Erandi Mendes Maciel, Walquíria Cubíssimo Frattini, Eliton Souto de Medeiros, Francisco Antonio Helfenstein Fonseca and Henrique Tria Bianco
Production and physicochemical characterization of TEMPO-oxidized bacterial cellulose nanofibers from industrial waste
Kely Silveira Bonfim, Daniella Lury Morgado, Renan da Silva Fernandes, Adhemar Watanuki Filho, Fauze Ahmad Aouada and Márcia Regina de Moura .........................................................................................................................................................
EVA hot-melt adhesive with thermoplastic starch blends compatibilized by modified maleic anhydride
e20250039
e20250037
Larissa Takigava Acrani and Antonio José Felix Carvalho e20250038
Green synthesis of N-doped carbon dots from cocoa fruit skin as antibacterial Marpongahtun, Amru Daulay, Putri, Aniza Salviana Prayugo, Roon Goei, Salmiati e20250040
Improving the properties of recycled Polyethylene terephthalate (PET) reinforced with different fibers
Tamam Mahdi Salih and Wafaa Mahdi Salih e20250041
Optimizing graphene-enhanced polycaprolactone nanofibers for superior biomedical properties
Sankar Thangavel, Kannan Thanneerpanthalpalayam Kandasamy, Rajasekar Rathanasamy and Ratchagaraja Dhairiyasamy e20250042
UV exposure analysis on mechanical resistance of rope yarns for offshore mooring
Daniel Magalhães da Cruz, Marcelo de Ávila Barreto, Larissa Basei Zangalli, Felipe Tempel Stumpf, Carlos Eduardo Marcos Guilherme, Ivan Napoleão Bastos and Ana Lúcia Nazareth da Silva e20250043
Modulating molecular weight and crosslinking in thiol-ene polymerization of renewable monomer limonene
Luiz Paulo Soares Pereira, Marina de Souza Melchiors, Thayne Yasmin Vieira, Tamara Agner, Bruno Augusto Mattar Carciofi, Pedro Henrique Hermes de Araújo, Débora de Oliveira and Claudia Sayer e20250044
Production and reuse of kombucha waste for cellulose production from different plants
Pâmela Barcelar Ferreira Gomes da Silva de Luna, Karina Carvalho de Souza, Rhodivam Lucas Mendes Feitosa, Daniella Stepheny Carvalho Andrade, Dayanna Kelly Marques de Oliveira, Fernanda Sobreira Silva, Alexciana Pereira de Melo and Glória Maria Vinhas e20250045
Analysis of wall-smoothed mesh refinement in polymer melt transient flow
Arthur Henrique Theiss and Diego Alves de Miranda e20250046
Properties of epoxy polymer materials reinforced with boric acid and nano silica
Cuong Huynh Le Huy, An Truong Thanh and Hao Nguyen Nhat e20250047
Characterization of PBAT bioplastic with Brazil nut urchin particles
Bruno Mello de Freitas, Carlos do Amaral Razzino and Paulo Noronha Lisboa Filho e20250048
Sebastião V. Canevarolo1*
1 Editor-in-Chief, Canevarolo Assessoria Industrial Ltda, São Carlos, SP, Brasil
* caneva@ufscar.br
Last October, 21, during the 18th Congresso Brasileiro de Polímeros, organized by ABPol and held in Campos do Jordão, SP, the members of the Polimeros Council Board met and various important proposals were approved, which the main ones are:
Prof. Edvani Curti Muniz, from Universidade Federal do Piauí, Teresina, PI, Brazil, (see his short CV below) was appointed the new President of the Council Board, effective from November, 22, 2025. He substitutes Prof. Antonio Aprígio da Silva Curvelo, from IQSC/USP, SP, who will remaining in the Council Board. We acknowledge the great work Prof. Aprígio has done to this journal during this past 8 years and salute Prof. Edvani to his new position.
Due to his recent retirement Prof. Marcelo Silveira Rabello, UFCG/PB, has asked to step down from the Editorial Board. Also, for private reasons, Prof. Osvaldo Novais de Oliveira Junior, IF/USP, Prof. Raquel Santos Mauler UFRGS, and Prof. Regina Célia Reis Nunes, UFRJ, asked to resign from the Editorial Committee.
Three new members were appointed to the Editorial Board: Prof. Nikos Hadjikristidis, from King Abdullah University of Science and Technology, Thuwal, JED, Kingdom of Saudi Arabia, Prof. Artur José Monteiro Valente, from Universidade de Coimbra, Coimbra, PBL, Portugal, and Prof. Roberto Pantani, from University of Salerno, Fisciano, SAL, Italy, with the latter two additionally serving on the Editorial Committee as Associated Editors.
The election of Prof. Sebastião V. Canevarolo as vice-representative of the Editors-in-Chief in the Exact and Earth Sciences and Engineering area of the SciELO Brazil Advisory Committee, for the period 2025-27.
To avoid fake reviewers a security measure was implemented by Polímeros, hiring the Web of Science (Clarivate) Reviewer Search tool to help Associated Editors the identification and selection of qualified and reputable reviewers.
Finally, the Article Publication Charge APC was adjusted to R$ 1.000,00 for authors based in Brazil and USD 300.00 for authors based abroad, applicable to articles accepted that were submitted from January, 1 2026.
We welcome all newly appointed members of the Polimeros Editorial Committee, wishing all the best in their new positions.

Professor Edvani Curti Muniz has been working in the field of Polymer Materials Chemistry since 1983. In 1986, he began his academic career in the Chemistry Department at the State University of Maringá (UEM), the same year he completed his master’s degree in Materials Engineering at UFRGS. In 1993, he completed his doctorate at UNICAMP in the area of Polymer Chemistry/Physical Chemistry. He completed a postdoctoral fellowship at the Université Libre de Bruxelles from 1998 to 2000. He has experience in the structure-property relationship of polymeric materials, chemometrics, multivariate data analysis, and physical chemistry. Professor Edvani’s scientometric data (as of January 2026) are: H-index = 62 (Web of Science); H-index = 63 (Scopus); H-index = 74 (Google Scholar). By December 2025, he had published 334 articles in specialized journals (Web of Science). He has approximately 14,000 citations in ISI, which equates to an average of about 42 citations per published article. He holds 3 patents granted by INPI and has 3 patent applications under review. Current affiliations: Federal University of Piauí, as a Full Professor (since 2019); Federal Technological University of Paraná (Londrina), as a Visiting Professor (volunteer), since 2016; State University of Maringá, as a Volunteer Professor, since retirement (2016). He was a member and coordinator of CA-MM, CNPq, from 2015 to 2018, and from 2022 to 2025. At CAPES, he served as deputy coordinator of the Materials area, from 2018-2022; currently, he holds the position of coordinator of the Materials area, valid until June 2026. He also held positions in the scientific associations SBQ (Director of the Materials Chemistry area) and ABPol (Director and Advisor, for several terms).
The Brazilian Polymer Conference (CBPol) is the main scientific forum in polymer science and technology in Brazil, being held every two years since 1991. CBPol has played a key role in advancing polymer science and technology in Brazil and in building collaborative networks among researchers and professionals in the field. Its 18th edition was organized by a group of professors from the Federal University of São Carlos, Mackenzie Presbyterian University, and University of São Paulo, in partnership with the Brazilian Polymer Association (ABPol). The conference was held at the Campos do Jordão Convention Center from October 19 to 23, 2025. Campos do Jordão, located in the Serra da Mantiqueira, is known as the “Brazilian Switzerland”. The town charms visitors with its mild climate and its European-inspired architecture and cuisine.
The 18th CBPol was sponsored by the Brazilian Funding Agencies CAPES, CNPq and FAPESP, Mackenzie Presbyterian University, CFQ/CRQ, Campos do Jordão Convention & Visitors Bureau, Ambiental Campos, Mantiqueira Viva, INCT Polysaccharides, INCT Circularity, Royal Society of Chemistry, Wiley, and the companies XGraphene, Waters-TA Instruments, Instron, DP Union, KCEN, Lauda, Zwick/Roell, PerkinElmer, Netzsch, Anton Paar, AX Plásticos Máquinas Técnicas Ltda, GrapheneUP, HSensor, ReoTerm, Shimadzu, AuTec, Altmann, Dinatest, Instrutécnica, ABIPET, IBA, INNOMA.
The opening session of the 18th CBPol took place on the evening of October 19, 2025 (Sunday). Those responsible for the session were Prof. Leonardo Bresciani Canto (President of ABPol), Prof. Daniela Becker (Vicepresident of ABPol), Prof. Guilhermino José Macêdo Fechine (Chair of the Conference), Prof. Ricardo Jorge Espanhol Andrade (Vice-chair), Prof. Denise Freitas Siqueira Petri (Coordinator of the Scientific Committee), Prof. Roselena Faez (Vice-coordinator of the Scientific Committee), Prof. Otavio Biachi (Events Director, ABPol), Prof. Lidiane C. Costa (Director of Technical Committees, ABPol), Prof. Cesar P. Liberato (Scientific Technical Director, ABPol), Prof. Mariana A. de Moraes (Young Researcher Award 2023) (Figure 1).
The president of ABPol, Prof. Leonardo Bresciani Canto, emphasized the importance of ABPol and CBPol for the continuous advancement of polymer science and technology in Brazil, and welcomed all participants and guests.
In his speech, the conference’s general coordinator, Prof. Guilhermino José Macêdo Fechine, highlighted the importance of circularity and innovation, which are currently vital for research in polymer science and technology. He also emphasized the significance of close collaboration between academia and the private sector, as it helps bring new technologies to society more quickly. This was also a

highlight of the conference, which several companies and academic members attended.
After the presentations, outstanding Brazilian researchers were awarded: Prof. Sebastião Vicente Canevarolo Júnior (UFSCar, SP) received the ABPol “Profa Eloisa Mano” award for Polymer Science, Prof. Roniérik Pioli Vieira (UNICAMP, SP) received the “ABPol Young Researcher” award and the ABPol “Polymer Technology” award was given to Thatiana Cristina Pereira de Macedo (SENAI-CIMATEC, BA) (Figure 2). Subsequently, Prof. Guilhermino José Macêdo Fechine (Chair of the Conference), Prof. Ricardo Jorge Espanhol Andrade (Vice-chair), Prof. Denise Freitas Siqueira Petri (Coordinator of the Scientific Committee), Prof. Roselena Faez (Vice-coordinator of the Scientific Committee) were awarded for their contribution to the 18th CBPol.
The ceremony ended with a memorable choir performance by student singers from the Mackenzie Presbyterian University Choir (Figure 3), followed by a welcome cocktail for all participants.
On Sunday afternoon, ABPol’s administrative assistants, Mr. Marcelo Perez Gomes and Ms. Layane Souza, began delivering the conference documents to the participants. At
the same time, there was the 1st. Meeting of the National Institute of Science and Technology in Circularity (INCT Circularidade), under the coordination of Prof. Caio Gomide Otoni, and the minicourse “High impact scientific writing and preparation for public competition”, held by Prof. Dr. Valtencir Zucolotto (USP, SP).
On the following days (Monday to Thursday), the activities for each period of the day (morning and afternoon) began with a plenary lecture, followed by keynotes and oral presentations in 5 parallel sessions, except on Thursday afternoon (only in the morning).
To strengthen existing areas and address topics that have been in high demand recently, 10 symposia were opened for paper submissions. The symposia and the corresponding coordinators were: (1) Polymer Blends and Composites, Profs. Sandro Campos Amico (UFRGS) & Daiane Romanzini (IFRS); (2) Polymer Nanocomposites and Nanostructures, Profs. Danilo Carastan & Suel Vidotti (UFABC); (3) Environmental Aspects of Polymers, Prof. Sandra Andrea Cruz (UFSCar); (4) Biomedical Applications of Polymers, Prof. Rodrigo Lambert Oréfice (UFMG); (5) Polymers for Functional Applications, Profs. Fauze Aouada & Márcia R. M. Aouada (UNESP); (6) Polymerization and


Chemistry of Polymers, Prof. Claudia Sayer (UFSC); (7) Characterization and Physics of Polymers, Prof. Baltus Cornelius Bonse; (8) Polymer Processing and Design, Prof. Lidiane Cristina Costa (UFSCar); (9) Rubber, Elastomers and Thermosets, Prof. Carlos Henrique Scuracchio & Rafael Barbosa (UFSCar); and Innovation and Management in Polymers and Education, Prof. Denise Petri (USP) & Roselena Faez (UFSCar). Figure 4 shows the number of submissions (abstracts and extended abstracts) accepted for presentation at each symposium. The most significant number of papers were submitted to the symposia Polymers for Functional Applications (206), Polymer Blends and Composites (195), and Polymer Nanocomposites and Nanostructures (186).
Out of a total of 1159 submissions, 1134 papers, with 2,940 authors, were accepted for presentation at the conference. All submissions have been previously peer reviewed. The review of the articles was coordinated by Profs. Denise Petri (USP) and Roselena Faez (UFSCar), with the collaboration of symposium coordinators and 118 ad hoc reviewers. The papers presented, including plenary and technical sessions, were divided as follows: 7 plenary
lectures (60 min each), 39 keynotes (30 min each), 125 oral presentations (20 min each), 19 technical presentations (20 min each), and 882 posters.
The plenary lectures, delivered by renowned Brazilian and international researchers (Table 1), covered emerging areas of polymer research worldwide.
About 1072 delegates participated, including 389 undergraduate, 199 graduate students, 70 post-docs (Figure 5) and 40 accompanying persons. This edition was one of the largest, particularly in terms of participation from undergraduate and graduate students.
The conference received paper submissions from Brazilian researchers (1034) and from researchers based in Austria (1), Belgium (1), Canada (4), Chile (8), China (1), Colombia (1), Cuba (1), Czech Republic (1), France (7), Germany (1), Luxemburg (1), Paraguay (5), Peru (3), Portugal (1), Spain (2), and United States (5).
The number of registered participants in Brazil by state (federal region) is shown in Figure 6, with congressmen from 19 states participating in the event. The largest number of researchers was from São Paulo (454), followed by Rio de

1.
presented at the 18th
Lecturer
October 20 Tatiana Budtova - CEMEF Mines Paris PSL, France
Title
All-cellulose composites: composites like no other 8:30 – 9:30
October 20 Hesheng Xia – Sichuan University, China
Carbon fiber reinforced dynamic crosslinked recyclable polymer composites 14:00 – 15:00
October 21 Iris Raquel Maia Tebeka – Univation Technologies, USA
Sustainability in the plastics industry: how to proactively drive change 8:30 – 9:30
October 21 André Ricardo Fajardo – Federal University of Pelotas, Brazil
14:00 – 15:00
October 22 Ludwig Cardon – Ghent University, Belgium
8:30 – 9:30
October 22 Roniérik Pioli Vieira – State University of Campinas, Brazil
Crosslinking strategies: Shaping hydrogels with customized properties for cutting-edge solutions
Comparing extrusion-based additive manufacturing and polymer processing techniques: a bottom-up approach for conductive composite applications
Terpene-derived polymers: unlocking multifunctionality from nature’s toolbox 14:00 – 15:00
October 23 Sebastião Vicente Canevarolo Jr. – Federal University of São Carlos
8:30 – 9:30
Understanding the extrusion process by in-line rheo-optical techniques, or, 51 years immersed in the polymer world
G. J. M. & Petri, D. F.S.

Janeiro (114), Rio Grande do Sul (92), Minas Gerais (85), and Santa Catarina (71). However, all Brazilian regions (N, NE, CO, SE and S) were present at the event.
This edition also introduced several new initiatives, including a Youth Committee composed of undergraduate and graduate students (Figure 7), a Kids’ Area for the children of congress participants (Figure 8), and a challenge of ideas (Figure 9). Recycling and educational activities were also implemented through a collaboration between Ambiental Campos, the company responsible for the municipal selective collection service, and Mantiqueira Viva, a recently established local cooperative. These partnerships enabled 15 students from a local school to attend the 18th CBPol on Monday morning.


The community was honored with presentations by Prof. Verônica M. A. Calado and Prof. Luiz A. Pessan, addressing “Engineering Area II – CAPES: Guidelines for 2025–2028” and “Policies for Supporting Graduate Education and Research”, respectively.
On Tuesday evening, immediately after the poster session, there was a meeting of the editorial board of the Journal “Polímeros: Ciência e Tecnologia”, with board
members in attendance, including Prof. Sebastião V. Canevarolo (Editor-in-Chief). In addition, a “happy hour” at the “Mercearia” bar was held, providing an additional opportunity for networking among participants.
On Wednesday evening, all participants could enjoy a joyful conference dinner with music and dancing, which helped warm and cheer everyone up (Figure 10).



The poster awards were presented during the closing ceremony in the late morning of October 23 (Thursday). All posters were carefully prepared, and the presenters showed great enthusiasm as they discussed their results with participants. As a result, selecting the best poster presentations was not a trivial task for the evaluation committee. Ultimately, three outstanding student posters were selected in each category (doctoral, master’s, and undergraduate), and 18 students received honorable mentions. The award-winning students are listed below.
Undergraduate Students:
1st PLACE – MORPHOLOGICAL AND SPECTROSCOPIC EVALUATION OF ELECTROSPUN FIBERS CONTAINING ALOE VERA AND COPAIBA
Presenter: Guilherme da Cunha Belem
Authors: Guilherme da Cunha Belem, Andrey Marcos Pinho da Silva, and Marcos Marques da Silva Paula
(Federal University of Amazonas – UFAM)
Area: Polymer Nanocomposites and Nanostructures
2nd PLACE – DEVELOPMENT AND CHARACTERIZATION OF SODIUM ALGINATE BEADS WITH CRAB SHELL (CALLINECTES SAPIDUS)
Presenter: Débora Giaretta
Authors: Débora Giaretta, Aline Fernandes de Oliveira, Cristian Berto da Silveira, Guilherme Dilarri, Antonella Valentina Lazzari Zortea, and Gabriel de Souza Laurentino
(State University of Santa Catarina – UDESC)
Area: Polymers for Functional Applications
3rd PLACE – DILATOMETRY OF POLYTETRAFLUOROETHYLENE ASSISTED BY DIGITAL IMAGE CORRELATION
Presenter: Taissa de Barros Fregate
Authors: Taissa de Barros Fregate, Rodrigo Bresciani Canto, and Vinicius Fiocco Sciuti
(Federal University of São Carlos – UFSCar)
Area: Polymer Characterization and Physics
Honorable Mentions:
- Débora Vitória de Freitas Leal dos Santos, Surface Roughness of Crosslinked and Non-Crosslinked UHMWPE: Relevance for Temporomandibular Joint (TMJ) Wear Testing, National Institute of Metrology, Quality, and Technology (INMETRO)
- Adrielly Botelho de Assis, Production of Pectin Films With Lignin Nanoparticles: Anti-UV Barrier and Concentration Effect, School of Engineering of Ilha Solteira (FEIS-UNESP)
- Gabriel D. Segredo, Mechanical, Rheological and Thermal Evaluation of Coating Films Additivated with Lignin and Conventional Stabilizers, Federal University of São Carlos (UFSCar)
- Bruno Pinto Moura, Development and Characterization of 3D-Printed Biocomposite Scaffolds Based on Poly(ε-caprolactone) with HA and TCP Fillers for Bone Regeneration, Federal University of São Carlos (UFSCar)
- Eduarda Conceição Ferreira, Synthesis and Characterization of Poly(3-dodecylthiophen) Nanocomposites/Carbon Nanotubes (P3DT/MWCNT), Federal University of Itajubá (UNIFEI)
- Eduardo A. V. de Souza, Development of Specialty Polymer Optical Fibers for Advanced Sensing Applications, University of Campinas (UNICAMP)
Master’s Students:
1st PLACE – FABRICATION AND CHARACTERIZATION OF BIODEGRADABLE NANOFIBROUS SUTURES USING ELECTROSPINNING AND TWISTING OF PCL/PLGA BLENDS
Presenter: Anderson Eugênio Corrêa
Authors: Anderson Eugênio Corrêa, Mayra Aparecida Nascimento, and Priscila Pereira Silva Caldeira (Federal Center for Technological Education of Minas Gerais – CEFET-MG)
Area: Biomedical Applications of Polymers
2nd PLACE – SYNTHESIS AND CHARACTERIZATION OF POLY-HISTIDINE ACRYLAMIDE AND POLY-LYSINE ACRYLAMIDE AS POTENTIAL ANTIBACTERIAL DENTAL MATERIALS
Presenter: Victor Rafael Ribeiro Santos
Authors: Victor Rafael Ribeiro Santos, Leandro Segat Perini, Gabriel Severgnini de Oliveira, and Cesar Liberato Petzhold
(Federal University of Rio Grande do Sul – UFRGS)
Area: Polymerization and Polymer Chemistry
3rd PLACE – SYNTHESISAND CHARACTERIZATION OF MOLECULARLY IMPRINTED POLYMERS APPLIED TO THE SELECTIVE REMOVAL OF THE DYE DIRECT YELLOW 50
Presenter: Júlia Paula Lima de Araújo
Authors: Júlia Paula Lima de Araújo, Claelson Oliveira Mancio Filho, Gloria Maria Leite Carlos, Karla Graziele Balbino de Melo, Rafael Barbosa Rios, Deiver Alessandro Teixeira, Maria Del Pilar Taboada Sotomayor, and Sabir Khan
(Federal Rural University of the Semi-Arid Region –UFERSA)
Area: Polymer Characterization and Physics
Honorable Mentions:
- Miguel Manuel Cassoma, PEO-b-PPO-b-PEO Copolymers and Lignin: Structure and Interfacial Properties, Institute of Chemistry – USP (IQ-USP)
- Luciana Braga da Costa, Effect of Internal Reactor Reflux on the Thermal Pyrolysis of Polypropylene, Federal University of Rio de Janeiro (UFRJ)
- Jeferson Mukuno, Predictive Modeling of Mechanical and Rheological Properties of Polybutadiene with Recovered Carbon Black Using Artificial Neural Networks, São Paulo State University (UNESP)
- Fabiano Renaldi, Thermal and Rheological Characterization of EVA/Clay/Niobium Pentoxide Compositions, Federal Technological University of Paraná (UTFPR)
- Andreia Maria S. F. Costa, Synthesis, Spectroscopic Characterization, and Conductometric Assessment of Poly(Ionic Liquid)–Biopolymer Interactions, Federal University of Pampa (UNIPAMPA)
- João Paulo Eckert, Electromechanical Performance Analysis of Nafion/Pt-Based IPMCs Coated with Polypyrrole, Federal University of São Carlos (UFSCar)
Doctoral Students:
1st PLACE – PRODUCTION OF BACTERIAL CELLULOSE MEMBRANE WITH UMBU POTATO AND EVALUATION OF ITS ANTIMICROBIAL PROPERTIES
Presenter: Dayanna Kelly Marques de Oliveira
Authors: Dayanna Kelly Marques de Oliveira, Alice da Conceição Alves de Lima, Yêda Medeiros Bastos de Almeida, and Glória Maria Vinhas
(Federal University of Pernambuco – UFPE)
Area: Polymers for Functional Applications
2nd PLACE – METHODOLOGY FOR ISOLATION AND CHARACTERIZATION OF MICROPLASTICS IN MATERNAL–FETAL SAMPLES
Presenter: Rafael de Lima Pinto
Authors: Rafael de Lima Pinto, Giovanna Marcele Vieira Machado, Marcos Antônio de Araújo Gouveia, Débora Baptista Pereira, Thiago Ramos Correia, Eduardo Faerstein, Carmen Ildes Rodrigues Fróes Asmus, Nataly Damasceno de Figueiredo, Armando Meyer, Volney de Magalhães Câmara, Ana Maria Furtado de Sousa, and Monica Regina da Costa Marques Calderari
(Federal University of Rio de Janeiro – UFRJ)
Area: Environmental Aspects of Polymers
3rd PLACE – OPTIMIZING KAOLIN-FILLED NATURAL
RUBBER COMPOUNDS USING TESPT SILANE COUPLING AGENT
Presenter: Michael Cezar Camargo
Authors: Michael Cezar Camargo, Abel Cardoso Gonzaga Neto, Samuel Marcio Toffoli, and Ticiane Sanches Valera (University of São Paulo – USP)
Area: Rubber, Elastomers, and Thermosets
Honorable Mentions:
- Julia L. D. Oliveira, Engineering Bioactive 3D Scaffolds: Combining Precision Architecture and Surface Functionalization for Tissue Regeneration, Federal University of Santa Catarina (UFSC)
- Amanda Caroline de Oliveira Diniz, Biodegradability of Bacterial Cellulose Films in Natural Soil from a Semiarid Climate, Federal University of Pernambuco (UFPE)
- Jéssica Caroline Ferreira Gimenez, Synergistic Effect of Titanium Dioxide and Few-Layer Graphene on the UV-C Photostabilization of Polypropylene, Federal University of São Carlos (UFSCar)
- Cléber Gomes de Jesus, Eugenol Effects on Catalysis and Detection in Urease and Conjugated Polymer Films, Federal University of São Paulo (UNIFESP)
- Samir L. Mathias, Tailoring Chitosan for Improved Performance – The Impact of Cyanoethoxyacrylate Grafting, Federal University of São Carlos (UFSCar)
- Thaís Gallina, Ethoxylated-Quaternized Hydroxyethyl Cellulose: Raw Material for Casting Films and for Synthesizing Bio-Based Polyurethanes with FilmForming Capabilities, Institute of Chemistry of São Carlos – USP (IQSC-USP)
The ideas challenge also awarded the winner, student Arthur Capriolli (UFRGS), for using reactive extrusion to disperse graphene in a thermoplastic polyurethane matrix.
The members of the CBPol Organizing Committee would like to express their deep appreciation to all the speakers and delegates for their contributions and participation, as well as the invaluable support of sponsors, Brazilian agencies (especially CNPq, CAPES, and FAPESP), and colleagues for making the event in Campos do Jordão successful and enjoyable.
We can’t wait to see you at the 19th CBPol!
Guilhermino José Macêdo Fechine (Chair) Mackenzie Presbyterian University Denise Freitas Siqueira Petri (Scientific Coordinator) University of São Paulo
INEOS Olefins & Polymers Europe has revealed its new Recycl-IN hybrid polymer grade containing 70% recycled material, said to boost the sustainability of contact-sensitive cosmetics packaging without compromising on quality or performance.
The company states that Recycl-IN hybrid polymers deliver the strength, aesthetics, and processing ease customers expect while ‘significantly increasing’ recycled content and reducing CO2 emissions. INEOS says this is achieved by combining high levels of mechanically recycled plastic with advanced ‘booster’ polymers.
The new product is a natural color polypropylene homopolymer designed for thin-walled injection molding and fiber extrusion. According to INEOS, this makes it ideal for manufacturing stiff, colored or translucent components such as screw caps, jars, and lids; mascara reservoirs and caps; deodorant roller balls and spray-over caps and dispenser parts.
INEOS states that the key features of the new grade, rPP1025C, are stiffness for shape retention, premium feel, and reliable functionality and heat resistance for product stability and shelf life. It is also designed as a drop-in solution for demanding applications as the ease of processing, mechanical strength, and optical properties apparently remain comparable to the qualities of virgin polypropylene while delivering a 35% lower carbon footprint.
INEOS adds that the new grade also has natural color to cut costs, simplify recycling and provide a neutral base for branding without added pigments; scratch resistance to preserve ‘premium appearance and brand integrity’; and ‘virgin-quality colorability’ which enables a full spectrum of shades from light to dark.
The recycled materials are said to be covered by an FDA No Objection Letter (NOL) and certified as PostConsumer Recyclate (PCR) by RecyClass, in line with ISO 14021 environmental labelling standards.
In other news, Borealis and Borouge recently revealed a global portfolio of mechanically recycled, post-industrial and consumer recyclates and compounds, expected to help customers lower their carbon footprints. The Recleo portfolio is expected to keep valuable raw materials in the loop, meet customer demand for recycled content and help users reduce their virgin feedstock consumption.
Last year Berry launched a ‘high-quality’ post-consumer recycled plastic polymer for non-contact-sensitive homecare and industrial packaging, said to eliminate around 36,000 tons of CO2 emissions every year. CleanStream is said to be compatible with existing waste management infrastructures, and its closed-loop system is expected to provide consistency and reliability for customers’ supply chains.
Source: Packaging Europe – packagingeurope.com
The remarkable silk used by net-casting spiders to snare prey is both highly elastic and exceptionally strong, offering clues for designing synthetic materials.
Spiders are nature’s artists, spinning intricate webs to capture prey or even convey messages, as depicted in the children’s book Charlotte’s Web. These threads combine exceptional strength and elasticity.
In polymer materials, these properties are often difficult to achieve simultaneously, as increased elasticity can come at the expense of strength. This challenge motivated researchers from the University of Greifswald, Germany, to investigate the properties of spider silk from netcasting spiders, seeking new insights that could inform the design of synthetic materials—taking a page, or rather a thread, from these arachnids to improve both strength and elasticity.
In a recent study, published in the Proceedings of the National Academy of Sciences, the team found that the architecture of the netcaster’s thread is like a bungee cable core surrounded by looped bundles of fine fibers that can stiffen and enhance load-bearing capacity when capturing prey (https://doi.org/10.1073/ pnas.2529200123). Thus, researchers may draw inspiration from the spider’s unique thread-production process to design improved synthetic materials.
The netcasting spiders, as their name aptly suggests, propel a web towards their prey. As it flies through the air, the web undergoes significant, yet reversible, deformation. This thread can sustain elongations over 150 percent; a staggering amount compared to orbweaver spiders whose silk can fracture at elongations over 20 percent.
The researchers used high-speed videography to assess the tensile properties of the web at different sections. As various parts of the web expand and contract, distinct regions experience differing levels of strain. They found that spiders create a gradient of stiffness along the thread through a reel-spinning technique.
Closer examination using polarized light microscopy and field-emission scanning electron microscopy revealed that each thread consists of an elastomeric core fiber surrounded by loops of silk fibers. These looped fibers varied in density, imparting strong, stiff properties in load-bearing regions and softer, hyperelastic behavior in other areas.
Although further research is needed to fully elucidate the mix of silk threads that contribute to web performance, these insights into looped fiber-reinforced cores may inspire the design of synthetic materials that require both high strength and elasticity.
Source: The Scientist – the-scientist.com
DMarch
2nd Global Polymers and Materials Congress
Date: March 23-24, 2026
Location: Rome, Italy
Website: globalpolymersmaterialscongress.com
April
2nd International Conference on Advance Chemical and Material Science (ACMS-2026)
Date: April 12-14, 2026
Location: Kolkata, India (hybrid)
Website: ceie.org.in/acms2026
Inscitech Meet on Polymer Science and Composite Materials (IMPOLYMER2026)
Date: April 20-22, 2026
Location: Rome, Italy
Website: inscitechsummits.com/2026/polymer-science
May
Fire & Polymers 2026
Date: May 17-20, 2026
Location: San Diego, California, United States of America
Website: polyacs.org/2026fireandpolymers
Polymer Sourcing and Distribution
Date: May 19-21, 2026
Location: Hamburg, Germany
Website:ami-events.com/event/aa711e6d-2de5-4e11-82ba97fdd7d4e05b
World’s Leading Conference on Polymer Science & Composite Materials (Polymer Summit 2026)
Date: May 29-30, 2026
Location: Berlin, Germany
Website: polyscienceconference.com
41st International Conference of the Polymer Processing Society (PPS-41)
Date: May 31-June 4, 2026
Location: Salerno, Italy
Website: pps-41.org
June
Bordeaux Polymer Conference (BPC 2026)
Date: June 1-4, 2026
Location: Bordeaux, France
Website: bpc2026.u-bordeaux.fr/en
Eighth International Symposium Frontiers in Polymer Science
Date: June 11-14, 2026
ALocation: Chengdu, China
Website: elsevier.com/events/conferences/all/frontiers-in-polymerscience
87th Prague Meeting on Macromolecules Smart Materials: Self-Organizing Polymers at the Interface of Technology and Nature (PMM 87 Smart Materials)
Date: June 21-25, 2026
Location: Prague, Czech Republic
Website: imc.cas.cz/sympo/87pmm
6th Global Conference on Polymers, Plastics & Composites (PPC-2026)
Date: June 24-25, 2026
Location: Barcelona, Spain (hybrid)
Website: polymers-plastics.org
Polymers 2026: Trends, Innovation and Future
Date: June 25-28, 2026
Location: Nanjing, China
Website: sciforum.net/event/polymers2026
Polymer Engineering and Sciences International (PESI 2026)
Date: June 28-July 2, 2026
Location: Kanazawa, Japan
Website: polymers-int.org
July
Polymers and Footwear Innovations
Date: July 22-23, 2026
Location: Portland, Oregon, United States of America
Website: ami-events.com/event/749a47b2-12dd-4e1d-a1090febf35491e5
9th International Congress on Advanced Materials Sciences and Engineering 2026 (AMSE-2026)
Date: July 22-24, 2026
Location: Zagreb, Croatia Website: istci.org/amse2026/index.asp
4th International Summit on Biopolymers and Polymer Science (ISBPS2026)
Date: July 23-25, 2026
Location: Prague, Czech Republic Website: polymerscience2026.spectrumconferences.com
15th World Congress on Biopolymers and Biomaterials
Date: July 27-28, 2026
Location: Paris, France Website: biopolymerscongress.conferenceseries.com
51st IUPAC World Polymer Congress (MACRO 2026)
Date: July 28-31, 2026
Location: Sarawak, Malaysia Website: macro2026.org
August
12th International Conference on Chemical and Polymer Engineering (ICCPE 2026)
Date: August 18-20, 2026
Location: London, United Kingdom Website: cpeconference.com
3rd Edition Global Summit on Polymer Science & Composite Materials
Date: August 24-25, 2026
Location: Paris, France Website: globalpolysciencesummit.com
Global Summit on Sustainable Biopolymers and Polymer Applications (POLYMERS2026)
Date: August 26-27, 2026
Location: Venice, Italy Website: biopolymers.researchconnects.org
September
Bioplastics
Date: September 1-2, 2026
Location: Cleveland, Ohio, United States of America
Website: ami-events.com/event/a57ba0e7-de68-4cf6-b4c58c0955be8ef5
Annual Global Summit on Polymers and Composite Materials (AGSPOLYMERS2026)
Date: September 21-23, 2026
Location: Prague, Czech Republic
Website: vividglobalsummits.com/2026/composite-materials
International Conference on Next Horizons in Polymers: Beyond the past 50, toward the next 100 (IUPAC-PSK50)
Date: September 28-October 1, 2026
Location: Busan, South Korea
Website: polymer.or.kr/conferenceintl/default
October
5th International Conference on Polymer Science and Engineering
Date: October 7-9, 2026
Location: San Francisco, California, United States of America
Website: polymers.unitedscientificgroup.org
6th International Conference on Polymer Science & Composite Materials (ISTDPCM 2026)
Date: October 7-9, 2026
Location: Dubai, United Arab Emirates
Website: inovscitechconferences.com/2026/dubai/polymerscience
XIX Latin American Symposium on Polymers and XVII Ibero-American Congress on Polymers - SLAP 2026
Date: October 19-23, 2026
Location: Salvador, Bahia, Brazil
Website: slap2026.com.br
November
International Connect & Expo on Biopolymers and Polymer Science (POLYMERCONNECT2026)
Date: November 26-28, 2026
Location: Paris, France
Website: polymerscience.theinfiniteminds.net

Roberto da Silva Gusmão1* , Erandi Mendes Maciel1 , Walquíria Cubíssimo Frattini1 , Eliton Souto de Medeiros2 , Francisco Antonio Helfenstein Fonseca1 and Henrique Tria Bianco1
1Laboratório de Aterosclerose, Biologia Vascular – LABIV, Programa de Pós-graduação em Cardiologia, Universidade Federal de São Paulo – UNIFESP, São Paulo, SP, Brasil
2Laboratório de Engenharia de Materiais, Departamento de Engenharia de Materiais, Universidade Federal da Paraíba – UFPB, João Pessoa, PB, Brasil
*gusmao.roberto@unifesp.br
Rbstract
This article presents a concise review of nanofiber production techniques, materials obtained by innovative technologies to produce nanofibers. The use of nanofibers has evolved significantly due to their unique properties, allowing maximization at the nanometric scale. The large-scale production capacity, simplicity in manufacturing and versatility have increased interest in several areas, especially in pharmaceuticals, for controlled drug release. Different nanofiber manufacturing techniques were explored and how each one can improve medical-pharmaceutical devices, biomaterials, nanotechnology, textile industries, air and water filters, human tissue engineering, among others. It was observed that interest in nanofibers has grown worldwide in research. Despite the advances, challenges remain to optimize production and expand knowledge in the pharmaceutical sector. Future research should focus on more economical and sustainable manufacturing processes, in addition to exploring biodegradable and biocompatible polymers to solve problems in pharmaceutical formulations.
Keywords: nanofibers, electrospinning, centrifugal spinning, melt blowing spinning, pharmaceutical applications.
Data Rvailability: All data supporting the findings of this study are included in this article and its supplementary materials.
How to cite: Gusmão, R. S., Maciel, E. M., Frattini, W. C., Medeiros, E. S., Fonseca, F. A. H., & Bianco, H. T. (2025). Advances and challenges in nanofiber production: techniques and applications in nanotechnology. Polímeros: Ciência e Tecnologia, 35(4), e20250039 https://doi.org/10.1590/0104-1428.20250039
1. Introduction
Nanotechnology is a field of science that focuses on the study of materials with dimensions ranging from 0.1 to 100 nanometers. Over the decades, this area has had a notable impact on improving the properties of biodegradable and non-biodegradable polymeric materials. Nanofibers, structures obtained from innovative one-dimensional, two-dimensional and three-dimensional nanomaterials, have attracted considerable attention from researchers around the world due to their large contact surface[1-5]
In the present work, it was possible to compile different nanofiber manufacturing techniques, such as melt blowing technology, electrospinning technology, supersonic CO2 laser stretching technology, solution blow spinning technology and, last but not least, roto-spinning/centrifuge spinning technology. We highlight the properties resulting from these techniques, including the high surface area/volume ratio[6-10]
Furthermore, it was possible to present an analysis of the most widely used pharmaceutical applications for nanofibers, which include the efficient delivery of different drugs and their controlled release, the diagnosis of different diseases,
such as different cancers, and the treatment of open wounds of different etiologies for the release of anti-inflammatories and antibiotics.
In the manufacture of nanofibers, several factors are carefully considered to optimize their properties. Furthermore, production parameters represent a crucial aspect, which vary significantly between different techniques. To this end, the techniques covered in this review include:
Nanofiber production by melt blowing emerged as an evolution of polymer processing techniques, aiming to obtain ultrafine fibers with improved properties. Although the melt blowing technique has its roots in older industrial processes, the specific application for nanofiber production
Gusmão, R. S., Maciel, E. M., Frattini, W. C., Medeiros, E. S., Fonseca, F. A. H., & Bianco, H. T.
has gained prominence in recent decades, driven by advances in nanotechnology[11-17]
The development of the technique has enabled the production of nanofibers from a variety of thermoplastic polymers, with precise control over the fiber diameter and the morphology of the fibrous mat. This has opened doors to diverse applications in areas such as filtration of different fluids, medicine, textile industry and composites, where the unique properties of nanofibers have proven advantageous[18 19]
Melt blowing technology consists of the production of fibers in a single step, through the extrusion of a given polymer, which may be biodegradable or not, which is melted through one or more holes in a given injection die, previously heated to the melting temperature of the chosen material, which is followed by stretching the material to be extruded with hot air[20,21]
The air exerts a drag force on the molten material, reducing the molten extrudate to micrometric and nanometric fibers, which are subsequently collected in the form of a non-woven mat in a cylindrical collector that winds the nanofiber produced. Melt blowing technology allows the use of thermoplastic polymers, representing an economically viable spinning process option (Figure 1).
Melt blowing technology, used in the production of nanofibers, has significant advantages over other techniques, boosting its application in various sectors[22-24] .
The production of nanofibers using melt blowing technology is often used in the manufacture of high-performance filters because it has a filtration efficiency of approximately 99%, resulting in greater purity of the fluid to be filtered in the nanofiber structure, elimination of pollution from water bodies and air treatment systems, reduction of corrosion, superior mechanical resistance to other available techniques, greater miscibility after treatment and modification of fluids subject
to filtration, as is the case of separation of compounds and sterilization of medicines by filtration at 0.22 µm.
One of the main advantages is the high production rate, which allows the manufacture of nanofibers on an industrial scale, meeting the demand for large volumes of material. This continuous and efficient process reduces production costs and increases the commercial viability of nanofibers.
Material versatility is another strength of melt blown technology. It enables the production of nanofibers from a wide range of thermoplastic polymers, including high-performance and biodegradable polymers. This flexibility makes it possible to create nanofibers with tailored properties for a variety of applications[11-21]
Control over fiber morphology is also an important advantage. Melt blowing technology allows parameters such as temperature, pressure, and air speed to be adjusted to control the diameter, orientation, and structure of nanofibers. This controllability enables the production of nanofibers with optimized mechanical, thermal, and electrical properties.
Furthermore, melt blowing technology is a relatively simple and low-cost process compared to other nanofiber production techniques. The absence of solvents and the lower complexity of the equipment contribute to the reduction of production costs and the sustainability of the process.
Finally, melt blowing technology enables the production of nanofibers with high porosity and specific surface area, which is advantageous for applications such as filtration, adsorption, and controlled drug release. The porous structure of nanofibers increases the efficiency of these processes and enables the creation of materials with unique properties.
The melt blowing technique, despite its ability to produce nanofibers on an industrial scale, has some disadvantages that limit its applicability in certain situations[25,26]

Advances and challenges in nanofiber production: techniques and applications in nanotechnology
One of the main disadvantages is the difficulty in controlling the morphology of nanofibers. Obtaining nanofibers with uniform diameter and precise alignment can be challenging, especially in large-scale melt blowing processes. Non-uniform diameter distribution and random fiber alignment can affect the mechanical, electrical, and other properties of nanofibers, limiting their applications in some areas that require specific properties.
Another disadvantage is the limited choice of materials. The melt blowing technique is best suited for thermoplastic polymers with high melt viscosity. Polymers with low viscosity or high thermal sensitivity may be difficult to process by melt blowing, limiting the range of materials that can be used.
High processing temperature is also a common disadvantage of the melt blowing technique. The need to heat the polymer to the melting temperature can lead to thermal degradation of some materials, affecting the properties of the nanofibers. In addition, high processing temperature can increase energy consumption and production costs.
The formation of defects in nanofibers is another disadvantage of the melt blowing technique. The presence of defects such as beads, knots and breaks in the fibers can affect the mechanical and other properties of the nanofibers. The formation of defects can be influenced by several factors such as polymer viscosity, processing temperature and blowing air velocity.
Finally, safety is a major concern in melt blowing due to the high processing temperature and high velocity of the blowing air. The need for appropriate protective equipment and stringent safety measures can increase the costs and complexity of the process.
The electrospinning technique is based on some parameters, without which it is impossible to produce quality nanofibers. Among the determining parameters for the electrospinning process, it is possible to mention the use of a polymer solution that must respect some physical-chemical parameters such as polymer concentration, conductivity, viscosity of the solution, molecular weight of the polymers used, volatility of the solvents used in the formulation and molecular structure of the components. Other parameters of relevant importance include the application of high voltages ranging from 10 kV to 50 kV, distance between the collector and the polymer injection needle, constant flow of the polymer solution that is carried out by means of an infusion pump and an appropriate collector. The electrospinning system has collectors that can be fixed or rotary, equipped with distance adjustment to eliminate possible imperfections in the structure of the nanofibers and/or formation of beads. Figure 2, below, shows details of the electrospinning process, taking into account solution variables, environmental variables and electrospinability variables[27 28]
Before being electrospun, the polymer solution must have an adequate pH to favor the electrical potential differential between the injection needle and the collector. The distance between the injection needle and the collector is crucial and facilitates fine adjustment of the final conditions of the nanofiber obtained. In cases where the drug incorporated into the polymer solution is thermolabile, it must have temperature and humidity control and be equipped with an exhaust fan to eliminate organic solvent vapors, which may be harmful to health[29 30]

R. S., Maciel, E. M., Frattini, W. C., Medeiros, E. S., Fonseca, F. A. H., & Bianco, H. T.
Electrospinning stands out as a versatile and efficient technique for the production of nanofibers, offering significant advantages in various fields. The main advantage lies in the ability to produce fibers with diameters on the nanometric scale, which imparts unique properties to the resulting materials[31,32] .
Another major advantage of electrospinning is the precise control over the morphology of nanofibers. By adjusting parameters such as applied voltage, solution flow rate, and the distance between the emitter and the collector, it is possible to control the diameter, alignment, and porosity of the fibers. This precision allows for the production of tailored materials for specific applications, ranging from biomedical devices to high-efficiency filters[33] .
The versatility of electrospinning also manifests in the wide range of materials that can be processed. Synthetic polymers, natural polymers, and mixtures of both, ceramics, metals, and even composites can be electrospun, opening doors to the creation of materials with combined properties and innovative functionalities[34] .
Additionally, electrospinning stands out for the simplicity of the equipment and ease of operation. The process can be carried out under controlled or uncontrolled environmental conditions, without the need for vacuum or high temperatures, which reduces costs and simplifies production. This characteristic makes electrospinning an accessible technique for research laboratories and industrial-scale production[35,36]
The ability to produce nanofibers with high surface area is another important advantage of electrospinning. This characteristic is particularly useful in applications such as catalysis, sensors, and energy storage devices, where the high surface area increases the efficiency of processes.
Finally, electrospinning allows for the production of complex structures, such as hollow nanofibers, multilayer fibers, and even three-dimensional fabrics. This ability to create customized structures opens up new possibilities for the development of advanced materials with innovative functionalities.
Despite its versatility and ability to produce nanofibers with unique properties, the electrospinning technique has some disadvantages that limit its applicability in certain situations[37]
One of the main disadvantages lies in the low production rate, which makes it difficult to scale the process for large-scale industrial applications. Electrospinning is a relatively slow process, which can increase production costs and limit its feasibility for mass manufacturing of nanofibers[38]
Another negative point is the complexity of controlling the process parameters. The morphology of nanofibers, such as diameter, alignment, and porosity, is highly sensitive to variations in electrospinning parameters, such as applied voltage, solution flow rate, distance between the emitter and the collector, and properties of the polymer solution. Small variations in these parameters can lead to significant changes in the morphology of nanofibers, requiring precise and constant control of the process[39]
The non-uniform distribution of nanofiber diameter is also a common disadvantage of electrospinning. Achieving nanofibers with uniform diameter throughout the fibrous mat
can be challenging, especially in large-scale electrospinning processes. The non-uniformity of diameter can affect the mechanical, electrical, and other properties of the nanofibers, limiting their applications in some areas[39]
Additionally, electrospinning can be limited by the viscosity and electrical conductivity of the polymer solution. Some polymer solutions may not be suitable for electrospinning due to their high viscosity or low electrical conductivity, which can hinder the formation of uniform nanofibers[39]
Finally, safety is an important concern in electrospinning due to the high electrical voltage involved in the process. The need for appropriate protective equipment and strict safety measures can increase the costs and complexity of the process[39]
The CO2 laser supersonic stretching technique stands out as a promising alternative for the production of nanofibers, especially in applications that require the absence of chemical solvents. In this process, a CO2 laser is used to fuse precursor fibers, generally with diameters in the range of 100 to 200 μm. The laser provides controlled thermal energy, allowing precise fusion of the material without compromising its properties[40]
After melting, the fibers are subjected to a supersonic air flow. This flow, generated by a high-speed nozzle, exerts a drag force on the molten material, inducing stretching and consequently the formation of nanofibers. The supersonic air speed ensures fast and efficient stretching, resulting in fibers with nanometric diameters and high uniformity[8]
One of the main advantages of this technique is its continuous process nature. Melting and stretching occur in sequence, allowing the production of long-chain nanofibers with high productivity. In addition, the absence of chemical solvents eliminates the need for drying and purification steps, reducing the time and cost of the process[41] .
The supersonic CO2 laser stretching technique is widely applied in the processing of thermoplastic polymers such as polyglycolic acid (PGA), polyethylene terephthalate (PET) and polylactic acid (PLLA). These polymers are biocompatible and biodegradable, making the nanofibers produced by this technique suitable for various pharmaceutical applications, tissue engineering, controlled drug delivery and medical devices[42,43]
The synthesis of nylon-66 nanofibers by this technique tends to result in a high melting point, close to the equilibrium melting point. Additionally, the technique enables the production of polymeric nanofibers with extended chains, which contributes to the improvement of mechanical properties[41]
The CO2 laser stands out for its high power and comparative efficiency, making it an immediate choice for sectors that require material processing. In addition to offering a low cost per watt of energy consumption and adequate beam quality, the CO2 laser has an output power ranging from a few watts to 15 kW. Its effectiveness surpasses that of He-Ne and argon lasers[8,44,45]
Advances and challenges in nanofiber production: techniques and applications in nanotechnology
Although less widespread compared to other nanofiber production techniques, it presents some promising advantages when compared to other nanofiber fabrication methods. Among the advantages, it is possible to mention precise control of fiber morphology, material versatility, production of aligned nanofibers, non-contact process, potential for high-scale production, improved material strength, and use in the manufacture of electronic devices[45]
The use of the CO2 laser allows for precise control of heating and stretching of the material, enabling the production of nanofibers with controlled diameter and alignment. Additionally, the high speed of the supersonic jet contributes to the efficient stretching of the fibers, resulting in ultrafine and uniform nanofibers[31,46]
The technique can be applied to a variety of materials, including thermoplastic polymers, ceramics, and composites. It also allows for the processing of materials with high melting temperatures, expanding the range of materials that can be used[47,48]
The supersonic jet and precise laser control enable the production of nanofibers with a high degree of alignment, which is advantageous for applications requiring anisotropic properties[49]
The use of the laser eliminates the need for physical contact with the material, reducing the risk of contamination and damage to the fibers[49-51]
The technique has the potential to be scaled up for mass production of nanofibers, which is important for industrial applications. Due to precise control and the ability to process various materials, the technique is promising for specific applications in areas such as the medical-pharmaceutical field for the production of scaffolds for tissue engineering and controlled drug release, electronics for the production of conductive nanofibers for flexible electronic devices, and composites for reinforcing materials with aligned nanofibers[50]
It is important to note that the technique is still under development and requires further research to optimize the process parameters and fully explore its potential[50]
2.3.2 Disadvantages
The CO2 laser supersonic stretching technique, although promising in certain applications, has some disadvantages that limit its applicability. Among the disadvantages, the divergence of the CO2 laser is inferior to that of He-Ne and argon lasers. The divergence ranges from 1 to 10 milliradians. The beam width varies from 3mm to 100mm. The optical cavity has considerable thickness and reduced length[52]
The technique requires sophisticated and expensive equipment, including high-power CO2 lasers and precise control systems for the supersonic flow. The process demands extremely precise control of various parameters, such as laser power, gas flow speed, and stretching rate, which increases the complexity and cost of the operation[52] .
The technique is more effective for materials that absorb CO2 laser radiation well. Materials with low absorption may require higher power lasers or pre-treatments, increasing the cost and complexity[52]
Heat-sensitive materials can be damaged by the laser, limiting the application of the technique. Additionally, the large-scale application of the technique remains a challenge due to the complexity of the process and the cost of the equipment[53]
Ensuring the uniformity of material properties over large areas can be challenging due to variations in laser power and gas flow. Additionally, high-power laser radiation poses a significant safety risk to operators, requiring stringent protective measures[54]
The supersonic gas flow can also pose risks, such as excessive noise and particle generation. Additionally, the high cost of regular preventive maintenance can be a disadvantage, and in some cases, the combination of these factors discourages the adoption of the technique[55]
The technique produces an irregular surface finish on some materials, requiring additional processing steps that are more time-consuming[56]
In summary, the CO2 laser supersonic stretching technique is a powerful tool for material processing, but its disadvantages in terms of complexity, cost, material limitations, scaling challenges, and safety must be carefully considered[56]
The solution blow spinning technique was developed to overcome the limitations of the conventional electrospinning technique, which include the need for high electric potential and the in situ synthesis of nanofibers. In solution blow spinning, these restrictions are minimized[57-60]
Being innovative, this technique is used for the production of microfibers and nanofibers in different size variations. Although the setup for this process is costly, it offers significant advantages and allows for the production of nanofibers with unique and stable properties[61]
This technique primarily requires three components: a polymer solution at a known concentration, a standard commercial airbrush with adjustable flow, and a source of compressed gas, preferably N2, as O2 is flammable. With these components, the technique can be employed for the in situ deposition of nanofiber mats and scaffolds, providing uniform coverage of non-conductive targets. The applications of this technique span various fields of tissue engineering and surgery[62] (Figure 3).
The solution blow spinning (SBS) technique offers several advantages in the production of nanofibers, making it a promising alternative to other techniques such as electrospinning and rotary spinning. Notable points include its versatility, simplicity, low cost, high productivity rate, and the fact that it does not require an electric field in the nanofiber manufacturing process[63]
SBS allows the processing of a wide range of materials, including polymers, ceramics, and composites, offering flexibility in material choice for different applications[64]
Compared to electrospinning, SBS generally requires simpler and less expensive equipment, facilitating the implementation of the technique on an industrial scale and allowing for large-scale production of nanofibers, with significantly higher production rates compared to electrospinning[65]

One of the greatest advantages, if not the most important, is that SBS does not require the application of an electric field, as is the case with electrospinning, which simplifies the process and reduces associated safety risks[66]
In summary, solution blow spinning stands out as a promising technique for large-scale nanofiber production, offering material versatility, simplicity, low cost, and high production rates[67] .
2.4.2
Although promising for nanofiber production, the solution blow spinning technique has some disadvantages that deserve attention. Among the disadvantages are the complexity of the process, the use of solvents, limited control over nanofiber morphology, variation in fiber distribution, and scalability, which remains a challenge and presents processing difficulties for some materials[67] .
Solution blow spinning involves various parameters that need to be precisely controlled, such as solution viscosity, temperature, air pressure, and fiber collection speed. This makes the process complex and challenging to optimize[68]
The technique requires the use of solvents, which can be toxic and harmful to the environment. The need to handle and dispose of these solvents demands safety precautions and increases production costs[69]
Compared to other techniques, such as electrospinning, solution blow spinning may offer less control over the diameter, alignment, and orientation of nanofibers. This can limit the application of nanofibers in some areas that require specific properties[70]
The technique can result in a wider distribution of fiber diameters, which can affect the uniformity of the final material’s properties[70]
Large-scale production using solution blow spinning is still a challenge, which limits its industrial application on a large scale[71]
Some materials can be difficult to process using solution blow spinning due to their viscosity or other rheological properties. Therefore, it is important to consider these disadvantages when choosing the most suitable nanofiber production technique for each application[71]
Rotary Jet Spinning, or centrifugal spinning, is a nanofiber production technique that uses the centrifugal force generated by a rotor attached to the shaft of a Brushless Spindle motor, which spins at high speed and is capable of stretching and solidifying polymer solutions, thus forming ultrafine fibers[72] .
Its operating principle is based on the centrifugal force that expels the polymer solution from the rotor’s reservoir compartment through orifices of known diameters. The polymer solution is poured into the rotor’s reservoir compartment during the equipment’s operation, which spins at high speeds between 2,000 and 24,000 rpm[73] .
The technique generally requires the use of highly volatile solvents, making it mandatory to use fume hoods to protect the equipment operator from the gases emitted by the solvents[6] .
Rotary Jet Spinning has been widely used in the medical-pharmaceutical field for the production of dressings, controlled drug release, tissue engineering, air and water filter manufacturing, fabrics with enhanced properties, and material reinforcement[74-77] (Figure 4).
The Rotary Jet Spinning technique, also known as ‘centrifugal spinning,’ offers several advantages in nanofiber production, making it an interesting alternative compared

to other conventional techniques. Here are some of the main advantages:
Rotary Jet Spinning allows for large-scale production of nanofibers, with significantly higher production rates compared to electrospinning. This is due to the centrifugal force used in the process, which enables the simultaneous ejection of multiple fibers in a short period of time[78] .
The technique is compatible with a wide range of materials, including polymers, ceramics, metals, and composites. This makes it suitable for various applications in different fields, such as pharmaceuticals, engineering, and the textile industry[79] .
Control of morphology is a noteworthy point, as Rotary Jet Spinning allows precise control over the diameter, alignment, and orientation of nanofibers, enabling the production of structures with specific properties for each application[80] .
Compared to electrospinning, Rotary Jet Spinning generally requires simpler and less expensive equipment, facilitating the implementation of the technique on an industrial scale and can be easily adapted for continuous production processes, which is advantageous for mass production of nanofibers[81]
In some cases, rotary spinning may require a smaller amount of solvents compared to electrospinning, which is beneficial from an environmental standpoint. Additionally, it has the capability to produce hollow nanofibers. The technique allows the production of hollow nanofibers, which have specific applications in areas such as drug microencapsulation and controlled substance release[82].
In summary, rotary spinning stands out as a promising technique for large-scale production of nanofibers, with a high production rate, material versatility, and control over fiber morphology[83]
Although rotary spinning offers significant advantages in the production of nanofibers, it also presents some disadvantages that should be considered, such as the limited control over fiber alignment. Unlike electrospinning, which allows for more precise fiber alignment, rotary spinning tends to produce nanofibers with random orientation. This can be a disadvantage in applications that require specific fiber alignment[84] .
Another feasible point of attention is the distribution of fiber diameter, as rotary spinning can present greater variation in fiber diameter compared to electrospinning. This can affect the uniformity of the final material’s properties[72]
Another relevant point is the difficulty in processing certain materials, as some materials can be more challenging to process through rotary spinning due to their viscosity or other rheological properties. This can limit the range of materials that can be used with this technique[85]
Precise control of the porosity of nanofiber mats can be more challenging in rotary spinning compared to electrospinning or other available techniques. Additionally, it is less suitable for the production of complex nanofiber structures, such as hollow or multilayer nanofibers[86] .
Safety is a determining factor in some cases, as the high rotation speed used in rotary spinning can pose safety risks, requiring appropriate protective equipment and strict safety measures[87 88]
It is important to emphasize that the choice of nanofiber production technique directly depends on the specific needs of each application. Rotary spinning can be an excellent option for large-scale production of nanofibers with random orientation, while electrospinning may be more suitable for applications that require precise control of fiber alignment
R. S., Maciel, E. M., Frattini, W. C., Medeiros, E. S., Fonseca, F. A. H., & Bianco, H. T.
and morphology[85,89]. Considering the different approaches discussed for nanofiber production, it is important to concisely summarize their main characteristics. Table 1 below presents a comparative overview of the five techniques discussed, highlighting the operating principle, advantages, limitations, and most common applications of each method. This summary contributes to a critical analysis in choosing the most appropriate technique, depending on the desired application.
Nanofibers have gained increasing attention in materials engineering, particularly for biomedical, pharmaceutical, and environmental applications. However, the transition of these technologies from bench to market faces substantial regulatory hurdles. The various nanofiber production techniques such as electrospinning, centrifugal spinning, self-assembly, and solution spinning pose specific challenges that hinder the standardization and validation processes required by regulatory agencies like the FDA (Food and Drug Administration) and EMA (European Medicines Agency)[90-93] .
One of the primary obstacles is related to scaling up manufacturing processes. While electrospinning is efficient at the laboratory scale, its low throughput and sensitivity to environmental conditions make it less suitable for large-scale production. Techniques like rotary jet spinning or melt-electrospinning writing demonstrate greater scalability potential but still lack standardized systems that ensure reproducibility across industrial batches[91-94]
Material reproducibility represents another critical challenge. Parameters such as solution viscosity, ambient humidity, surface tension, collection speed, and temperature directly affect nanofiber morphology, porosity, and diameter. Minor variations in these factors can lead to inconsistencies in physicochemical and functional properties, complicating efforts to meet strict quality and safety standards imposed by international regulations[92-94]
In addition, comprehensive characterization of nanofibers remains inadequately regulated. Methods to evaluate uniformity, stability, mechanical integrity, release kinetics, and behavior in biological systems are diverse and sometimes lack consensus. The absence of universally accepted protocols complicates harmonization among researchers, manufacturers, and regulatory bodies, making the approval process longer and less predictable[91-93]
In the pharmaceutical field, regulatory demands are even stricter. Nanofibers used for drug delivery or tissue engineering must demonstrate not only safety and efficacy but also interbatch reproducibility, long-term stability, absence of impurities, and biocompatibility. Manufacturing in Good Manufacturing Practice (GMP) environments is mandatory, yet not all current production methods are compatible with GMP requirements without significant technological adaptation[91-93]
Another major regulatory consideration is the need for robust preclinical and clinical testing. Although many nanofiber-based technologies show promising results in vitro and in animal models, translating these findings to human use requires extensive data on toxicokinetics, biodistribution, immunogenicity, and metabolic fate. Many devices or formulations fail at this stage not due to inefficacy, but due to a lack of comprehensive regulatory data[91-93]
The lack of international standardization in nanotechnology regulation further complicates product development. Each regulatory agency may use different criteria for evaluation, forcing developers to tailor regulatory dossiers for each jurisdiction. This increases costs and extends timelines, particularly impacting academic groups and startups with limited resources[91-93]
Consequently, despite the high innovation potential of nanofiber production techniques, their regulatory viability still depends on overcoming both technical and structural barriers. Advancements in automated manufacturing
TECHNIQUE WORKING PRINCIPLE ADVANTAGES DISADVANTAGES TYPICAL APPLICATIONS
Melt Blowing Extrusion of molten polymer with hot air to form nanofibers
Electrospinning Application of high electric field to a polymer solution to eject a jet
Supersonic CO2 Laser Stretching
Melting with CO2 laser followed by stretching with a supersonic jet
Solution Blow Spinning Spraying polymer solution with compressed gas (e.g., N2)
Rotary Jet Spinning Ejection of polymer solution by centrifugal force from a rotating rotor
Source: Own file.
High production rate, no solvent use, relatively low cost, high porosity
Precise control of morphology, wide range of materials, simple equipment
Solvent-free, continuous production, high uniformity, precise morphology control
High productivity, no need for electric field, versatile and low cost
High production rate, simple equipment, control over diameter and porosity
Limited morphology control, high temperature, limited materials, defect formation
Low production rate, complex parameter control, electrical safety risks
Expensive equipment, complex process, thermal risks, challenging scale-up
Less control over morphology, solvent use, fiber diameter variation
Limited fiber alignment, diameter variation, mechanical safety risk, porous structure control
Filtration, textile industry, industrial composites
Controlled drug delivery, tissue engineering, sensors
Medical devices, tissue engineering, flexible electronics
Wound dressings, tissue engineering, nanofibrous films
Wound dressings, drug release, tissue engineering, filters
Advances and challenges in nanofiber production: techniques and applications in nanotechnology
platforms, validated characterization protocols, and stronger collaboration among academia, industry, and regulatory bodies are essential to convert these promising technologies into accessible, approved products[91-93]
Nanofibers demonstrate vast potential in various engineering fields; however, their application in the medicalpharmaceutical field has stood out as a true revolution. The ability to provide more effective treatments, coupled with the concern for reducing healing time and the side effects of conventional medications, highlights the significant impact of this technology[90-93]. The applications discussed in this article will be presented below in a simple flowchart (Figure 5), followed by a detailed analysis later.
The control and efficient delivery of drugs to the site of action have been one of the greatest and main applications of nanofibers. The proper delivery of active pharmaceutical ingredients (API) and diagnostic agents to the receptor or desired site mainly depends on the choice of drug carrier[95-97]
The main purpose of the drug carrier in this field of knowledge is to ensure that the API has the maximum effect upon reaching the desired area, maintaining all its properties from the initial stage to the point where it reaches the target organs, thereby promoting proper drug release for better patient recovery[98-100]
Given this, nanofibers effectively meet all criteria for drug delivery. The use of polymers in nanofibers, such as gelatin, has proven to be a choice that provides better performance of the API, as it offers biodegradability and efficient compatibility with the human body, thus not causing damage to target organs nor allowing the fixation of toxins in the human body[101]
Drug delivery in wound treatment, when using conventional treatments, faces the problem of side effects caused by medications due to their low surface contact and inadequate uniformity. However, with the aid of nanofibers with drugs incorporated into them, it is possible to help partially or completely reduce the side effects[101,102] .
From another perspective, nanofibers act as a protective shield against enzymes and external agents that may settle and, in some way, hinder the ongoing healing process. When all these factors are considered and understood, it becomes evident that nanofibers are efficient drug carriers[96 99 103-105]
Nanofibers, structures with nanometric dimensions, emerge as promising tools in the fight against cancer, offering innovative applications in both diagnosis and treatment. In terms of diagnosis, nanofibers enable the creation of highly sensitive biosensors capable of detecting tumor biomarkers at minimal concentrations, allowing for early and precise disease diagnosis. Additionally, the ability to functionalize nanofibers with antibodies or other specific ligands allows for the creation of targeted imaging systems, which facilitate the visualization of tumors at early stages[101,106,107] .
Cancer has been a type of problem for the natural entity that has weakened everyone due to its limitations in curing. However, nanofibers have shown impressive performance in cancer diagnosis. Currently, for example, pathological examination is the technique used to detect tumors present in the body in general. However, single sample testing cannot fully provide the genomic character of a given tumor[108-110]
To counter this, Liquid Biopsy is being strongly preferred and involves collecting a blood sample to identify Circulating Tumor Cells (CTCs) that are directly injected into the bloodstream by solid tumors. Given this, nanofibers are very useful in regulating or delivering these CTCs much more easily[111,112]
In cancer treatment, nanofibers offer several advantages. Their high surface area and porosity allow the incorporation of anticancer drugs, therapeutic agents, or genetic material, enabling controlled and targeted release of these compounds to tumor cells. This approach minimizes the side effects associated with conventional chemotherapy and increases treatment efficacy. Additionally, nanofibers can be used in photothermal therapy, where they are functionalized with nanomaterials that absorb light and generate heat, selectively destroying cancer cells[113]
Cancer cells can also be efficiently cured and treated using magnetic nanofibers, which work in such a way that the magnetic nanoparticles present in the nanofibers heat the tumor from the inside and then it is destroyed. This heat is generated with the help of an external alternating magnetic field (AMF). Although heat regulation here is still a major concern. Thus, this proves that nanofiber is an effective technique for cancer diagnosis and treatment[114-116]
Additionally, biodegradable nanofibers can be used in the regeneration of tissues damaged by cancer or conventional treatments, promoting patient recovery. The versatility of nanofibers allows for the creation of personalized devices

R. S., Maciel, E. M., Frattini, W. C., Medeiros, E. S., Fonseca, F. A. H., & Bianco, H. T.
tailored to the specific needs of each patient, opening new perspectives for cancer treatment and diagnosis[117,118]
Nanofibers have shown extraordinary potential in the development of wound dressings and coverings, offering several advantages over traditional materials. Their nanometric structure provides a high surface area, which facilitates interaction with cells and tissues, promoting healing. Additionally, nanofibers can be designed to gradually release therapeutic agents, such as antibiotics and growth factors, accelerating the tissue repair process and preventing infections[119-121] .
The ability to control the composition and morphology of nanofibers allows for the creation of customized dressings for different types of wounds, ranging from superficial injuries to chronic ulcers. The flexibility and conformability of nanofibers also ensure a perfect adaptation to the wound surface, minimizing patient discomfort and promoting tissue regeneration. Additionally, the biodegradability of many nanofibers eliminates the need for dressing removal, reducing the risk of damage to newly formed tissue[122-124]
Continuous research in this area has explored the use of different polymers and manufacturing techniques to optimize the properties of nanofibers and expand their clinical applications. The combination of nanofibers with other technologies, such as photodynamic therapy and controlled gene release, has also shown promising results in the treatment of complex wounds. With the advancement of nanotechnology, nanofibers are expected to play an increasingly important role in regenerative medicine, offering innovative solutions for wound treatment and improving patients’ quality of life[125-127] .
In summary, the production of biodegradable nanofibers through the techniques explored in this article represents a significant advancement for pharmaceutical applications. Each method, from electrospinning to rotary jet spinning, offers unique advantages in terms of controlling the morphology, composition, and properties of nanofibers, allowing customization for different therapeutic needs. The diversity of techniques presented demonstrates the potential for innovation and the adaptability of nanotechnology to overcome challenges in drug delivery and regenerative medicine.
The choice of the ideal technique will depend on the specific application, the materials used, and the desired properties of the nanofibers. Continuous research and the development of new methodologies are crucial for improving the production of biodegradable nanofibers, optimizing drug release, interaction with biological tissues, and biodegradability. Additionally, the combination of different techniques and the incorporation of innovative materials can open new frontiers for the development of more effective and safer drug delivery systems.
Finally, biodegradable nanofibers represent a promising platform for the future of medicine, with the potential to revolutionize the treatment of various diseases and improve patients’ quality of life. Continuous research and development
in this area are essential to explore the full potential of this technology and ensure its benefits are accessible to everyone.
The future prospects for nanofiber production techniques are promising and diverse. With the continuous advancement of nanotechnology, it is expected that new production methodologies will be developed, focusing on more economical and sustainable processes. The exploration of biodegradable and biocompatible polymers will be crucial to overcoming current challenges, especially in the pharmaceutical sector, where controlled drug release can be enhanced. It can be inferred that research should also focus on optimizing existing techniques, aiming to increase the efficiency and quality of the nanofibers produced, which can lead to significant improvements in medical-pharmaceutical devices, biomaterials, and other industrial applications.
Additionally, the versatility of nanofibers will continue to expand their use in various fields. Human tissue engineering, air and water filter manufacturing, and the textile industry are just a few sectors that can benefit from the unique properties of nanofibers. The ability for large-scale production and the simplicity of manufacturing are factors driving continuous interest and global research. With increased investment in nanotechnology, it is likely that new applications and technological improvements will emerge, solidifying nanofibers as essential components in various industries and promoting significant advancements in science and medicine.
• Conceptualization – Roberto da Silva Gusmão; Erandi Mendes Maciel; Walquíria Cubíssimo Frattini; Eliton Souto de Medeiros; Francisco Antonio Helfenstein Fonseca; Henrique Tria Bianco.
• Data curation – Roberto da Silva Gusmão; Erandi Mendes Maciel; Walquíria Cubíssimo Frattini; Eliton Souto de Medeiros; Francisco Antonio Helfenstein Fonseca; Henrique Tria Bianco.
• Formal analysis – Roberto da Silva Gusmão; Erandi Mendes Maciel; Walquíria Cubíssimo Frattini; Eliton Souto de Medeiros; Francisco Antonio Helfenstein Fonseca; Henrique Tria Bianco.
• Funding acquisition – NA.
• Investigation – Roberto da Silva Gusmão; Erandi Mendes Maciel; Walquíria Cubíssimo Frattini; Eliton Souto de Medeiros.
• Methodology – Roberto da Silva Gusmão; Erandi Mendes Maciel; Walquíria Cubíssimo Frattini; Eliton Souto de Medeiros; Francisco Antonio Helfenstein Fonseca; Henrique Tria Bianco.
• Project administration – Roberto da Silva Gusmão.
• Resources – NA.
• Software – Roberto da Silva Gusmão.
• Supervision – Roberto da Silva Gusmão; Francisco Antonio Helfenstein Fonseca; Henrique Tria Bianco.
• Validation – Francisco Antonio Helfenstein Fonseca; Henrique Tria Bianco.
Advances and challenges in nanofiber production: techniques and applications in nanotechnology
• Visualization – Roberto da Silva Gusmão; Erandi Mendes Maciel; Walquíria Cubíssimo Frattini; Eliton Souto de Medeiros; Francisco Antonio Helfenstein Fonseca; Henrique Tria Bianco.
• Writing – original draft – Roberto da Silva Gusmão.
• Writing – review & editing – Roberto da Silva Gusmão; Erandi Mendes Maciel; Walquíria Cubíssimo Frattini; Eliton Souto de Medeiros; Francisco Antonio Helfenstein Fonseca; Henrique Tria Bianco.
1 Al-Jbour, N. D., Beg, M. D., Gimbun, J., & Alam, A. (2019). An overview of chitosan nanofibers and their applications in the drug delivery process. Current Drug Delivery, 16(4), 272-294 http://doi.org/10.2174/156720181666619012312 1425
2 Chen, Z., Guan, M., Bian, Y., & Yin, X. (2023). Multifunctional electrospun nanofibers for biosensing and biomedical engineering applications. Biosensors, 14(1), 13 http://doi. org/10.3390/bios14010013 PMid:38248390.
3. Haque, S. T., Saha, S. K., Haque, M. E., & Biswas, N. (2021). Nanotechnology-based therapeutic applications: in vitro and in vivo clinical studies for diabetic wound healing. Biomaterials Science, 9(23), 7705-7747 http://doi.org/10.1039/ D1BM01211H PMid:34709244.
4 Naidu, K. C. B., Kumar, N. S., Banerjee, P., & Reddy, B. V. S. (2021). A review on the origin of nanofibers/nanorods structures and applications. Journal of Materials Science. Materials in Medicine , 32 (6), 68 http://doi.org/10.1007/ s10856-021-06541-7 PMid:34117944.
5 Rasouli, R., Barhoum, A., Bechelany, M., & Dufresne, A. (2019). Nanofibers for biomedical and healthcare applications. Macromolecular Bioscience, 19(2), e1800256. http://doi. org/10.1002/mabi.201800256 PMid:30485660.
6 Bahú, J. O., Andrade, L. R. M., Crivellin, S., Khouri, N. G., Sousa, S. O., Fernandes, L. M. I., Souza, S. D. A., Concha, L. S. C., Schiavon, M. I. R. B., Benites, C. I., Severino, P., Souto, E. B., & Concha, V. O. C. (2022). Rotary Jet Spinning (RJS): a key process to produce biopolymeric wound dressings. Pharmaceutics, 14(11), 2500 http://doi. org/10.3390/pharmaceutics14112500 PMid:36432691.
7 Snari, R. M., Bayazeed, A., Ibarhiam, S. F., Alnoman, R. B., Attar, R., Abumelha, H. M., & El-Metwaly, N. M. (2022). Solution blowing spinning of polylactate/polyvinyl alcohol/ ZnO nanocomposite toward green and sustainable preparation of wound dressing nanofibrous films. Microscopy Research and Technique, 85(12), 3860-3870 http://doi.org/10.1002/ jemt.24237 PMid:36178460.
8 Suzuki, A., & Arino, K. (2012). Polypropylene nanofiber sheets prepared by CO2 laser supersonic multi-drawing. European Polymer Journal, 48(7), 1169-1176 http://doi. org/10.1016/j.eurpolymj.2012.04.003
9 Vass , P. , Szabó , E. , Domokos , A. , Hirsch , E. , Galata , D. , Farkas , B. , Démuth , B. , Andersen , S. K. , Vigh , T. , Verreck, G., Marosi, G., & Nagy, Z. K. (2020). Scale-up of electrospinning technology: applications in the pharmaceutical industry. Wiley Interdisciplinary Reviews. Nanomedicine and Nanobiotechnology, 12(4), e1611 http://doi.org/10.1002/ wnan.1611 PMid:31863572.
10 Wu , W. , Han , W. , Sun , Y. , Yi , H. , & Wang , X. ( 2024 ). Experimental study of the airflow field and fiber motion in the melt-blowing process. Polymers , 16 ( 4 ), 469 http://doi.org/10.3390/polym16040469 PMid:38399847.
11 Hufenus, R., Yan, Y., Dauner, M., & Kikutani, T. (2020). Meltspun fibers for textile applications. Materials, 13(19), 4298. http://doi.org/10.3390/ma13194298 PMid:32993085.
12. Koenig, K., Beukenberg, K., Langensiepen, F., & Seide, G. (2019). A new prototype melt-electrospinning device for the production of biobased thermoplastic sub-microfibers and nanofibers. Biomaterials Research , 23 ( 1 ), 10 http://doi.org/10.1186/s40824-019-0159-9. PMid:30976458.
13 König, S., Kreis, P., Herbert, C., Wego, A., Steinmann, M., Wang, D., Frank, E., & Buchmeiser, M. R. (2020). Melt-spinning of an intrinsically flame-retardant polyacrylonitrile copolymer. Materials, 13(21), 4826 http://doi.org/10.3390/ma13214826 PMid:33126721.
14. Marx, B., Bostan, L., Herrmann, A. S., Boskamp, L., & Koschek, K. (2023). Properties of stereocomplex PLA for melt spinning. Polymers, 15(23), 4510 http://doi.org/10.3390/polym15234510 PMid:38231930.
15. Rosenbaum, C., Großmann, L., Neumann, E., Jungfleisch, P., Türeli, E., & Weitschies, W. (2022). Development of a hot-melt-extrusion-based spinning process to produce pharmaceutical fibers and yarns. Pharmaceutics, 14(6), 1229 http://doi.org/10.3390/pharmaceutics14061229 PMid:35745801.
16 Roungpaisan, N., Srisawat, N., Rungruangkitkrai, N., Chartvivatpornchai, N., Boonyarit, J., Kittikorn, T., & Chollakup, R. (2023). Melt spinning process optimization of polyethylene terephthalate fiber structure and properties from Tetron cotton knitted fabric. Polymers, 15(22), 4364 http://doi.org/10.3390/ polym15224364 PMid:38006089.
17 Zhang, K., Zhao, W., Liu, Q., & Yu, M. (2021). A new magnetic melt spinning device for patterned nanofiber. Scientific Reports, 11(1), 8895 http://doi.org/10.1038/s41598-021-88520-0 PMid:33903691.
18 Rostamitabar, M., Abdelgawad, A. M., Jockenhoevel, S., & Ghazanfari, S. (2021). Drug-eluting medical textiles: from fiber production and textile fabrication to drug loading and delivery. Macromolecular Bioscience, 21(7), e2100021 http://doi.org/10.1002/mabi.202100021 PMid:33951278.
19 Zhao, R., He, H., Cai, M., Miao, D., Yuan, D., Ming, J., Wang, N., & Ning, X. (2019). Nano-crystalline sandwich formed in polylactic acid fibers. Macromolecular Rapid Communications, 40(23), e1900492 http://doi.org/10.1002/marc.201900492 PMid:31693258.
20 Probst, H., Katzer, K., Nocke, A., Hickmann, R., Zimmermann, M., & Cherif, C. (2021). Melt spinning of highly stretchable, electrically conductive filament yarns. Polymers, 13(4), 590 http://doi.org/10.3390/polym13040590 PMid:33669330.
21 Wannid, P., Hararak, B., Padee, S., Klinsukhon, W., Suwannamek, N., Raita, M., Champreda, V., & Prahsarn, C. (2023). Fiber melt spinning and thermo-stabilization of para-rubber wood lignin: an approach for fully biomass precursor preparation. ACS Omega, 8(37), 33891-33903. http://doi.org/10.1021/acsomega.3c04590. PMid:37744868.
22 Kim, D. H., Kim, T., Lee, S. W., Kim, H.-S., Shin, W. H., & Kim, S.-I. (2021). Investigation of phase segregation in p-type Bi0.5Sb1.5Te3 thermoelectric alloys by in situ melt spinning to determine possible carrier filtering effect. Materials, 14(24), 7567. http://doi.org/10.3390/ma14247567. PMid:34947161.
23 Ostheller, M.-E., Balakrishnan, N. K., Beukenberg, K., Groten, R., & Seide, G. (2023). Pilot-scale melt electrospinning of polybutylene succinate fiber mats for a biobased and biodegradable face mask. Polymers , 15 (13), 2936. http://doi.org/10.3390/polym15132936 PMid:37447581.
24 Stieglitz, L., Geiger, C., Großmann, P. F., Kränzlein, M., Rodewald, K., Müller-Buschbaum, P., & Rieger, B. (2023). Fiber spinning of ultrahigh molecular weight isotactic polypropylene: melt spinning and melt drawing. ChemPlusChem, 88(3), e202300045 http://doi.org/10.1002/cplu.202300045 PMid:36786339.
Gusmão, R. S., Maciel, E. M., Frattini, W. C., Medeiros, E. S., Fonseca, F. A. H., & Bianco, H. T.
25 Balogh, A., Farkas, B., Faragó, K., Farkas, A., Wagner, I., Van Assche, I., Verreck, G., Nagy, Z. K., & Marosi, G. (2015). Melt-blown and electrospun drug-loaded polymer fiber mats for dissolution enhancement: a comparative study. Journal of Pharmaceutical Sciences, 104(5), 1767-1776 http://doi. org/10.1002/jps.24399. PMid:25761776.
26 Song, J., Li, Z., & Wu, H. (2020). Blowspinning: a new choice for nanofibers. ACS Applied Materials & Interfaces, 12(30), 33447-33464. http://doi.org/10.1021/acsami.0c05740. PMid:32628010.
27 Halim, N., Nallusamy, N., Lakshminarayanan, R., Ramakrishna, S., & Vigneswari, S. (2025). Electrospinning in drug delivery: progress and future outlook. Macromolecular Rapid Communications, 46(13), e2400903 http://doi.org/10.1002/marc.202400903 PMid:39973618.
28 Nadaf, A., Gupta, A., Hasan, N., Fauziya, Ahmad, S., Kesharwani, P., & Ahmad, F. J. (2022). Recent update on electrospinning and electrospun nanofibers: current trends and their applications. RSC Advances, 12(37), 23808-23828. http://doi.org/10.1039/ D2RA02864F PMid:36093244.
29 Ingavle, G. C., & Leach, J. K. (2014). Advancements in electrospinning of polymeric nanofibrous scaffolds for tissue engineering. Tissue Engineering. Part B, Reviews, 20(4), 277-293 http://doi.org/10.1089/ten.teb.2013.0276 PMid:24004443.
30 Valizadeh, A., & Farkhani, S. M. (2014). Electrospinning and electrospun nanofibres. IET Nanobiotechnology, 8(2), 83-92 http://doi.org/10.1049/iet-nbt.2012.0040 PMid:25014079.
31 Huang, H., Song, Y., Zhang, Y., Li, Y., Li, J., Lu, X., & Wang, C. (2022). Electrospun nanofibers: current progress and applications in food systems. Journal of Agricultural and Food Chemistry, 70(5), 1391-1409 http://doi.org/10.1021/ acs.jafc.1c05352. PMid:35089013.
32 Khalf, A., & Madihally, S. V. (2017). Recent advances in multiaxial electrospinning for drug delivery. European Journal of Pharmaceutics and Biopharmaceutics, 112, 1-17. http://doi. org/10.1016/j.ejpb.2016.11.010 PMid:27865991.
33 Zulkifli, M. Z. A., Nordin, D., Shaari, N., & Kamarudin, S. K. (2023). Overview of electrospinning for tissue engineering applications. Polymers, 15(11), 2418 http://doi.org/10.3390/ polym15112418 PMid:37299217.
34 Nangare, S., Jadhav, N., Ghagare, P., & Muthane, T. (2020). Pharmaceutical applications of electrospinning. Annales Pharmaceutiques Francaises, 78(1), 1-11 http://doi.org/10.1016/j. pharma.2019.07.002 PMid:31564424.
35 Che, H., & Yuan, J. (2021). Recent advances in electrospinning supramolecular systems. Journal of Materials Chemistry. B, Materials for Biology and Medicine , 10 ( 1 ), 8 - 19 http://doi.org/10.1039/D1TB02304G. PMid:34878489.
36 Yu, D.-G., He, W., He, C., Liu, H., & Yang, H. (2025). Versatility of electrospun Janus wound dressings. Nanomedicine (London), 20(3), 271-278. http://doi.org/10.1080/17435889.202 4.2446139 PMid:39716850.
37 Madruga, L. Y. C., & Kipper, M. J. (2022). Expanding the repertoire of electrospinning: new and emerging biopolymers, techniques, and applications. Advanced Healthcare Materials, 11(4), e2101979 http://doi.org/10.1002/adhm.202101979 PMid:34788898.
38 Zhang, C., Li, Y., Wang, P., & Zhang, H. (2020). Electrospinning of nanofibers: potentials and perspectives for active food packaging. Comprehensive Reviews in Food Science and Food Safety, 19(2), 479-502. http://doi.org/10.1111/1541-4337.12536. PMid:33325166.
39 Gupta , K. C. , Haider, A. , Choi , Y.-R. , & Kang , I.-K. (2014). Nanofibrous scaffolds in biomedical applications. Biomaterials Research , 18 ( 1 ), BMC2055-7124-18-5 http://doi.org/10.1186/2055-7124-18-5
40 Suzuki, A., & Tanizawa, K. (2009). Poly(ethylene terephthalate) nanofibers prepared by CO2 laser supersonic drawing. Polymer, 50(3), 913-921. http://doi.org/10.1016/j.polymer.2008.12.037.
41 Suzuki, A., Mikuni, T., & Hasegawa, T. (2014). Nylon 66 nanofibers prepared by CO2 laser supersonic drawing. Journal of Applied Polymer Science, 131(6), app.40015. http://doi. org/10.1002/app.40015
42 Suzuki, A., & Aoki, K. (2008). Biodegradable poly(l-lactic acid) nanofiber prepared by a carbon dioxide laser supersonic drawing. European Polymer Journal , 44(8), 2499-2505. http://doi.org/10.1016/j.eurpolymj.2008.05.021
43 Suzuki, A., & Imajo, K. (2016). Poly(l-lactic acid) nanofiber multifilament prepared by carbon dioxide laser supersonic multi-drawing. Polymer, 91, 24-32 http://doi.org/10.1016/j. polymer.2016.03.053
44 Fukuhara, K., Yamada, T., & Suzuki, A. (2012). Characterization of fluoropolymer nanofiber sheets fabricated by CO2 laser drawing without solvents. Industrial & Engineering Chemistry Research, 51(30), 10117-10123 http://doi.org/10.1021/ ie301138t
45 Ueta, I., Sekiguchi, N., Suzuki, A., Kobayashi, Y., Kuwabara, T., & Saito, Y. (2020). Polyethylene terephthalate nanofiber sheet as the novel extraction medium for the determination of phthalates in water samples. Analytical Sciences, 36(2), 277-281. http://doi.org/10.2116/analsci.19P317 PMid:31611475.
46 Zhang, C., Chen, M., Li, H., Yang, W., & Tan, J. (2022). The critical roles of the gas flow in fabricating polymer nanofibers: a mini-review. Advanced Fiber Materials, 4(2), 162-170 http://doi.org/10.1007/s42765-021-00114-7
47 Chen, X., Cao, H., He, Y., Zhou, Q., Li, Z., Wang, W., He, Y., Tao, G., & Hou, C. (2022). Advanced functional nanofibers: strategies to improve performance and expand functions. Frontiers of Optoelectronics, 15(1), 50 http://doi.org/10.1007/ s12200-022-00051-2 PMid:36567731.
48 Singh, S. (2019). Nanofiber Electrodes for Biosensors. In A. Barhoum, M. Bechelany, & A. Makhlouf (Eds.), Handbook of nanofibers (pp 869-885). Cham: Springer http://doi. org/10.1007/978-3-319-53655-2_41
49 Zhang, X., Jin, G., Ma, W., Meng, L., Yin, H., Zhu, Z., Dong, Z., & Wang, R. (2015). Fabrication and properties of poly (l‐lactide) nanofibers via blend sea‐island melt spinning. Journal of Applied Polymer Science, 132(1), 41228. http://doi.org/10.1002/app.41228
50 Riveiro, A., Quintero, F., del Val, J., Pires, R. A., Comesaña, R., Lusquiños, F., Jones, J. R., Reis, R. L., & Pou, J. (2019). Laser spinning of 13-93 bioactive glass nanofibers. In Materials Science and Technology 2019 (MS&T19). Pittsburgh: TMS http://doi.org/10.7449/2019/MST_2019_946_951
51. Silva, V., Gonçalves, J. M., Dias, Y. J., Simões, T. A., Macedo, D. A., Shahbazian-Yassar, R., Torresi, R. M., Yarin, A. L., & Medeiros, E. S. (2024). Supersonic solution blowing: a novel approach to producing self-supported carbon–silica microporous nanofibers for Li-ion battery anodes. Journal of Materials Science, 59(6), 2449-2465 http://doi.org/10.1007/ s10853-024-09374-1
52 Oliveira, A. E., Bonfim, D. P. F., Salussoglia, A. I. P., Medeiros, G. B., Guerra, V. G., & Aguiar, M. L. (2022). Nanofiber production techniques applied to filtration processes. In C. M. Hussain, & G. M. Costa (Eds.),Environmental, ethical, and economical issues of nanotechnology (pp. 31-60). New York: Jenny Stanford Publishing http://doi.org/10.1201/9781003261858-2
53 Lu, J., Aggarwal, R., Pompili, V. J., & Das, H. (2010). A novel technology for hematopoietic stem cell expansion using combination of nanofiber and growth factors. Recent Patents on Nanotechnology , 4 ( 2 ), 125 - 135 http://doi.org/10.2174/187221010791208777 PMid:20420564.
35(4), e20250039, 2025
Advances and challenges in nanofiber production: techniques and applications in nanotechnology
54 Sekar, A. D., & Manickam, M. (2019). Current trends of electrospun nanofibers in water and wastewater treatment. In X. T. Bui, C. Chiemchaisri, T. Fujioka, & S. Varjani (Eds.), Water and wastewater treatment technologies (pp. 469-485). Singapore: Springer http://doi.org/10.1007/978-981-13-3259-3_21
55 Batool, S., Nabipour, H., Ramakrishna, S., & Mozafari, M. (2022). Nanotechnology and quantum science enabled advances in neurological medical applications: diagnostics and treatments. Medical & Biological Engineering & Computing, 60(12), 33413356 http://doi.org/10.1007/s11517-022-02664-3 PMid:36207564.
56. Bose, S., Padilla, V., Salinas, A., Ahmad, F., Lodge, T. P., Ellison, C. J., & Lozano, K. (2023). Hierarchical design strategies to produce internally structured nanofibers. Polymer Reviews, 63(3), 679-714 http://doi.org/10.1080/15583724.2022.2132509
57. Farias, R. M. C., Menezes, R. R., Oliveira, J. E., & Medeiros, E. S. (2015). Production of submicrometric fibers of mullite by solution blow spinning (SBS). Materials Letters, 149, 47-49 http://doi.org/10.1016/j.matlet.2015.02.111
58. Medeiros, E. S., Glenn, G. M., Klamczynski, A. P., Orts, W. J., & Mattoso, L. H. C. (2009). Solution blow spinning: A new method to produce micro- and nanofibers from polymer solutions. Journal of Applied Polymer Science , 113 (4), 2322-2330. http://doi.org/10.1002/app.30275.
59 Silva, V. D. (2023). Produção de nanofibras pelas técnicas de Solution Blow Spinning (SBS) e Supersonic Solution Blowing (SSB) e suas aplicações para conversão e armazenamento de energia (Tese de doutorado). Universidade Federal da Paraíba, João Pessoa Retrieved in 2025, May 20, from https://repositorio.ufpb.br/jspui/handle/123456789/26994
60 Silva, V., Medeiros, E. S., & Torresi, R. M. (2024). A perspective on the Supersonic Solution Blowing: nanofibers at the forefront of energy storage and conversion, and environmental remediation. Journal of the Brazilian Chemical Society, 35(11), e-20240065 http://doi.org/10.21577/0103-5053.20240065
61. Medeiros, E. L. G., Braz, A. L., Porto, I. J., Menner, A., Bismarck, A., Boccaccini, A. R., Lepry, W. C., Nazhat, S. N., Medeiros, E. S., & Blaker, J. J. (2016). Porous bioactive nanofibers via cryogenic solution blow spinning and their formation into 3D macroporous scaffolds. ACS Biomaterials Science & Engineering, 2(9), 1442-1449 http://doi.org/10.1021/ acsbiomaterials.6b00072 PMid:33440582.
62 Santos, D. M., Correa, D. S., Medeiros, E. S., Oliveira, J. E., & Mattoso, L. H. C. (2020). Advances in functional polymer nanofibers: from spinning fabrication techniques to recent biomedical applications. ACS Applied Materials & Interfaces, 12(41), 45673-45701 http://doi.org/10.1021/acsami.0c12410 PMid:32937068.
63 Santos, A. M. C., Medeiros, E. L. G., Blaker, J. J., & Medeiros, E. S. (2016). Aqueous solution blow spinning of poly (vinyl alcohol) micro- and nanofibers. Materials Letters, 176, 122-126 http://doi.org/10.1016/j.matlet.2016.04.101
64 Raimundo, R. A., Silva, V. D., Silva, T. R., Medeiros, E. S., Macedo, D. A., Gomes, U. U., Gomes, R. M., & Morales, M. A. (2022). Synthesis and characterization of NiFe-carbon fibers by solution blow spinning and application for the oxygen evolution reaction. Journal of Physics and Chemistry of Solids, 160, 110311 http://doi.org/10.1016/j.jpcs.2021.110311
65 Ferreira, K. N., Oliveira, R. R., Castellano, L. R. C., Bonan, P. R. F., Carvalho, O. V., Pena, L., Souza, J. R., Oliveira, J. E., & Medeiros, E. S. (2022). Controlled release and antiviral activity of acyclovir-loaded PLA/PEG nanofibers produced by solution blow spinning. Biomaterials Advances, 136, 212785 http://doi.org/10.1016/j.bioadv.2022.212785 PMid:35929318.
66 Cerqueira, G. R. C., Gomes, D. S., Victor, R. S., Figueiredo, L. R. F., Medeiros, E. S., Neves, G. A., Menezes, R. R., & Silva, S. M. L. (2024). Development of PVA/chitosan nanofibers
by a green route using solution blow spinning. Journal of Polymers and the Environment, 32(3), 1489-1499 http://doi. org/10.1007/s10924-023-03033-3
67 Natarelli, C. V. L., Lopes, C. M. S., Carneiro, J. S. S., Melo, L. C. A., Oliveira, J. E., & Medeiros, E. S. (2021). Zinc slow-release systems for maize using biodegradable PBAT nanofibers obtained by solution blow spinning. Journal of Materials Science, 56(7), 4896-4908 http://doi.org/10.1007/ s10853-020-05545-y
68. Shi, L., Zhuang, X., Cheng, B., Tao, X., & Kang, W. (2014). Solution blowing of poly (dimethylsiloxane)/nylon 6 nanofiber mats for protective applications. Chinese Journal of Polymer Science, 32(6), 786-792 http://doi.org/10.1007/s10118-0141452-7
69 Medeiros, E. L. G. (2018). Desenvolvimento de scaffolds nanofibrilares de vidros bioativos pelo solution blow spinning (SBS) (Dissertação de mestrado). Universidade Federal de Campina Grande, Campina Grande. Retrieved in 2025, May 20, from https://dspace.sti.ufcg.edu.br/handle/riufcg/17962
70 Lopes, C. M. S. (2024). Produção de fibras de carbono por solution blow spinning usando poliacrilonitrila (PAN) como precursor (Dissertação de mestrado). Universidade Federal da Paraíba, João Pessoa. Retrieved in 2025, May 20, from https://repositorio.ufpb.br/jspui/handle/123456789/33431
71 Dias, R. T. A. (2019). Desenvolvimento de sistemas visando o tratamento de lesões cutâneas à base de fibras de PLA/PEG e própolis vermelha produzidas por solution blow spinning (Tese de doutorado). Universidade Federal da Paraíba, João Pessoa. Retrieved in 2025, May 20, from https://repositorio. ufpb.br/jspui/handle/123456789/19172
72. Rogalski, J. J., Bastiaansen, C. W., & Peijs, T. (2017). Rotary jet spinning review: a potential high yield future for polymer nanofibers. Nanocomposites, 3(4), 97-121. http://doi.org/10. 1080/20550324.2017.1393919.
73 Badrossamay, M. R., McIlwee, H. A., Goss, J. A., & Parker, K. K. (2010). Nanofiber assembly by rotary jet-spinning. Nano Letters, 10(6), 2257-2261 http://doi.org/10.1021/nl101355x PMid:20491499.
74 Pinto, S. A. A., Dias, F. J. N., Cardoso, G. B. C., Santos, A. R., Jr., Aro, A. A., Pino, D. S., Meneghetti, D. H., Vitti, R. P., Santos, G. M. T., & Zavaglia, C. A. C. (2022). Polycaprolactone/betatricalcium phosphate scaffolds obtained via rotary jet-spinning: in vitro and in vivo evaluation. Cells, Tissues, Organs, 211(4), 477-491 http://doi.org/10.1159/000511570 PMid:33691307.
75 Golecki, H. M., Yuan, H., Glavin, C., Potter, B., Badrossamay, M. R., Goss, J. A., Phillips, M. D., & Parker, K. K. (2014). Effect of solvent evaporation on fiber morphology in rotary jet spinning. Langmuir, 30(44), 13369-13374 http://doi. org/10.1021/la5023104 PMid:25353398.
76. Huang, X., Hong, D., Chen, Z., Zhang, Z., Ye, P., & Xu, Q. (2025). Simulation of polymer solution slip motion and composite fiber fabrication in rotary jet spinning. Journal of the Textile Institute, 116(5), 817-824. http://doi.org/10.1080/ 00405000.2024.2356320.
77 Mellado, P., McIlwee, H. A., Badrossamay, M. R., Goss, J. A., Mahadevan, L., & Parker, K. K. (2011). A simple model for nanofiber formation by rotary jet-spinning. Applied Physics Letters, 99(20), 203107 http://doi.org/10.1063/1.3662015
78 Chang, H., Liu, Q., Zimmerman, J. F., Lee, K. Y., Jin, Q., Peters, M. M., Rosnach, M., Choi, S., Kim, S. L., Ardoña, H. A. M., MacQueen, L. A., Chantre, C. O., Motta, S. E., Cordoves, E. M., & Parker, K. K. (2022). Recreating the heart’s helical structure-function relationship with focused rotary jet spinning. Science, 377(6602), 180-185 http://doi.org/10.1126/science. abl6395 PMid:35857545.
79 Mîndru, T. B., Ignat, L., Mîndru, I. B., & Pinteala, M. (2013). Morphological aspects of polymer fiber mats obtained by air flow rotary-jet spinning. Fibers and Polymers, 14(9), 1526-1534. http://doi.org/10.1007/s12221-013-1526-0
80 Dias, F. J. N., Pinto, S. A. A., Santos, A. R., Jr., Mainardi, M. C. A. J., Rischka, K., & Zavaglia, C. A. C. (2022). Resveratrolloaded polycaprolactone scaffolds obtained by rotary jet spinning. IJPAC. International Journal of Polymer Analysis and Characterization, 27(5), 289-301 http://doi.org/10.1080 /1023666X.2022.2068242.
81 Vida, T. A., Motta, A. C., Santos, A. R., Jr., Cardoso, G. B. C., Brito, C. C., & Zavaglia, C. A. C. (2018). Fibrous PCL/PLLA scaffolds obtained by rotary jet spinning and electrospinning. Materials Research, 20(Suppl 2), 910-916 http://doi.org/10.1590/1980-5373-mr-2016-0969
82 Vida, T. A., Motta, A. C., Santos, A. R., Jr., Zavaglia, C. A. C., & Cardoso, G. B. C. (2016). Fibrous scaffold produced by rotary jet spinning technique. International Journal of Engineering Research and Applications, 6(8), 22-27. Retrieved in 2025, May 20, from https://www.ijera.com/papers/Vol6_issue8/ Part-%201/E0608012227.pdf
83 Rigon, G. R. (2013). Matrizes de compósitos de PLDLA com hidroxiapatita obtidas por rotofiação para utilização em engenharia tecidual (Dissertação de mestrado). Universidade Estadual de Campinas, Campinas http://doi.org/10.47749/T/ UNICAMP.2013.905868
84 Barbosa, M. A. (2016). Desenvolvimento e avaliação antimicrobiana “in vitro” de nanofibras de PLA/PEG com Terpinen-4-OL e clorexidina contra Aggregatibacter actinomycetemcomitans (Dissertação de mestrado). Universidade Federal da Paraíba, João Pessoa. Retrieved in 2025, May 20, from https://repositorio. ufpb.br/jspui/handle/tede/9096
85 Yang, S. B., Sabina, Y., Deng, Y., & Yeum, J. H. (2018). Variation in nanofiber-collection location depending on process variables for centrifugal spinning system. Nanoscience and Nanotechnology Letters, 10(8), 1046-1052 http://doi. org/10.1166/nnl.2018.2745
86 Oh, H. J., Kim, D., Choi, Y. C., Lim, S., Jeong, J. B., Ko, J. H., Hahm, W., Kim, S., Lee, Y., Kim, H., & Yeang, B. J. (2020). Fabrication of piezoelectric poly(L-lactic acid)/BaTiO3 fiber by the melt-spinning process. Scientific Reports, 10(1), 16339 http://doi.org/10.1038/s41598-020-73261-3 PMid:33004904.
87 Chen, C., Dirican, M., & Zhang, X. (2019). Centrifugal spinning: high rate production of nanofibers. In B. Ding, X. Wang, & J. Yu (Eds.), Electrospinning: nanofabrication and applications (pp. 321-338). Amsterdam: Elsevier http://doi. org/10.1016/B978-0-323-51270-1.00010-8
88 Ma, J., Wang, Y., Chen, Z., Zhang, Z., & Ji, Q. (2025). Investigation of PEO/HEC composite fiber fabrication and liquid-wall slip behavior in rotary force spinning. Journal of Applied Polymer Science, 142(19), e56868 http://doi.org/10.1002/app.56868
89 Yang, H., Wang, Y. C., Jang, Y., Shani, K., Jiao, Q., Peters, M., Parker, K. K., & Vlassak, J. J. (2025). Biomimetic hierarchical fibrous hydrogels with high alignment and flaw insensitivity. Matter, 8(6), 102054 http://doi.org/10.1016/j.matt.2025.102054
90 Brako, F., & Boateng, J. (2025). Transmucosal drug delivery: prospects, challenges, advances, and future directions. Expert Opinion on Drug Delivery, 22(4), 525-553 http://doi.org/10. 1080/17425247.2025.2470224 PMid:39976299.
91 Panda, P., Mohanty, S., Gouda, S. R., & Mohapatra, R. (2025). Advances in nanomedicine for retinal drug delivery: overcoming barriers and enhancing therapeutic outcomes. Journal of Drug Targeting, 33(5), 587-611 http://doi.org/10. 1080/1061186X.2024.2443144. PMid:39694681.
92 Schumacher, G., Preston, S., Smith, A., Sajgalik, P., Flambard, A. R., Juliet, P., Knott, B., Lee-Müller, S.-L., Lences, Z.,
Reschke, S., & Tunger, D. (2007). Future perspectives of european materials research Jülich: Forschungszentrum Jülich
93 Shiva, Y., Vadla, P., Rodda, S., Parimi, D. S., Paila, B., Dasari, V. V., & Suresh, A. K. (2025). Fundamentals of nano-based drug delivery systems. In M. M. Ansari, A. K. Suresh, & N. Akhtar (Eds.), Emergence of sustainable biomaterials in tackling inflammatory diseases (pp. 131-152). Singapore: Springer. http://doi.org/10.1007/978-981-96-2112-5_4
94 Barhoum, A., García-Betancourt, M. L., Jeevanandam, J., Hussien, E. A., Mekkawy, S. A., Mostafa, M., Omran, M. M., Abdalla, M. S., & Bechelany, M. (2022). Review on natural, incidental, bioinspired, and engineered nanomaterials: History, definitions, classifications, synthesis, properties, market, toxicities, risks, and regulations. Nanomaterials, 12(2), 177 http://doi.org/10.3390/nano12020177 PMid:35055196.
95 Rahmani, M., Bidgoli, S. A., & Rezayat, S. M. (2017). Electrospun polymeric nanofibers for transdermal drug delivery. Nanomedicine Journal, 4(2), 61-70 http://doi.org/10.22038/ nmj.2017.8407.
96 Sa’adon, S., Abd Razak, S. I., Ismail, A. E., & Fakhruddin, K. (2019). Drug-loaded poly-vinyl alcohol electrospun nanofibers for transdermal drug delivery: review on factors affecting the drug release. Procedia Computer Science, 158, 436-442. http://doi.org/10.1016/j.procs.2019.09.073
97 Talebi, N., Lopes, D., Lopes, J., Macário-Soares, A., Dan, A. K., Ghanbari, R., Kahkesh, K. H., Peixoto, D., Giram, P. S., Raza, F., Veiga, F., Sharifi, E., Hamishehkar, H., & Paiva-Santos, A. C. (2023). Natural polymeric nanofibers in transdermal drug delivery. Applied Materials Today, 30, 101726 http://doi.org/10.1016/j.apmt.2022.101726
98. Cui, Z., Zheng, Z., Lin, L., Si, J., Wang, Q., Peng, X., & Chen, W. (2018). Electrospinning and crosslinking of polyvinyl alcohol/chitosan composite nanofiber for transdermal drug delivery. Advances in Polymer Technology, 37(6), 1917-1928 http://doi.org/10.1002/adv.21850
99 Kumar, L., Verma, S., Joshi, K., Utreja, P., & Sharma, S. (2021). Nanofiber as a novel vehicle for transdermal delivery of therapeutic agents: challenges and opportunities. Future Journal of Pharmaceutical Sciences, 7(1), 175 http://doi. org/10.1186/s43094-021-00324-1 PMid:34056014.
100 Patel, R., Pandya, J., Patel, K., Joshi, H., Parmar, M., Shah, N., & Shah, S. (2025). Revolutionizing transdermal drug delivery: harnessing the power of nanofibers for drug delivery. International Journal of Polymeric Materials, 74(15), 14451467 http://doi.org/10.1080/00914037.2024.2447733
101 Nahar Singh, D. K., Dhakate, S. R., & Gupta, A. (2015). Anti-emetic drug delivery for cancer patients through electrospun composite nanofibers transdermal patch: in vitro study. Advanced Materials Letters, 6(1), 33-39 http://doi.org/10.5185/amlett.2015.5594
102 Gencturk, A., Kahraman, E., Güngör, S., Özhan, G., Özsoy, Y., & Sarac, A. S. (2017). Polyurethane/hydroxypropyl cellulose electrospun nanofiber mats as potential transdermal drug delivery system: characterization studies and in vitro assays. Artificial Cells, Nanomedicine, and Biotechnology, 45(3), 655-664 http:// doi.org/10.3109/21691401.2016.1173047 PMid:27103498.
103 Kataria, K., Gupta, A., Rath, G., Mathur, R. B., & Dhakate, S. R. (2014). In vivo wound healing performance of drugloaded electrospun composite nanofibers transdermal patch. International Journal of Pharmaceutics, 469(1), 102-110 http://doi.org/10.1016/j.ijpharm.2014.04.047 PMid:24751731.
104 Sharma, A., Gupta, A., Rath, G., Goyal, A., Mathur, R. B., & Dhakate, S. R. (2013). Electrospun composite nanofiberbased transmucosal patch for anti-diabetic drug delivery. Journal of Materials Chemistry. B, Materials for Biology and Medicine, 1(27), 3410-3418 http://doi.org/10.1039/c3tb20487a PMid:32260931.
Gusmão, R. S., Maciel, E. M., Frattini, W. C., Medeiros, E. S., Fonseca, F. A. H., & Bianco, H. T. Polímeros, 35(4), e20250039, 2025
Advances and challenges in nanofiber production: techniques and applications in nanotechnology
105 Zhang, Y., Gao, Z., Chao, S., Lu, W., & Zhang, P. (2022). Transdermal delivery of inflammatory factors regulated drugs for rheumatoid arthritis. Drug Delivery, 29(1), 1934-1950 http:// doi.org/10.1080/10717544.2022.2089295 PMid:35757855.
106.Goyal, R., Macri, L. K., Kaplan, H. M., & Kohn, J. (2016). Nanoparticles and nanofibers for topical drug delivery. Journal of Controlled Release, 240, 77-92 http://doi.org/10.1016/j. jconrel.2015.10.049 PMid:26518723.
107 Mehnath, S., Chitra, K., Karthikeyan, K., & Jeyaraj, M. (2020). Localized delivery of active targeting micelles from nanofibers patch for effective breast cancer therapy. International Journal of Pharmaceutics, 584, 119412 http://doi.org/10.1016/j. ijpharm.2020.119412. PMid:32418898.
108 Balaji, A., Vellayappan, M. V., John, A. A., Subramanian, A. P., Jaganathan, S. K., Supriyanto, E., & Razak, S. I. A. (2015). An insight on electrospun-nanofibers-inspired modern drug delivery system in the treatment of deadly cancers. RSC Advances, 5(71), 57984-58004 http://doi.org/10.1039/ C5RA07595E
109 Morad, H., Jahanshahi, M., Akbari, J., Saeedi, M., Gill, P., & Enayatifard, R. (2021). Novel topical and transdermal delivery of colchicine with chitosan-based biocomposite nanofiberous system: Formulation, optimization, characterization, ex vivo skin deposition/permeation, and anti-melanoma evaluation. Materials Chemistry and Physics, 263, 124381 http://doi. org/10.1016/j.matchemphys.2021.124381
110 Zhu, L.-F., Zheng, Y., Fan, J., Yao, Y., Ahmad, Z., & Chang, M.-W. (2019). A novel core-shell nanofiber drug delivery system intended for the synergistic treatment of melanoma. European Journal of Pharmaceutical Sciences, 137, 105002 http://doi.org/10.1016/j.ejps.2019.105002 PMid:31302215.
111 Erickson, A., Chiarelli, P. A., Huang, J., Levengood, S. L., & Zhang, M. (2022). Electrospun nanofibers for 3-D cancer models, diagnostics, and therapy. Nanoscale Horizons, 7(11), 12791298 http://doi.org/10.1039/D2NH00328G PMid:36106417.
112 Wongkaew, N. (2019). Nanofiber-integrated miniaturized systems: an intelligent platform for cancer diagnosis. Analytical and Bioanalytical Chemistry, 411(19), 4251-4264 http://doi. org/10.1007/s00216-019-01589-5 PMid:30706075.
113 Rancan, F., Contardi, M., Jurisch, J., Blume-Peytavi, U., Vogt, A., Bayer, I. S., & Schaudinn, C. (2019). Evaluation of drug delivery and efficacy of ciprofloxacin-loaded povidone foils and nanofiber mats in a wound-infection model based on ex vivo human skin. Pharmaceutics , 11 (10), 527 http://doi.org/10.3390/pharmaceutics11100527. PMid:31614886.
114 Kumbhar, P. R., Kumar, P., Lasure, A., Velayutham, R., & Mandal, D. (2023). An updated landscape on nanotechnologybased drug delivery, immunotherapy, vaccinations, imaging, and biomarker detections for cancers: recent trends and future directions with clinical success. Discover Nano , 18 ( 1 ), 156 http://doi.org/10.1186/s11671-023-03913-6 PMid:38112935.
115.Sasikala, A. R. K., Unnithan, A. R., Yun, Y.-H., Park, C. H., & Kim, C. S. (2016). An implantable smart magnetic nanofiber device for endoscopic hyperthermia treatment and tumor-triggered controlled drug release. Acta Biomaterialia, 31, 122-133 http://doi.org/10.1016/j.actbio.2015.12.015 PMid:26687978.
116 Soares, P. I. P., & Borges, J. P. (2021). Recent advances in magnetic electrospun nanofibers for cancer theranostics application. Progress in Natural Science, 31(6), 835-844. http://doi.org/10.1016/j.pnsc.2021.11.003
117 Li, L., Hao, R., Qin, J., Song, J., Chen, X., Rao, F., Zhai, J., Zhao, Y., Zhang, L., & Xue, J. (2022). Electrospun fibers
control drug delivery for tissue regeneration and cancer therapy. Advanced Fiber Materials , 4 (6), 1375-1413 http://doi.org/10.1007/s42765-022-00198-9
118 Sridhar, R., Lakshminarayanan, R., Madhaiyan, K., Barathi, V. A., Lim, K. H. C., & Ramakrishna, S. (2015). Electrosprayed nanoparticles and electrospun nanofibers based on natural materials: applications in tissue regeneration, drug delivery and pharmaceuticals. Chemical Society Reviews, 44(3), 790-814 http://doi.org/10.1039/C4CS00226A PMid:25408245.
119 Esentürk-Güzel, I., Abdo, L., Yapar, E. A., Esentürk, E., Büyükkayhan, D., & Sindhu, R. K. (2022). An overview of nanofiber applications for development of phytopharmaceuticals. Bezmialem Science, 10(5), 666-673 http://doi.org/10.14235/ bas.galenos.2022.30502
120 Kamble, P., Sadarani, B., Majumdar, A., & Bhullar, S. (2017). Nanofiber based drug delivery systems for skin: A promising therapeutic approach. Journal of Drug Delivery Science and Technology, 41, 124-133 http://doi.org/10.1016/j. jddst.2017.07.003
121 Krysiak, Z. J., & Stachewicz, U. (2023). Electrospun fibers as carriers for topical drug delivery and release in skin bandages and patches for atopic dermatitis treatment. Wiley Interdisciplinary Reviews. Nanomedicine and Nanobiotechnology, 15(1), e1829 http://doi.org/10.1002/wnan.1829 PMid:35817463.
122 Gainza, G., Villullas, S., Pedraz, J. L., Hernandez, R. M., & Igartua, M. (2015). Advances in drug delivery systems (DDSs) to release growth factors for wound healing and skin regeneration. Nanomedicine; Nanotechnology, Biology, and Medicine, 11(6), 1551-1573 http://doi.org/10.1016/j. nano.2015.03.002 PMid:25804415.
123 Jeckson, T. A., Neo, Y. P., Sisinthy, S. P., Foo, J. B., Choudhury, H., & Gorain, B. (2021). Formulation and characterization of deferoxamine nanofiber as potential wound dressing for the treatment of diabetic foot ulcer. Journal of Drug Delivery Science and Technology, 66, 102751 http://doi.org/10.1016/j. jddst.2021.102751
124 Pachuau, L. (2015). Recent developments in novel drug delivery systems for wound healing. Expert Opinion on Drug Delivery, 12(12), 1895-1909 http://doi.org/10.1517/1742524 7.2015.1070143 PMid:26289672.
125 Medina-Cruz, D., Saleh, B., Vernet-Crua, A., Ajo, A., Roy, A. K., & Webster, T. J. (2020). Drug-delivery nanocarriers for skin wound-healing applications. In D. Bagchi, A. Das, & S. Roy (Eds.), Wound healing, tissue repair, and regeneration in diabetes (pp. 439-488). San Diego: Elsevier http://doi. org/10.1016/B978-0-12-816413-6.00022-8
126 Shariatzadeh, F. J., Currie, S., Logsetty, S., Spiwak, R., & Liu, S. (2025). Enhancing wound healing and minimizing scarring: a comprehensive review of nanofiber technology in wound dressings. Progress in Materials Science, 147, 101350 http:// doi.org/10.1016/j.pmatsci.2024.101350
127 Tiwari, R., Tiwari, G., Lahiri, A., Vadivelan, R., & Rai, A. K. (2021). Localized delivery of drugs through medical textiles for treatment of burns: a perspective approach. Advanced Pharmaceutical Bulletin, 11(2), 248-260 http://doi.org/10.34172/ apb.2021.030 PMid:33880346.
Received: May 20, 2025
Revised: June 18, 2025
Accepted: July 01, 2025
Editor-in-Chief: Sebastião V. Canevarolo
Kely Silveira Bonfim1* , Daniella Lury Morgado2 , Renan da Silva Fernandes1 , Adhemar Watanuki Filho1,3 , Fauze Ahmad Aouada1 and Márcia Regina de Moura1
1Grupo de Compósitos e Nanocompósitos Híbridos – GCNH, Departamento de Física e Química, Faculdade de Engenharia de Ilha Solteira – FEIS, Universidade Estadual Paulista “Júlio de Mesquita Filho” –UNESP, Ilha Solteira, SP, Brasil
2Departamento de Química, Universidade Federal de São Carlos – UFSCar, São Carlos, SP, Brasil
3Instituto Federal de São Paulo – IFS, Ilha Solteira, SP, Brasil
*This paper has been partially presented at the 17th Brazilian Polymer Congress, held in Joinville, SC, 29/Oct - 02/Nov/2023.
*kely.s.bonfim@gmail.com
Obstract
This study demonstrates the sustainable production and physicochemical characterization of nanofibers from bacterial cellulose (BC) waste generated during the commercial production of wound dressing films, using TEMPO-mediated oxidation. The produced BC nanofibers (TO-BCNF) were evaluated in terms of yield (82.68%) and water content (98.84%), and characterized by Transmission Electron Microscopy (TEM), Scanning Electron Microscopy (SEM), Fourier-Transform Infrared Spectroscopy (FTIR), X-Ray Diffraction (XRD), and Thermogravimetric Analysis (TGA). TEM revealed nanofibers with an average diameter of 116.07 ± 21.35 nm, while XRD confirmed the preservation of the semi-crystalline structure of BC, with a crystallinity index of 88.15%. TGA indicated thermal stability with degradation onset at 186 °C. The process also preserved the nanofibrillar morphology and the three-dimensional network of BC. This sustainable approach supports the circular bioeconomy by converting industrial waste into functional nanomaterials, offering potential for applications in wound dressings, films, hydrogels, and controlled release systems.
Keywords: bio-based nanomaterials, nanofibrillated cellulose, circular bioeconomy, oxidative functionalization, biopolymer composites.
Data Ovailability: Research data is available upon request from the corresponding author
How to cite: Bonfim, K. S., Morgado, D. L., Fernandes, R. S., Watanuki Filho, A., Aouada, F. A., & Moura, M. R. (2025). Production and physicochemical characterization of TEMPO-oxidized bacterial cellulose nanofibers from industrial waste. Polímeros: Ciência e Tecnologia, 35(4), e20250037 https://doi.org/10.1590/0104-1428.20240129
1. Introduction
In order to mitigate environmental effects and investigate substitutes for synthetic polymers has prompted materials scientists to focus more on finding novel and sustainable materials in recent years. In this context, biopolymers are promising sources for developing of novel materials and applications[1 2]. The most abundant biopolymer on Earth is cellulose (C6H10O5)n, a fundamental component of plant fibers, with an estimated annual production of 7.5 x 1010 tons per year[3,4]. Its linear, unbranched structure results from the condensation polymerization of anhydroglucose units joined by β-1,4 glycosidic bonds[5]. This homopolysaccharide exhibits high chain rigidity, it is insoluble in water, and is highly hygroscopic due to its free hydroxyl groups and hydrogen bonding[6] .
Despite these properties, plant cellulose (PC) contains lignin, hemicellulose, and extractives, which require removal
to obtain pure cellulose for technological applications. Extracting these components presents a significant challenge, given the intensive chemical processes that may compromise the material’s sustainability[7]. Bacterial cellulose (BC), also known as biocellulose, has garnered significant attention from the scientific community due to its unique characteristics compared to PC. BC is biosynthesized by bacteria such as Gluconacetobacter, Rhizobium, Sarcina, Agrobacterium, and Alcaligenes in culture media containing fructose, glucose, sucrose, and xylose. This process results in a highly pure polymer, free from the other components typically found in PC, thus helping to reduce both environmental impacts and purification costs[8]. It must be pointed out that the dimensions and characteristics of the resulting materials are strongly influenced by both the origin of the cellulose and the specific conditions applied during extraction[9].
Bonfim, K. S., Morgado D. L., Fernandes, R. S., Watanuki Filho, A., Aouada, F. A., & Moura, M. R.
BC was first identified in 1886 during the vinegar fermentation[10]. It shares the same chemical composition as PC, but its fiber dimensions and structural organization differ[11] , imparting unique properties: nano-scale fibers, high crystallinity, excellent mechanical and optical properties, flexibility, and the ability to form highly hydrated three-dimensional networks[12]. Due to these, BC has a wide range of including food packaging[13,14], the release of active materials[15,16], wound dressings[17,18], cosmetics[19,20], and electronics[21,22]
The increasing demand for sustainable materials has highlighted cellulose as a promising biopolymer. However, its intrinsic properties, such as limited mechanical strength and thermal resistance, restrict its applicability. Significant efforts have been undertaken to improve the properties of this material and expand its applications in composite synthesis and materials research. Nanostructured cellulose, such as nanofibers and nanocrystals, offers superior performance in advanced systems. Cellulose nanofibers (CNFs) differ markedly from cellulose nanocrystals (CNCs) in both structural features and potential applications. While the former nanomaterial is composed by long, thin fibers with lengths of up to 100 µm and diameters ranging from 3 to 100 nm[23] and the latter are shorter, rod-like particles obtained predominantly via strong acid hydrolysis, characterized by higher crystallinity and lower aspect ratios. CNCs show high crystallinity, aspect ratio, and excellent mechanical strength contribute significantly to the improvement of composite properties[4], notably in biodegradable polymers such as polylactic acid (PLA). For instance, Shi et al.[24] demonstrated that CNC incorporation into PLA substantially enhanced the mechanical performance of the biocomposite, broadening its potential for engineering plastic applications.
The investigation of cellulose nanofibers (CNFs) as a means of generating value from bacterial cellulose waste is supported by the fact that, although CNCs are well-established in the literature, CNFs have unique morphological and physicochemical characteristics that make them a flexible substitute. In particular, studies have increasingly focused on the nanostructures of bacterial cellulose, particularly its nanofibers[25,26]. In addition to their nanoscale dimensions, CNFs display a high surface area and the ability to form a highly porous network, both of which are essential properties for advanced applications in composite materials. Mechanical methods were the first employed in the disintegration of BC for the production of nanofibers. However, these methods have disadvantages, such as high energy consumption and equipment wear, limiting their viability on a large scale[27]
Chemical methods to obtain bacterial cellulose nanofibers (BCNF) include several strategies such as acid hydrolysis, alkali treatment, and oxidation reactions, such as TEMPOoxidation. Acid hydrolysis is a widely employed method to break down cellulose fibers into smaller nanoparticles, while alkali treatment is often used to purify bacterial cellulose by removing any residual non-cellulosic impurities. However, acid hydrolysis lowers the crystallinity of cellulose fibers, affecting their mechanical and structural integrity. Furthermore, it exhibits poor selectivity, affecting both amorphous and crystalline areas. In contrast, alkali treatment successfully cleanses cellulose but does not introduce functional groups such as carboxylates, limiting its use. It may also modify the fiber surface, influencing how it interacts with other chemicals[28]
Alternatively, methods based on 2,2,6,6-tetramethyl1-piperidinyloxyl (TEMPO)-mediated oxidation are wellestablished and widely used to produce bacterial cellulose nanofibers (TO-BCNF), offering advantages over these traditional approaches. In this process, the addition of sodium hypochlorite (NaClO) in the presence of catalytic amounts of TEMPO and sodium bromide (NaBr) at pH 10; facilitates the selective oxidation of the fibers. Specifically, the primary hydroxyl groups located at the C6 carbon of cellulose are first oxidized into aldehyde groups and subsequently converted into carboxylic acids. This chemical modification weakens the hydrogen bonds between fibrils, facilitating their disintegration into nanofibers. Moreover, the introduction of carboxylate groups not only improves the dispersibility of the fibers but also enables selective functionalization, thereby enhancing interactions with other materials[29-31]. These properties make TO-BCNF highly attractive for developing advanced nanocomposites, establishing the TEMPO method as a critical approach in materials chemistry. The literature includes numerous studies on TEMPO-mediated oxidation of bacterial cellulose[23,30-34]. In the field of dressings, BC is available as a form of film with pre-defined dimensions[35] . After the cutting process during commercial production of these dressings, the offcuts are discarded as waste and not reused. Utilizing this waste represents an innovative approach, promoting sustainability and contributing to the circular bioeconomy. Although few studies have explored industrial waste as a source of bacterial cellulose for BCNF production, further investigation is required[32-34,36-42]
Therefore, this study aimed to produce investigate the feasibility of utilizing industrial bacterial cellulose (BC) residues for the preparation of TEMPO-oxidized bacterial cellulose nanofibers (TO-BCNFs), without focusing on the optimization of the oxidation reaction conditions. We hypothesize that residual BC can be efficiently converted into high-quality nanofibers with structural and functional properties comparable to those from commercial BC. This strategy not only decreases the cost of manufacturing, but also improves sustainability by incorporating waste valorisation into nanocellulose production. The TEMPOoxidation process was chosen because of its selectivity, which allows surface functionalization without affecting the crystalline structure, preserving the material’s performance for advanced applications. The main objective was to assess how the selective oxidation of primary hydroxyl groups at the C6 position into carboxylate groups impacts the material’s properties, while preserving its original crystalline structure and nanofibrillar morphology. Therefore, the obtained nanofibers were comprehensively characterized by X-ray diffraction (XRD), Fourier-transform infrared spectroscopy (FTIR), scanning electron microscopy (SEM), transmission electron microscopy (TEM), and thermogravimetric analysis (TGA). This approach not only promotes the valorization of biotechnological waste but also supports the development of advanced polymeric materials with potential applications such as wound dressings, films, hydrogels, and controlled release systems.
2.1 Materials
Polímeros, 35(4), e20250037, 2025
Production and physicochemical characterization of TEMPO-Oxidized bacterial cellulose nanofibers from industrial waste
Bacterial cellulose (BC) scraps, originating from film-cutting operations during the manufacture of commercial dressings Nexfill®, Seven Indústria de Produtos Biotecnológicos Ltda), were generously supplied by the company and used as raw material in this study. 2,2,6,6-Tetramethylpiperidine-1-oxyl - TEMPO (C9H18NO) (CAS 2564-83-2, Sigma-Aldrich), sodium bromide (NaBr) (CAS 7647-15-6, Dinâmica), sodium hypochlorite 11% (NaClO) (CAS 7681-52-9, Dinâmica), sodium hydroxide (NaOH) (CAS 1310-73-2, Cinética) were used as received, without any purification. Deionized water (99% purity and electrical conductivity < 5 um.cm-2 - Reverse Osmosis ORBC-10A BFilters) was used for all experiments.
The oxidation of BC was carried out according to the method described in the literature[8], with some modifications. Briefly, 10 g of BC residues were homogenized and immersed in 1 L of an aqueous solution containing 0.16 g of 2,2,6,6-tetramethylpiperidine 1-oxyl and 1 g of NaBr. The oxidation reaction was initiated by adding NaClO (5.0 mmol.g-1 of dry CB). After the NaClO was fully consumed, the system’s pH was maintained at 10.0 by dropwise adding a 0.5 mol.L-1 NaOH solution. The reaction system was mechanically stirred at 1000 rpm at room temperature for 2 hours. Upon completion of the oxidation, the suspension was sonicated for 10 minutes using a bath ultrasonicator (Unique Ultracleaner 1400), followed by filtration and washing with deionized water until the pH reached equal to 7.0. The remaining solids were subsequently fibrillated using a blender (Power L-22, Mondial) in seven cycles for 2 minutes each. The resulting material, being hereinafter referred to as TEMPO-oxidized bacterial cellulose nanofibers (TO-BCNF), was stored in a glass container under refrigeration for future analysis and applications.
2.3 Evaluation of dry matter yield after oxidation
The yield ( Y ) of TO-BCNF isolation via the TEMPOmediated oxidation method was determined in triplicate based on the literature[43], using Equation 1, where: mf is the mass of TO-BCNF after drying in an oven at 100°C until constant weight; and mi is the dry mass of the BC residue used in the oxidation process.
( ) % 100 mf
2.4 Quantification of water content
The evaluation of water content of the TO-BCNF sample was determined in triplicate following the procedure described in the literature[44], using Equation 2, where: mi is the mass of TO-BCNF in suspension; and mf is the final mass of TO-BCNF after drying in an oven at 100 °C until constant weight.
Nano- and microstructural analyses of BC and TOBCNF samples were performed using scanning (SEM) and transmission (TEM) electron microscopy. Transmission Electron Microscopy (TEM) was used to characterize the morphology and size of the obtained TO-BCNFs. A diluted aqueous slurry containing TO-BCNF was dropped onto ultra-thin carbon-coated copper grids under ambient temperature and humidity. The sample was mounted in the of a TEM (TECNAI G2F20 - FEG) operated at 200 kV. The images were taken in conventional bright-field mode. The nanofiber diameter measurements were analyzed using ImageJ software, and the corresponding histograms were generated with OriginPro 9.
Scanning Electron Microscopy (SEM) was employed to evaluate the morphology and aggregation state of the TO-BCNFs after oxidation. The nanofibers suspension was freeze-dried at -55 ºC for 24 hours to preserve the structural integratiy of the material. The resulting material was mounted on an aluminum stub and coated with a thin layer of gold. Films samples (BC scraps) were used for BC analysis. Imaging was carried out using a scanning electron microscope (ZEISS, EVO/LS15) operated at an accelerating voltage of 10.0 kV.
The insertion of functional groups from TEMPO-mediated oxidation was qualitatively analyzed using attenuated total reflectance Fourier transform infrared spectroscopy (ATRFTIR). BC and TO-BCNF samples, in the form of films, were placed in the sample holder of an Agilent Cary 630 spectrometer and subjected to 128 scans in the 4000 to 650 cm-1 range with a resolution of 4 cm-1 to obtain the spectra.
The crystalline and semi-crystalline structures of the BC and TO-BCNF samples were analyzed using XRD analysis. The samples were placed in a glass sample holder of a Shimadzu-XRD-600 diffractometer with Cuα X-ray source (λ = 0,154 nm, a voltage of 30 kV, a current of 40 mA, an angular range (2θ) from 4° to 60°, and a 2°.min-1 scan rate). The crystallinity index ( CrI ) was determined following the literature[45] using the Segal equation (Equation 3), where: 200 I is the maximum intensity (in arbitrary units) of the peak referring to the plane (200); and am I is the diffraction intensity at 2θ = 18°.
2.5 Electron Microscopy Characterization (SEM/TEM)
TGA analysis was performed using a thermal analyzer (TA Instruments SDT Q600 V20.9 Build 20). Prior to analysis, all samples were previously dried at 80 °C in an oven and subsequently stored in a desiccator. The samples, weighing approximately 8.0 mg and prepared as films, were placed in an aluminum sample holder and heated from room temperature to 800 °C, with a heating of 10 °C.min−1 under dynamic nitrogen atmosphere (100 mL.min−1) Thermogravimetric curves were calculated using TA Instruments Advantage/ Universal Analysis (UA) software.
Bonfim, K. S., Morgado D. L., Fernandes, R. S., Watanuki Filho, A., Aouada, F. A., & Moura, M. R.
The yield of a process is an important metric used to identify losses that may occur during the conversion of a material into a final product. A thorough understanding of these losses is essential for optimizing the process and ensuring its effective implementation[46]. The yield of the BC waste oxidation process to produce TO-BCNF and the water content of the resulting material are presented in Table 1
It can be seen that the oxidation process achieved a high yield, with only a 17.32% loss during the oxidation, sonication, filtration, washing, fibrillation and drying. This result shows that about 82.68% (Table 1) of the original bacterial cellulose mass was recovered as TO-BCNF. The observed mass loss can be attributed to the elimination of low-molecular-weight fractions, soluble byproducts produced during the oxidation reaction, and material losses caused by the nanofibrillation and purification phases. These results are consistent with those reported in the literature for oxidation processes using 5.0 mmol of NaClO, where yields of 89%[46] and 74%[47] were obtained. The result obtained for the yield of the oxidation reaction with TEMPO is satisfactory; however, it should be shown that the chemical reagents used, such as TEMPO and sodium bromide, contribute to the total cost of this type of reaction. In addition, it is worth mentioning that the raw material used in this study is an industrial waste material, thus supporting a more sustainable approach. The high water content of the produced TO-BCNF indicates its strong hydrophilic nature (Table 1). Quantifying the dry mass was essential for accurately determining the material’s solid content, which is critical for
reliable characterization, reproducibility of experimental conditions, and precise control of concentration-dependent properties in subsequent applications.
Figure 1 shows the SEM and TEM images of the BC scraps and TO-BCNF obtained by TEMPO-mediated oxidation. The morphology of the BC nanofibers was assessed using SEM (Figure 1a and b) and TEM images (Figure 1c and d), which revealed a homogeneous threedimensional network structure. The obtained TO-BCNF exhibited the characteristic appearance of long and thin, and tangled fibers, consistent with morphological features commonly reported for bacterial cellulose nanofibers in the literature[31,48-50]. A comparison between the micrographs of BC and TO-BCNF residues, as shown in Figure 1a-d, indicates that TEMPO-mediated oxidation did not alter the overall fibrillar morphology or network integrity of the material. However, the sonication process played a crucial role in promoting better dispersion of the nanofibrils, as the ultrasonic cavitation effect facilitates the breaking of chains in the amorphous regions[31,51]. Moreover, after oxidation, the anhydroglucose units may be cleaved, resulting in is the breakdown of cellulose into smaller nanofibrils[52]
The TO-BCNF produced in this study exhibited an average diameter of 116.07 ± 21.35 nm, within the typical range for nanofibers obtained via TEMPO-mediated oxidation. Song et al.[53] reported TOBCNs with an average diameter of ~80 nm, with such variations attributed to differences in source material, oxidation parameters, post-treatment conditions, and cellulose’s physical state, particularly whether dried or never-dried[54]. Depending on these factors, more intense fibrillation and oxidation may be required to achieve specific morphological features; however, this can also generate fines and structural changes in the nanofibrillar network, potentially compromising its integrity and mechanical performance[55–57]. Notably, the optimal nanofiber diameter

Production and physicochemical characterization of TEMPO-Oxidized bacterial cellulose nanofibers from industrial waste
depends on the intended application, as different fields require distinct specifications for mechanical properties and morphology. Overall, the TO-BCNF obtained here confirms that the adopted oxidation and sonication protocol effectively converted industrial BC residues into nanofibrils with consistent nanoscale features.
Fourier-transform infrared (FTIR) spectra of BC and TO-BCNF samples were acquired in the range of 4000–600 cm−1, as shown in Figure 2. The spectra of both BC and TOBCNF (Figure 2) display characteristic absorption bands associated with the typical cellulose structure. The moderate intensity peak around 3324 cm-1 (Figure 2a) is attributed to O-H bond stretching vibrations, which is observed in both samples[21]. The peaks located at approximately 1160 and 1030 cm-1 (Figure 2c) corresponding to the asymmetric stretching vibrations of C-O-C linkages and the C-O stretching of secondary alcohols, respectively[21]. These peaks remain unchanged after oxidation, indicating that the cellulose polysaccharide backbone is preserved, and no significant degradation or disruption of the glycosidic linkages occurred. According to previous research, TEMPO-mediated oxidation primarily targets the principal hydroxyl groups (C6) while not altering the secondary hydroxyl groups (C2 and C3)[58]. The absorption at 2895 cm-1 (Figure 2a) is related to aliphatic C-H stretching, while the peak at 1370 is associated with C–H bending vibrations of the glucopyranose ring. The band at 1046 cm−1 (Figure 2b) is attributed to C–O stretching vibrations, mainly from C–OH and C–O–C linkages in the cellulose backbone[59]
It must be pointed out that the oxidation process applied to BC can be confirmed by FTIR analysis, primarily based on two key observations: (i) the appearance of a new absorption band at 1600 cm-1 in the TO-BNCF spectrum (Figure 2b), attributed to the asymmetric stretching vibration of carboxylate group (-COO-), which is absent in the BC spectrum, and (ii) the lack of aldehyde-related bands in the 1720 – 1740 cm-1 region, indicating that the aldehyde groups (-CHO) were fully oxidized to carboxylate groups (-COO-). This result indicates that the oxidation of primary hydroxyl groups at C6 occurred,
although the carboxyl groups remain deprotonated under the current conditions. These results provide strong evidence for the selective oxidation of BC[46,60]. Moreover, TEMPOmediated oxidation efficiently introduced carboxylate groups while preserving the nanofibrillar structure, as evidenced by SEM/TEM images and FTIR data, confirming the process’s precision and reliability.
XDR diffraction patterns of BC and TO-BCNF samples are presented in Figure 3, which confirm the semi-crystalline nature of both materials, with two main peaks. In the BC sample, characteristic diffraction peaks appear at 14.50° and 22.72°, corresponding to the (110) and (200) crystallographic planes of cellulose Iα, respectively[60]. These peaks indicate the highly crystalline structure of BC. Following TEMPOmediated oxidation, the TO-BCNF sample maintained a similar diffraction pattern, confirming that the cellulose I polymorph was preserved. However, a slightly shifted to 14.68° and 22.86°, likely due to the introduction of carboxylate groups on the surface of cellulose I crystals, which could lead to subtle modifications in the inter-planar spacing[61]
The crystallinity index (CrI) of the samples was determined (Table 2), showing that both BC and TO-BCNF have a high degree of crystallinity. This result indicates that TEMPOmediated oxidation does not significantly affect the crystalline structure of BC. It is likely that the carboxylate groups were primarily introduced at the surfaces of the crystallites and in the amorphous regions, rather than affecting the crystalline core[52,61,62]. These results clarify that, unlike plant-derived celluloses, which often show increased crystallinity after oxidation due to the removal of non-cellulosic amorphous components, such as lignin and hemicellulose, BC is already highly crystalline and essentially free of such impurities. Therefore, the TEMPO-mediated oxidation acted mainly on the accessible surfaces and amorphous regions without inducing recrystallization or significant reorganization of the crystalline domains. This explains the absence of a crystallinity increase despite the chemical modification[63]

Bonfim, K. S., Morgado D. L., Fernandes, R. S., Watanuki Filho, A., Aouada, F. A., & Moura, M. R.
These XRD data corroborate the FTIR results, indicating that TEMPO-mediated oxidation selectively changed the amorphous areas while leaving the crystalline cellulose domains intact. Notably, the structural properties of TO-BCNF generated from residual BC were equivalent to those frequently described for nanofibers derived from commercial BC, demonstrating the possibility of residual sources as a high-quality alternative.
Thermogravimetric analysis (TGA) was performed to evaluate the thermal stability and degradation profile of BC and TO-BCNF samples. Figure 4 presents the thermogravimetric (TGA, Figure 4a) and derivative thermogravimetric (DTG, Figure 4b) curves of both materials, recorded from room
temperature up to 800 °C. Both samples exhibit typical multistep thermal degradation profiles, although TO-BCNF shows additional complexity due to surface modifications, as shown in Figure 4. The thermal analysis results were crucial for determining the initial (Ti), maximum (Tmax), and final (Tf) degradation temperatures, which are essential for understanding the material’s stability. The mass loss at each stage further provides insight into the structural changes that occur during the heating process. BC exhibited two main stages of weight loss, and TO-BCNF exhibited three main stages (Table 3)

BC and TO-BCNF both exhibited an initial weight loss between 50 and 122 °C for BC and 68 and 116 °C for TOBCNF, attributed to the evaporation of physically adsorbed water, which is a typical feature of hydrophilic cellulose materials[64]. Notably, TO-BCNF showed a slightly higher weight loss in this region compared to BC, reflecting its increased hydrophilicity due to the introduction of carboxylate groups during TEMPO-mediated oxidation. This modification enhances water retention by increasing the number of polar sites available for hydrogen bonding. These results confirm that oxidation not only alters the chemical structure but also significantly impacts the moisture affinity of the material. Although our TO-BCNF sample exhibited a high overall water content (98.84%, Table 1), both materials showed relatively low mass loss in the first thermal event (Table 3). This behavior is consistent with the known effects of cellulose drying. According to previous studies[54,65] drying induces hornification, leading to pore collapse and reduced accessibility to loosely bound water. Consequently, although dried cellulose can retain significant water structurally or through strong interactions, the amount of physically adsorbed water available for evaporation at low temperatures is limited. Therefore, the low water-related mass loss observed by TGA aligns with the structural characteristics of dried cellulose materials.
TO-BCNF demonstrated one additional thermal event compared to BC, emphasizing the oxidation process’s impact on the material’s thermal stability. Like BC, TOBCNF also displayed a peak corresponding to the loss of water in the first stage. However, in the second and third stages, TO-BCNF showed two exothermic peaks, indicating cellulose breakdown following the oxidation process. These

Production and physicochemical characterization of TEMPO-Oxidized bacterial cellulose nanofibers from industrial waste
Table 3. Initial (Ti), Maximum (Tmax), and Final (Tf) temperatures, as well as the Mass Loss (%) for each thermal event of Bacterial Cellulose (BC) and Bacterial Cellulose Nanofibers (TO-BCNF). Samples
findings indicate that the oxidation treatment not only adds carboxylate groups, but also alters the material’s thermal characteristics, making it more prone to deterioration at higher temperatures than native BC. BC begins to degrade thermally at 224 °C, exhibiting a significant mass loss (73%, Table 3), at Tmax at 354 °C, related to cellulose degradation, dehydration and decomposition of glycosidic units[66]. In contrast, TO-BCNF shows its degradation event at a lower temperature of 186°C with a mass loss of 18% and the maximum thermal degradation temperature at 241°C, as shown in Table 3. This result indicates a reduction of 17% in thermal stability compared to BC[67]
This second thermal event for BC concluded at 398 °C, indicating a broad decomposition process typical of cellulosebased materials. In contrast, TO-BCNF shows its second thermal event at a lower temperature of 186 °C with a mass loss of 18% and the maximum thermal degradation temperature at 241 °C, as shown in Table 3. This event concluded at 263 °C, marking the end of the decomposition associated with the more labile amorphous regions of the oxidized nanofibers. The third thermal event of TO-BCNF was characterized by a 37% mass loss, occurring at a Tmax of 312 °C. This event initiated at 263 °C and finalized at 361 °C, corresponding to the progressive breakdown of partially crystalline domains and oxidized residues. This effect can be linked to the inclusion of carboxylate groups by TEMPO-mediated oxidation, which enhances the material’s hydrophilicity while decreasing hydrogen bonding between cellulose strands. As a result, thermal degradation of the amorphous regions takes place at lower temperatures. The reduction in thermal stability is due to the insertion of these functional groups, which improve moisture retention and facilitate decarbonation processes, as reported in the literature. Previous research has shown that the thermal instability of TEMPO-oxidized cellulose is caused predominantly by the presence of thermally unstable anhydroglucuronate units, rather than glycosidic bond breakage or crystalline backbone degradation[68] .
This interpretation is further reinforced by FTIR, XRD, SEM, and TEM results in this study, which collectively confirm the preservation of the polysaccharide backbone, the retention of cellulose I crystalline domains, and the maintenance of the nanofibrillar morphology after oxidation. Consequently, the additional thermal event observed in TOBCNF is attributed to surface functionalization and increased chemical heterogeneity, rather than structural deterioration. The results shown here demonstrate that TEMPO-mediated oxidation lowers the thermal stability of BC, as previously reported in the literature[68,69]. Nonetheless, the TO-BCNF developed in this work has high heat resistance, with early degradation temperatures reaching 186 °C. Other investigations have shown similar results, with heat breakdown of oxidized
BC beginning approximately 170 °C[70]. This suggests that, despite its early degradation onset, TO-BCNF has sufficient thermal resistance for applications requiring moderate stability. Additionally, valorising leftover BC enhances sustainability, offering a greener and more cost-effective alternative for cellulose-based nanomaterial production.
This work demonstrated the feasibility of repurposing industrial bacterial cellulose (BC) residue to generate nanofibers. The results showed that TEMPO-mediated oxidation can be employed as a strategic method aligned with circular bioeconomy principles, promoting both sustainability and industrial waste recovery. Furthermore, the produced bacterial cellulose nanofibers (TO-BCNF) exhibited high crystallinity and good thermal stability. The combination of TEMPO-mediated oxidation and fibrillation enabled the production of nanofibers with reduced diameters and improved dispersibility while preserving the semi-crystalline structure of BC. These properties highlight the potential of TO-BCNF as a high-performance functional material for advanced nanocomposites, with applications in wound dressings, films, hydrogels, and controlled release systems. This work contributes not only to the advancement of new polymeric materials but also to sustainable practices by repurposing bacterial cellulose waste, establishing it as a viable and valuable approach within the framework of the circular economy.
• Conceptualization – Kely Silveira Bonfim; Adhemar Watanuki Filho; Renan da Silva Fernandes; Márcia Regina de Moura.
• Data curation – Kely Silveira Bonfim.
• Formal analysis – Kely Silveira Bonfim; Daniella Lury Morgado.
• Funding acquisition – Márcia Regina de Moura; Fauze Ahmad Aouada.
• Investigation – Kely Silveira Bonfim.
• Methodology – Kely Silveira Bonfim; Adhemar Watanuki Filho; Renan da Silva Fernandes.
• Project administration – Kely Silveira Bonfim; Márcia Regina de Moura.
• Resources – Márcia Regina de Moura; Fauze Ahmad Aouada.
• Software – NA.
Bonfim, K. S., Morgado D. L., Fernandes, R. S., Watanuki Filho, A., Aouada, F. A., & Moura, M. R.
• Supervision – Márcia Regina de Moura; Fauze Ahmad Aouada.
• Validation – Kely Silveira Bonfim; Daniella Lury Morgado.
• Visualization – Kely Silveira Bonfim; Daniella Lury Morgado.
• Writing – original draft – Kely Silveira Bonfim; Adhemar Watanuki Filho; Renan da Silva Fernandes.
• Writing – review & editing – Kely Silveira Bonfim; Daniella Lury Morgado; Márcia Regina de Moura; Fauze Ahmad Aouada.
6. Acknowledgements
This research was funded by São Paulo State University (UNESP). São Paulo Research Foundation (FAPESP) (2019/06170-1; 2013/07296-2 – CEPID), and National Council for Scientific and Technological Development (CNPq) (MRM 408691/2023-9; 315513/2021-7; FAA 316174/2021-1; MCTIC Grant #406973/2022-9 through INCT/Polysaccharides - National Technology-Science Institute for Polysaccharides; and 307622/2023-1). This study was financed in part by the Coordenação de Aperfeiçoamento de Pessoal de Nível Superior - Brazil (CAPES) - “Finance Code 001”, as well as grant numbers 88887.643328/2021-00 and 88887.712628/2022-00.
1 Getahun, M. J., Kassie, B. B., & Alemu, T. S. (2024). Recent advances in biopolymer synthesis, properties, & commercial applications: a review. Process Biochemistry (Barking, London, England), 145, 261-287. http://doi.org/10.1016/j. procbio.2024.06.034
2 Islam, M. R., Rashid, M. N., Dev, B., Sayeed, M. Y., Alam, M. R., Mahmud, R. U., & Rahman, M. Z. (2024). Progress in sustainable applications of polymers and biopolymers. In S. Hashmi (Ed.), Comprehensive materials processing (pp. 523-554). USA: Elsevier. http://doi.org/10.1016/B978-0-323-96020-5.00212-0
3 Suhas, G. V. K., Carrott, P. J. M., Singh, R., Chaudhary, M., & Kushwaha, S. (2016). Cellulose: a review as natural, modified and activated carbon adsorbent. Bioresource Technology, 216, 1066-1076 http://doi.org/10.1016/j.biortech.2016.05.106 PMid:27265088.
4 Salleh, K. M., Selamat, M. E., Nordin, N. A., & Zuo, Q. (2025). Understanding nonwoody cellulose extractions, treatments, and properties for biomedical applications. International Journal of Biological Macromolecules, 308(Pt 3), 142455 http://doi. org/10.1016/j.ijbiomac.2025.142455 PMid:40158602.
5 Channab, B.-E., El Idrissi, A., Essamlali, Y., & Zahouily, M. (2024). Nanocellulose: Structure, modification, biodegradation and applications in agriculture as slow/controlled release fertilizer, superabsorbent, and crop protection: a review. Journal of Environmental Management, 352, 119928 http:// doi.org/10.1016/j.jenvman.2023.119928 PMid:38219662.
6. Chashchilov, D. V. (2024). Regenerated Cellulose. Review. Part 1. Cellulose Structure, Solvent Systems, and Dissolution Mechanisms. Polymer Science, Series D. Glues and Sealing Materials, 17(2), 466-473 http://doi.org/10.1134/ S1995421224700801
7 Islam, M. U., Ullah, M. W., Khan, S., Shah, N., & Park, J. K. (2017). Strategies for cost-effective and enhanced production of bacterial cellulose. International Journal of Biological
Macromolecules, 102, 1166-1173 http://doi.org/10.1016/j. ijbiomac.2017.04.110 PMid:28487196.
8 Viana, R. M., Sá, N. M. S. M., Barros, M. O., Borges, M. F., & Azeredo, H. M. C. (2018). Nanofibrillated bacterial cellulose and pectin edible films added with fruit purees. Carbohydrate Polymers, 196, 27-32. http://doi.org/10.1016/j. carbpol.2018.05.017. PMid:29891296.
9 Jonoobi, M., Oladi, R., Davoudpour, Y., Oksman, K., Dufresne, A., Hamzeh, Y., & Davoodi, R. (2015). Different preparation methods and properties of nanostructured cellulose from various natural resources and residues: a review. Cellulose (London, England), 22(2), 935-969 http://doi.org/10.1007/s10570-015-0551-0
10 Brown, A. J. (1886). XLIII.: on an acetic ferment which forms cellulose. Journal of the Chemical Society Transactions, 49(0), 432-439 http://doi.org/10.1039/CT8864900432
11 Du, R., Zhao, F., Peng, Q., Zhou, Z., & Han, Y. (2018). Production and characterization of bacterial cellulose produced by Gluconacetobacter xylinus isolated from Chinese persimmon vinegar. Carbohydrate Polymers, 194, 200-207. http://doi. org/10.1016/j.carbpol.2018.04.041. PMid:29801830.
12 Pecoraro, É., Manzani, D., Messaddeq, Y., & Ribeiro, S. J. L. (2007). Bacterial cellulose from glucanacetobacter xylinus: preparation, properties and applications. In M. N. Belgacem, & A. Gandini, Monomers, polymers and composites from renewable resources (pp. 369-383). USA: Elsevier https:// www.doi.org/10.1016/B978-0-08-045316-3.00017-X
13 Koreshkov, M., Takatsuna, Y., Bismarck, A., Fritz, I., Reimhult, E., & Zirbs, R. (2024). Sustainable food packaging using modified kombucha-derived bacterial cellulose nanofillers in biodegradable polymers. RSC Sustainability, 2(8), 2367-2376 http://doi.org/10.1039/D4SU00168K
14. Kusuma, A. C., Chou, Y.-C., Hsieh, C.-C., Santoso, S. P., Go, A. W., Lin, H.-T. V., Hsiao, I.-L., & Lin, S.-P. (2024). Agaraltered foaming bacterial cellulose with carvacrol for active food packaging applications. Food Packaging and Shelf Life, 42, 101269 http://doi.org/10.1016/j.fpsl.2024.101269
15 Sukhtezari, S., Almasi, H., Pirsa, S., Zandi, M., & Pirouzifard, M. (2017). Development of bacterial cellulose based slowrelease active films by incorporation of Scrophularia striata Boiss. extract. Carbohydrate Polymers, 156, 340-350 http:// doi.org/10.1016/j.carbpol.2016.09.058 PMid:27842832.
16 Tsai, Y.-H., Yang, Y.-N., Ho, Y.-C., Tsai, M.-L., & Mi, F.-L. (2018). Drug release and antioxidant/antibacterial activities of silymarin-zein nanoparticle/bacterial cellulose nanofiber composite films. Carbohydrate Polymers, 180, 286-296. http:// doi.org/10.1016/j.carbpol.2017.09.100. PMid:29103507.
17 Kumineck, S. R. (2023). Development of bacterial cellulose incorporated with essential oils for wound treatment. Polímeros: Ciência e Tecnologia, 33(4), e20230041 http:// doi.org/10.1590/0104-1428.20230026
18 Meng, S., Borjihan, Q., Xiao, D., Wang, Y., Chen, M., Cheng, C., & Dong, A. (2024). Biosynthesis of positively charged bacterial cellulose hydrogel with antibacterial and anti-inflammatory function for efficient wound healing. International Journal of Biological Macromolecules, 279(Pt 3), 135263 http://doi. org/10.1016/j.ijbiomac.2024.135263 PMid:39244128.
19. Chantereau, G., Sharma, M., Abednejad, A., Vilela, C., Costa, E. M., Veiga, M., Antunes, F., Pintado, M. M., Sèbe, G., Coma, V., Freire, M. G., Freire, C. S. R., & Silvestre, A. J. D. (2020). Bacterial nanocellulose membranes loaded with vitamin B-based ionic liquids for dermal care applications. Journal of Molecular Liquids, 302, 112547 http://doi.org/10.1016/j.molliq.2020.112547
20 Amorim, J. D. P., & Galdino, C. J., Jr., Costa, A. F. S., Nascimento, H., Vinhas, G. M., & Sarubbo, L. A. (2020). BioMask, a polymer blend for treatment and healing of skin
Polímeros, 35(4), e20250037, 2025
Production and physicochemical characterization of TEMPO-Oxidized bacterial cellulose nanofibers from industrial waste
prone to acne. Chemical Engineering Transactions, 79, 205210 https://doi.org/10.3303/CET2079035
21 Zhang, T., Kuang, K., Lu, L., Li, Q., Sun, Y., & Miao, H. (2024). High strength bacterial cellulose/PANa-based hydrogel polyelectrolyte for flexible zinc−air batteries Journal of Energy Storage, 100(Pt B), 113629 https://doi.org/10.1016/j.est.2024.113629
22 Saputra, A. M. A. (2025). Facile synthesis and electrochemical performance of bacterial cellulose/reduced graphene oxide/ NiCo-layered double hydroxide composite film for self-standing supercapacitor electrode. Materials Science for Energy Technologies, 8, 66-81 http://doi.org/10.1016/j.mset.2024.08.001
23 Xu, H., Sanchez-Salvador, J. L., Blanco, A., Balea, A., & Negro, C. (2023). Recycling of TEMPO-mediated oxidation medium and its effect on nanocellulose properties. Carbohydrate Polymers, 319, 121168 http://doi.org/10.1016/j.carbpol.2023.121168 PMid:37567710.
24. Shi , S.-C. , Hsieh , C.-F. , & Rahmadiawan , D. ( 2024 ). Enhancing mechanical properties of polylactic acid through the incorporation of cellulose nanocrystals for engineering plastic applications. Teknomekanik, 7(1), 20-28 http://doi. org/10.24036/teknomekanik.v7i1.30072
25 Adepu, S., Siju, C. R., Kaki, S., Bagannagari, S., Khandelwal, M., & Bharti, V. K. (2024). Review on need for designing sustainable and biodegradable face masks: opportunities for nanofibrous cellulosic filters. International Journal of Biological Macromolecules, 283(Pt 2), 137627 http://doi.org/10.1016/j. ijbiomac.2024.137627 PMid:39547626.
26 Li, W., Yu, J., Li, Q., Wang, H., Liu, X., Li, P., Jiang, X., & Yang, J. (2024). Bacterial cellulose nanofiber reinforced self-healing hydrogel to construct a theranostic platform of antibacterial and enhanced wound healing. International Journal of Biological Macromolecules, 281(Pt 2), 136336 http://doi.org/10.1016/j. ijbiomac.2024.136336 PMid:39370083.
27 Sofiah, A. G. N., Pasupuleti, J., Samykano, M., Kadirgama, K., Koh, S. P., Tiong, S. K., Pandey, A. K., Yaw, C. T., & Natarajan, S. K. (2023). Harnessing Nature’s Ingenuity: a comprehensive exploration of nanocellulose from production to cutting-edge applications in engineering and sciences. Polymers, 15(14), 3044. http://doi.org/10.3390/polym15143044. PMid:37514434.
28 Rostamabadi, H., Bist, Y., Kumar, Y., Yildirim‐Yalcin, M., Ceyhan, T., & Falsafi, S. R. (2024). Cellulose nanofibers, nanocrystals, and bacterial nanocellulose: fabrication, characterization, and their most recent applications. Future Postharvest and Food, 1(1), 5-33 http://doi.org/10.1002/fpf2.12001
29 Nascimento, E. S., Pereira, A. L. S., Barros, M. O., Barroso, M. K. A., Lima, H. L. S., Borges, M. F., Feitosa, J. P. A., Azeredo, H. M. C., & Rosa, M. F. (2019). TEMPO oxidation and high-speed blending as a combined approach to disassemble bacterial cellulose. Cellulose (London, England), 26(4), 22912302. http://doi.org/10.1007/s10570-018-2208-2.
30 Saito, T., Kimura, S., Nishiyama, Y., & Isogai, A. (2007). Cellulose Nanofibers Prepared by TEMPO-Mediated oxidation of native cellulose. Biomacromolecules, 8(8), 2485-2491 http:// doi.org/10.1021/bm0703970 PMid:17630692.
31 Isogai, A., Saito, T., & Fukuzumi, H. (2011). TEMPO-oxidized cellulose nanofibers. Nanoscale, 3(1), 71-85 http://doi. org/10.1039/C0NR00583E. PMid:20957280.
32 Rahmadiawan, D., Abral, H., Azka, M. A., Sapuan, S. M., Admi, R. I., Shi, S.-C., Zainul, R., Azril, A., Zikrii, A., & Mahardika, M. (2024). Enhanced properties of TEMPO-oxidized bacterial cellulose films via eco-friendly non-pressurized hot water vapor treatment for sustainable and smart food packaging. RSC Advances, 14(40), 29624-29635 http://doi.org/10.1039/ D4RA06099G. PMid:39297036.
33 Zhou, S., Peng, H., Zhao, A., Zhang, R., Li, T., Yang, X., & Lin, D. (2024). Synthesis of bacterial cellulose nanofibers/Ag nanoparticles:
structure, characterization and antibacterial activity. International Journal of Biological Macromolecules, 259(Pt 2), 129392 http:// doi.org/10.1016/j.ijbiomac.2024.129392. PMid:38218289.
34 Ono, Y., Horikawa, Y., Takeuchi, M., Funada, R., & Isogai, A. (2024). Distribution of carboxy groups in TEMPO-oxidized cellulose nanofibrils prepared from never-dried Japanese cedar holocellulose, Japanese cedar-callus, and bacterial cellulose. Cellulose (London, England), 31(7), 4231-4245 http://doi. org/10.1007/s10570-024-05863-3
35 Vuelo Pharma. (2024). Membracel – Membrana Regeneradora Porosa. Retrieved in 2024, November 29, from https://www. vuelopharma.com/membracel-porosa/
36 Chen, L., Lou, J., Rong, X., Liu, Z., Ding, Q., Li, X., Jiang, Y., Ji, X., & Han, W. (2023). Super-stretching and high-performance ionic thermoelectric hydrogels based on carboxylated bacterial cellulose coordination for self-powered sensors. Carbohydrate Polymers, 321, 121310 http://doi.org/10.1016/j. carbpol.2023.121310 PMid:37739507.
37. Wang, F., Kim, H.-J., Park, S., Kee, C.-D., Kim, S.-J., & Oh, I.-K. (2016). Bendable and flexible supercapacitor based on polypyrrole-coated bacterial cellulose core-shell composite network. Composites Science and Technology, 128, 33-40 http://doi.org/10.1016/j.compscitech.2016.03.012.
38 Chitbanyong, K., Pisutpiched, S., Khantayanuwong, S., Theeragool, G., & Puangsin, B. (2020). TEMPO-oxidized cellulose nanofibril film from nano-structured bacterial cellulose derived from the recently developed thermotolerant Komagataeibacter xylinus C30 and Komagataeibacter oboediens R37–9 strains. International Journal of Biological Macromolecules, 163, 1908-1914 http:// doi.org/10.1016/j.ijbiomac.2020.09.124 PMid:32976905.
39. Wang, X., Tang, S., Chai, S., Wang, P., Qin, J., Pei, W., Bian, H., Jiang, Q., & Huang, C. (2021). Preparing printable bacterial cellulose based gelatin gel to promote in vivo bone regeneration. Carbohydrate Polymers, 270, 118342 http:// doi.org/10.1016/j.carbpol.2021.118342 PMid:34364595.
40 Wang, K., Hazra, R. S., Ma, Q., Jiang, L., Liu, Z., Zhang, Y., Wang, S., & Han, G. (2022). Multifunctional silk fibroin/ PVA bio-nanocomposite films containing TEMPO-oxidized bacterial cellulose nanofibers and silver nanoparticles. Cellulose (London, England), 29(3), 1647-1666 http://doi.org/10.1007/ s10570-021-04369-6
41 Ono, Y., Takeuchi, M., Kimura, S., Puangsin, B., Wu, C.-N., & Isogai, A. (2022). Structures, molar mass distributions, and morphologies of TEMPO-oxidized bacterial cellulose fibrils. Cellulose (London, England), 29(9), 4977-4992 http://doi. org/10.1007/s10570-022-04617-3
42. Wu, C.-N., Fuh, S.-C., Lin, S.-P., Lin, Y.-Y., Chen, H.-Y., Liu, J.-M., & Cheng, K.-C. (2018). TEMPO-Oxidized Bacterial Cellulose Pellicle with Silver Nanoparticles for Wound Dressing. Biomacromolecules, 19(2), 544-554 http://doi.org/10.1021/ acs.biomac.7b01660 PMid:29334612.
43 Moussa, I., Khiari, R., Moussa, A., Belgacem, M. N., & Mhenni, M. F. (2019). Preparation and characterization of carboxymethyl cellulose with a high degree of substitution from agricultural wastes. Fibers and Polymers, 20(5), 933943. http://doi.org/10.1007/s12221-019-8665-x.
44 Fischer, M. R., Garcia, M. C. F., Nogueira, A. L., Porto, L. M., Schneider, A. L. S., & Pezzin, A. P. T. (2018). Biossíntese e caracterização de nanocelulose bacteriana para engenharia de tecidos. Matéria (Rio de Janeiro), 22(suppl 1), 22 http:// doi.org/10.1590/s1517-707620170005.0270
45 Segal, L., Creely, J. J., Martin, A. E., Jr., & Conrad, C. M. (1959). An empirical method for estimating the degree of crystallinity of native cellulose using the X-Ray Diffractometer. Textile Research Journal , 29 ( 10 ), 786 - 794 http://doi. org/10.1177/004051755902901003
Bonfim, K. S., Morgado D. L., Fernandes, R. S., Watanuki Filho, A., Aouada, F. A., & Moura, M. R.
46 Nascimento, E. S. (2018). Filmes nanocompósitos à base de celulose bacteriana e nanocristais de celulose (Doctoral dissertation). Universidade Federal do Ceará, Fortaleza. Retrieved in 2024, November 29, from https://repositorio.ufc.br/handle/riufc/34774
47 Nunes, T. F. G. (2014). Produção, caracterização e aplicação de nanofibras de celulose (Master’s thesis). Faculdade de Ciências e Tecnologia, Universidade de Coimbra, Portugal. Retrieved in 2024, November 29, from https://hdl.handle.net/10316/30004
48 Liu, Z., Lin, D., Lopez-Sanchez, P., & Yang, X. (2020). Characterizations of bacterial cellulose nanofibers reinforced edible films based on konjac glucomannan. International Journal of Biological Macromolecules, 145, 634-645 http:// doi.org/10.1016/j.ijbiomac.2019.12.109 PMid:31857167.
49 Zhai, X., Lin, D., Liu, D., & Yang, X. (2018). Emulsions stabilized by nanofibers from bacterial cellulose: new potential food-grade Pickering emulsions. Food Research International, 103, 12-20 http://doi.org/10.1016/j.foodres.2017.10.030 PMid:29389597.
50. Chen, Y., Chen, S., Wang, B., Yao, J., & Wang, H. (2017). TEMPO-oxidized bacterial cellulose nanofibers-supported gold nanoparticles with superior catalytic properties. Carbohydrate Polymers, 160, 34-42 http://doi.org/10.1016/j. carbpol.2016.12.020 PMid:28115098.
51 Zanon, C. D. (2016). Produção de nanocompósitos obtenção de nanofibras de celulose de folhas de bananeira via oxidação catalítica (Master’s thesis). Universidade Estadual de Campinas, Campinas https://www.doi.org/10.47749/T/ UNICAMP.2016.971491
52 Li, L., Chen, Y., Yu, T., Wang, N., Wang, C., & Wang, H. (2019). Preparation of polylactic acid/TEMPO-oxidized bacterial cellulose nanocomposites for 3D printing via Pickering emulsion approach. Composites Communications, 16, 162-167 http:// doi.org/10.1016/j.coco.2019.10.004.
53 Song, J. E., Jun, S.-H., Park, S.-G., & Kang, N.-G. (2020). A semi-dissolving microneedle patch incorporating TEMPOoxidized bacterial cellulose nanofibers for enhanced transdermal delivery. Polymers , 12 (9), 1873 http://doi.org/10.3390/ polym12091873 PMid:32825232.
54 Saito, T., Nishiyama, Y., Putaux, J.-L., Vignon, M., & Isogai, A. (2006). Homogeneous suspensions of individualized microfibrils from TEMPO-Catalyzed oxidation of native cellulose. Biomacromolecules, 7(6), 1687-1691 http://doi. org/10.1021/bm060154s PMid:16768384.
55 Levanič, J., Šenk, V. P., Nadrah, P., Poljanšek, I., Oven, P., & Haapala, A. (2020). Analyzing TEMPO-Oxidized cellulose fiber morphology: new insights into optimization of the oxidation process and nanocellulose dispersion quality. ACS Sustainable Chemistry & Engineering, 8(48), 17752-17762 http://doi.org/10.1021/acssuschemeng.0c05989
56 Wang, M., Miao, X., Li, H., & Chen, C. (2021). Effect of length of cellulose nanofibers on mechanical reinforcement of polyvinyl alcohol. Polymers, 14(1), 128 http://doi.org/10.3390/ polym14010128 PMid:35012151.
57 Kafy, A., Kim, H. C., Zhai, L., Kim, J. W., Van Hai, L., Kang, T. J., & Kim, J. (2017). Cellulose long fibers fabricated from cellulose nanofibers and its strong and tough characteristics. Scientific Reports, 7(1), 17683 http://doi.org/10.1038/s41598017-17713-3 PMid:29247191.
58. Jun, S.-H., Park, S.-G., & Kang, N.-G. (2019). One-pot method of synthesizing TEMPO-oxidized bacterial cellulose nanofibers using immobilized TEMPO for skincare applications. Polymers, 11(6), 1044 http://doi.org/10.3390/polym11061044 PMid:31197111.
59 Yang, Y.-N., Lu, K.-Y., Wang, P., Ho, Y.-C., Tsai, M.-L., & Mi, F.-L. (2020). Development of bacterial cellulose/chitin multinanofibers based smart films containing natural active microspheres and nanoparticles formed in situ. Carbohydrate Polymers,
228, 115370 http://doi.org/10.1016/j.carbpol.2019.115370 PMid:31635728.
60 Ye, J., Li, J., Wang, X., Wang, Q., Wang, S., Wang, H., Zhu, H., & Xu, J. (2024). Preparation of bacterial cellulose-based antibacterial membranes with prolonged release of drugs: emphasis on the chemical structure of drugs. Carbohydrate Polymers, 323, 121379 http://doi.org/10.1016/j.carbpol.2023.121379 PMid:37940275.
61 Saito, T., & Isogai, A. (2004). TEMPO-Mediated oxidation of native cellulose. The effect of oxidation conditions on chemical and crystal structures of the water-insoluble fractions. Biomacromolecules, 5(5), 1983-1989 http://doi.org/10.1021/ bm0497769 PMid:15360314.
62 Fu, R., Ren, Y., Fang, K., Sun, Y., Zhang, Z., & Luo, A. (2021). Preparation, Characterization and Biocompatibility of Chitosan/ TEMPO-oxidized bacterial cellulose composite film for potential wound dressing applications. Fibers and Polymers, 22(7), 1790-1799 http://doi.org/10.1007/s12221-021-0854-8
63 Pratama, A. W., Piluharto, B., Mahardika, M., Widiastuti, N., Firmanda, A., & Norrrahim, M. N. F. (2024). Comparative study of oxidized cellulose nanofibrils properties from diverse sources via TEMPO-mediated oxidation. Case Studies in Chemical and Environmental Engineering, 10, 100823 http:// doi.org/10.1016/j.cscee.2024.100823
64 Vasconcelos, N. F., Cunha, A. P., Ricardo, N. M. P. S., Freire, R. S., Vieira, L. A. P., Santa Brígida, A. I., Borges, M. de F., Rosa, M. F., Vieira, R. S., & Andrade, F. K. (2020). Papain immobilization on heterofunctional membrane bacterial cellulose as a potential strategy for the debridement of skin wounds. International Journal of Biological Macromolecules, 165(Pt B), 3065-3077 http://doi. org/10.1016/j.ijbiomac.2020.10.200. PMid:33127544.
65 Spinu, M., Santos, N., Le Moigne, N., & Navard, P. (2011). How does the never-dried state influence the swelling and dissolution of cellulose fibres in aqueous solvent? Cellulose (London, England), 18(2), 247-256 http://doi.org/10.1007/s10570-010-9485-8
66 Gaulke, E., Garcia, M. C. F., Segat, B., Apati, G. P., Schneider, A. L. S., Pezzin, A. P. T., Cesca, K., & Porto, L. M. (2023). Evaluation of potential biomaterials for application in guide bone regeneration from Bacterial nanocellulose/Hydroxyapatite. Polímeros: Ciência e Tecnologia, 33(3), e20230034. http://doi. org/10.1590/0104-1428.20220121
67 Nóvak, I. C., Segat, B., Garcia, M. C. F., Pezzin, A. P. T., & Schneider, A. L. S. (2024). Alternative production of bacterial cellulose by Komagataeibacter hansenii and microbial consortium. Polímeros: Ciência e Tecnologia, 34(2), e20240021 http://doi. org/10.1590/0104-1428.20230080.
68 Fukuzumi, H., Saito, T., Okita, Y., & Isogai, A. (2010). Thermal stabilization of TEMPO-oxidized cellulose. Polymer Degradation & Stability, 95 (9), 1502-1508. http://doi.org/10.1016/j. polymdegradstab.2010.06.015
69 Jayani, T., Sanjeev, B., Marimuthu, S., & Uthandi, S. (2020). Bacterial Cellulose Nano Fiber (BCNF) as carrier support for the immobilization of probiotic, Lactobacillus acidophilus 016. Carbohydrate Polymers, 250, 116965 http://doi.org/10.1016/j. carbpol.2020.116965. PMid:33049863.
70 Wen, Y., Liu, J., Jiang, L., Zhu, Z., He, S., He, S., & Shao, W. (2021). Development of intelligent/active food packaging film based on TEMPO-oxidized bacterial cellulose containing thymol and anthocyanin-rich purple potato extract for shelf life extension of shrimp. Food Packaging and Shelf Life, 29, 100709. http://doi.org/10.1016/j.fpsl.2021.100709.
Received: Feb. 08, 2025
Revised: May 28, 2025
Accepted: Jun. 09, 2025
Associate Editor: César L. Petzhold
Polímeros, 35(4), e20250037, 2025
Larissa Takigava Acrani1* and Antonio José Felix Carvalho1
1Escola de Engenharia de São Carlos, Universidade de São Paulo - USP, São Carlos, SP, Brasil *larissatacrani@gmail.com
Obstract
Hot melt adhesives based on blends of poly (ethylene-co-vinyl acetate), (EVA), and thermoplastic starch modified with citric acid (TPS), compatibilized with polyolefin grafted with maleic anhydride (PO-g-MA) were prepared. The materials were characterized by scanning electron microscopy (SEM) of fragile fractured surface, rotational viscosimeter (Brookfield) and FTIR. SEM showed interfacial failure in non-compatibilized blends and a decrease in the size of TPS dispersed phase as compatibilizer is added. When adding 5 and 7% of the compatibilizer, results from the viscosimeter indicated increase of 85% and 109% in viscosity, respectively. FTIR showed a dislocation in the absorption of hydrogen bands and ester linkages. These results indicated the effectiveness of the polyolefin functionalized. In performance analysis, compatibilized blends with 25% TPS, exhibited greater adhesion compared to standard hot melt adhesive at low application temperature (140°C), which demonstrates great potential for natural materials in adhesive’s industry.
Keywords: adhesion, blends, hot-melt adhesive, thermoplastic starch.
Data Ovailability: Research data is available upon request from the corresponding author.
How to cite: Acrani, L. T., & Carvalho, A. J. F. (2025). EVA hot-melt adhesive with thermoplastic starch blends compatibilized by modified maleic anhydride. Polímeros: Ciência e Tecnologia, 35(4), e20250038. https://doi.org/10.1590/0104-1428.20240105
Adhesives play a crucial role in society with application in a wide range of materials[1 2]. Due to their versatile functionality and multidisciplinary applications, adhesives are utilized across various industries such as wood processing, furniture, construction, aerospace, automotive, electronics, packaging and medical applications[1-5]. Each of these applications has its own unique requirements and specific characteristics.
In recent years, driven by growing environmental awareness and regulations, the entire chemical industry has focused on improve the sustainability of process and products[6]. For adhesives segment, this shift has mostly exhibited in the transition from solvent-based to water-based or 100% solid content adhesives, such as hot melt adhesives[6,7] .
Hot melt adhesives (HMA) were introduced in the market in 1950, and have steadily gained significance, now occupying approximately 15 – 21% of the adhesives segment[8]. This substantial share is attributed to several factors, such as the absence of solvent in their formulation, allowing for application in high-speed machines[9] and their role in addressing environmental concerns regarding volatile organic compounds (VOC) emissions[10]. Even though substantial progress has been made, there still a long way to go in the adhesive industry. Notably, most of their raw materials are derived from petroleum sources, which are in predominantly non-biodegradable and non-recyclable[11]
Given the issue with petroleum feedstock and the associated environmental concerns, studies have been
exploring more sustainable alternatives for raw materials in adhesives. The most intuitive path involves natural renewable polymers that already possess natural adhesion characteristics, such as starch (a polysaccharide) and casein (a protein)[6 10]. Starch serves as the primary source of energy to sustain life and is a great promise for biopolymers, because of its versatility, low cost, and abundance[7,12] In addition, it can be transformed into a thermoplastic material, known as TPS, by processing in the presence of plasticizers such as glycerol under high temperature, pressure, and shear forces[12]
Carvalho et al.[13], developed a thermoplastic starch (TPS) based hot melt adhesive (HMA) with reduced viscosity, achieved through the incorporation of citric acid into the formulation. While the complete biodegradability of such HMAs is highly promising, these materials still present critical limitations for industrial application, particularly regarding water absorption and thermal stability.
To overcome these drawbacks, one promising strategy is blending TPS with synthetic polymers to enhance performance. Among them, poly(ethylene-co-vinyl acetate) (EVA), a widely used polymer in the adhesive industry, has been the focus of numerous studies. TPS/EVA blends have shown encouraging results, such as a 50% reduction in water uptake[14], indicating strong potential for further development[15]. However, these studies have focused on simplified binary systems, such as EVA/TPS blends.
Acrani, L. T., & Carvalho, A. J. F.
In contrast, the present study expands on this by exploring a more complex, multi-component system of an EVA/TPS hot melt adhesive (HMA), incorporating standard HMA components such as waxes and resins, along with polyolefin grafted with maleic anhydride (PO-g-MA) as a compatibilizer.
The blends were characterized by Fourier-transform infrared spectroscopy (FTIR), rotational viscometry, thermal stability analysis, adhesion testing, and scanning electron microscopy (SEM). Despite being less commonly applied to hot melt adhesives, SEM was employed as a complementary technique to investigate morphological aspects related to blend compatibilization.
This study addresses existing gaps in the literature by exploring the application of TPS/EVA blends in more complex hot melt adhesive (HMA) system, incorporating waxes and conventional tackifiers such as rosin ester and hydrocarbon resins. Additionally, it investigates the effects of compatibilization on morphology, viscosity behavior, offering an application-oriented approach to the research of sustainable HMA formulations, highlighting excellent adhesion performance—specially at reduced application temperatures (140 °C)—while also emphasizing the remaining challenges and opportunities for industrial implementation.
2.1 Materials
In this study, regular corn starch with an amylose content of approximately 28% was combined with glycerol, citric acid, and stearic acid. The components of the standard hot melt adhesives are detailed in Table 1. Additionally, the specifications of the substrate for the adhesion tests are provided.
2.2.1 Preparation of thermoplastic starch (TPS)
The TPS composition consisted of 61% starch, 33% glycerol, 5% citric acid, and 1% stearic acid. The mixture of components was stored overnight before processing. The mixture was passed through a sieve and fed into a single-screw extruder with a screw diameter of 16 mm and an L/D ratio of 26. The temperature profile was 110°C, 120°C, and 130°C from feed to die, and the screw speed was set to 74 rpm.
2.2.2 Preparation of hot melt adhesives (F1 and F2)
For the production of hot melt adhesives, a mechanical system digestor was utilized to blend all components. Initially, less viscous materials – wax, resin – were introduced, followed by the addition of the polymers, which is more viscous. Finally, after some homogenization, the antioxidant was added. The operating temperature was maintained at 140°C with a rotor speed of 250 rpm. Two standard formulations of hot melt adhesives were prepared, featuring ingredients as detailed in Table 1. The proportions were: 49% resin, 30% EVA polymer, 20% wax, and 1% antioxidant.
2.2.3 Preparation of the blends
To prepare the blends, the same procedure used to prepare hot melt adhesives was employed, wherein TPS was mixed with the standard hot melt. Taking this into account, the final formulations are presented in Table 2
Even formulations that incorporate only a fraction of renewable raw materials can represent a significant step toward environmental sustainability—particularly when these formulations maintain performance standards without incurring additional costs[6]. The formulated blends explores incorporating 25% thermoplastic starch (TPS), which is a low cost material, in standard industrial formulas of hot melt adhesives.
1. Materials of the formula of citric modified starch-EVA based hot melt adhesive.
Samples
Both formulas
Materials
Polymer: EVA(28% of acetate vinyl content, MFI: 400g/10min), Antioxidant: Primary type F1 and F2
F1: Standard hot melt adhesive with hydrocarbon resin
F2: Standard hot melt adhesive with ester resin
Carton paper for packaging
Resin: Hydrogenated hydrocarbon (C5 Aliphatic)
Wax: Fischer-Tropsch, Compatibilizer: Polyolefin functionalized with maleic anhydride
Resin: Glycerol ester, Wax: Ethene Copolymer EVA Wax
(Acetic Acid Ethyl Ester, with 13% Vinyl Acetate)
Composition: triple-layer coating comprising short and long fiber cellulose, a blend of short and long fiber cellulose with CMTP, and long fiber cellulose enhanced with starch. Grammage 205 to 360 gsm. Cobb value of 40 g H2O/m3
Table 2. Composition of the blends studied, showing thermoplastic starch (TPS), hot melt adhesive (HMA) content and type (F1 or F2 formulation), and the percentage of polyolefin-grafted-maleic anhydride (PO-g-MA) used as compatibilizer (C).
EVA hot-melt adhesive with thermoplastic starch blends compatibilized by modified maleic anhydride
To overcome the pronounced polarity mismatch between thermoplastic starch (TPS) and low-polarity HMA F1 and its blends, the compatibilizer (C), as known as polyolefin-grafted maleic anhydride (PO-g-MA), was incorporated at varying concentrations (5% and 7%). This formulation strategy enables a targeted assessment of the compatibilizing effect of PO-g-MA in systems with intrinsically poor interfacial affinity. Conversely, no compatibilizer was added to the blend with the F2 system, as the higher polarity of the ester-based tackifiers enhance compatibility with TPS through more favorable intermolecular interactions.
The base formulation (TPS/F1) and its modified versions containing 5% and 7% PO-g-MA (TPS/F1/5C and TPS/F1/7C) were extensively characterized using FTIR spectroscopy and viscosity analysis. These techniques were applied exclusively to these formulations due to their high sensitivity in detecting molecular interactions and variations in flow behavior induced by the PO-g-MA compatibilizer. All blend formulations, including TPS/F2, were evaluated by SEM, thermal stability, and adhesion testing to assess performance and compare the morphology of the matrix and dispersed phases.
2.3.1 Thermal stability
Thermal stability were performed according to ASTM D4499 – 17. The samples were placed in a preheated oven set to 150°C and the temperature was monitored and maintained consistently throughout the duration of the test. The samples were then subjected to the specified temperature for a total duration of 3 hours. After the 3-hour heating period, the samples were removed from the oven and allowed to cool to room temperature. The blends were then visually inspected for signs of phase segregation, such as changes in color, texture, and the presence of distinct layers or domains within the samples. Since there was completely phase segregation for all blends the viscosity was measured only before testing.
2.3.2 Scanning Electron Microscopy
For the analysis, the samples were cryogenically fractured using liquid nitrogen, coated with a thin layer of platinum, and examined using an Inspect F-50 scanning electron microscope (SEM). This well-established preparation method for polymeric materials was chosen to overcome the inherent softness and low electrical conductivity of the hot melt adhesives.
2.3.3
The FTIR analysis was performed using a Perkin Elmer Spectrum 3 spectrometer, equipped with an ATR (Attenuated Total Reflectance) module for the measurements. FTIR spectra were recorded in the range of 4000 to 650 cm−1 , with 16 scans per sample.
2.3.4
The viscosity of the blends was measured using a Brookfield viscometer, equipped with spindles 27 and 29. Measurements were taken within the temperature range of 120 to 150 °C, with rotational speeds set at 20, 50, and 100 rpm.
2.3.5
The application of adhesives was performed using a Slautterback Mini Squirt II application gun on a standardized rectangular surface measuring 50 mm x 100 mm. To ensure precise bonding, temperatures of 140 °C for TPS blends and 150 °C for standard hot melt adhesives were carefully maintained. Initially, the adhesive was applied to the internal surface of the carton paper, promoting adherence with the external counterpart. After a brief open time of 1 second, a 100 g weight was applied to the substrate for 3 seconds, effectively characterizing the adhesive’s setting time. Following a 24-hour period to facilitate bond development, the adhered substrates underwent manual separation using a peel force technique to evaluate adhesion performance, focusing on fiber tear of the substrate. The primary objective was to assess the interaction between the adhesive and the substrate, emphasizing bond effectiveness as demonstrated by fiber tear performance rather than solely measuring the force required to separate the samples.
Following the fiber tear classification method described by Robertson et al. (2021), the bonds were pulled apart after the 24-hour period to evaluate the extent of fiber tear. Five bonds were tested for each adhesive, and an average value was calculated. The averages were classified as follows: 81–100% fiber tear = Full fiber tear; 51–80% fiber tear = Partial fiber tear; 21–50% fiber tear = Slight fiber tear; and 0–20% fiber tear = No fiber tear[16]
3.1 Materials characterization
The thermal stability results obtained of the blends are presented in Figure 1
The blends exposed for 3 hours at 150 °C exhibited visible phase separation, as illustrated in Figure 1. This phenomenon may be attributed to the disruption of hydrogen bonding within the blend, as well as the coalescence of the dispersed phase, further exacerbated by the low thermal stability of TPS, which promotes rapid phase differentiation from the matrix. Notably, in Figure 1a, the formulation TPS/F1 displayed the most pronounced phase segregation at 150 °C, with the dispersed TPS phase exhibiting a larger domain size due to polarity mismatch with the matrix, F1, demonstrating coalescence effects. Conversely, the results upon the addition of the compatibilizer in Figure 1b and Figure 1c, led to a significant improvement in phase homogeneity, although some degree of segregation persisted. Furthermore, a similar performance was observed for the blend containing ester resin (TPS/F2), Figure 1d when compared to the compatibilized blends shown in Figures 1b, c
3.1.2
In the TPS/F1 blend (Figure 2a), only the matrix phase of HMA F1 is visible. According to the literature[17,18], the presence of the TPS phase would typically manifest as a failure characterized by a flat and uniform structure due to brittle fracture associated with the amorphous phase.
Acrani, L. T., & Carvalho, A. J. F.
This observation suggests that the failures depicted in Figures 2b-d may be attributed to the dispersed TPS phase within the matrix.
In contrast, the morphology observed in the TPS/F1 blend, at Figure 2a, which did not show the presence of TPS, may result from the macroscopic phase segregation within the mixture, likely due to low compatibility between TPS and HMA F1. The addition of a compatibilizer significantly improved the interfacial interactions between the phases, as demonstrated in the blends TPS/F1/5C ( Figure 2c ) and TPS/F1/7C ( Figure 2d ). In these modified blends, the presence of voids indicates
the detachment of the TPS dispersed phase, which is a result of adhesion failure.
Furthermore, as the proportion of the compatibilizer, functionalized polyolefin increased (PO-g-MA), a corresponding decrease in particle diameter was observed, indicating a reduction in interfacial tension between the phases, as shown in Figure 2c and Figure 2d. These results align with expectations, as the compatibilizer effectively reduces interfacial tension between the components, thereby increasing adhesion energy and stabilizing their morphology[19,20]. Consequently, this leads to a decrease in the particle diameters of the dispersed phases.


EVA hot-melt adhesive with thermoplastic starch blends compatibilized by modified maleic anhydride
The resulting blends with EVA hot-melt adhesive F1, with thermoplastic starch (TPS) are presented in Figure 3 and Figure 4 for the following formulations: (a) TPS/F1, (b)TPS/F1/5C, and (c) TPS/F1/7C. Figure 3a-c provides a comparative overview of the FTIR spectra of the blends against their individual components—namely (d) F1, (e) the compatibilizer PO-g-MA, and (f) TPS. In contrast, Figure 4 offers a more detailed analysis of the absorption bands corresponding to functional groups within the blends, revealing the differences between them and how they result
from the molecular structures of the individual components in Figure 3d-f
The absorption bands observed in Figure 4a-c can be primarily correlated with the spectra of HMA F1 in Figure 3d and TPS in Figure 3f, as they are the major components of the blends. Due to the low concentration of the compatibilizer (PO-g-MA), it is not possible to clearly identify its characteristic absorption bands in Figure 4a–c based on the spectrum shown in Figure 3e. However, its influence on the blend’s properties will be further discussed in Figure 5



of the blends (a) TPS/F1 (b) TPS/F1/5C (c) TPS/F1/7C and their individual components (d) F1 (e) Compatibilizer PO-g-MA (f) TPS in the region between 990 to 1.020 cm-1 highlighting band dislocations.
L. T., & Carvalho, A. J. F.
Characteristic absorptions from the HMA F1 are clearly identified in Figure 4a-c, such as the C–H asymmetric and symmetric stretching vibrations at 2922 and 2850 cm−1 , respectively. Bending vibrations of methylene groups (–CH2–) are also evident at 1465 cm−1. These absorptions can be attributed to multiple constituents of the HMA F1, including hydrogenated hydrocarbon resins, paraffin wax, and EVA copolymer itself. Additionally, ester groups specific to poly(ethylene-co-vinyl acetate) (EVA) are observed at 1735 cm−1 (C=O stretching) and 1235 cm−1 (C–O stretching) [21]
Furthermore, functional groups associated with TPS are also clearly present in Figure 4a-c. A broad and intense O–H stretching vibration appears at 3300 cm−1, along with a weaker band at 1645 cm−1. Notably, the region from 1235 to 650 cm−1 in Figure 3a-c and Figure 4a-c closely resembles that of pure TPS from Figure 3e. In this region, C–O stretching vibrations from the glucopyranose ring are observed at 1077 and 858 cm−1. Additional bands at 1153 and 927 cm−1 are attributed to C–O vibrations associated with α-1,4 glycosidic linkages. A prominent doublet between 1020 and 990 cm−1 is also evident, corresponding to the stretching of C–OH groups[21] .
Figure 5 presents a more detailed analysis of the two most intense absorption bands in the blends, originally assigned to TPS at 1013 cm−1 and 990 cm−1, from Figure 5f, both associated with C–OH stretching vibrations. In the blends, these bands show noticeable dislocations to 1020 and 990 cm−1, respectively. However, for the uncompatibilized blend (TPS/F1) shown in Figure 5a, the second absorption band at 990 cm−1 is nearly absent.
Upon incorporating the compatibilizer PO-g-MA (polyolefin grafted with maleic anhydride) at concentrations of 5% and 7%, the FTIR spectra of the compatibilized blends TPS/F1/5C and TPS/F1/7C show a significant increase in band intensity around 1000 cm−1 at Figure 5b, c, with incrising PO-g-MA concentration. In contrast, this band was barely detectable in the uncompatibilized blend (TPS/F1) in Figure 5a. The enhanced intensity indicates stronger intermolecular interactions, contributing to improved interfacial compatibility and adhesion between the polar TPS and the nonpolar EVA-based HMA matrix of F1. This result supports the role of PO-g-MA as an effective compatibilizer, enhancing molecular affinity and dispersion at the interface.
Furthermore, as shown in Figure 4a-c, the addition of the compatibilizer leads to a significant decrease in the intensity of the hydroxyl stretching vibrations at 3300 and 1645 cm−1 , which becomes more pronounced with increasing amounts of PO-g-MA. This reduction in band intensity may indicate a lower concentration of free hydroxyl groups from TPS, likely due to interactions with the maleic anhydride groups.
This suggests improved incorporation of the dispersed TPS phase into the HMA F1 matrix, highlighting the strong compatibilizing effect of PO-g-MA.
The results of viscosity measurement for the adhesives are presented in Table 3
The sample of thermoplastic starch blended with the standard hot melt containing hydrogenated hydrocarbon resin (TPS/F1) exhibited a viscosity comparable to that of the pure HMA formula (F1). In the evaluation of other blends (TPS/F1/5C, TPS/F1/7C), it was observed that as the proportion of the compatibilizer increased, the viscosity also rose significantly. These findings are consistent with the results from the SEM and FTIR analysis, which demonstrate the compatibilizer’s effectiveness in enhancing compatibilization and reducing surface energy at the interface of the samples. This effect likely facilitates the formation of entanglements, as polymer chain entanglements typically lead to an increase in molar mass and, consequently, an increase in the viscosity of the final polymeric mixture[22]
3.1.5
The blend (TPS/F1) exhibited adhesion failure, resulting in 0% fiber tear, mirroring the performance of the standard HMA F1 formula, as shown in Figure 6a and 6e This inadequate performance can be attributed to several interconnected factors: the application temperature of the standard formula was set at 140 °C, which is lower than the optimal range typically required for strong adhesive bonding, potentially leading to insufficient wettability and coverage; phase segregation within the blend may have occurred due to inadequate compatibility between the TPS and HMA components, resulting in weak regions that contribute to failure; additionally, the challenges of adhering to carton paper substrates—characterized by a smoother surface and lower surface energy compared to corrugated paper—further hinder effective bonding.
In contrast, blends incorporating thermoplastic starch (TPS) and polyolefin functionalized with maleic anhydride (PO-g-MA), as TPS/F1/5C and TPS/F1/7C, demonstrated great adhesion at 140°C, as illustrated in Figure 6b and 6c, with fiber tear exceeding 90%. Furthermore, Figures 6d and 6f showcased excellent performance, achieving 100% fiber tear for both HMA F2 and the blend TPS/F2.
The results of these blends highlight the effectiveness of the formulations in achieving robust adhesion, even at lower application temperatures. The incorporation of polyolefin functionalized with maleic anhydride (PO-g-MA) significantly enhances the adhesive properties by improving compatibilization between the adhesive matrix and the substrate.
EVA hot-melt adhesive with thermoplastic starch blends compatibilized by modified maleic anhydride

This enhanced interaction leads to increased adhesion strength and overall performance, particularly when combined with thermoplastic starch, which also contributes to adhesion enhancement through its cohesive properties.
Furthermore, these formulations demonstrate excellent interaction with the evaluated carton paper, which has starch on its surface. This compatibility is pivotal in explaining the superior performance of blends containing TPS, as it fosters improved bonding at the interface. In summary, the integration of thermoplastic starch and polyolefin functionalized with maleic anhydride not only enhances adhesion performance but also optimizes compatibility with the substrate. This results in superior adhesive properties, particularly at application temperatures as low as 140 °C.
The results demonstrate the significant potential of thermoplastic starch (TPS) as an adhesive at low application temperatures. One promising strategy to enhance the compatibility of TPS with non-polar materials, such as those found in standard hot melt adhesive formulations, is the use of polyolefins functionalized with maleic anhydride (PO-g-MA). The incorporation of PO-g-MA helps reduce phase separation and enhances compatibility between the polyolefin matrix and the dispersed TPS phase, demonstrating a synergistic approach. Beyond its sustainability benefits, TPS also improves adhesive performance, as shown by adhesion tests on carton paper, and delivers superior bonding properties at lower application temperatures.
However, to successfully introduce green adhesives into the market, key advancements are needed, particularly in improving thermal stability, which plays a crucial role in industrial machinability. Additionally, natural polymer blends with ester resins present an intriguing opportunity due to their renewable origin, polar functional groups, and the availability of high-quality variants specially in Brazil, which compatibilization techniques with this resin wasn’t further explored in this article. In conclusion, while TPS-based adhesives, also natural polymers adhesives show considerable promise for adhesion industry, further research is required to address thermal stability, compatibility and processing challenges to unlock their potential in industrial applications.
• Conceptualization – Larissa Takigava Acrani; Antonio José Felix Carvalho.
• Data curation – Larissa Takigava Acrani.
• Formal analysis – Larissa Takigava Acrani, Antonio José Felix Carvalho.
• Funding acquisition – Antonio José Felix Carvalho.
• Investigation – Larissa Takigava Acrani
• Methodology – Larissa Takigava Acrani; Antonio José Felix Carvalho.
• Project administration – Larissa Takigava Acrani.
• Resources – Larissa Takigava Acrani; Antonio José Felix Carvalho.
• Software – NA.
• Supervision – Antonio José Felix Carvalho.
• Validation – Larissa Takigava Acrani.
• Visualization – Larissa Takigava Acrani.
• Writing – original draft – Larissa Takigava Acrani.
• Writing – review & editing – Larissa Takigava Acrani; Antonio José Felix Carvalho.
6. Acknowledgements
The authors would like to acknowledge Research and Development & Application Engineering Department of Henkel Ltda, Jundiaí, SP/Brazil. Antonio J. F. Carvalho is CNPq fellow (Number: 308709/2023-3).
7. References
1 Ma, Y., Kou, Z., Hu, Y., Zhou, J., Bei, Y., Hu, L., Huang, Q., Jia, P., & Zhou, Y. (2023). Research advances in bio-based adhesives. International Journal of Adhesion and Adhesives, 126(4), 103444 http://doi.org/10.1016/j.ijadhadh.2023.103444
2. Pereira, A. B., & Pereira, A. L. (2023). Introductory chapter: the importance of adhesives in the world. In L. Li, A. B. Pereira, & A. L. Pereira (Eds.), Next generation fiber-reinforced composites – New insights IntechOpen http://doi.org/10.5772/ intechopen.108295
3 Arias, A., González-García, S., González-Rodríguez, S., Feijoo, G., & Moreira, M. T. (2020). Cradle-to-gate Life Cycle Assessment of bio-adhesives for the wood panel industry. A comparison with petrochemical alternatives. The Science of the Total Environment, 738, 140357 http://doi.org/10.1016/j. scitotenv.2020.140357 PMid:32806374.
4 Emblem, A., & Hardwidge, M. (2012). Adhesives for packaging. In A. Emblem, & M. Hardwidge (Eds.), Packaging Technology – Fundamentals, materials and processes (pp. 381-394). Sawston: Woodhead Publishing
5 Webster, I., & West, P. J. (2001). Adhesives for medical applications. In S. Dumitriu (Eds.), Polymeric biomaterials, revised and expanded (pp. 717-752). Boca Raton: CRC Press http://doi.org/10.1201/9780203904671.ch26
6 Heinrich, L. A. (2019). Future opportunities for bio-based adhesives – advantages beyond renewability. Green Chemistry, 21(8), 1866-1888 http://doi.org/10.1039/C8GC03746A
7 Frihart, R. C., Hunt, C. G., & Birkeland, M. J. (2013). Soy Proteins as Wood Adhesives. In W. Gutowski, & H. Dodiuk (Eds.), Recent Advances in Adhesion Science and Technology in Honor of Dr. Kash Mittal (pp. 277-291). Boca Raton: CRC Press
8. Khairullin, I. K. (2013). Adhesive-melts-the most dynamically developing area in world production and consumption of adhesives. Polymer Science, Series D. Glues and Sealing Materials, 6(1), 77-81 http://doi.org/10.1134/S1995421213010073
9 Paul, C. W. (2002). Hot melt adhesives. In D. A. Dillard, A. V. Pocius, & M. K. Chaudhury (Eds.), Adhesion science and engineering (pp. 711-757). USA: Elsevier Science B. V.
10 Vineeth, S. K., & Gadhave, R. V. (2020). Sustainable raw materials in hot melt adhesives: a review. Open Journal of Polymer Chemistry, 10(3), 49-65 http://doi.org/10.4236/ ojpchem.2020.103003.
11 Li, W., Bouzidi, L., & Narine, S. S. (2008). Current research and development status and prospect of hot-melt adhesives: a review Industrial & Engineering Chemistry Research, 47(20), 7524-7532 http://doi.org/10.1021/ie800189b
12 Carvalho, A. J. F. (2008). Starch: major sources, properties and applications as thermoplastic materials. In M. N. Belgacem, & A. Gandini (Eds.), Monomers, polymers and composites from renewable resources (pp. 321-342). USA: Elsevier Science http://doi.org/10.1016/B978-0-08-045316-3.00015-6
13 Carvalho, A. J. F. (2010). Processo para a preparação de adesivo aplicado por aquecimento (cola quente ou hot melt) biodegradável a base de amido termoplástico (Patente BR PI 1005124-4 A2). Universidade Federal de São Carlos – UFSCar, Brasil
14 Da Róz, A. L., Ferreira, A. M., Yamaji, F. M., & Carvalho, A. J. F. (2012). Compatible blends of thermoplastic starch and hydrolyzed ethylene-vinyl acetate copolymers. Carbohydrate Polymers, 90(1), 34-40 http://doi.org/10.1016/j.carbpol.2012.04.055 PMid:24751007.
15 Patel , V. (2009 ). Preparation and Characterization Of Biodegradable and Compatible Ethylene Vinyl Acetate (EVA)/ Thermoplastic Starch (TPS) Blend Nanocomposites. Advanced Materials Research, 67, 185-189 http://doi.org/10.4028/www. scientific.net/AMR.67.185
16 Robertson, D., Van Reenen, A. J., Duveskog, H., & Brady, F. (2021). A comparative study of the application-based properties of hot melt adhesives (HMAs) formulated with different waxes. International Journal of Adhesion and Adhesives, 111, 102974 http://doi.org/10.1016/j.ijadhadh.2021.102974
17. Miranda, V. R., & Carvalho, A. J. F. (2011). Blendas compatíveis de amido termoplástico e polietileno de baixa densidade compatibilizadas com ácido cítrico. Polímeros: Ciência e Tecnologia, 21(5), 353-360 https://doi.org/10.1590/S0104-14282011005000067
18 Oliveira, C. F. P. (2022). Obtenção e caracterização de amido termoplástico e de suas misturas com polipropileno (Doctoral dissertation). Escola Politécnica, Universidade de São Paulo, São Paulo.
19 Utracki, L. A. (2022). Compatibilization of polymer blends. Canadian Journal of Chemical Engineering, 80(6), 1008-1016 http://doi.org/10.1002/cjce.5450800601
20 Thumber, C. M. (2015). Compatibilization of polyolefin blends (Doctoral dissertation). University of Minnesota, Minnesota, USA
21 Pavia, D. L., Lampman, G. M., Kriz, G. S., & Vyvyan, J. A (2008). Introduction to spectroscopy Boston: Cengage Learning
22 Bretas, R. E. S., & D’Ávila, M. A. (2006). Reologia de polímeros fundidos. São Carlos: Edufscar.
Received: Jan. 02, 2025
Revised: May 02, 2025
Accepted: Jun. 16, 2025
Editor-in-Chief: Sebastião V. Canevarolo
Marpongahtun1* , Amru Daulay 2 , Putri3 , Aniza Salviana Prayugo4 , Roon Goei5 , Salmiati6
1Department of Chemistry, Faculty of Mathematics and Natural Sciences, Universitas Sumatera Utara, Medan, Indonesia
2Research Center for Mining Technology, National Research and Innovation Agency – BRIN, Lampung Province, Indonesia
3Department of Chemistry, Faculty of Mathematics and Natural Sciences, Graduate School, Universitas Sumatera Utara, Medan, Indonesia
4Department of Chemistry, Faculty of Mathematics and Natural Sciences, Postgraduate School, Universitas Sumatera Utara, Medan, Indonesia
5School of Material Science and Engineering, Nanyang Technological University, Singapore, Singapore
6Department of Environmental Engineering, Universitas Sumatera Utara, Medan, Indonesia
*marpongahtun@usu.ac.id
Obstract
Organic pollutants can be broken down by photocatalysis with the help of carbon dots. Also, it is widely used as a material to stop microorganisms from growing. This study synthesized N-doped carbon dots from cocoa fruit skin as a potential antibacterial. TEM images on N-CDs show the material is dispersed well without forming aggregation. The spacing of the lattice fringe formed is around 0.23 nm, corresponding to graphite’s diffraction. FTIR spectra show adsorption peak difference between CDs and N-CDs is 1118 cm-1, indicating C-N stretching. UV-Vis absorption spectrum shows the formation of a peak at 294 nm, which shows the π-π* transition of sp2, PL QY of N–CDs in a water solution was about 18.25%. It has been seen that N-CDs work very quickly and kill many bacteria compared to CDs. In both CDs, the highest value for the zone of inhibition is 100 µg mL-1 .
Keywords: antibacterial, cocoa fruit skin, nitrogen-doped carbon dots, Theobroma cacao L.
Data Ovailability: All data supporting the findings of this study are available from the corresponding author upon request.
How to cite: Marpongahtun, Daulay, A., Putri, Prayugo, A. S., Goei, R., & Salmiati. (2025). Green synthesis of N-doped carbon dots from cocoa fruit skin as antibacterial. Polímeros: Ciência e Tecnologia, 35(4), e20250040. https://doi.org/10.1590/0104-1428.20250001
1. Introduction
Biomass, a renewable resource, demonstrates advantages in biotechnology processes, corrosion inhibition, and pharmaceutical formulation development. Cocoa fruit skin comes from a plant called Theobroma cacao L., which is a biomass derived from plants in the Malvaceae family. It contains bioactive compounds such as polyphenols, flavonoids, and tannins that may not be present in some types of lignocellulosic biomass[1]. The utilization of cocoa husks is increasingly expanding, including as animal feed[2] and activated carbon nanoparticles for energy storage devices[3]
Zero-dimensional carbon nanoparticles (<10 nm) known as carbon dots (CDs) consist of a core and shell structure[4]. This material is used as an alternative to fluorescent semiconductor quantum dots, metal NPs/metal oxides, and other nanoparticles, due to its biocompatibility, hydrophilicity, low toxicity, and tunable surface functional groups. CDs have been implemented as sensitizers in solar cells, sensors for detection of heavy metals, organics, and
bacteria, and in many other applications[5]. CDs can be made in many ways, such as by acid oxidation[6], laser ablation[7], hydrothermal[8], microwave treatment[9], electrochemical[10], and solvothermal[11]. CDs have been made using green carbon from fruit biomass, vegetables, milk, sugar, and honey[12] Natural carbon sources like plants, roots, leaves, fruits, and waste products are also used to make N-doped carbon dots (N-CDs)[13]. In particular, the N-CDs have improved the quantum yield, and both the amine and carboxyl groups help make the CDs highly stable. Also, CDs are widely used for their healing properties[14]. Microorganisms can be stopped from growing when they are made of carbon. CDs could be used to stop diseases caused by germs and fungi. Also, these studies on bacteria can help make antibacterial antibiotics and ingredients.
Regarding CDs using biomass and by-products, Thariq’s team[15] prepared CDs using figs (Ficus religiosa tree) as raw material through chloroform as solvent. Chloroform
Marpongahtun, Daulay, A., Putri, Prayugo, A. S., Goei, R., & Salmiati
interaction with CDs can alter their properties and ultimately affect their quantum yield[16]. Meng et al.[17] obtained a good water solubility of N-CDs through coke powder and H2SO4 and HNO3 as raw materials and solvents. Using strong oxidizing acids is hazardous for the environment and impurifies the sample mixture[13]. Saravanan et al.[18] created CDs using turmeric leaves as raw material and their potential antibacterial activities. CDs synthesized from natural precursors often exhibit low fluorescence quantum yields. Nitrogen doping can enhance the optical properties of CDs, including increasing fluorescence[19]
It would be good to make biogenic CDs from natural plants and waste materials and study antibacterial properties. This study considered these goals when it chose cocoa fruit skin as the carbon source to make N-CDs. Also, the cocoa fruit skin has many alkaloids, flavonoids, tannins, saponins, and polyphenols. The solvothermal method was used to synthesise CDs from the cocoa fruit skin. This study has also made N-CDs with urea and cocoa fruit skin using the solvothermal method. This study also used N-CDs as antibiotic agents to stop the growth of Staphylococcus aureus and Escherichia coli. Conclude that N-CDs were good at stopping the growth of germs by acting as antibacterial agents.
2. Materials and Methods
2.1 Materials
Cocoa fruit skin was obtained from Batubara Regency, Indonesia. Urea (CO(NH2)2 98wt%), ethanol (C2H6O 99wt%), hydrochloric acid (HCl 37wt%), ferric chloride (FeCl3 97wt%), sodium hydroxide (NaOH 98wt%), ammonia (NH3 25wt%), chloroform (CHCl3 99wt%), magnesium (Mg 99wt%), sulfuric acid (H2SO4 99 wt%), phosphate-buffered saline (PBS pH 7.4), Mayer’s reagent, and Dragendorf reagent were purchased by Sigma-Aldrich. Deionized water (18.2 MΩ/cm) was purchased from CV. Rudang Jaya. Bacteriological agar and yeast extract were obtained from Universitas Sumatera Utara. At the same time, tryptone and sodium chloride were used to prepare Luria broth and agar media for culturing Escherichia coli (gram-negative ATCC 25922) and Staphylococcus aureus (gram-positive ATCC 23235) bacteria were purchased from Sigma-Aldrich. All chemicals were of analytical grade and were used as received without further purification.
2.2
Cocoa pods that have been obtained are washed with deionized water. Then it was dried using an oven at a temperature of 65 °C. The dried cocoa pods were smoothed using a blender until smooth into powder. After getting the cocoa pod skin powder, it was sifted using a 40-mesh sieve. Then the maceration process was carried out with a sample ratio of 1: 10 in 70% ethanol for 72 h with several stirrings and filtered using filter paper.
2.3
A cocoa fruit skin was put into a 25 mL autoclave with a Teflon-lined autoclave and heated at 220 °C for 2 h. After cooling to room temperature, the solution was centrifuged for 20 min at 8000 rpm. The solution was dialyzed for 48 h by changing the water every 4 h. This sample was named CDs.
2.4 Synthesis of N-doped carbon dots
A cocoa fruit skin of 50 mL added with 2 m/v% urea, was mixed while stirring for 10 min at 240 rpm. The resultant solution was put into a 25 mL autoclave with a Teflon-lined autoclave and heated at 220 °C for 2 h. After cooling to room temperature, the solution was centrifuged for 20 min at 8000 rpm. The solution was dialyzed for 48 h by changing the water every 4 h . The filtrate was stored in a dark container. This sample was named N-CDs.
Alkaloid test using procedure: put enough cocoa fruit skin into the Erlenmeyer, then add 10 mL of ammonia and 10 mL of chloroform. Stir for a few minutes. Then 10 mL of 2N HCl was added and shaken, then divided into 3 test tubes, (i) tube 1 was dripped with Bouchardart reagent, (ii) tube 2 was dripped with Mayer’s reagent, and (iii) tube 3 was dripped with Dragendorf reagent. Flavonoid test using procedure: (i) tube 1 was put into a test tube added with 5% FeCl3 and 10% NaOH, (ii) tube 2 was adding of concentrated HCl and Mg powder to the cocoa fruit skin, and (iii) tube 3 adding H2SO4 to the cocoa fruit skin. Saponin test using procedure: the cocoa fruit skin was put into a test tube, added deionized water was, and then shaken for 3 min. Tannin Test using procedure: cocoa fruit skin was put into a test tube and added with 5% of FeCl3. Polyphenol test using procedure: cocoa fruit skin was put into a test tube and added with 5% of FeCl3. The terpenoid test using the procedure: (i) tube 1 was cocoa fruit skin added Liebermann-Burchard reagent, and (ii) tube 1 was cocoa fruit skin added Salkowsky reagent.
High resolution transmission electron microscopy (HRTEM) images were collected using a JEOL-2100 TEM (operated at an accelerating voltage of 200 kV). The fourier-transform infrared spectroscopy (FTIR) spectra were recorded using a PerkinElmer spectrometer in the spectral range of 4000 cm-1 - 700 cm-1 at the ambient temperature. The optical absorption spectra were recorded using a Shimadzu UV-1800 spectrophotometer. Photoluminescence (PL) spectra of the samples were collected using a single-beam PerkinElmer LS45 fluorescence spectrometer. X-ray Diffraction (XRD) analysis was performed on solid-state Carbon Dots (CDs) samples using a Rigaku MiniFlex II instrument. Energy-dipersive X-ray (EDX) spectra were recorded using EDAX TSL system operated at 20 kV accelerating Volatage. Antibacterial studies of Gram-negative and Gram-positive were examined in the biological laboratory at Universitas Sumatera Utara.
3.1 Preparation of N-CDs
Phytochemical analysis was carried out on cocoa fruit skin to ensure whether the cocoa fruit skin content was genuinely pure. Cocoa fruit skin contains alkaloids, flavonoids, tannins, saponins, polyphenols, and others. The results of the phytochemical analysis of cocoa fruit skin can be seen in Figure 1. At alkaloid test (Figure 1a) show
Green synthesis of N-doped carbon dots from cocoa fruit skin as antibacterial
a brown precipitate then it is for tube 1, a yellowish-white precipitate for tube 2, and a brick-red precipitate for tube 3. All the tube tests show positive for alkaloids. The flavonoid test (Figure 1b) shows a green solution for tube 1, an orange solution for tube 2, and a red brick solution for tube 3. All the tube tests show positive for flavonoid. The saponin test (Figure 1c) shows that the foam is formed. It concludes the positive for saponin. The tannin test (Figure 1d) shows that a green solution is formed. It shows that a positive for tannin. The polyphenol test (Figure 1e) shows that a black solution is formed. It shows that a positive for polyphenol. The terpenoid test (Figure 1f), in tube 1, shows a two-phase solution with a yellow color at the bottom and brownish yellow at the top which shows negative for terpenoids. Use the Liebermann-Burchard reagent in the terpenoid test to determine the presence of cholesterol in cocoa fruit skin[20]. The results did not show the presence of cholesterol. Tube 2 shows a red solution which indicates positive terpenoids. The results of screening phytochemical cocoa fruit skin can be seen in Table 1.
In synthesizing CDs and N-CDs, a solvothermal reaction at 220oC is used for carbonization to produce fluorescent CDs. The scheme illustration synthesis N-CDs with the solvothermal method can be seen in Figure 2. The fundamental
difference between hydrothermal and solvothermal is the solution used. Hydrothermal prefers to use H2O solutions, while solvothermal uses solutions other than H2O[21]. The similarities between hydrothermal and solvothermal are using an autoclave to carry out the reaction[22]. The synthesis process yielded 25 mL of purified CDs solution from 2.0 g of cocoa fruit skin powder as the raw material.
Method Result
Alkaloid Maeyer + Bouchardart + Dragendorff +
Flavonoid
H2SO4 +
Mg.HCl +
FeCl3 +
Terpenoid Liebermann-BurchardSalkowsky +
Saponin Aquadest +
Tanin
Polifenol
FeCl3 +
FeCl3 + +: Positive; -: Negative.


Daulay, A., Putri, Prayugo, A. S., Goei, R., & Salmiati
The TEM images and size distribution of CDs and N-CDs can be seen in Figure 3. The TEM images on the CDs (Figure 3a) show that the material is very well dispersed without forming aggregation. In the HR-TEM CDs (Figure 3b), it can see that the dots have formed. The spacing of the lattice fringe formed is around 0.23 nm, corresponding to graphite’s diffraction (100)[23]. It shows that CDs are formed to resemble graphite in structure. The size distribution of CDs (Figure 3e) shows a size range of 2.52 nm. TEM images on N-CDs (Figure 3c) show that the material is dispersed well without forming aggregates. Looking at the HR-TEM N-CDs (Figure 3d), it can see that the dots have formed. The spacing of the lattice fringe formed is around 0.23 nm, corresponding to graphite’s diffraction (100)[24]. It shows that the N-CDs are formed to resemble graphite structures. The size distribution of N-CDs (Figure 3f) shows a size range of 2.58 nm. The addition of elemental N to CDs did increase the particle size, although not significantly[25]. Bai et al.[26] also compared the sizes of CDs and N-CDs, and it was found that adding N to CDs increased the particle size. Das et al.[27] compared the addition of N elements to CDs, and it was found that the more N elements in CDS, the more the particle size would also increase, although not significantly. XRD results revealed a broad and prominent diffraction peak at 2θ = 25.56°[28] , corresponding to the (002) crystal plane of graphite. This indicates the amorphous nature of the N-CDs, characterized by a non-crystalline structure of disordered carbon atoms.
This amorphous structure is attributed to the incorporation of nitrogen and the solvothermal synthesis conditions, both of which disrupt the formation of graphite layers.
FTIR spectra can be seen in Figure 4 to confirm the surface function group for CDs and N-CDs. It is known that there is an adsorption band at 3324 cm-1, which shows O-H on both CDs and N-CDs. The adsorption band at 3324 cm-1 also shows asymmetric N-H stretching on the N-CDs[29]. The peaks of 2944 cm-1 and 2832 cm-1 show C-H stretching vibrations. The adsorption peak at 1654 cm-1 corresponds to C=O, and the adsorption peak at 1013 cm-1 corresponds to C-O. There is adsorption at 1409 cm-1 for the C-C bond. The adsorption peak difference between CDs and N-CDs is 1118 cm-1, indicating C-N stretching[30]. FTIR spectra of N-CDS showed variations of the COOH, OH, and NH2 functional groups. It can provide excellent stability in aqueous solutions[29] .
EDS analysis (Figure 4) confirmed the composition of the sample elements. The results show that the carbon dots (CDs) primarily consist of carbon (C) at 58.51 atomic% and oxygen (O) at 16.29 atomic%, thus validating the successful synthesis of CDs[31]. Trace amounts of sodium (Na) and potassium (K) were also detected, likely contaminants from the glass slide used for analysis. The oxygen content in the synthesised CDs is attributed to the hydroxyl and carbonyl groups present in cocoa skin, the source material. Notably, the absence of nitrogen (N) peaks suggests a low nitrogen concentration in the EDS spectrum.

Green synthesis of N-doped carbon dots from cocoa fruit skin as antibacterial

UV-Vis absorption spectrum can be seen in Figure 5 In UV-Vis adsorption, and it can be seen the formation of curves on the long adsorption edge in the 300-600 nm region. CDs and N-CDs form peaks at 312 nm and 350 nm showing n-π* non-conjugated electron orbitals originating from oxygen bonding groups (C=O) or amino groups that occur in N-CDs[32]. The difference in the UV-Vis spectra of CDs and N-CDs is that the N-CDs show the formation of a peak at 294 nm, which shows the π-π* transition of sp2, which is hybridized carbon core[33]. The exposed to around 350 nm in the UV-Vis absorption spectrum, the well-dispersed CDs and N-CDs showed blue emission, respectively. It shows that the emission depends on the size of the particles and the sp2 carbon framework[34]. It was also shown that the more extensive conjugated system and the higher graphitization of the nitrogen-doped polyaromatic structure were important in lowering the energy bandgap. N–CDs have strong blue emissions that can be seen with the human eye. It is a good candidate for use in various fields, including bioimaging, biomedicine, and chemical sensing.
The PL spectra of CDs and N-CDs that are excited at 350 nm can be seen in Figure 6a. From the graph, it show that N–CDs had a more significant emission than CDs with the same absorption. Figure 6b shows that the highest PL QY of N–CDs in a water solution was about 18.25%. It was better
than the highest fluorescence QY CDs, 8.00%. The QY on CDs is 8.18%. However, when added, urea increased the QY on N-CDs by 18.25% during synthesis. Simões et al.[35] also synthesized N-CDs, and it was found that the QY increased, originally QY CDs by 8%, QY NCDs increased by 12%. Likewise, Wang et al.[36] previously showed that QY CDs were 6.05%, but QY N-CDs were 18.79%. It was shown that urea did not produce emissions when it was made by hydrothermal synthesis on its own. It showed how important it is to use urea as a surface passivating agent and source of nitrogen to improve the PL features of N-CDs.
The selective light spectrum of CDs can be seen in Figure 6c. The excited by light with different excitation values (300-380 nm). The excitation frequency was less than 350 nm, and the emission peaks moved to the blue. Figure 6d shows how the selective light spectrum of N-CDs looks. The excited by light with different excitation values (300-380 nm), comprehensive emission features could be seen, in which the excitation rose to a maximum of 350 nm and then dropped quickly. The excitation frequency was less than 350 nm, and the emission peaks moved to the blue. This excitation dependence/independence emission range was probably caused by the surface state emission from the many reactive oxygen/nitrogen functional groups, which changes the energy bandgap of N–CDs[37]. Also, the selected luminescence excitation wavelength could have been caused by the difference in the size of the sp2 hybridized carbon framework and the amount of nitrogen in the graphitic structure[38]
Marpongahtun, Daulay, A., Putri, Prayugo, A. S., Goei, R., & Salmiati


The CDs and N-CDs carried out an antibacterial test. Streptomycin sulphate was used as a control for the antimicrobial study, and the size of the wells was 6 mm. We used the well-known and easy-to-use Agar-diffusion disk method for antibacterial strains in this method. Gram-positive and Gram-negative bacteria, both used in this study, are two types of these bacteria. Human bacteria like Staphylococcus aureus and Escherichia coli have been used to get CDs, and N-CDs can be seen in Figure 7. It has been
Polímeros, 35(4), e20250040, 2025
Green synthesis of N-doped carbon dots from cocoa fruit skin as antibacterial

Table 2. The zone of inhibition of CDs and N-CDs was involved in gram-positive and gram-negative human pathogens in concentrations of 100 µg. Variant
Gram + Staphylococcus aureus 13.2 ± 0.80
Gram - Escherichia coli
± 0.50
seen that N-CDs work very quickly and kill many bacteria compared to CDs. In both CDs, the highest value for the zone of inhibition is 100 µg mL-1 Table 2 shows the zone of inhibition for gram-negative and gram-positive bacterial species. Different band gaps between the N-CDs due to their ground and excited states reduce the formation of highly reactive oxygen species (ROS) and lessen their ability to kill bacteria in their respective applications[39]. N-CDs do have an advantage as an antibacterial when compared to CDs. Several studies have also concluded that N-CDs have good antibacterial properties. Rajapandi et al.[40] tested antibacterial N-CDs and CDs and showed that N-CDs had a better antibacterial ability. Wen et al.[41] researched N-CDs and added curcumin to increase the antibacterial ability compared to CDs.
N-Doped Carbon Dots From Cocoa Fruit Skin has been successfully synthesized. Phytochemical results in cocoa fruit skin contain alkaloids, flavonoids, terpenoids, saponins, tannins, and polyphenols. TEM images on N-CDs show the material is dispersed well without forming aggregation. The spacing of the lattice fringe formed is around 0.23 nm,
and N-CDs (µg mL-1)
7.3 ± 0.16
± 0.82
± 0.13
± 0.97
corresponding to graphite’s diffraction (100). FTIR spectra show adsorption peak difference between CDs and N-CDs is 1118 cm-1, indicating C-N stretching. UV-Vis absorption spectrum shows the formation of a peak at 294 nm, which shows the π-π* transition of sp2, which is hybridized carbon core. PL QY of N–CDs in a water solution was about 18.25%. The excitation dependence/independence emission range was probably caused by the surface state emission from the many reactive oxygen/nitrogen functional groups, which changes the energy bandgap of N–CDs. Also, the selected luminescence excitation wavelength could have been caused by the difference in the size of the sp2 hybridized carbon framework and the amount of nitrogen in the graphitic structure. It has been seen that N-CDs work very quickly and kill many bacteria compared to CDs. In both CDs, the highest value for the zone of inhibition is 100 µg mL-1
5. Author’s Contribution
• Conceptualization – Marpongahtun; Amru Daulay; Putri; Aniza Salviana Prayugo; Roon Goei, Salmiati.
• Data curation – Marpongahtun; Amru Daulay; Putri; Aniza Salviana Prayugo; Roon Goei, Salmiati.
• Formal analysis – Marpongahtun; Amru Daulay; Putri.
Marpongahtun, Daulay, A., Putri, Prayugo, A. S., Goei, R., & Salmiati
• Funding acquisition – Marpongahtun.
• Investigation – Marpongahtun; Amru Daulay; Putri; Aniza Salviana Prayugo; Roon Goei, Salmiati.
• Methodology – Marpongahtun; Amru Daulay; Putri.
• Project administration – Marpongahtun; Amru Daulay; Putri; Aniza Salviana Prayugo; Roon Goei, Salmiati.
• Resources – Marpongahtun; Amru Daulay; Putri; Roon Goei.
• Software – Marpongahtun; Amru Daulay; Putri.
• Supervision – Marpongahtun; Amru Daulay; Putri; Aniza Salviana Prayugo; Roon Goei, Salmiati.
• Validation – Marpongahtun; Amru Daulay; Putri; Aniza Salviana Prayugo; Roon Goei, Salmiati.
• Visualization – Marpongahtun; Amru Daulay; Putri; Aniza Salviana Prayugo; Roon Goei, Salmiati.
• Writing – original draft – Marpongahtun; Amru Daulay; Putri.
• Writing – review & editing – Marpongahtun; Amru Daulay; Putri; Aniza Salviana Prayugo; Roon Goei, Salmiati.
6. Acknowledgements
The authors acknowledge the support from Universitas Sumatera Utara and the School of Material Science and Engineering and Nanyang Technological University, in conducting material characterization.
7. References
1 Rachmawaty, Mu’nisa, A., Hasri, Pagarra, H., Hartati, & Maulana, Z. (2018). Active compounds extraction of cocoa pod husk (Theobroma cacao L.) and potential as fungicides. Journal of Physics: Conference Series , 1028 , 012013 http://doi.org/10.1088/1742-6596/1028/1/012013
2 Mael, S. H. (2024). Cocoa pod husk meal as a feed ingredient for livestock. Food and Energy Security , 13(5), e70003 http://doi.org/10.1002/fes3.70003.
3 Yuli, Y., & Eka, S., Rakiman, & Yazmendra, R. (2021). Biomass waste of cocoa skin for basic activated carbon as source of eco-friendly energy storage. Journal of Physics: Conference Series, 1788, 012020 http://doi.org/10.1088/17426596/1788/1/012020
4 Liu, J., Li, R., & Yang, B. (2020). Carbon dots: a new type of carbon-based nanomaterial with wide applications. ACS Central Science, 6(12), 2179-2195. http://doi.org/10.1021/ acscentsci.0c01306 PMid:33376780.
5 Zhao, F., Liu, Z., Sui, S., Huang, K., Yang, Y., Chen, Z., & Yin, H. (2023). Surficial amino groups coupling induced concentration-dependent fluorescence and fluorescence quantum yield of nitrogen-doped carbon quantum dots via efficient charge transfer. Spectrochimica Acta. Part A: Molecular and Biomolecular Spectroscopy, 294, 122542 http://doi.org/10.1016/j. saa.2023.122542 PMid:36848858.
6 Desai, M. L., Jha, S., Basu, H., Singhal, R. K., Park, T.-J., & Kailasa, S. K. (2019). Acid oxidation of muskmelon fruit for the fabrication of carbon dots with specific emission colors for recognition of Hg2+ ions and cell imaging. ACS Omega, 4(21), 19332-19340 http://doi.org/10.1021/acsomega.9b02730 PMid:31763557.
7 Chen, Z.-W., Hsieh, T.-H., & Liu, C.-P. (2022). Production of carbon dots by pulsed laser ablation: precursors and photo‐oxidase properties. Journal of the Chinese Chemical Society, 69(1), 193-199 http://doi.org/10.1002/jccs.202100271
8 Pramudita, R., Marpongahtun, Gea, S., Daulay, A., Harahap, M , Tan, Y. Z., Goei, R., & Tok, A. I. Y. (2022). Synthesis of fluorescent citric acid carbon dots composites derived from empty fruit bunches of palm oil tree and its anti-bacterial property. Case Studies in Chemical and Environmental Engineering, 6, 100277 http://doi.org/10.1016/j.cscee.2022.100277
9 . Marpongahtun, S., Siregar, I. P. H., Irham, W. H., & Saragih, S. W. (2023). Improving carbon dots optical properties of molasses using EDTA as a passivation agent with the microwave method. Rasayan Journal of Chemistry, 16(2), 826-832 http://doi.org/10.31788/RJC.2023.1628237
10 Wang, C.-I., Wu, W.-C., Periasamy, A. P., & Chang, H.-T. (2014). Electrochemical synthesis of photoluminescent carbon nanodots from glycine for highly sensitive detection of hemoglobin. Green Chemistry, 16(5), 2509-2514. http://doi.org/10.1039/ c3gc42325e
11 Otten, M., Hildebrandt, M., Kühnemuth, R., & Karg, M. (2022). Pyrolysis and solvothermal synthesis for carbon dots: role of purification and molecular fluorophores. Langmuir, 38(19), 6148-6157 http://doi.org/10.1021/acs.langmuir.2c00508 PMid:35502848.
12 Kurian, M., & Paul, A. (2021). Recent trends in the use of green sources for carbon dot synthesis: a short review. Carbon Trends, 3, 100032 http://doi.org/10.1016/j.cartre.2021.100032
13 Jing, H. H., Bardakci, F., Akgöl, S., Kusat, K., Adnan, M., Alam, M. J., Gupta, R., Sahreen, S., Chen, Y., Gopinath, S. C. B., & Sasidharan, S. (2023). Green carbon dots: Synthesis, characterization, properties and biomedical applications. Journal of Functional Biomaterials, 14(1), 27 http://doi.org/10.3390/ jfb14010027 PMid:36662074.
14. Wang, Y., Wu, R., Zhang, Y., Cheng, S., & Zhang, Y. (2023). High quantum yield nitrogen doped carbon dots for Ag+ sensing and bioimaging. Journal of Molecular Structure, 1283, 135212 http://doi.org/10.1016/j.molstruc.2023.135212
15. Tariq, M., Singh, A., Varshney, N., Samanta, S. K., & Sk, M. P. (2022). Biomass-derived carbon dots as an emergent antibacterial agent. Materials Today. Communications, 33, 104347 http://doi.org/10.1016/j.mtcomm.2022.104347
16. Sato, K., Katakami, R., Iso, Y., & Isobe, T. (2022). Surfacemodified carbon dots with improved photoluminescence quantum yield for color conversion in white-light-emitting diodes. ACS Applied Nano Materials , 5 (6), 7664-7669 http://doi.org/10.1021/acsanm.2c01868
17 Meng, J., Li, S., Ding, L., Zhou, C., Jiang, R., Zhang, Q., Cheng, Z., Gauthier, M., Hu, Y., & Wu, L. (2022). Preparation of nitrogen-doped carbon dots from coke powder as a fluorescent chemosensor for selective and sensitive detection of Cr (VI). Journal of Wuhan University of Technology, Materials Science Edition, 37(6), 1096-1104 http://doi.org/10.1007/s11595-0222639-3
18. Saravanan, A., Maruthapandi, M., Das, P., Luong, J. H. T., & Gedanken, A. (2021). Green synthesis of multifunctional carbon dots with antibacterial activities. Nanomaterials, 11(2), 369 http://doi.org/10.3390/nano11020369 PMid:33540607.
19. Prayugo, A. S., Marpongahtun, Gea, S., Daulay, A., Harahap, M., Siow, J., Goei, R., & Tok, A. I. Y. (2023). Highly fluorescent nitrogen-doped carbon dots derived from jengkol peels (Archidendron pauciflorum) by solvothermal synthesis for sensitive Hg2+ ions detection. Biosensors and Bioelectronics: X, 14, 100363 http://doi.org/10.1016/j.biosx.2023.100363
20 Adu, J. K., Amengor, C. D. K., Kabiri, N., Orman, E., Patamia, S. A. G., & Okrah, B. K. (2019). Validation of a simple and robust Liebermann-Burchard colorimetric method for the assay of cholesterol in selected milk products in Ghana. International Journal of Food Sciences, 2019(1), 9045938 http://doi.org/10.1155/2019/9045938 PMid:31737650.
2025
Green synthesis of N-doped carbon dots from cocoa fruit skin as antibacterial
21 Feng, S.-H., & Li, G.-H. (2017). Hydrothermal and solvothermal syntheses. In R. Xu, & Y. Xu (Eds.), Modern inorganic synthetic chemistry (pp. 73-104). Amsterdam: Elsevier http://doi.org/10.1016/B978-0-444-63591-4.00004-5
22. Monday, Y. N., Abdullah, J., Yusof, N. A., Rashid, S. A., & Shueb, R. H. (2021). Facile hydrothermal and solvothermal synthesis and characterization of nitrogen-doped carbon dots from palm kernel shell precursor. Applied Sciences, 11(4), 1630 http://doi.org/10.3390/app11041630
23. Guo, J., Qin, L., & Wang, D. (2023). Carbon dots preserve strong blue emission in both aqueous and solid states and their application in intracellular temperature sensing and white light-emitting diodes. Journal of Luminescence, 257, 119690. http://doi.org/10.1016/j.jlumin.2023.119690
24 Li, C., Liang, H., Bai, S., Zhu, J., Chen, Z., Yang, G., & Zhu, Y. (2023). Efficient color-tunable room temperature phosphorescence through carbon dot confinement in urea crystals. Journal of Luminescence, 254, 119497 http://doi.org/10.1016/j.jlumin.2022.119497
25 Nguyen, K. G., Baragau, I.-A., Gromicova, R., Nicolaev, A., Thomson, S. A. J., Rennie, A., Power, N. P., Sajjad, M. T., & Kellici, S. (2022). Investigating the effect of N-doping on carbon quantum dots structure, optical properties and metal ion screening. Scientific Reports, 12(1), 13806 http://doi.org/10.1038/ s41598-022-16893-x PMid:35970901.
26 Bai, J., Xiao, N., Wang, Y., Li, H., Liu, C., Xiao, J., Wei, Y , Guo, Z., & Qiu, J. (2021). Coal tar pitch derived nitrogen-doped carbon dots with adjustable particle size for photocatalytic hydrogen generation. Carbon, 174, 750-756 http://doi.org/10.1016/j. carbon.2020.10.088.
27 Das, D., & Dutta, R. K. (2021). N-doped carbon dots synthesized from ethylene glycol and β-alanine for detection of Cr(VI) and 4-nitrophenol via photoluminescence quenching. ACS Applied Nano Materials, 4(4), 3444-3454 http://doi.org/10.1021/ acsanm.0c03329
28 Cai, D., Zhong, X., Xu, L., Xiong, Y., Deng, W., Zou, G., Hou, H , & Ji, X. (2025). Biomass-derived carbon dots: synthesis, modification and application in batteries. Chemical Science, 16(12), 4937-4970 http://doi.org/10.1039/D4SC08659G PMid:40046072.
29 Liu, X., Liu, J., Zheng, B., Yan, L., Dai, J., Zhuang, Z., Du, J., Guo, Y., & Xiao, D. (2017). N-doped carbon dots: green and efficient synthesis on a large scale and their application in fluorescent pH sensing. New Journal of Chemistry, 41(19), 10607-10612 http://doi.org/10.1039/C7NJ01889D
30 Jenab, A., Roghanian, R., Ghorbani, N., Ghaedi, K., & Emtiazi, G. (2020). The efficacy of electrospun PAN/kefiran nanofiber and kefir in mammalian cell culture: promotion of PC12 cell growth, anti-MCF7 breast cancer cells activities, and cytokine production of PBMC. International Journal of Nanomedicine, 15, 717-728 http://doi.org/10.2147/IJN. S232264 PMid:32099360.
31 Mansuriya, B. D., & Altintas, Z. (2021). Carbon dots: classification, properties, synthesis, characterization, and applications in health care: an updated review (2018-2021). Nanomaterials, 11(10), 2525 http://doi.org/10.3390/nano11102525 PMid:34684966.
32 Issa, M. A., Abidin, Z. Z., Sobri, S., Rashid, S., Mahdi, M. A , Ibrahim, N. A., & Pudza, M. Y. (2019). Facile synthesis of nitrogen-doped carbon dots from lignocellulosic waste. Nanomaterials, 9(10), 1500 http://doi.org/10.3390/nano9101500 PMid:31652527.
33 Li, Y., Liu, C., Chen, M., Zheng, Y., Tian, H., Shi, R., He, X., & Lin, X. (2022). Preparing colour-tunable tannic acid-based carbon dots by changing the pH value of the reaction system. Nanomaterials, 12(17), 3062 http://doi.org/10.3390/ nano12173062 PMid:36080100.
34 Li , X. (2021 ). sp 2 carbon-conjugated covalent organic frameworks: Synthesis, properties, and applications. Materials Chemistry Frontiers, 5(7), 2931-2949 http://doi.org/10.1039/ D1QM00015B
35 Simões, E. F. C., Leitão, J. M. M., & Silva, J. C. G. E. (2016). Carbon dots prepared from citric acid and urea as fluorescent probes for hypochlorite and peroxynitrite. Mikrochimica Acta, 183(5), 1769-1777 http://doi.org/10.1007/s00604-016-1807-6
36 Wang, K., Geng, C., Wang, F., Zhao, Y., & Ru, Z. (2021). Urea-doped carbon dots as fluorescent switches for the selective detection of iodide ions and their mechanistic study. RSC Advances, 11(44), 27645-27652 http://doi.org/10.1039/ D1RA04558J PMid:35480658.
37. Olla, C., Cappai, A., Porcu, S., Stagi, L., Fantauzzi, M., Casula, M. F , Mocci, F., Corpino, R., Chiriu, D., Ricci, P. C., & Carbonaro, C. M. (2023). Exploring the impact of nitrogen doping on the optical properties of carbon dots synthesized from citric acid. Nanomaterials, 13(8), 1344 http://doi.org/10.3390/ nano13081344. PMid:37110929.
38 Ray, P., Moitra, P., & Pan, D. (2022). Emerging theranostic applications of carbon dots and its variants. View, 3(2), 20200089 http://doi.org/10.1002/VIW.20200089
39 Quan, L., Jiang, W., Li, H., Li, H., Wang, Q., & Chen, L. (2022). Intelligent intra-row robotic weeding system combining deep learning technology with a targeted weeding mode. Biosystems Engineering, 216, 13-31 http://doi.org/10.1016/j. biosystemseng.2022.01.019.
40 Rajapandi, S., Pandeeswaran, M., & Kousalya, G. N. (2022). Novel green synthesis of N-doped carbon dots from fruits of Opuntia ficus-indica as an effective catalyst for the photocatalytic degradation of methyl orange dye and antibacterial studies. Inorganic Chemistry Communications, 146, 110041 http://doi.org/10.1016/j.inoche.2022.110041
41 Wen, F., Li, P., Meng, H., Yan, H., Huang, X., Cui, H., & Su, W. (2022). Nitrogen-doped carbon dots/curcumin nanocomposite for combined photodynamic/photothermal dual-mode antibacterial therapy. Photodiagnosis and Photodynamic Therapy, 39, 103033 http://doi.org/10.1016/j.pdpdt.2022.103033 PMid:35905831.
Received: Feb. 19, 2025
Revised: June 05, 2025
Accepted: June 11, 2025
Associate Editor: Sebastião V. Canevarolo
Tamam Mahdi Salih1* and Wafaa Mahdi Salih2
1Chemistry Lab, Ibn Sina University of Medical and Pharmaceucal Sciences, Baghdad, Iraq
2Inspection and Characterization of Materials Lab, Materials Engineering Department, University of Technology, Baghdad, Iraq
*tamam.alnaser@ibnsina.edu.iq
Obstract
The accumulation of plastic waste, especially polyethylene terephthalate (PET), is a major environmental concern. This research focuses on the use of recycled polyethylene terephthalate (r-PET) as a building material in concrete, and studies the improvement of its properties by reinforcing it with natural and synthetic fibers. The effect of adding hemp fibers on the mechanical and physical properties of PET composites was investigated. Results after curing each sample for 7, 14, and 28 days showed that reinforcing r-PET with fibers significantly increased compressive strength, flexural strength, and density, making it a suitable option as a complement or partial replacement for conventional concrete. Furthermore, the use of hemp fibers, as a renewable and biodegradable resource, enhances the sustainability of the resulting materials. It contributes to the production of high-performance, environmentally friendly building materials, reduces plastic waste, supports the economy, and can be applied in semi-structural concrete to promote sustainable construction techniques.
Keywords: building materials, cement concrete, polyethylene terephthalate (PET), hemp fiber, recycling.
Data Ovailability: Research data is available upon request from the corresponding author.
How to cite: Salih, T. M., & Salih, W. M. (2025). Improving the properties of recycled Polyethylene terephthalate (PET) reinforced with different fibers. Polímeros: Ciência e Tecnologia, 35(4), e20250041. https://orcid.org/10.1590/01041428.20240088
The relentless accumulation of plastic waste, coupled with the absence of effective disposal methods, has precipitated a critical and unprecedented crisis. This crisis manifests as plastic waste choking our water resources and waterways, overwhelming landfills, seeping into the soil, and dispersing through the air, thereby contaminating every natural facet of our environment. Despite the longevity that makes plastic a durable material, it becomes a detriment to safe disposal, as plastic never truly degrades but instead breaks down into smaller fragments over centuries. According to a report from the United Nations Environment Programme, a staggering 300 million tonnes of plastic waste is generated globally each year, with a meager 9% being recycled. UNEP’s executive director, Inger Andersen, grimly projects a future scenario where approximately a billion metric tons of plastic will occupy our landfills by 2050. This alarming forecast underscores the urgent need for a paradigm shift in our approach to plastic waste managemen[1]. There are many factors that contribute to the growth of plastic waste in the environment, such as the way it affects aquatic organisms[2,3]. The use of plastic waste in construction applications, such as building mixtures, has recently received a great deal of attention in a lot of modern studies[4]. As a result of waste plastics’ organic and inorganic contents, these investigations revealed challenges in recycling[5]. There is significant
potential in using plastic waste as a raw material in concrete[6] To accomplish this, plastic waste can be ground into a fine powder or mixed into different-sized granules[7]. In addition to reducing plastic waste, this method makes sustainable construction materials[8].
In conventional concrete, 12% cement is used along with 80% sand and gravel, requiring an abundance of natural resources to produce[9]. A brick or concrete block produced using this mixture will have a great deal of weight, and it will not be suitable for most uses.
As sustainable manufacturing processes become more popular, they include recycling, non-traditional methods, and reutilization of waste to create new materials. As sustainability goals are being strived for, the use of non-traditional brick production methods, such as repurposing industrial waste, has gained momentum in recent years. This creative approach to brick production has been explored in several studies. Among the potential alternatives is plastic waste, which is considered to be one of the greatest substantial solid non-degradable contaminants[10]. Recyclable polyethylene terephthalate (PET) enhances water conservation, reduces environmental impact, and promotes a circular economy by enabling the production of new items, such as construction and automobiles, from used polyethylene products[8]
Salih, T. M., & Salih, W. M.
Building materials such as concrete are widely used around the world. Although it is heavy, it does not absorb much energy, and it has low ductility and poor tensile strength. For these attributes, civil engineers have been using conventional strengthening to increase concrete’s tensile strength and ductility[11]. A cement composite is typically used in architecture because of its numerous benefits, including close availability, superior compressive strength, good stiffness, and sturdiness[12]. However, the low tensile strength of these composites makes them prone to cracking impairment, forming structural perils in practice[13]. Thus, fibers are commonly utilized to strengthen cement matrices to prevent cracks from forming and propagating[14,15]. The use of a variety of fibers in cement matrices has been reported, comprising basalt fibers[12,16], glass fibers[17], carbon fibers[18,19], graphene fibers[20], steel fibers[21], plastic fibers[22–24], and natural fibers[25,26]. The sustainability and environmental friendliness of natural fibers such as coconut fibers[27] and flax fibers[28] make them competitive alternatives to other types. Plants of the hemp family are perfectly suitable in a wide range of soil and environmental circumstances, making them grow in many locations throughout the world. The plantations of hemp has been developed extensively in Europe, producing high-quality industrial fiber crops[29,30]. Europe’s hemp cultivation area had expanded to 33020 ha in 2022, reference to European agriculture and rural development[31]. A total of 179020 tonnes of hemp were produced in the meantime. Thus, Hemp fiber (HF), which is extracted from the stem of the Cannabis Sativa plant, therefore has a greater rate of production. Additionally, HF exhibits relatively good mechanical strength and stiffness[32]. Thus, the vast use of HF in cement composites may substantially improve the composite’s ductile strength. Because HF is renewable, affordable, and biodegradable, it additionally endorses the objectives of the creation of green and long-lasting cement composites. The effects of HF on improving cement composites conduct, including pastes and mortars, have been demonstrated in previous studies as Li et al.[33]
To protect the environment, researchers have modified cement mixtures with recycled plastic bottle waste to make them environmentally friendly. In the next section, some of the research being conducted on using this environmentally friendly material in different applications was discussed.
Fahad Amin et al.[34], stated that the Coronavirus (COVID-19) pandemic has an environmental threat as well as its global health. This study intends to investigate an inventive approach to handle the concern of the extra waste produced due to the epidemic. Particularly, the investigation aims to explore the use of recycled concrete aggregate (RCA) and silica fume (SFM) in civil constructions using discarded face masks. The ear loops and nose strips were taken off the disposable face masks, and they were then chopped into tiny fibers that have a length of 20 mm, width of 5 mm, and thickness of 0.46 mm, giving a 24 aspect ratio. The concrete mix was formulated with different ratios of SFM and RCA, with a concentration on assessing its durability, compressive strength, and split tensile strength. Results revealed that as a result of adding SFM, both compressive and split tensile strength improved, but durability did not improve significantly.
Gonzalez Laria et al.[35], researched the development of a new technology for the production of a new CM based on two types of recycled plastic (PE/PET) with high availability. The proposed procedure is easy to apply and requires low cost. The main physical and mechanical properties were studied. Components manufactured with this plastic compound comply with non-structural materials regulations based on CIRSOC standards.
Mishra[11] endeavored to reduce trash and reduce the negative ecological effects due to growing economic and industrial expansion. A summary of the experimental exertions on the usage of PET in the construction of roads and cement concrete is provided in this study. Investigations show that adding waste PET to cement and bituminous concrete mixes improved several of the mixture’s features and lowered expenses. PET can be utilized as a building material to reduce the use of new polymeric materials that have negative environmental impacts.
This study intends to employ reclaimed PET bottles to make amended cement building mixes. These changed mixtures should be enhanced concerning durability, permeability, drainage, abrasion, and stability. The importance of using damaged materials and making use of them, as well as connecting them with natural fibers to resist heat and flames.
2.1
PET is thermoplastic in origin, it is likewise termed as “polyester,” which is frequently confused owing to polyester resins being thermosetting materials. Despite its transparency, PET has good mechanical properties and good dimensional stability when subjected to varying loads. PET is also a proper gas barricade and chemically resistant material. PET’s aforementioned properties have led to its use in electrical components, bottles, and thermally stabilized films (e.g. recording tapes, film bases, graphics, capacitors, etc.). Textile fibers can also be produced using PET, which has many uses in the industry. PET is a thermoplastic that has superior physical characteristics. The PET market consumes around 30% of the global PET demand, which constitutes 18% of the entire polymers yielded globally. Above 60% of its production goes into manufactured fibers and bottles. Table 1 presents an overview of the key attributes associated with PET plastics.rPET powder was manufactured through the following sequential procedures: PET water bottles were subjected to a cleaning and drying process. In this experiment, the bottle underwent a shredding process and was then turned into a powder using an industrial stainless steel grinder. Figure 1 depicts the above method.
Improving the properties of recycled Polyethylene terephthalate (PET) reinforced with different fibers
The mortar mixtures used ordinary Portland cement CEM I 52.5 R in combination with standard sand according to UNE-EN 1961[37]. As shown in Table 2, hemp fibers with a 5 mm length, their geometry characteristics, and their composition are described.
Based on Table 3’s mixing ratios, different mixtures were made using resistant cement. Sand; The proportions of components in the first sample were (cement, sand, water / 1, 0.5, 0.5) and all materials were mixed according to ASTM C305 practice[39]. Then different percentages of recycled polyethylene terephthalate (rPET/0.01, 0.02, 0.03) were added. Fixed proportions of hemp fiber (0.01) were
added. Manual mixing was performed until a homogeneous mixture was obtained. As a side note, each mixture of PET pellets was made separately to ensure its precise proportion and weight. Produced bricks are made uniformly composed and have mechanical properties through detailed preparation of raw materials.
2.3
In the present section, Tables 4, 5 and 6 provide the number and characteristics of the specimens made. The manufactured specimens are categorized into three classes of compressive specimens as per ASTM C39[40]. Flexural and standard specimens according to ASTM D790-03[41]. Standard and bulk density specimens according to ASTM C567[42].


2.3.1 Flexural
In order to determine the flexural strength of the plastic bricks, ASTM D790-03 was followed. Figure 2 illustrates how the test was conducted using a universal inspecting machine with a 100 kNA loading capacity. The test was conducted when specimens were placed on two support points 120 mm apart and loaded at 0.05 mm/min until failure was reached by exerting a load at its center. The strength of flexion was computed using the typical equation after the maximum load that the specimen underwent was registered. The average value was reported.
2.3.2 Compression test
The plastic bricks were tested for compression strength using a compression testing machine to comply with ASTM C39. The testing machine’s lower plate was filled with bricks, which were compressed until failure happened. Located at Resistance Lab of the University of the Materials Engineering Department University of Technology - Iraq. As per ASTM standards, the loading rate was kept at 3.5 MPa/min. To conduct the test samples were reserved under standard laboratory conditions at room temperature before testing. Tests were performed on moist cured specimens after 7, 14, and 28 days. Plastic bricks were evaluated for their suitability for construction applications according to the compression test results.
2.3.3
It is a property of a material that expresses how much matter it contains compared to its volume. Different materials have different densities based on their compactness.
6. The bulk density of concrete with and without rPET and hemp.
Often, true and apparent density are calculated by dividing a material’s mass by its volume, and these can be expressed mathematically as follows:
where m = material mass, V = materials’ bulk volume, true volume, or apparent volume, ƿ = true, apparent or bulk density of the material[43] testing of bulk density and moist density for different concrete mixes according to ASTM C567[42]
3.1 Flexural test
Out of all the tests conducted on concrete, the most crucial one that provides insight into all of its properties is the flexural strength test. This one test allows one to determine if concreting was done correctly or not. Molds with dimensions of 40 mm x 40 mm x 160 mm are frequently used for concrete testing.
Improving the properties of recycled Polyethylene terephthalate (PET) reinforced with different fibers
The table below shows the results of all specimens evaluated for flexural strength. The average results of the flexural strength test, which was performed at 7 and 28 days of age, are shown in Table 4 and Figure 3. Flexural strength varies depending on the fiber mix ratio. The results show that the flexural strength of conventional concrete reaches its peak after 7 days, but the flexural strength of concrete made with mix (0.03 PET+ 0.01 fiber) reaches its peak at 28 days. It has been found that adding 0.01 fiber to concrete increases its flexural strength compared to normal concrete throughout the course of a 28-day test.
The increase in flexural strength of the samples relative to the control sample can be explained by the fact that rPET granules are less elastic than the coarse blocks and the modulus of elasticity decreases with increasing proportion of recycled PET granules in the mix. The results can also be related to the percentage of rPET replacement concerning the total weight of concrete along with the different gradations, shapes, and sizes of rPET particles[44]. It was observed that the hemp fiber reinforced concrete shows an increasing trend in flexural strength as in specimens (2, 3, 4, and 5). This may be because at this ratio of 0.01, the fibers may interlock tightly with the rPET and the rest of the mixture resulting in a concrete mass with fewer voids and this is responsible for the higher strength characteristics[45]
Table 5 and Figure 4 present the results of the compressive strength for the cubic specimens. The compressive strength of concrete without rPET particles is moderate but rises when rPET particles are added at different percentages. Furthermore, the compressive strength values augment gradually between 7-28 days of curing. A reduction in cement hydration may be caused by the existence of non-degradable materials (rPET). Based on results, 7-day compressive strength is lower than 28-day compressive strength. Several techniques are known to improve the strength of materials, including blending, fiber insertion, utilizing fillers, and/or combining these methods. The reinforcement provided by smaller particles is usually greater. Concrete with 0.01 fiber added at 28 days increases by 37% on average in compressive strength, as demonstrated in sample No. 3[46]. At samples No. 4, 5, and 6 as shown by the experimental results, if we add fibers with increasing proportion of rPET, the compressive strength of the samples decreases[47,48]. The decrease in compressive strength can be explained by the decrease in adhesion between the fiber surface and rPET and the concrete matrix. Therefore, when the volume of injected fibers increases, the compressive strength decreases[49]. The decrease in compressive strength can be explained by the decrease in adhesion between the fiber surface and rPET and the concrete matrix. Therefore, when the volume of injected fibers increases, the compressive strength decreases[49]
The test results of the density of the specimens are presented in Table 5 and Figure 5. It can be seen that the density of concrete decreased with the increment of rPET



content in concrete. The density for concrete with 0.01, 0.02, and 0.03 ratios was found to be 2.37 gm/cm2, 2.32 gm/cm2 and 2.21 gm/cm2, respectively, which were relatively close to that of the control sample (2.48gm/cm2). The reason for the decrease in the density of fresh concrete with the increase in the rPET content is that the density of rPET particles is very low compared to the mixed materials[50]
Alternatively, at 0.01 hemp fiber content, the density value decreased as compared to the reference specimen. The low density of hemp fibers compared to other components of concrete also results in a decline in the value of density in hemp-based concrete due to the high amount of air trapped in the concrete and the high amount of entrapped air[51]
This study examined the mechanical and physical properties of concrete containing rPET and hemp and came to the following conclusions.
1. Concrete samples with different amounts of rPET particle content showed diverse conducts in flexural and compressive strength. In fact, for the rPET content of 0.01, the compressive strength increased by 37.7%. Alternatively, with the ascend of rPET content, the compressive strength reduced. The highest compressive strength was obtained for the hemp particle size of 37.9 mm with a ratio of 0.01 and cured for 28 days.
2. Flexural strength test results. Increasing rPET by up to 0.03 with hemp by up to 0.01 will increase the flexural strength. A spent rPET bottle can be reused as a raw material for concrete if it is in particle form. The concrete will be improved in terms of its mechanical and physical properties, as well as being an environmentally friendly alternative to previously used RPET bottles.
5. Author’s Contributions
• Conceptualization – Tamam Mahdi Salih; Wafaa Mahdi Salih.
• Data curation – Tamam Mahdi Salih.
• Formal analysis – Tamam Mahdi Salih.
• Funding acquisition – Tamam Mahdi Salih.
• Investigation – Tamam Mahdi Salih.
• Methodology – Tamam Mahdi Salih; Wafaa Mahdi Salih.
• Project administration – Wafaa Mahdi Salih.
• Resources – Tamam Mahdi Salih; Wafaa Mahdi Salih.
• Software – Tamam Mahdi Salih; Wafaa Mahdi Salih.
• Supervision – Wafaa Mahdi Salih.
• Validation – Tamam Mahdi Salih; Wafaa Mahdi Salih.
• Visualization – Tamam Mahdi Salih; Wafaa Mahdi Salih.
• Writing – original draft – Wafaa Mahdi Salih.
• Writing – review & editing – Tamam Mahdi Salih; Wafaa Mahdi Salih.
6. Acknowledgements
The authors would like to thank the University of Technology for their technical support in completing this study.
7. References
1 Lamba, P., Kaur, D. P., Raj, S., & Sorout, J. (2022). Recycling/ reuse of plastic waste as construction material for sustainable development: a review. Environmental Science and Pollution Research International, 29(57), 86156-86179 http://doi.org/10.1007/ s11356-021-16980-y PMid:34655383.
2 Almtori, S. A. S., Jassim, R. J., Ali, D. C., Kadhim, E. H., & Al-Sabur, R. (2023). Sustainable manufacturing process applied to produce waste polymer-polymer matrix composites. Environmental Research, Engineering and Management, 79(1), 122-132 http://doi.org/10.5755/j01.erem.79.1.32907
3 Gross, L., & Enck, J. (2021). Confronting plastic pollution to protect environmental and public health. PLoS Biology, 19(3), e3001131 http://doi.org/10.1371/journal.pbio.3001131 PMid:33784292.
4. Jassim, A. K. (2023). Effect of microplastic on the human health. In E.-S. Salama (Ed.), Advances and challenges in microplastics London: IntechOpen http://doi.org/10.5772/ intechopen.107149
5 Chen, H., Xu, Y., Zhang, D., Huang, L., Zhu, Y., & Huang, L. (2019). The Influence of Nano‐SiO2 and recycled polypropylene plastic content on physical, mechanical, and shrinkage properties of mortar. Advances in Civil Engineering, 2019(1), 6960216 http://doi.org/10.1155/2019/6960216
6. Babafemi, A. J., Šavija, B., Paul, S. C., & Anggraini, V. (2018). Engineering properties of concrete with waste recycled plastic: a review. Sustainability, 10(11), 3875 http://doi.org/10.3390/ su10113875
7 Sangal, G. S. (2018). Study the effect of plastic waste on strength of concrete. International Journal for Advance Research and Development, 3(7), 36-39. Retrieved in 2025, April 21, from https://www.ijarnd.com/manuscripts/v3i7/V3I7-1158.pdf
8 Ali, D. C., Jassim, A. K., & Al-Sabur, R. (2023). Recycling of polyethylene and polypropylene waste to produce plastic bricks. Journal of Sustainable Development of Energy, Water and Environment Systems, 11(4), 1110462 http://doi.org/10.13044/j. sdewes.d11.0462
9 Khalil, W. I., & Mahdi, H. M. (2020, February). Some properties of sustainable concrete with mixed plastic waste aggregate. In Proceedings of the 4th International Conference on Buildings, Construction and Environmental Engineering, Istanbul, Turkey IOP Publishing http://doi.org/10.1088/1757-899X/737/1/012073
10. Baksa, P., Cepak, F., Lukman, R. K., & Ducman, V. (2018). An evaluation of marine sediments in terms of their usability in the brick industry: case study Port of Koper. Journal of Sustainable Development of Energy, Water And Environment Systems, 6(1), 78-88 http://doi.org/10.13044/j.sdewes.d5.0183
11 Mishra, B. (2016). A study on use of recycled polyethylene terephthalate (PET) as construction material. International Journal of Scientific Research, 5(1), 724-730
12 Iorio, M., Marra, F., Santarelli, M. L., & González-Benito, J (2021). Reinforcement-matrix interactions and their consequences on the mechanical behavior of basalt fi bers-ceme nt composites. Construction & Building Materials, 309, 125103 http://doi.org/10.1016/j.conbuildmat.2021.125103
13 Brandt, A. M. (2008). Fibre reinforced cement-based (FRC) composites after over 40 years of development in building and civil engineering. Composite Structures, 86(1-3), 3-9 http://doi.org/10.1016/j.compstruct.2008.03.006
14 Raoufi, K., & Weiss, J. (2011). The role of fiber reinforcement in mitigating shrinkage cracks in concrete. In R. Fangueiro (Ed.), Fibrous and composite materials for civil engineering applications (pp. 168-188). Sawston: Woodhead Publishing http://doi.org/10.1533/9780857095583.2.168
15 Banthia, N., & Nandakumar, N. (2003). Crack growth resistance of hybrid fiber reinforced cement composites. Cement and Concrete Composites, 25(1), 3-9 http://doi.org/10.1016/S09589465(01)00043-9
16 Khandelwal, S., & Rhee, K. Y. (2020). Recent advances in basalt-fiber-reinforced composites: tailoring the fiber-matrix interface. Composites. Part B, Engineering, 192, 108011. http://doi.org/10.1016/j.compositesb.2020.108011
17 Ylmaz, V. T., Lachowski, E. E., & Glasser, F. P. (1991). Chemical and microstructural changes at alkali‐resistant glass fiber–cement interfaces. Journal of the American Ceramic Society, 74(12), 3054-3060 http://doi.org/10.1111/j.1151-2916.1991.tb04301.x
Improving the properties of recycled Polyethylene terephthalate (PET) reinforced with different fibers
18 Toutanji , H. A. , El-Korchi , T. , & Katz , R. N. ( 1994 ). Strength and reliability of carbon-fiber-reinforced cement composites. Cement and Concrete Composites, 16(1), 15-21 http://doi.org/10.1016/0958-9465(94)90026-4
19 Yang, Z., Yang, J., Shuai, B., Niu, Y., Yong, Z., Wu, K., Zhang, C., Qiao, X., & Zhang, Y. (2022). Superflexible yet robust functionalized carbon nanotube fiber reinforced sulphoaluminate cement-based grouting materials with excellent mechanical, electrical and thermal properties. Construction & Building Materials, 328, 126999 http://doi.org/10.1016/j.conbuildmat.2022.126999
20 Zhang, C., Shuai, B., Jia, S., Lv, X., Yang, T., Chen, T., & Yang, Z. (2021). Plasma-functionalized graphene fiber reinforced sulphoaluminate cement-based grouting materials. Ceramics International, 47(11), 15392-15399 http://doi.org/10.1016/j. ceramint.2021.02.104
21 Igarashi, S., Bentur, A., & Mindess, S. (1996). The effect of processing on the bond and interfaces in steel fiber reinforced cement composites. Cement and Concrete Composites, 18(5), 313-322. http://doi.org/10.1016/0958-9465(96)00022-4.
22 Soroushian, P., Tlili, A., Alhozaimy, A., & Khan, A. (1993). Development and characterization of hybrid polyethylene-fibrereinforced composites. Construction & Building Materials, 7(4), 221-229 http://doi.org/10.1016/0950-0618(93)90006-X
23 Wang, S., & Li, V. C. (2005). Polyvinyl alcohol fiber reinforced engineered cementitious composites: material design and performances. In Proceedings of the Int’l RILEM Workshop on HPFRCC in Structural Applications Hawaii Retrieved in 2025, April 21, from https://hdl.handle.net/2027.42/84790
24 Li, J., Yang, L., He, L., Guo, R., Li, X., Chen, Y., Muhammad, Y., & Liu, Y. (2023). Research progresses of fibers in asphalt and cement materials: a review. Journal of Road Engineering, 3(1), 35-70. http://doi.org/10.1016/j.jreng.2022.09.002.
25 Amaral, L. M., Rodrigues, C. S., & Poggiali, F. S. J. (2022). Hornification on vegetable fibers to improve fiber-cement composites: a critical review. Journal of Building Engineering, 48, 103947 http://doi.org/10.1016/j.jobe.2021.103947
26 Ferreira, S. R., Silva, F. A., Lima, P. R. L., & Toledo, R. D., Fo. (2017). Effect of hornification on the structure, tensile behavior and fiber matrix bond of sisal, jute and curauá fiber cement based composite systems. Construction & Building Materials, 139, 551-561 http://doi.org/10.1016/j.conbuildmat.2016.10.004
27 Martinelli, F. R. B., Ribeiro, F. R. C., Marvila, M. T., Monteiro, S. N., Garcia, F. C., Fo., & Azevedo, A. R. G. (2023). A review of the use of coconut fiber in cement composites. Polymers, 15(5), 1309. http://doi.org/10.3390/polym15051309. PMid:36904550.
28 Sawsen, C., Fouzia, K., Mohamed, B., & Moussa, G. (2015). Effect of flax fibers treatments on the rheological and the mechanical behavior of a cement composite. Construction & Building Materials, 79, 229-235 http://doi.org/10.1016/j. conbuildmat.2014.12.091
29. Van Der Werf, H. M. G., Mathussen, E. W. J. M., & Haverkort, A. J. (1996). The potential of hemp (Cannabis sativa L.) for sustainable fibre production: a crop physiological appraisal. Annals of Applied Biology, 129 (1), 109-123 http://doi.org/10.1111/j.1744-7348.1996.tb05736.x
30 Salentijn, E. M. J., Zhang, Q., Amaducci, S., Yang, M., & Trindade, L. M. (2015). New developments in fiber hemp (Cannabis sativa L.) breeding. Industrial Crops and Products, 68, 32-41 http://doi.org/10.1016/j.indcrop.2014.08.011
31 Mateos-Aparicio, I. (2021). Plant-based by-products. In C. M. Galanakis (Ed.), Food waste recovery (pp. 367-397). Cambridge: Academic Press http://doi.org/10.1016/B978-012-820563-1.00022-6
32. Shahzad , A. (2012 ). Hemp fiber and its composites–a review. Journal of Composite Materials, 46(8), 973-986 http://doi.org/10.1177/0021998311413623
33 Li, Z., Wang, L., & Wang, X. (2004). Compressive and flexural properties of hemp fiber reinforced concrete. Fibers and Polymers, 5(3), 187-197 http://doi.org/10.1007/BF02902998
34 Amin, F., Javed, M. F., Ahmad, I., Asad, O., Khan, N., Khan, A. B., Ali, S., Abdullaev, S., Awwad, F. A., & Ismail, E. A. A. (2024). Utilization of discarded face masks in combination with recycled concrete aggregate and silica fume for sustainable civil construction projects. Scientific Reports, 14(1), 449 http://doi.org/10.1038/s41598-023-50946-z. PMid:38172191.
35 Gonzalez Laria, J., Gaggino, R., Kreiker, J., Peisino, L. E., Positieri, M., & Cappelletti, A. (2023). Mechanical and processing properties of recycled PET and LDPE-HDPE composite materials for building components. Journal of Thermoplastic Composite Materials , 36(1), 418-431 http://doi.org/10.1177/0892705720939141
36 Almahri, G., Madi, K., Alkaabi, F., Badran, Y., Shehadeh, K., ElHassan, A., Ahmed, W., & Alzahmi, S. (2023). Characterization of hybrid FRP composite produced from recycled PET and CFRP. Polymers, 15(13), 2946. http://doi.org/10.3390/ polym15132946 PMid:37447589.
37 Song, H., Liu, T., & Gauvin, F. (2024). Enhancing mechanical performance of green fiber cement composites: role of eco-friendly alkyl ketene dimer on surfaces of hemp fibers. Journal of Materials Research and Technology, 28, 3121-3132 http://doi.org/10.1016/j.jmrt.2023.12.255
38 Manaia, J. P., Manaia, A. T., & Rodriges, L. (2019). Industrial hemp fibers: an overview. Fibers, 7(12), 106 http://doi.org/10.3390/ fib7120106
39 Han, D., & Ferron, R. D. (2015). Effect of mixing method on microstructure and rheology of cement paste. Construction & Building Materials, 93, 278-288 http://doi.org/10.1016/j. conbuildmat.2015.05.124.
40 British Standards Institution (2009). BS EN 12390-3:2009: testing hardened concrete: compressive strength of test specimens London: British Standards Institution.
41 American Society for Testing and Materials – ASTM. (2010). ASTM C1609/C1609M-07: standard test method for flexural performance of fiber-reinforced concrete. West Conshohocken: ASTM International
42 Abed, H. S. (2019). Production of lightweight concrete by using construction lightweight wastes. Engineering and Technology Journal, 37(1A), 12-19 http://doi.org/10.30684/etj.37.1A.3
43 Robert, U. W., Etuk, S. E., & Agbasi, O. E. (2019). Modified water displacement method and its use for determination of bulk density of porous materials. Journal of Renewable Energy and Mechanics, 2(1), 1-16 http://doi.org/10.25299/ rem.2019.2292
44 Eyni Kangavar, M., Lokuge, W., Manalo, A., Karunasena, W., & Frigione, M. (2022). Investigation on the properties of concrete with recycled polyethylene terephthalate (PET) granules as fine aggregate replacement. Case Studies in Construction Materials, 16, e00934 http://doi.org/10.1016/j. cscm.2022.e00934
45. Abdulridha, S. Q., Nasr, M. S., Al-Abbas, B. H., & Hasan, Z. A. (2022). Case study Mechanical and structural properties of waste rope fibers-based concrete: an experimental study. Case Studies in Construction Materials, 16, e00964 http://doi.org/10.1016/j. cscm.2022.e00964.
46 Córdoba, L. Á., Martínez-Barrera, G., Díaz, C. B., Nuñez, F. U. , & Yañez , A. L. ( 2013 ). Effects on Mechanical Properties of Recycled PET in Cement‐Based Composites. International Journal of Polymer Science, 763276, 1-6 http://doi.org/10.1155/2013/763276
47. Sharma, R., & Bansal, P. P. (2016). Use of different forms of waste plastic in concrete–a review. Journal of Cleaner Production, 112(Pt 1), 473-482 http://doi.org/10.1016/j.jclepro.2015.08.042
T. M., & Salih, W. M.
48 Borg , R. P. , Baldacchino , O. , & Ferrara , L. ( 2016 ). Early age performance and mechanical characteristics of recycled PET fibre reinforced concrete. Construction & Building Materials , 108 , 29-47 http://doi.org/10.1016/j. conbuildmat.2016.01.029.
49. Kiyanets, A. V. (2018). Concrete with recycled polyethylene terephthalate fiber. Magazine of Civil Engineering, 8(84), 109-118 http://doi.org/10.18720/MCE.84.11
50 Nibudey, R. N., Nagarnaik, P. B., Parbat, D. K., & Pande, A. M. (2013). Strengths prediction of plastic fiber reinforced concrete (M30). International Journal of Engineering Research and Applications , 3 ( 1 ), 1818 - 1825 . Retrieved
in 2025, April 21, from https://www.researchgate.net/ publication/271528657
51 Saadi, Z. M., Sadiq, A. T., Akif, O. Z., & Farhan, A. K. (2024). A survey: security vulnerabilities and protective strategies for graphical passwords. Electronics, 13(15), 3042. http://doi.org/10.3390/electronics13153042
Received: Apr. 21, 2025
Revised: Jul. 04, 2025
Accepted: Jul. 12, 2025
Editor-in-Chief: Sebastião V. Canevarolo
Sankar Thangavel1* , Kannan Thanneerpanthalpalayam Kandasamy2 , Rajasekar Rathanasamy3 and Ratchagaraja Dhairiyasamy4,5
1Department of Mechanical Engineering, Paavai College of Engineering, Namakkal, Tamilnadu, India
2Department of Mechanical Engineering, Jerusalem College of Engineering, Chennai, Tamil Nadu, India
3Department of Mechanical Engineering, Kongu Engineering College, Erode, Tamilnadu, India
4Department of Electronics and Communication Engineering, Saveetha School of Engineering, Saveetha Institute of Medical and Technical Sciences, Saveetha University, Chennai, Tamilnadu, India
5Centre of Research Impact and Outcome, Chitkara University, Rajpura, Punjab, India
*ersankar.t@gmail.com
Obstract
Electrospun polycaprolactone (PCL) nanofibers are widely studied for biomedical applications due to their biodegradability and processability, but their limited mechanical strength and bioactivity restrict advanced use. This study addresses these challenges by incorporating four types of functionalized graphene—carboxyl (CFG), hydroxyl (HFG), amine (AFG), and sulfonic (SFG)—into PCL at varying concentrations. Nanocomposite fibers were fabricated via electrospinning and characterized using SEM, FTIR, Raman, DSC, TGA, tensile testing, and MTT assay. Among all, PCL reinforced with 1 wt% SFG showed superior properties, including a tensile strength of 5.8 MPa, 34% thermal residue at 600°C, and 93% cell viability at 72 hours, outperforming pure PCL by over 60% in strength and 9% in biocompatibility. The enhancement is attributed to improved dispersion and strong interfacial bonding from polar functional groups. These results highlight the potential of functionalized graphene to engineer high-performance nanofibers for tissue engineering and regenerative medicine applications.
Keywords: PCL nanocomposites, electrospinning, graphene, mechanical properties, biocompatibility.
Data Ovailability: Research data is available upon request from the corresponding author.
How to cite: Thangavel, S., Kandasamy, K. T., Rathanasamy, R., & Dhairiyasamy, R. (2025). Optimizing graphene-enhanced polycaprolactone nanofibers for superior biomedical properties. Polímeros: Ciência e Tecnologia, 35(4), e20250042. https://doi.org10.1590/0104-1428.20240133
The increasing demand for advanced biomaterials has prompted significant interest in nanotechnology-driven approaches to develop next-generation scaffolds for biomedical applications. Among various nanostructured platforms, electrospun polymeric nanofibers have gained considerable attention due to their structural similarity to natural extracellular matrices, which promotes cellular adhesion, proliferation, and differentiation. Electrospinning technology offers the advantage of producing continuous nanofibers with high surface-to-volume ratios, tunable porosity, and the capacity to incorporate functional additives, making it an ideal tool for fabricating scaffolds for tissue engineering, wound dressings, and drug delivery systems[1]. However, the full potential of electrospun scaffolds relies heavily on the selection and engineering of suitable polymeric systems with enhanced mechanical, thermal, and biological properties.
Polycaprolactone (PCL) is a semicrystalline, aliphatic polyester widely recognized for its biodegradability, non-toxic degradation byproducts, and compatibility with human tissue. Its low melting temperature and solubility in
a range of organic solvents make it particularly attractive for electrospinning. Nevertheless, pure PCL suffers from inherent limitations such as low tensile strength, slow degradation rate, and insufficient bioactivity, restricting its applicability in mechanically demanding or rapidly healing tissues[2]. Various modification strategies have been proposed to overcome these drawbacks, including polymer blending, surface functionalization, and the incorporation of nanofillers. Among them, reinforcement with carbon-based nanomaterials has shown great promise in enhancing the structural and functional attributes of PCL nanofibers[3]
Graphene and its derivatives have emerged as superior nanofillers due to their exceptional electrical, thermal, and mechanical properties, as well as their large surface area and tunable surface chemistry. Functionalized graphene, particularly those modified with oxygen-containing groups such as carboxyl (–COOH), hydroxyl (–OH), amine (–NH2), or sulfonic acid (–SO3H), has demonstrated improved dispersibility in polymer matrices and stronger interfacial bonding [4]. These functional groups are known
Thangavel, S., Kandasamy, K. T., Rathanasamy, R., & Dhairiyasamy, R.
to form hydrogen bonds or electrostatic interactions with polymer chains, enhancing filler-matrix compatibility and promoting stress transfer across the interface. Furthermore, graphene-based nanocomposites have been reported to exhibit antibacterial activity and support cellular behaviors critical for tissue regeneration, making them ideal candidates for biomedical scaffolding[5]
The reviewed literature ( Table 1) confirms that electrospinning is a versatile and effective method for fabricating nanocomposite fibers with improved properties. Several studies emphasize the role of graphene and other nanofillers in enhancing thermal stability, mechanical strength, and structural uniformity. However, few works systematically evaluate the impact of different functional groups (e.g., –COOH, –OH, –NH2, –SO3H) on fiber properties or include biocompatibility assessments[16]. The current study bridges this gap by comparing four functionalized graphene derivatives in a unified PCL matrix, revealing the superior reinforcement and biological response offered by AFG and SFG systems, which have received minimal attention in past biomedical research.
Previous research has explored the incorporation of graphene oxide (GO) or reduced graphene oxide (rGO) into PCL matrices, with results indicating improvements in mechanical strength, thermal stability, and biological response. However, most of these studies have been limited to a single form of graphene derivative, often lacking comparative analysis across different functional groups[17]. Moreover, limited attention has been given to systematically optimizing the graphene content to balance mechanical reinforcement with dispersion quality and cytocompatibility. Without this optimization, the tendency of graphene to agglomerate at higher concentrations can negate its beneficial effects, leading to inconsistent fiber morphology and compromised
performance. Additionally, few investigations have examined the role of newer functional groups such as sulfonic or amine moieties in modifying PCL-based nanofibers.
To fill these gaps, the current research focuses on the design and optimization of electrospun PCL nanofibers reinforced by chemically prepared graphene derivatives like (CFG), (HFG), (AFG) and (SFG). It was possible with such tailored graphene derivatives to introduce diverse chemical complements, which control dispersion dynamics, interfacial bonding, and final performance qualities of the nanocomposite fibers. The investigation includes changing the ratio of graphene to 0.5 wt%, 1 wt%, and 2 wt% to determine the optimal loading of the filler for every derivative at the aspects of morphological stability, mechanical properties, thermal performance, and biological safety[18]
This research aims to prepare and evaluate multifunctional nanofiber mats from PCL and graphene derivatives prepared by electrospinning for selecting the best mixture providing mechanical, thermal and biological performance. SEM, FTIR, Raman spectroscopy, DSC, TGA, tensile testing, and MTT assay analyze the nanocomposites. Using such analytical methods, we can analyze such parameters as fiber morphology, intermolecular forces, graphene integration, as well as biocompatibility with HDFs to enable a comprehensive analysis of the structure–property–function correlations in the fabricated nanocomposites[19] .
The novelty of the present study lies in the simultaneous exploration and comparison of four distinct functionalized graphene derivatives within a unified experimental framework. Unlike previous studies that focused on GO or rGO alone, this research highlights the unique contributions of less-explored derivatives like AFG and SFG, revealing their superior influence on fiber refinement and reinforcement. The inclusion of these
Hydroxyapatite
Catalysis & magnetic recyclability
Functionalized GO (NH2-POSS) Yes Thermal applications
MXene@AgNP Yes Wastewater treatment
CuO, Al, GO
Energetic materials
Graphene Yes Electronics
Graphene, Fe3O4 Yes Magnetic fiber fabrication
BaTiO3 Yes Dielectric materials
(fibrous, uniform)
(hierarchical nanostructure)
(dense, aligned)
(intercalated flakes)
(dense, ultrafine)
(smooth, uniform)
(mesh-like)
(aligned via magnetic/ electric field)
(dispersed, low loss)
the role of nanofillers in wettability and morphology enhancement[6]
Demonstrates the role of mineral fillers for cytocompatibility—parallels with HFG[7]
Highlights multifunctionality potential of electrospun nanofibers[8]
Directly supports current use of NH2GO (AFG) for thermal/mechanical tuning[9]
Reinforces the benefit of dispersion strategy to avoid agglomeration[10]
Supports the effectiveness of COOH functional groups for composite performance[11]
Highlights the impact of 0.5 wt% GO on fiber quality and reaction enhancement[12]
Validates fiber alignment and graphene’s effect on conductivity and thermal properties[13]
Highlights innovative alignment strategies—applicable to scaffold orientation[14]
Shows electrospinning’s role in nanofiller dispersion and matrix enhancement[15]
Optimizing graphene-enhanced polycaprolactone nanofibers for superior biomedical properties
derivatives is particularly significant, as they introduce highly polar or reactive functional groups capable of forming stronger intermolecular interactions with PCL chains. The observed improvements in fiber uniformity, tensile strength, and thermal degradation resistance establish these nanofillers as viable candidates for high-performance biomedical applications. Moreover, the use of a standardized electrospinning protocol ensures that the effects of functional group chemistry and filler concentration can be directly compared across formulations, strengthening the study’s internal consistency[20]
The outcomes of this research are expected to contribute valuable insights into the rational design of advanced nanofiberbased scaffolds for biomedical engineering. By demonstrating the synergistic effects of functionalized graphene with tailored surface chemistry, the study offers new possibilities for enhancing the mechanical and biological performance of electrospun nanocomposites. In particular, the findings may benefit the development of tissue engineering scaffolds with improved load-bearing capability, wound dressings with prolonged stability and antibacterial function, and drug delivery systems with extended degradation profiles. The study’s systematic approach to filler optimization and functional group evaluation represents a forward step in creating customizable nanomaterials for diverse clinical applications[21]
This work responds to a critical need for multifunctional and high-performance biomaterials by developing electrospun PCL nanofibers reinforced with various functionalized graphene derivatives. Through comparative analysis and optimization of graphene content, the study establishes structure–property relationships that govern the mechanical, thermal, and biological behavior of the resulting nanocomposites. The inclusion of underexplored functional groups such as –NH2 and –SO3H introduces new perspectives on filler design, while the comprehensive characterization strategy ensures robust evaluation of material performance. The knowledge gained from this research can inform future innovations in polymer nanocomposite development for biomedical applications, thereby advancing the field toward more effective and personalized medical solutions.
The base polymer used in the present study was polycaprolactone (PCL), a widely employed biodegradable aliphatic polyester. It was procured from Sigma-Aldrich with an average molecular weight of 80,000 g/mol. Its known advantages such as biocompatibility, processability, and biodegradation suitability, make it ideal for biomedical applications. In order to enhance the performance of PCL, it was reinforced with functionalized graphene derivatives. Specifically, two forms of chemically functionalized graphene were selected: carboxyl-functionalized graphene (CFG) and hydroxyl-functionalized graphene (HFG). These derivatives were purchased from Graphene Supermarket and featured a purity of 99% with particle sizes ranging from 1 to 10 µm. Their functional groups were chosen to improve dispersion within the polymer and increase interaction at the filler–matrix interface. In later extensions of the study, amine-functionalized graphene (AFG) and sulfonic-functionalized graphene (SFG) were incorporated to provide a comparative perspective of functionality-induced enhancements[22]
To prepare the electrospinning solution, PCL was dissolved in a solvent blend composed of chloroform and N,N-dimethylformamide (DMF) in a 4:1 volume ratio. The polymer concentration was maintained at 12 wt% to ensure appropriate viscosity and conductivity for stable jet formation during electrospinning. The graphene derivatives were first dispersed in DMF by probe sonication for 60 minutes at 100 W to reduce agglomeration. This step was critical to achieve exfoliation of graphene sheets and homogeneous nanofiller distribution. After ultrasonication, the dispersed nanofiller solution was gradually added to the pre-prepared PCL solution, followed by magnetic stirring for 4 hours at 500 rpm. An additional ultrasonication step of 30 minutes was then conducted to further reduce any micro-agglomerates and promote complete dispersion. The mixtures were prepared at three concentrations—0.5 wt%, 1.0 wt%, and 2.0 wt%—for each graphene derivative to systematically investigate the effect of nanofiller loading on the morphology and performance of the resulting nanofibers.
The electrospinning apparatus consisted of a programmable syringe pump, a 21-gauge needle connected to a high-voltage power supply, and a grounded rotating drum collector. The optimized electrospinning parameters included an applied voltage of 15 kV, a feed rate of 1 mL/h, and a fixed distance of 15 cm between the needle tip and the collector. The drum rotation speed was kept low to fabricate randomly oriented fibers. All electrospinning procedures were conducted at ambient room temperature under controlled humidity conditions. Fibers were collected continuously for four hours per sample onto aluminum foil-wrapped collectors. After deposition, the fiber mats were dried at room temperature for 24 hours to ensure the complete removal of residual solvents. This setup is illustrated in Figure 1, which depicts the electrospinning assembly and process flow.
To ensure experimental reliability and repeatability, all samples were prepared in triplicate (n = 3). For characterization studies such as FTIR, SEM, Raman, DSC, and tensile testing, a minimum of three independent measurements were obtained from different regions of each sample. For tensile properties, five replicates were tested per group (n = 5), and for MTT assay-based biocompatibility tests, both biological and technical replicates (n = 3 × 3) were employed at each time point.
Morphological characterization was conducted using a JEOL JSM-IT200 scanning electron microscope to evaluate the surface structure and fiber formation in the electrospun mats. Prior to SEM imaging, all nanofiber samples were gold-sputtered under vacuum to eliminate surface charging and ensure image clarity. Imaging was carried out at magnifications ranging from 5000x to 10000x to capture detailed features of fiber morphology. From each micrograph, the fiber diameter was quantitatively analyzed using ImageJ software by measuring 100 randomly selected fibers per image, enabling statistically robust assessment of the average diameter and distribution. Figures present SEM micrographs of electrospun PCL nanofibers reinforced with carboxyl-functionalized graphene (CFG) at concentrations of 0.5 wt%, 1.0 wt%, and 2.0 wt%. The images demonstrate how increasing CFG content alters the fiber characteristics in terms of surface smoothness, structural uniformity, and average thickness[23]
Thangavel, S., Kandasamy, K. T., Rathanasamy, R., & Dhairiyasamy, R.

In addition, SEM images were obtained for nanofibers containing h(HFG), (AFG), and (SFG), each at a loading of 1 wt%. These are displayed in Figures, which enable direct comparison of the effects of different functional groups on fiber formation. The SFG-reinforced fibers exhibited the most refined morphology, with the smallest average diameter and highly uniform structure, attributed to enhanced dispersion and interfacial bonding. Fibers containing AFG and HFG showed improved structure compared to unreinforced PCL but with slightly larger diameters and minor variations in alignment, indicating moderate interaction and dispersion levels.
To further visualize the influence of both graphene content and functional group type on fiber diameter, comparative fiber diameter plots were prepared. This analysis highlights a consistent reduction in average fiber diameter with increasing nanofiller concentration up to 1 wt%, followed by a slight increase at 2 wt%, likely due to nanoparticle agglomeration. All graphene types showed the lowest diameter at 1 wt%, confirming this as the optimal concentration for achieving uniform, fine nanofiber morphology.
(FTIR) was conducted to verify the successful incorporation of functionalized graphene into the PCL matrix and to examine possible chemical interactions. Spectra were recorded in the range of 4000 to 400 cm−1 using a Bruker Tensor 27 spectrometer. Peaks corresponding to the ester bond (C=O at 1720 cm−1), CH2 stretching vibrations (~2945 and 2865 cm−1), and C–O–C stretching (~1100–1240 cm−1) were analyzed. Any changes in peak intensity or position were attributed to hydrogen bonding or electrostatic interaction between the graphene functional groups and the polymer chains. The FTIR spectra for all samples are presented[24]
Raman spectroscopy was employed to confirm the structural presence and dispersion quality of graphene within the PCL matrix. Spectra were collected using a 532 nm excitation laser with a spectral resolution of 1 cm−1 Key bands, including the D-band (~1350 cm−1), G-band (~1580 cm−1), and the 2D-band (~2700 cm−1), were monitored. The relative intensity ratio of D to G bands (I_D/I_G) was calculated to assess defect levels in functionalized graphene.
Raman mapping further validated the spatial uniformity of the filler across the nanofiber surface[25]
The mechanical properties of the electrospun nanofiber mats were evaluated using an Instron 5567 universal testing machine with a 100 N load cell. Samples were cut into rectangular strips (5 mm × 30 mm), and tensile testing was performed at a crosshead speed of 5 mm/min. Young’s modulus, ultimate tensile strength, and elongation at break were determined for each sample type. These properties were statistically averaged across five specimens per group. The tensile performance of all compositions is summarized graphically.
Thermal stability and crystallinity of the samples were assessed using differential scanning calorimetry (DSC) and thermogravimetric analysis (TGA). DSC analysis was carried out under nitrogen from 25°C to 100°C at a heating rate of 10°C/min. The melting temperature (Tm), crystallization temperature (Tc), and degree of crystallinity were calculated from endothermic peak areas. TGA was conducted under nitrogen with a temperature ramp from 30°C to 600°C at 10°C/min to determine the onset of thermal degradation and residual weight percentage. TGA results for 1 wt% nanocomposites are shown[26]
To evaluate the cytocompatibility of the nanofiber mats, an in vitro MTT assay was performed using human dermal fibroblasts (HDFs). Electrospun mats were UV-sterilized and placed in 24-well plates, where HDFs were seeded at a density of 1 × 104 cells/well. The cells were incubated at 37°C in a humidified CO2 environment and assessed at 24, 48, and 72 hours post-seeding. At each time point, the MTT reagent was added, and after incubation, formazan crystals were dissolved in DMSO and absorbance was measured at 570 nm using a microplate reader. The procedure allowed quantification of cell viability and proliferation, which was used to infer the biocompatibility of each nanocomposite formulation.
All materials and methods adopted in this study were selected to ensure the fabrication of high-performance nanofibrous mats with potential for biomedical applications. The stepwise optimization of each variable—from solvent system and filler dispersion to electrospinning conditions and biological testing—ensured consistency and reproducibility
Optimizing graphene-enhanced polycaprolactone nanofibers for superior biomedical properties
across the experiments. The full experimental matrix, including sample composition, test types, and replicates, was implemented to guarantee the scientific rigor required for biomaterial development[27]
SEM images (Figure 2) reveal the influence of functionalized graphene derivatives on the morphology of electrospun polycaprolactone (PCL) nanofibers. Pure PCL nanofibers serve as the baseline, displaying a smooth, bead-free surface with an average diameter of approximately 620 nm and a randomly oriented fiber network. Upon incorporation of 0.5 wt% carboxyl-functionalized graphene (CFG), a noticeable reduction in fiber diameter is observed (~580 nm), along with the development of slight surface texture, suggesting early-stage polymer-filler interaction and enhanced solution conductivity. At 1 wt% CFG, the fiber morphology is optimized, exhibiting thinner, more uniform fibers with an average diameter around 520 nm. This reflects the improved alignment and chain stretching attributed to the hydrogen bonding and electrostatic interactions offered by carboxyl groups. However, increasing the CFG content to 2 wt% results in partial agglomeration, as evidenced by a marginal increase in diameter (~610 nm) and less regular fiber arrangement, likely due to increased viscosity and nanoparticle clustering disrupting the electrospinning jet[28]
Hydroxyl- and sulfonic-functionalized graphene (HFG and SFG), the effect of functional group chemistry becomes more distinct. PCL nanofibers with 0.5 wt% HFG show a modest decrease in diameter (~570 nm), similar to CFG at the same loading, but with a slightly rougher fiber texture. At 1 wt% HFG, the morphology improves further with an average diameter of approximately 510 nm, though still not as refined as CFG, reflecting the relatively weaker interaction strength of hydroxyl groups. With 2 wt% HFG, aggregation effects become evident, leading to larger, less uniform fibers (~600 nm) and minor surface irregularities. In contrast, nanofibers containing 1 wt% sulfonic-functionalized
graphene (SFG) display the most refined morphology, with the thinnest diameter (~495 nm) and highly uniform, smooth fibers. The strong ionic nature of sulfonic groups enhances dispersion and interfacial bonding, resulting in superior electrospinning stability and fiber alignment.
The SEM images confirm that both the type and concentration of graphene derivatives significantly influence fiber morphology. The optimal morphology is observed at 1 wt% loading, with SFG providing the most effective reinforcement, followed by CFG and HFG. These morphological improvements support the enhancements seen in mechanical and thermal performance, validating the role of surface-functionalized graphene in engineering advanced nanofiber scaffolds.
Figure 3 shows the variation in fiber diameter of electrospun polycaprolactone (PCL) nanofibers reinforced with different types of functionalized graphene—(CFG), h(HFG), (AFG), and (SFG)—across three graphene concentrations: 0.5 wt%, 1.0 wt%, and 2.0 wt%. The graph highlights the morphological response of the fibers to nanoparticle loading and surface chemistry[29] .
At 0 wt%, the baseline fiber diameter for pure PCL is approximately 620 nm. With the introduction of graphene, the fiber diameter decreases across all derivatives, reaching a minimum at 1.0 wt%. Specifically, PCL/SFG shows the lowest average diameter at this concentration (~495 nm), which corresponds to a 20.2% reduction compared to pure PCL. This is followed by AFG (~500 nm), HFG (~510 nm), and CFG (~520 nm), suggesting that highly polar and reactive groups like –SO3H and –NH2 enhance solution conductivity and polymer chain alignment, thereby producing finer fibers.
At 2.0 wt%, a reversal trend is observed, with the diameters increasing again. This likely indicates the onset of graphene agglomeration at higher concentrations, which disrupts the homogeneity and viscosity of the spinning solution. Still, even at 2.0 wt%, SFG and AFG retain a 5.6–6.5% smaller fiber

Thangavel, S., Kandasamy, K. T., Rathanasamy, R., & Dhairiyasamy, R.
diameter than CFG, highlighting their superior dispersibility and interaction with the PCL matrix[30]
The data confirms that both graphene concentration and surface functionalization strongly influence fiber morphology. Sulfonic and amine groups contribute most effectively to diameter reduction due to enhanced interfacial compatibility, resulting in more uniform and finer nanofiber formation ideal for biomedical scaffold applications.
Figure 4 shows the Fourier Transform Infrared (FTIR) spectroscopy analysis of pure polycaprolactone (PCL) and its nanocomposites with different functionalized graphene derivatives, including (CFG), (HFG), (AFG), and (SFG). The spectra span the wavenumber range of 4000 to 500 cm−1 and present the characteristic absorption bands associated with PCL’s molecular structure and its interactions with the incorporated graphene materials[31]
The dominant peaks at ~2945 cm−1 and ~2865 cm−1 correspond to CH2 asymmetric and symmetric stretching vibrations, respectively. These bands are preserved across all samples, indicating the structural integrity of the PCL
backbone. A sharp peak around ~1720 cm−1 is observed in all spectra and is attributed to the C=O stretching vibration of the ester functional group, which is the hallmark of PCL. Notably, this peak shows a slight increase in intensity for graphene-reinforced samples, particularly for PCL/1% SFG and PCL/1% AFG, reflecting enhanced dipole interactions due to strong hydrogen bonding or polar interactions between the carbonyl group and functional groups like –SO3H or –NH2 [32]. The C–O and C–O–C stretching bands appearing between ~1240–1100 cm−1 are also evident, and these regions display subtle differences in intensity. The samples containing SFG and AFG show slightly broader peaks in this region, suggesting stronger interfacial bonding and possibly slight changes in local chain conformation or orientation[33]
The consistent presence and modest shifts in key absorption bands validate the successful incorporation of functionalized graphene into the PCL matrix without disrupting the polymer’s molecular framework. The enhanced peak intensities and band broadening in SFG- and AFG-based nanocomposites indicate


Optimizing graphene-enhanced polycaprolactone nanofibers for superior biomedical properties
stronger chemical interactions and potentially superior dispersion compared to conventional CFG and HFG, making them promising for property enhancement in biomedical scaffolds.
Figure 5 shows the Raman spectroscopy analysis of pure polycaprolactone (PCL) and its nanocomposites reinforced with different functionalized graphene derivatives, including (CFG), (HFG), (AFG), and (SFG), alongside a spectrum of pristine graphene. The graph presents clear D (~1350 cm−1), G (~1580 cm−1), and 2D (~2700 cm−1) peaks, which are characteristic of graphene-based materials and validate the presence and structural features of the incorporated graphene in the PCL matrix [34]
The pure PCL sample exhibits a flat spectral profile, lacking the prominent D and G bands, as expected due to the absence of graphitic content. With the addition of functionalized graphene, distinct D and G peaks emerge, with increasing intensity correlating with higher graphene content. For instance, PCL/1% CFG and PCL/1% AFG display pronounced G peaks with approximately 30–35%
higher intensity than PCL/0.5% CFG, indicating enhanced graphene dispersion and interaction. Among the samples, PCL/1% SFG exhibits the most intense D and G peaks, suggesting robust integration and interfacial bonding due to the ionic character of sulfonic groups, which may enhance π–π interactions with the polymer backbone.
Notably, the 2D peak, visible only in pristine graphene, is absent or significantly diminished in the composite spectra, confirming that the graphene used was primarily few-layer or functionalized, lacking long-range order [35]. The slight redshift in G-band position in functionalized samples (e.g., ~1582–1585 cm−1) is attributed to strain or doping effects from chemical functionalization. These spectral features confirm successful incorporation of graphene derivatives and illustrate the influence of surface chemistry on structural integrity, bonding, and dispersion quality within the nanocomposite framework [36]
Figure 6 shows the variation in tensile strength of electrospun PCL nanofibers as a function of graphene content for four


Thangavel, S., Kandasamy, K. T., Rathanasamy, R., & Dhairiyasamy, R.
different functionalized graphene derivatives: (CFG), (HFG), (AFG), and (SFG). All formulations demonstrate a clear trend of mechanical reinforcement with increasing graphene concentration up to 1 wt%, followed by a marginal decline at 2 wt% due to probable nanoparticle agglomeration[37] .
At 1 wt% loading, PCL/SFG nanofibers achieve the highest tensile strength of approximately 5.8 MPa, which represents a 65.7% increase compared to pure PCL (3.5 MPa). This enhancement is primarily attributed to the ionic and hydrogen bonding capacity of sulfonic groups (–SO3H), which form strong electrostatic interactions with the polymer chains, promoting efficient load transfer. PCL/AFG reaches 5.6 MPa at 1 wt%, marking a 60% improvement, likely due to the polar –NH2 groups engaging in hydrogen bonding with the ester backbone of PCL. In comparison, CFG and HFG reach 5.5 MPa and 5.2 MPa, translating to 57.1% and 48.5% gains, respectively[38]
At 2 wt%, all formulations exhibit a slight drop, with PCL/SFG and PCL/AFG decreasing to 5.4 and 5.3 MPa, suggesting that overloading leads to filler agglomeration, disrupting matrix continuity. Nonetheless, their strengths remain higher than CFG (5.2 MPa) and HFG (5.0 MPa), confirming the superior reinforcing efficiency of multifunctional groups. The steeper gradient observed between 0.5 and 1 wt% highlights the critical dispersion threshold, beyond which the benefits plateau or diminish[39]
These findings emphasize that beyond filler dispersion, the nature of surface functional groups plays a pivotal role in modulating interfacial adhesion and stress transfer. Sulfonic and amine groups, due to their high polarity and hydrogen bonding ability, show the highest reinforcement potential, suggesting their broader applicability in load-bearing biomedical scaffolds.
Figure 7 shows the thermal degradation profiles of pure PCL and its nanocomposites reinforced with (CFG), (HFG), (AFG), and (SFG) at a concentration of 1 wt%. The inclusion of AFG and SFG represents a novel functional group strategy to enhance material performance by exploiting their reactive surface chemistries[40]. Among all samples,
PCL/1 wt% SFG exhibits the highest thermal resistance, maintaining approximately 34% residual mass at 600°C, which is a 54% improvement compared to pure PCL (22%). This substantial enhancement can be attributed to the strong sulfonic acid groups (–SO3H) on SFG, which form robust hydrogen bonds and ionic interactions with the PCL matrix, thereby hindering chain mobility and heat diffusion. Similarly, PCL/1 wt% AFG retains 33% of its mass at 600°C—around 50% higher than pure PCL—demonstrating the stabilizing role of amine groups (–NH2), which likely interact with ester bonds in PCL through hydrogen bonding[41]
Compared to conventional CFG and HFG systems, AFG and SFG derivatives show 5–10% greater thermal protection across most temperature ranges. At 400°C, PCL/1 wt% SFG retains 79% weight versus 75% in PCL/1 wt% HFG and 76% in PCL/1 wt% CFG, translating to a 5.3% and 3.9% improvement, respectively. These findings underscore the importance of selecting functional groups that not only disperse well but also chemically engage with the polymer chains to form a more thermally robust network. The improved resistance offered by SFG and AFG indicates their potential as multifunctional nanofillers not only for thermal stability but also for extended roles in drug delivery or antimicrobial performance due to their charged surface functionalities .
The cytocompatibility of the electrospun nanofiber mats was quantitatively evaluated using the MTT assay, with results measured at 24-, 48-, and 72-hours post-incubation on human dermal fibroblasts (HDFs). As shown in Figure 8, cell viability increased progressively over time for all samples, indicating that the nanofiber mats supported cellular attachment and proliferation. At 24 hours, pure PCL exhibited a cell viability of 79%, while samples containing 1 wt% CFG, HFG, AFG, and SFG demonstrated improved values of 83%, 84%, 86%, and 88%, respectively. This trend continued at 48 and 72 hours, where PCL/1 wt% SFG reached the highest viability of 93%, significantly greater than the 85% observed for pure PCL (p < 0.05, ANOVA followed by Tukey’s post hoc test). These enhancements were statistically significant (p < 0.05) across all graphene-containing samples.

Optimizing graphene-enhanced polycaprolactone nanofibers for superior biomedical properties

24, 48, and 72 hours.
The improved biocompatibility of the graphene-reinforced fibers can be attributed to the presence of polar functional groups such as –NH2 in AFG and –SO3H in SFG, which enhance hydrophilicity and promote favorable interactions with the cellular membrane. These groups may also contribute to the adsorption of serum proteins that facilitate cell adhesion and metabolic activity[42]. The consistent viability above 90% at 72 hours for AFG and SFG samples confirms that the functionalized graphene not only reinforces the fiber matrix structurally but also supports a bioactive surface conducive to cell growth. The results affirm that the developed nanofibers are non-cytotoxic and potentially suitable for applications in regenerative scaffolding or wound healing environments.
The present study successfully demonstrates the enhancement of polycaprolactone (PCL) nanofibers through the incorporation of four chemically functionalized graphene derivatives—CFG, HFG, AFG, and SFG—using electrospinning. The nanocomposites were optimized at 1 wt% loading, where significant improvements in mechanical, thermal, and biological performance were achieved. Among all formulations, PCL reinforced with 1 wt% SFG exhibited the highest tensile strength of 5.8 MPa, marking a 65.7% increase compared to neat PCL (3.5 MPa), while PCL/AFG achieved a closely comparable strength of 5.6 MPa. Thermal stability was markedly improved, with TGA showing 34% residual weight for PCL/SFG at 600°C—an enhancement of over 54% relative to unreinforced PCL. Fiber morphology was also optimized at this concentration, where average diameters decreased by over 20% for SFG and AFG, confirming excellent dispersion and interfacial bonding. Notably, the MTT assay revealed that PCL/SFG maintained cell viability above 93% at 72 hours, significantly outperforming pure PCL at 85%, indicating excellent cytocompatibility.
The inclusion of underexplored functional groups such as –SO3H and –NH2 played a pivotal role in modulating the material’s behavior, as they promoted hydrogen bonding, enhanced filler–matrix compatibility, and improved the
bioactive surface profile of the nanofibers. This study provides compelling evidence that graphene surface functionalization is a critical parameter in optimizing nanofiber scaffolds for biomedical use.
Future research should explore long-term biodegradation behavior, in vivo evaluations, and potential drug-loading capabilities of these nanocomposites. Additionally, the effect of dual or hybrid functionalized graphene systems could be investigated to further synergize reinforcement and bioactivity. These directions would strengthen the clinical translation of functionalized graphene-based nanofibers in tissue engineering and regenerative medicine.
4. Author’s Contribution
• Conceptualization – Sankar Thangavel; Kannan Thanneerpanthalpalayam Kandasamy.
• Data curation – Sankar Thangavel; Rajasekar Rathanasamy; Ratchagaraja Dhairiyasamy.
• Formal analysis – Sankar Thangavel; Balakrishnan Nanjappan; Ratchagaraja Dhairiyasamy.
• Funding acquisition – Sankar Thangavel; Kannan Thanneerpanthalpalayam Kandasamy.
• Investigation – Sankar Thangavel; Rajasekar Rathanasamy; Ratchagaraja Dhairiyasamy.
• Methodology – Sankar Thangavel; Kannan Thanneerpanthalpalayam Kandasamy.
• Project administration – Sankar Thangavel; Rajasekar Rathanasamy.
• Resources – Kannan Thanneerpanthalpalayam Kandasamy; Ratchagaraja Dhairiyasamy.
• Software – Sankar Thangavel; Rajasekar Rathanasamy.
• Supervision – Sankar Thangavel; Kannan Thanneerpanthalpalayam Kandasamy.
• Validation – Rajasekar Rathanasamy; Ratchagaraja Dhairiyasamy.
• Visualization – Sankar Thangavel; Ratchagaraja Dhairiyasamy.
Thangavel, S., Kandasamy, K. T., Rathanasamy, R., & Dhairiyasamy, R.
• Writing – original draft – Sankar Thangavel; Kannan Thanneerpanthalpalayam Kandasamy.
• Writing – review & editing – Sankar Thangavel; Kannan Thanneerpanthalpalayam Kandasamy; Rajasekar Rathanasamy; Ratchagaraja Dhairiyasamy.
The authors sincerely acknowledge the Department of Mechanical Engineering at Paavai College of Engineering, Gnanamani College of Technology, and Kongu Engineering College for their invaluable support and for providing the essential infrastructure and facilities that enabled the successful completion of this research. Gratitude is further expressed to the technical staff and colleagues whose assistance during the electrospinning procedures and material characterization was instrumental to the research efforts.
1 Ruan, K., Guo, Y., Tang, Y., Zhang, Y., Zhang, J., He, M., Kong, J., & Gu, J. (2018). Improved thermal conductivities in polystyrene nanocomposites by incorporating thermal reduced graphene oxide via electrospinning-hot press technique. Composites Communications, 10, 68-72 http://doi.org/10.1016/j. coco.2018.07.003
2 Vergara-Figueroa, J., Alejandro-Martin, S., Cerda-Leal, F., & Gacitúa, W. (2020). Dual electrospinning of a nanocomposites biofilm: potential use as an antimicrobial barrier. Materials Today. Communications , 25 , 101671 . http://doi.org/10.1016/j. mtcomm.2020.101671
3 Garuti, G. L., Freitas, R. R. M., Lima, V. H., Carmo, K. P., Pádua, F. A., & Botaro, V. R. (2024). Nanocellulose reinforced starch biocomposite films via tape-casting technique. Polímeros: Ciência e Tecnologia, 34(1), e20240004 https://doi.org/10.1590/0104-1428.20230084
4 Yin, J., Zhan, F., Jiao, T., Deng, H., Zou, G., Bai, Z., Zhang, Q., & Peng, Q. (2020). Highly efficient catalytic performances of nitro compounds via hierarchical PdNPs-loaded MXene/ polymer nanocomposites synthesized through electrospinning strategy for wastewater treatment. Chinese Chemical Letters, 31(4), 992-995 http://doi.org/10.1016/j.cclet.2019.08.047
5 Manfrinato, M. D., Leite, E. C., Pavani, R. R., Pereira, H. B., Silva, L. C. S. C., & Rossino, L. S. (2024). Welding parameters process study of non-metallic expansion joints polymeric composite. Polímeros: Ciência e Tecnologia, 34(1), e20240002 https://doi.org/10.1590/0104-1428.20230004
6 Diaa, B. M., & Jaafar, H. T. (2017). Superhydrophobic nanocomposites coating using electrospinning technique on different materials. International Journal of Applied Engineering Research: IJAER, 12(24), 16032-16038. Retrieved in 2025, January 29, from https://www.ripublication.com/ijaer17/ ijaerv12n24_280.pdf
7 Esfahani, H., Darvishghanbar, M., & Farshid, B. (2018). Enhanced bone regeneration of zirconia-toughened alumina nanocomposites using PA6/HA nanofiber coating via electrospinning. Journal of Materials Research, 33(24), 42874295 http://doi.org/10.1557/jmr.2018.391
8 Guo, R., Jiao, T., Xing, R., Chen, Y., Guo, W., Zhou, J., Zhang, L., & Peng, Q. (2017). Hierarchical AuNPs-loaded fe3o4/ polymers nanocomposites constructed by electrospinning with enhanced and magnetically recyclable catalytic capacities. Nanomaterials (Basel, Switzerland), 7(10), 317 http://doi.org/10.3390/nano7100317 PMid:29023427.
9 Guo, Y., Xu, G., Yang, X., Ruan, K., Ma, T., Zhang, Q., Gu, J., Wu, Y., Liu, H., & Guo, Z. (2018). Significantly enhanced and precisely modeled thermal conductivity in polyimide nanocomposites with chemically modified graphene: via in situ polymerization and electrospinning-hot press technology. Journal of Materials Chemistry. C, Materials for Optical and Electronic Devices, 6(12), 3004-3015 http://doi.org/10.1039/ C8TC00452H
10 Huang, X., Wang, R., Jiao, T., Zou, G., Zhan, F., Yin, J., Zhang, L., Zhou, J., & Peng, Q. (2019). Facile Preparation of Hierarchical AgNP-Loaded MXene/Fe3O4/Polymer Nanocomposites by Electrospinning with Enhanced Catalytic Performance for Wastewater Treatment. ACS Omega, 4(1), 1897-1906 http://doi.org/10.1021/acsomega.8b03615 PMid:31459444.
11. Liu, Y., Hou, C., Jiao, T., Song, J., Zhang, X., Xing, R., Zhou, J., Zhang, L., & Peng, Q. (2018). Self-assembled AgNPcontaining nanocomposites constructed by electrospinning as efficient dye photocatalyst materials for wastewater treatment. Nanomaterials (Basel, Switzerland) , 8(1), 35 http://doi.org/10.3390/nano8010035. PMid:29320426.
12 Lyu, J.-Y., Chen, S., He, W., Zhang, X.-X., Tang, D.-Y., Liu, P.-J., & Yan, Q.-L. (2019). Fabrication of high-performance graphene oxide doped PVDF/CuO/Al nanocomposites via electrospinning. Chemical Engineering Journal, 368, 129-137. http://doi.org/10.1016/j.cej.2019.02.170
13 Meng, N., Zheng, Y., & Xin, B. (2018). Fabrication and characterization of graphene enriched polysulfon amide nanocomposites by electrospinning system. Fibers and Polymers, 19(2), 357-363 http://doi.org/10.1007/s12221-018-7888-6
14 Song , Y. , Xu , L. , & Sui , J. ( 2019 ). Fabrication and characterization of magnetic nanocomposites by electric fields assisted electrospinning. Thermal Science, 23(4), 2365-2372 http://doi.org/10.2298/TSCI1904365S
15 Yoon, H. W., Park, J. Y., Park, N. K., Won, J. C., Kim, Y. H., & Kang, Y. Y. (2017). Preparation and characterization of BaTiO3/polyimide composite nanofibers and nanocomposites via electrospinning with enhanced dielectric properties. Porrime, 41(6), 978-983 http://doi.org/10.7317/pk.2017.41.6.978
16 Scaffaro, R., Gammino, M., & Maio, A. (2022). Wet electrospinningaided self-assembly of multifunctional GO-CNT@PCL coreshell nanocomposites with spider leg bioinspired hierarchical architectures. Composites Science and Technology, 221, 109363 http://doi.org/10.1016/j.compscitech.2022.109363
17 Akturk, A., Taygun, M. E., & Goller, G. (2020). Optimization of the electrospinning process variables for gelatin/silver nanoparticles/bioactive glass nanocomposites for bone tissue engineering. Polymer Composites, 41(6), 2411-2425 http://doi.org/10.1002/pc.25545.
18 Yang, L., Zhang, L., & Li, C. (2020). Bridging boron nitride nanosheets with oriented carbon nanotubes by electrospinning for the fabrication of thermal conductivity enhanced flexible nanocomposites. Composites Science and Technology, 200, 108429 http://doi.org/10.1016/j.compscitech.2020.108429
19 Yang, F., Yu, X., Liu, Z., Niu, J., Zhang, T., Nie, J., Zhao, N., Li, J., & Yao, B. (2021). Preparation of Z-scheme CuBi2O4/ Bi2O3 nanocomposites using electrospinning and their enhanced photocatalytic performance. Materials Today. Communications, 26, 101735 http://doi.org/10.1016/j.mtcomm.2020.101735
20 Schiefferdecker, V. M., Barra, G. M. O., Ramôa, S. D. A. S., & Merlini, C. (2019). Comparative study of the structure and properties of poly(vinylidene fluoride)/montmorillonitepolypyrrole nanocomposites prepared by electrospinning and solution casting. Frontiers in Materials, 6, 193 http://doi. org/10.3389/fmats.2019.00193.
21 Chang, S., Wang, M., Zhang, F., Liu, Y., Liu, X., Yu, D.-G., & Shen, H. (2020). Sheath-separate-core nanocomposites
Optimizing graphene-enhanced polycaprolactone nanofibers for superior biomedical properties
fabricated using a trifluid electrospinning. Materials & Design, 192, 108782 http://doi.org/10.1016/j.matdes.2020.108782
22. Barbosa, M. C., Razzino, C. A., Stocco, T. D., Santana, M. V., Ghosh, A., Pereira, L. F., Tierra-Criollo, C. J., & Lobo, A. (2022). Production of rGO-based electrospinning nanocomposites incorporated in recycled PET as an alternative dry electrode. Polymers, 14(20), 4288 http://doi.org/10.3390/polym14204288 PMid:36297865.
23 Abid, M., Sayegh, S., Iatsunskyi, I., Coy, E., Lesage, G., Ramanavicius, A., Ben Haj Amara, A., & Bechelany, M. (2022). Design of halloysite-based nanocomposites by electrospinning for water treatment. Colloids and Surfaces. A, Physicochemical and Engineering Aspects, 651, 129696 http://doi.org/10.1016/j. colsurfa.2022.129696
24 Souza, N. L. G. D., Cavallini, G. S., Alves, T. T., Pereira, M. M., Brandão, H. M., & Oliveira, L. F. C. (2024). Compatibility and cytotoxicity of poly(ε-caprolactone)/ polypyrroleblock-poly(ε-caprolactone) blend films in fibroblast bovine cells. Polímeros: Ciência e Tecnologia, 34(1), e20240007 https://doi.org/10.1590/0104-1428.20230082
25. Canales, D., Moyano, D., Alvarez, F., Grande-Tovar, C. D., Valencia-Llano, C. H., Peponi, L., Boccaccini, A. R., & Zapata, P. A. (2023). Preparation and characterization of novel poly (lactic acid)/calcium oxide nanocomposites by electrospinning as a potential bone tissue scaffold. Biomaterials Advances, 153, 213578 http://doi.org/10.1016/j.bioadv.2023.213578 PMid:37572597.
26 Özcan, M., Kaya, C., & Kaya, F. (2023). Cosmic radiation shielding property of boron reinforced continuous fiber nanocomposites produced by electrospinning. Discover Nano, 18(1), 152 http:// doi.org/10.1186/s11671-023-03940-3 PMid:38078987.
27 Zhang, J., Jia, G., Wang, J., Kong, H., Li, H., & Zhang, C. (2022). Hollow chain-like SiO2/ZnO nanocomposites: electrospinning synthesis, defect-related luminescence, and applications for drug delivery. Colloids and Surfaces. A, Physicochemical and Engineering Aspects, 647, 129139 http://doi.org/10.1016/j. colsurfa.2022.129139
28 Alkelaby, A. S., Ahmadi, M. T., Esmaeili, A., Sedghi, H., & Abass, K. H. (2024). Fabricate of one-dimensional structure poly (vinyl alcohol)- polyethylene glycol: calcium fluoride nanocomposites via electrospinning technique: characterization and antibacterial application. Polymer Bulletin, 81(18), 1737717391 http://doi.org/10.1007/s00289-024-05503-7
29 Chaji , A. , Sajjadi , S. A. , & Darband , G. B. ( 2024 ). Electrochemical efficiency of carbon nanofiber/molybdenum oxide nanocomposites synthesized by electrospinning used in supercapacitors and oxygen evolution reaction. Journal of Electroanalytical Chemistry (Lausanne, Switzerland), 965, 118368 http://doi.org/10.1016/j.jelechem.2024.118368
30. Wu, C.-S., Wu, D.-Y., & Wang, S.-S. (2023). Nanocomposites of Bio-Base Polyester Containing Natural Hydroxyapatite and Duck Eggshell Made by Electrospinning: fabrication and Characterization. Journal of Polymers and the Environment, 31(2), 519-532 http://doi.org/10.1007/s10924-022-02558-3
31 Thirumalvalavan, S., Perumal, G., Senthilkumar, N., & Selvarasu, S. (2025). Enhancing Tribological Characteristics of Titanium Grade-5 Alloy through HVOF Thermal-Sprayed WC-Co Nano Coatings by TOPSIS and Golden Jack Optimization Algorithm. Recent Patents on Nanotechnology, 19(4), 544-567 http://doi.org/10.2174/0118722105306841240808092616. PMid:39171599.
32 Raja, K., Bejaxhin, A. B. H., Jayaprakash, G., Gopi Krishnan, P., & Ramanan, N. (2025). Microstructural and mechanical analysis of achieving crack-free joints in high-speed friction stir spot welding of Cu–Al dissimilar material. International Journal on Interactive Design and Manufacturing, 19(1), 325-336 http://doi.org/10.1007/s12008-024-01747-9
33 Luna, P. B. F. G. S., Caetano, V. F., Andrade, M. F., Silva, I. D. L., Araújo, T. L., Souza, K. C., Almeida, Y. M. B., & Vinhas, G. M. (2024). Effect of thyme essential oil on the properties of poly (butylene adipate-co-terephthalate) (PBAT). Polímeros: Ciência e Tecnologia, 34(1), e20240005. https://doi.org/10.1590/0104-1428.20230009.
34 Venkatesh, R., Hossain, I., Mohanavel, V., Soudagar, M. E. M., Ali Alharbi, S., & Al Obaid, S. (2025). Enriching performance of Al-Mg composites by incorporating nano-alumina and SiC via semi-solid stir processing. International Journal of Cast Metals Research, 38(1), 50-60 http://doi.org/10.1080/13640461.2025. 2476826
35 Alves, M. C. C., Oliveira, R. N., Oliveira, G. F., Ferreira, T. P., Middea, A., Tavares, M. I. B., Sabença, H., Gomes, B. T., Rosado, L. H. G., Scott, F. B., & Cid, Y. P. (2024). Pyriproxyfen-based Rumino-Reticulum Device for horn fly control in cattle: development and characterization. Polímeros: Ciência e Tecnologia, 34(2), e20240019 https://doi.org/10.1590/0104-1428.20230079
36 Hacen, D., Abdallah, M., Ali, A., Mohamed, K., Rafik, S. M., Idris, S. A., & Mahariq, I. (2025). Entropy Generation and Thermal Performance Analysis of MHD Ternary Hybrid Nanofluid Jeffery–Hamel Flow Under Heat Generation/ Absorption. Advanced Theory and Simulations, 8(7), 240120 http://doi.org/10.1002/adts.202401120.
37. Ramu, S., Senthilkumar, N., & Deepanraj, B. (2025). Twophase Hybrid Thermal Interface Alkali-treated E-Glass Fiber/MWCNT/Graphene/Copper Oxide Nanocomposites for Electronic Gadgets. Recent Patents on Nanotechnology, 19(4), 511-523 http://doi.org/10.2174/01187221052967252 40308094344 PMid:38797904.
38 Macedo, M. C. C., Silva, V. D. M., Rodrigues, C. G., Pereira, D. T. V., Garcia, M. A. V. T., Pires, C. V., & Fante, C. A. (2025). Valorization of passion fruit: development, characterization and optimization of biodegradable edible films. Polímeros: Ciência e Tecnologia, 35(1), e20250002. https://doi.org/10.1590/01041428.20240043
39 Thanikodi, S., Giri, J., Ramesh, P. T., Jagadeesan, A. K., & Saravanan, R. (2025). Optimization of friction stir processing to improve the mechanical properties of bone fixation plate inputs made of ZK60 magnesium alloy. International Journal of Advanced Manufacturing Technology, 136(1), 297-314 http://doi.org/10.1007/s00170-024-14002-y
40 Rodrigues, A. O., Fornazaro, G., Silva, G. V. A., Radovanovic, E., Santos, A., Nascimento, H. M., Pereira, A. G. B., & Favaro, S. L. (2024). Modelling hydration effect on the mechanical performance of polyamide 6.6/glass fibers composites. Polímeros: Ciência e Tecnologia , 34 ( 4 ), e20240039 https://doi.org/10.1590/0104-1428.20240046
41 Ross, N. S., Mashinini, P. M., Vinayagamoorthy, D., Rai, R., Sivaraman, V., Ananth, B. J., Kumar, D. S., & Gupta, M. K. (2025). Performance evaluation of cutting fluids formulated with recycled toner waste and rice bran oil in sustainable machining of LMD processed Ti64 alloy. International Journal of Precision Engineering and Manufacturing - Green Technology, 12(1), 151-167 http://doi.org/10.1007/s40684-024-00640-w
42 Souza, P. S., Sousa, A. M. F., & Silva, A. L. N. (2024). Effect of process parameters on the properties of LDPE/ sepiolite composites. Polímeros: Ciência e Tecnologia, 34(2), e20240015 https://doi.org/10.1590/0104-1428.20230059
Received: Jan. 29, 2025
Revised: May 11, 2025
Accepted: Jul. 15, 2025
Editor-in-Chief: Sebastião V. Canevarolo
Daniel Magalhães da Cruz1,2* , Marcelo de Ávila Barreto2,3 , Larissa Basei Zangalli2 , Felipe Tempel Stumpf1 , Carlos Eduardo Marcos Guilherme3 , Ivan Napoleão Bastos4 and Ana Lúcia Nazareth da Silva5,6
1Grupo de Mecânica Aplicada – GMAp, Programa de Pós-graduação em Engenharia Mecânica – PROMEC, Universidade Federal do Rio Grande do Sul – UFRGS, Porto Alegre, RS, Brasil
2Tecnofibers Desenvolvimento e Tecnologia Ltda., Itajaí, SC, Brasil
3Laboratório de Análise de Tensões Policab, Programa de Pós-graduação em Engenharia Mecânica – PPMec, Universidade Federal do Rio Grande – FURG, Rio Grande, RS, Brasil
4Laboratório de Corrosão – LabCor, Instituto Politécnico da Universidade do Estado do Rio de Janeiro – IPRJ, Universidade do Estado do Rio de Janeiro – UERJ, Nova Friburgo, RJ, Brasil
5Instituto de Macromoléculas Professora Eloisa Mano – IMA, Universidade Federal do Rio de Janeiro – UFRJ, Rio de Janeiro, RJ, Brasil
6Programa de Engenharia Ambiental – PEA, Universidade Federal do Rio de Janeiro – UFRJ, Rio de Janeiro, RJ, Brasil
*daniel.cruz@ufrgs.br
* This paper has been partially presented at the 17th Brazilian Polymer Congress, held in Joinville, SC, 29/Oct - 02/Nov/2023.
Obstract
Polyester (polyethylene terephthalate, PET) and high-modulus polyethylene (HMPE) fibers are currently among the most commonly used materials in the manufacturing of ropes for offshore operations. Several studies have been conducted in analytical, experimental, and numerical domains, addressing various factors such as tensile tests, fatigue, creep, and environmental exposure conditions that influence their mechanical behavior. This work presents data from an experimental study on rupture resistance in semi-finished products (rope yarns) of PET and HMPE fibers subjected to different ultraviolet (UV) radiation exposure durations. The experimental procedure involved UV exposure for up to 84 days, followed by tensile rupture tests based on ISO 2062. The results showed that UV degradation occurs in a monotonic manner for PET, whereas HMPE exhibits relative stability for rope yarns.
Keywords: experimental characterization, offshore applications, polymeric fibers, strength at break, ultraviolet degradation.
Data Ovailability: Research data is available upon request from the corresponding author
How to cite: Da Cruz, D. M., Barreto, M. A., Zangalli, L. B., Stumpf, F. T., Guilherme, C. E. M., Bastos, I. N., & Silva, A. L. N. (2025). UV exposure analysis on mechanical resistance of rope yarns for offshore mooring. Polímeros: Ciência e Tecnologia, 35(4), e20250043.
The adoption of polymeric fibers in offshore mooring systems began in the 1990s with Del Vecchio’s pioneering proposal to replace steel lines with synthetic ropes[1]. This shift enabled the transition from catenary to Taut-Leg systems, offering benefits such as lower weight, easier installation, improved dynamic response, greater corrosion resistance, and more efficient offshore deployment[2-7] . Since then, polymeric fibers have evolved from an alternative to a key component in offshore mooring and other marine applications[8-10] .
Polyester (PET) is the most widely used fiber in mooring ropes, valued for its mechanical performance, ease of
processing, dimensional stability, recyclability, and especially its low cost[5,10-13]. Its broad availability and industrial maturity also reinforce its dominance[14]. However, growing offshore demands have driven the adoption of alternative fibers such as polyamide, aramid, and high-modulus polyethylene (HMPE)[9,10,15,16] .
Each fiber has found its niche in specific applications: polyamide, with high energy absorption, is used in shallow-water mooring and Single Point Moorings (SPM)[17-19]; aramid and HMPE, with high specific strength, are common in nautical ropes, towing lines, and structural offshore components requiring lightness and strength[20-22]
Da Cruz, D. M., Barreto, M. A., Zangalli, L. B., Stumpf, F. T., Guilherme, C. E. M., Bastos, I. N., & Silva, A. L. N.
In permanent offshore mooring, HMPE has recently gained attention as an alternative to polyester, due to its low elongation (suitable for deeper waters), high tensile strength, and tenacity—classifying it as a high-performance fiber[23-26]. The development of low-creep HMPE and advances in production (reducing costs) further boost its offshore potential[27,28] .
Beyond mechanical performance, the durability of synthetic fibers in marine environments is crucial for their selection and use. Alongside static and cyclic loads, environmental factors like abrasion, temperature changes, seawater immersion, and ultraviolet (UV) radiation can significantly impact long-term fiber integrity[29-33]. UV exposure is especially critical in top-line regions, where direct sunlight accelerates degradation and reduces mechanical properties[34-36] .
Several studies have investigated the effects of UV radiation on synthetic fibers used in different applications, analyzing parameters such as mass loss, morphological changes, and tensile strength reduction. Said et al.[37] examined Ultra Long Duration Balloons (ULDB), where films act as gas barriers and fiber tendons provide structural strength. Their results showed significant strength loss in most fibers after UV exposure, except for Spectra®, which exhibited superior stability. Flory and Banfield[38] focused on synthetic ropes in offshore environments, addressing myths and facts about sunlight-induced degradation. They found LCP fibers highly sensitive to UV, while polyester and HMPE showed greater stability. The study also noted that rope color affects UV susceptibility and that larger-diameter ropes tend to suffer less UV damage than thinner ones.
Sørensen et al.[39] examined UV degradation in natural and synthetic microfibers, including combined effects of UV and seawater exposure. Polyamide showed notable surface changes without fragmentation, while PET and wool exhibited both surface damage and fragmentation, indicating chain scission. Da Cruz et al.[40] evaluated UV effects on the tensile strength of multifilaments used in offshore mooring. After up to 28 days of exposure, polyamide and polyester showed high stability, aramid and HMPE moderate degradation, and LCP significant mechanical loss. Del Vecchio et al.[41] investigated replacing top chains with synthetic ropes in mooring systems, noting that UV effects must be considered near the surface. Braided covers with internal filters offered effective protection, though small-diameter ropes with thinner layers allowed greater UV penetration.
In this context, the present study proposes an experimental approach to analyze UV aging in synthetic rope yarns—twisted but unbraided structures one level above multifilaments in the mooring rope hierarchy, as shown in Figure 1[42]. This setup facilitates understanding mechanical behavior under UV exposure and comparing fiber types. HMPE and PET samples underwent Type A ultraviolet exposure cycles for up to 84 days under controlled lab conditions. After exposure, standardized rupture tests assessed breaking strength, while stress-strain and tangent modulus curves were also obtained.
With this approach, the study aims to improve understanding of UV radiation effects on synthetic fibers used in offshore mooring, providing technical insights for selecting, sizing, and predicting the service life of ropes in harsh environments.

The comparative results between materials, along with their agreement or divergence from existing literature, may also guide future research.
2.1 Fiber information and rope yarn construction
The materials tested for ultraviolet aging were semi-finished products (SFP) or rope yarns made from high-modulus polyethylene (HMPE) and polyester (PET) fibers. For HMPE, 7 yarns with a linear density of 1760 dtex, each containing 480 filaments, were used; the manufacturer yarn code is JX99 1600D/480f. For PET, 19 yarns with a linear density of 2200 dtex, each with 192 filaments, were used; the manufacturer yarn code is SFS5202 2200dtex/192f.
The rope yarns were twisted to a ratio of 60 turns per meter for both HMPE and PET samples, using industrial rope-making twist equipment. These semi-finished products are commercial-grade constructions typically employed as protective jackets in offshore mooring ropes. The selected configurations (7 HMPE yarns and 19 PET yarns), were chosen to produce similar rope yarn diameters compatible with the twisting process for both materials, while also maintaining a comparable total filament count (3360f for HMPE and 3648f for PET). This balance ensured consistent manufacturability and handling during fabrication. Due to confidentiality agreements with the supplier, the manufacturer’s name and the specific twisting apparatus cannot be disclosed, although the provided twist density enables reproduction of the rope yarn structure.
Semi-finished products, or rope yarns, are made from multifilaments drawn from untwisted spools and come with a manufacturer-provided test report, as shown in Table 1 Figure 2 displays the single multifilament spools for HMPE and PET, along with coils of the final rope yarn samples for both fibers
Both fibers studied are intended for offshore use but differ significantly in cost: HMPE at approximately 17.50 USD/kg and PET at 3.20 USD/kg. The test report at the multifilament level (Table 1) show elongation values consistent with literature[15,16,40,43,44], with HMPE rupture strain below 4% and PET rupture strain between 11% and 14%. Linear tenacity values in Table 1 are also notable.
UV exposure analysis on mechanical resistance of rope yarns for offshore mooring


Table 1. Test report results for single yarns used in constructions of rope
HMPE results comply with ISO 18692-3[45], which requires a minimum linear tenacity of 2.5 N/tex. And PET values meet ISO 18692-2[46], specifying a minimum linear tenacity of 0.78 N/tex.
UV exposure tests were conducted at the Polytechnic Institute of the State University of Rio de Janeiro in Nova Friburgo. A Q-Lab UVA-340 ultraviolet lamp[47] was used, simulating sunlight in the critical short-wavelength range of 295-365 nm, peaking at 340 nm with irradiance between 0.68-0.89 W/m2/nm (Figure 3a[47]). Five rope yarn samples were tested for each UV exposure condition.
The sample holder and sample length are shown in Figure 3b. Areas outside the analysis region were covered with aluminum foil to block UV radiation. Figure 3c depicts the UV exposure setup, with the lamp positioned 150 mm from the samples. Exposure times were 0 (without exposure), 14, 28, 42, 56, 70, and 84 days. Samples were rotated halfway
Table 2. Ultraviolet exposure times: withdraw and rotation samples, HMPE and PET.
(dd/mm/yyyy)
0 10/05/2022 Sampes without exposure 7 17/05/2022 Rotation 14 days 14 24/05/2022 Withdraw 14 days & rotation 28 days 21 31/05/2022 Rotation 42 days 28 07/06/2022 Withdraw 28 days & rotation 56 days 35 14/06/2022 Rotation 70 days
42 21/06/2022 Withdraw 42 days & rotation 84 days
56 05/07/2022 Withdraw samples 56 days
70 19/07/2022 Withdraw samples 70 days
84 02/08/2022 Withdraw samples 84 days
through each exposure period to ensure uniform irradiation, as detailed in Table 2
Da Cruz, D. M., Barreto, M. A., Zangalli, L. B., Stumpf, F. T., Guilherme, C. E. M., Bastos, I. N., & Silva, A. L. N.
Mechanical characterization of the rope yarns was performed at the Policab Stress Analysis Laboratory, Federal University of Rio Grande, Brazil. Tensile strength tests covered all seven UV exposure conditions in Table 2 and followed ISO 2062[48]. Samples were 2500 mm long for handling and gripping (Figure 4a), with an effective gauge length of 250 mm between grips. For each UV condition, 5 specimens twisted at 60 turns per meter were tested to rupture using Instron 8801 servohydraulic testing machine (Figure 4b), recording force [N] and strain [%] continuously. A constant extension rate of 250 mm/min was applied until break.
An additional set of unexposed specimens (10 per material) was tested for linear density ( Lρ ) per ASTM D1577[49] using a precision balance (Figure 4c). This allowed calculation of linear tenacity values for HMPE and PET without UV exposure. All mechanical tests after UV exposure were conducted under ISO 139[50] standard temperature and humidity conditions. Figure 4d shows an SFP specimen mounted in the testing machine before rupture.
Before analyzing and interpreting the experimental results, appropriate filtering and statistical tests were applied to improve data reliability and consistency[51]. This step minimizes the influence of outliers and strengthens the robustness of the study’s conclusions. In experiments involving synthetic polymeric fibers, statistical treatment is especially important due to the inherent variability linked to their viscoelastic behavior[52]. Nevertheless, Boiko et al.[53] note that, under controlled conditions, many of these materials tend to show an approximately normal distribution in their mechanical response.
Thus, individual data points for rupture force and strain were filtered using the statistical software Orange[54], applying outlier detection via boxplot analysis, the Ryan-Joiner normality test, Levene’s test for homogeneity of variance, and one-way ANOVA. All tests were performed with a significance level of 0.05 α = , indicating a probability of incorrectly rejecting the null hypothesis ( 0 H ), which corresponds to a Type I error.
With the filtered data following ultraviolet exposure, the initial analysis presents raw rupture force and strain values plotted against UV exposure time. Normalized values, relative to the unexposed condition, are also considered. To model the behavior of rupture force or strain over time, mathematical fitting using linearization and the method of least squares (MLS)[55] are applied, with the coefficient of determination serving as the criterion for model selection.
Beyond rupture data, the full constitutive behavior during tensile testing is captured in terms of force and strain. To represent this, a stress-strain curve is constructed. However, directly applying the conventional stress definition (force over cross-sectional area) is impractical due to the difficulty in accurately measuring the area of fiber bundle. Instead, a mathematical approach from the literature[40 56] is used, where stress (σ) is calculated from rupture force ( F ), linear density ( Lρ ), and material density (ρ), as shown in Equation 1.
From the constitutive stress-strain curves, the tangent modulus curve ( Et ) can be derived by calculating the first derivative of stress with respect to strain, as shown in Equation 2. This parameter represents the instantaneous stiffness of the material at a given strain level. In addition to the complete curve profile, particular attention is given to extracting the maximum tangent modulus ( Etmax ) along the curve and the tangent modulus at the rupture point ( Etrup
From the same constitutive stress-strain data, the secant modulus ( Es) can be calculated, defined as the slope of a straight line connecting the origin to a specific point of the stress-strain curve, as expressed in Equation 3. This parameter provides a measure of the mean stiffness of the material up to the chosen strain level.

UV exposure analysis on mechanical resistance of rope yarns for offshore mooring
The data were filtered using boxplot analysis, resulting in the exclusion of 6 out of 140 individual rupture data points (≈4.3%). All groups demonstrated normal distribution and homogeneity of variance. The ANOVA tests further confirmed the findings that will be discussed later regarding the rupture force and strain after UV exposure in the HMPE and PET.
The mean values of rupture force and rupture strain for each UV exposure time, along with their respective standard deviations, are presented in Table 3 for HMPE and
PET. The same data are graphically represented in Figure 5 for HMPE and in Figure 6 for PET, allowing for a clearer visualization of the effects of UV exposure on the rupture force and rupture strain.
Table 3 shows that both fibers reach their highest rupture force in the unexposed condition. Figure 5 and Figure 6 highlight distinct behaviors under UV exposure: polyester exhibits a progressive decline in both rupture force and strain, while high-modulus polyethylene shows no statistically significant change.
To further interpret the data, values were normalized against the unexposed condition (0 days), enabling the calculation of percentage reductions for each exposure duration.


Da Cruz, D. M., Barreto, M. A., Zangalli, L. B., Stumpf, F. T., Guilherme, C. E. M., Bastos, I. N., & Silva, A. L. N.
Normalized results reinforce the contrasting UV responses of HMPE and PET rope yarns. PET shows a monotonic decline in rupture force and strain, with reductions of 38.27% and 42.49%, respectively, after 84 days of exposure. HMPE, on the other hand, reaches its lowest values at 70 days, but with more moderate reductions: 15.88% in force and 7.38% in strain relative to the unexposed condition.
The experimental results reveal an unexpected behavior in HMPE rope yarns subjected to ultraviolet exposure, with upward fluctuations in mean rupture force and mean rupture strain even at longer exposure durations (Figure 5), contradicting the typical progressive degradation trend expected for these materials. These apparent gains occur within the overlap of standard deviations and were not statistically significant according to the applied tests (analysis of variance and post-hoc multiple comparison), suggesting they may stem from experimental scatter and intrinsic material variability.
At the same time, the trends suggested by the mean values cannot be overlooked. Possible hypotheses—requiring comparison with recent literature—include UV-induced surface crosslinking, relaxation of internal stresses, molecular rearrangement during exposure, minor moisture absorption effects, environmental fluctuations affecting mechanical response, and microstructural reorientation of fibers under combined effects[57-59]. In this context, the use of UV radiation for polymerization is well established under specific conditions. Decker[60] describes several UV-curing technologies, emphasizing kinetic aspects of ultrafast polymerization; Yin et al.[61] report improved mechanical properties in thermoplastic starch optimized by UV irradiation under wettability and hygroscopic conditions. For ultra-high molecular weight polyethylene (UHMWPE), Verma et al.[62] and Dong et al.[63] demonstrate mechanical enhancements from UV crosslinking, with indications of crystal packing formation and fiber shrinkage due to molecular disorientation. As crosslinking restricts molecular mobility, it can yield improved strength even after extended exposure.
Conversely, other studies report degradation consistent with the expected monotonic loss from UV aging, as seen in PET rope yarns results in the present study (Figure 6) and in Ainali et al.[64], that show UV-B irradiation reduces plasticity and causes gradual embrittlement. This contrast suggests that
for HMPE, UV radiation may promote crosslinked structures via radiation energy absorption, bond scission, free radical generation, and subsequent new bond formation, altering molecular architecture and mechanical response. For PET, by contrast, results indicate no significant crosslinking, instead showing a gradual strength reduction without HMPE-like fluctuations. These considerations, although derived from mechanical results for HMPE and PET rope yarns, may guide future research across structural scales in offshore mooring systems, especially when physicochemical aspects of UV exposure are accounted for.
Curve fitting used only mean values and a literature-based script[55] testing linear, power, exponential, reciprocal, and Michaelis-Menten models. Using the coefficient of determination ( 2 R ) to select the best fit, all graphs favored the linear model. For PET rope yarns, linear fitting showed good 2 R for both rupture force and strain. In contrast, HMPE’s linear fit had a notably low 2 R despite being the best among the tested models.
For HMPE rope yarns, the rupture force fit yielded 2 0.625 R ≅ (Equation 4), while rupture strain showed a low 2 0.116 R ≅ (Equation 5). Both fitted models, alongside experimental data, are plotted in Figure 7
For PET rope yarn samples, the fitted models performed excellently ( 2 (0.9 R > ). Rupture force achieved 2 0.994 R ≅ (Equation 6), and rupture strain 2 0.928 R ≅ (Equation 7). Both models and their experimental data are shown in Figure 8.
Due to the poor fit for HMPE, the equation coefficients lack interpretative value. In contrast, the strong fits for PET (high 2 R ) make the slope coefficients reliable indicators of degradation rates: rupture force declines by ≈13 N/day, and rupture strain by ≈0.24%/day.

UV exposure analysis on mechanical resistance of rope yarns for offshore mooring


3.2
The rupture data in Section 3.1 refer to the final break point. However, as shown in Figure 5 and Figure 6, the force-strain curve shapes differ between HMPE and PET. Thus, plotting the full constitutive curve is relevant, as UV exposure may affect the material’s behavior throughout the rupture process.
The constitutive curve, stress-strain terms, relies on stress calculations from Equation 1, which require fiber density—0.97 g/cm3 for HMPE and 1.38 g/cm3 for PET[10 15 40]—and linear density. For this reason, linear density tests were conducted. Combined with unexposed condition results, they provide the reference tenacity values listed in Table 4 for rope yarns.
Each UV exposure condition includes five rupture curves per material. However, aligning multiple experimental curves is challenging—particularly when computing pointwise first derivatives, which can introduce noise or discontinuities.
Thus, a representative curve was selected for each condition and smoothed to reduce noise while preserving the constitutive behavior during rupture.
Figure 9a shows the constitutive curves for HMPE rope yarns under each UV exposure condition, while Figure 9b presents the corresponding curves for PET rope yarns.
The constitutive graphs represent raw experimental curves, which explains the visible oscillations—particularly in the PET curves (Figure 9b). Despite the reduction in rupture properties over time, PET yarns show nearly identical constitutive behavior across conditions, suggesting UV exposure primarily limits the extent of an otherwise consistent response. In contrast, HMPE curves show more variability, with some overlapping and others diverging significantly across exposure times in stress-strain behavior.
A notable aspect under constant extension rate loading is the material response at the multifilament level: HMPE typically shows near-linear behavior, while PET displays
Da Cruz, D. M., Barreto, M. A., Zangalli, L. B., Stumpf, F. T., Guilherme, C. E. M., Bastos, I. N., & Silva, A. L. N.
initial curvature and changes along the stress-strain curve—consistent with literature reports[10,15,65]. However, in the curves obtained here, PET appears more linear and responsive than HMPE. In Figure 9b, PET shows only slight curvature near 50 MPa (≈5% of its ultimate stress), whereas HMPE (Figure 9a) exhibits a broader initial curvature extending to 400-500 MPa (≈20% of its ultimate stress).
3.3 Construction of tangent modulus curves and secant modulus curves
Despite smoothing, some variation is expected in the tangent modulus curves due to oscillations in the constitutive data. The goal is to analyze how the tangent modulus behaves across different regions of the curve. Using Equation 2, the tangent modulus is computed via numerical differentiation of the discrete experimental data, as shown in Equation 8, where Etk is the tangent modulus at the k -th data point, kσ and 1 kσ + are the stress values at points k and 1 k + , respectively, and kε and 1 kε + are the corresponding strain values. The index k refers to the position of the data point along the experimental curve.
Figure 10a shows the tangent modulus curves for HMPE rope yarns under each UV exposure condition, while Figure 10b presents the corresponding curves for PET rope yarns.
Figure 10 shows that HMPE’s tangent modulus values are about four times higher than PET’s. PET curves also
exhibit greater oscillation, likely due to partial filament breaks causing small drops and recoveries from stress redistribution during rupture. For both fibers, the maximum tangent modulus occurs at the curve’s start.
In the central region of HMPE tangent modulus curves (Figure 10a), a clear downward concavity appears across all UV exposures, with minimal noise or oscillation. Conversely, PET curves (Figure 10b) exhibit a generally constant modulus in this region but with significant oscillations, consistent with filament breakages and stress redistribution.
Maximum tangent modulus ( Etmax) and tangent modulus at rupture ( Etrup) were obtained by numerically differentiating discrete stress-strain data. Etmax is the highest derivative value and sensitive to data acquisition frequency, so different sampling rates may affect results. Etrup is calculated between the rupture point and its preceding data point. Table 5 shows these values for both HMPE and PET rope yarns.
The results are inconclusive behaviorally, likely because direct numerical differentiation is sensitive to experimental scatter caused by data acquisition rate and mechanical effects like partial filament breaks and stress redistribution. Future studies should consider alternative methods combining analytical and numerical approaches for adjustments to the tangent modulus analysis.
For the secant modulus curves, it is important to highlight their calculation using Equation 3, which, for a constitutive rupture dataset with k -th terms, takes the form presented in Equation 9, since the secant modulus is computed with respect to the origin ( 00 , σε ).


Accordingly, the secant modulus can be plotted as a function of strain, representing a mean measure of stiffness at each point, which accounts for the entire loading history, given that the calculation incorporates the cumulative stress and strain up to that k -th instant. These secant modulus curves are shown in Figure 11a for all UV exposure conditions of the HMPE rope yarns, and similarly in Figure 11b for the PET rope yarns.
The secant modulus curve was smoothed relative to the experimental data, removing initial points with Es very high values tending toward infinity. Unlike the tangent modulus curves (which represent a measure of instantaneous stiffness between successive data points), the secant modulus curves (representing a mean stiffness) are quite stable, exhibiting minimal noise and a well-defined shape.
When comparing the secant modulus curves across materials, attention is drawn not only to the magnitude scale (HMPE rope yarns showing values approximately six times greater than PET rope yarns) but especially to the curve shape, which remains consistent for each material individually, even under different UV exposure conditions, but differs distinctly between the materials. HMPE rope yarns exhibit a smooth and progressive change in curvature, presenting a maximum secant modulus value that, at times, does not coincide with rupture due to a concavity change in the curve, Figure 11a. In contrast, PET rope yarns display two distinct regimes of monotonic tangent modulus increase: an initial segment with a steeper slope (higher rate) followed by a second segment characterized by a lower secant modulus gain rate (shallower slope), Figure 11b
However, for both HMPE and PET, no clearly defined ordering of the secant modulus curves was observed as a function of UV exposure conditions, except for the non-exposed conditions, which for both materials exhibit behavior distinct from the other curves subjected to UV exposure (regardless of exposure duration).
This study investigated the effects of UV exposure on the mechanical behavior of synthetic rope yarns made of HMPE and PET used in offshore mooring systems.
Using standardized tests, rigorous statistical filtering, and thorough analysis, the rupture force, rupture strain, and constitutive responses were comprehensively assessed. PET yarns showed a clear, monotonic decline in mechanical strength with increasing UV exposure, with strong linear correlations for both rupture force and rupture strain. In contrast, HMPE yarns exhibited only minor variations and no statistically significant degradation, despite some shifts in constitutive behavior.
The constitutive curves and tangent modulus analysis revealed distinct structural responses: PET exhibited more oscillations, likely due to internal filament failures, while HMPE maintained a more stable and consistent behavior. Although direct numerical differentiation offered insights into tangent modulus trends, its limitations suggest the need for refined analytical methods in future studies. Regarding the secant modulus, which represents a mean stiffness throughout the rupture test, the distinct curve shapes and magnitude differences between the two fiber types are noteworthy. However, no clear pattern was identified concerning the UV exposure conditions.
These results confirm HMPE’s superior UV resistance compared to PET at the rope yarn scale—opposite to the typical behavior observed at the multifilament level, where PET is usually more UV stable and HMPE shows slight degradation. These findings, influenced by both UV exposure and sample type, provide valuable data for the design and lifetime assessment of synthetic mooring systems in offshore environments.
Future studies should consider the progression to other structural levels, longer ultraviolet exposure durations, and the inclusion of other fibers such as aramid and polyamide. Additionally, a more in-depth physicochemical analysis is needed to address the hypotheses raised in this work concerning the literature on surface cross-linking induced by UV radiation, which may contribute to mechanical improvement and strength even under prolonged UV exposure conditions (as observed for HMPE rope yarns)
• Conceptualization – Daniel Magalhães Da Cruz; Felipe Tempel Stumpf; Carlos Eduardo Marcos Guilherme; Ivan Napoleão Bastos; Ana Lúcia Nazareth da Silva
Da Cruz, D. M., Barreto, M. A., Zangalli, L. B., Stumpf, F. T., Guilherme, C. E. M., Bastos, I. N., & Silva, A. L. N.
• Data curation – Daniel Magalhães Da Cruz; Marcelo de Ávila Barreto.
• Formal analysis – Daniel Magalhães Da Cruz.
• Funding acquisition – Larissa Basei Zangalli; Carlos Eduardo Marcos Guilherme; Ivan Napoleão Bastos.
• Investigation – Daniel Magalhães Da Cruz; Marcelo de Ávila Barreto; Ivan Napoleão Bastos.
• Methodology – Daniel Magalhães Da Cruz; Larissa Basei Zangalli; Carlos Eduardo Marcos Guilherme; Ivan Napoleão Bastos.
• Project administration – Felipe Tempel Stumpf; Carlos Eduardo Marcos Guilherme; Ivan Napoleão Bastos; Ana Lúcia Nazareth da Silva.
• Resources – Larissa Basei Zangalli; Felipe Tempel Stumpf; Carlos Eduardo Marcos Guilherme; Ivan Napoleão Bastos; Ana Lúcia Nazareth da Silva.
• Software – NA.
• Supervision – Carlos Eduardo Marcos Guilherme; Ivan Napoleão Bastos.
• Validation – Daniel Magalhães Da Cruz; Ivan Napoleão Bastos; Ana Lúcia Nazareth da Silva.
• Visualization – Daniel Magalhães Da Cruz; Ivan Napoleão Bastos; Ana Lúcia Nazareth da Silva.
• Writing – original draft – Daniel Magalhães Da Cruz.
• Writing – review & editing – Daniel Magalhães Da Cruz; Ivan Napoleão Bastos; Ana Lúcia Nazareth da Silva.
6. Acknowledgements
This study was financed in part by the Coordenação de Aperfeiçoamento de Pessoal de Nível Superior – Brasil (CAPES) – Finance Code 001 and Conselho Nacional de Desenvolvimento Científico e Tecnológico – CNPq [307889/2022], as well as the support of other funding agencies: Fundação de Amparo à Pesquisa do Estado do Rio Grande do Sul (FAPERGS), Fundação Carlos Chagas Filho de Amparo à Pesquisa do Estado do Rio de Janeiro (FAPERJ), and Financiadora de Estudos e Projetos (Finep). We are also grateful for the financial support provided by the company Tecnofibers Desenvolvimento e Tecnologia Ltda. The authors also want to express the eternal thanks to Milton Briguet Bastos (in memorian).
7. References
1. Del Vecchio, C. J. M. (1992). Light weight materials for deep water moorings (Doctoral dissertation). University of Reading, Reading
2 Winkler, M. M., & McKenna, H. A. (1995). The polyester rope taut leg mooring concept: a feasible means for reducing deepwater mooring cost and improving stationkeeping performance. In Offshore Technology Conference Houston: OTC http://doi.org/10.4043/7708-MS
3. Ma, W., Huang, K., Lee, M.-Y., Albuquerque, S., & Palazzo, F. G. (1999). On the design and installation of an innovative deepwater taut-leg mooring system. In Offshore Technology Conference Houston: OTC http://doi.org/10.4043/10780-MS
4 Wibner, C., Versavel, T., & Masetti, I. (2003). Specifying and testing polyester mooring rope for the Barracuda and Caratinga
FPSO deepwater mooring systems. In Offshore Technology Conference Houston: OTC http://doi.org/10.4043/15139-MS
5 McKenna, H. A., Hearle, J. W. S., & O’Hear, N. (2004). Handbook of fibre rope technology Sawston: Woodhead publishing http://doi.org/10.1533/9781855739932
6 Flory, J. F. , Banfield , S. J. , & Berryman , C. ( 2007 ). Polyester mooring lines on platforms and MODUs in deep water. In Offshore Technology Conference. Houston: OTC. http://doi.org/10.4043/18768-MS
7 Rossi, R., Del Vecchio, C. J., & Gonçalves, R. C. F. (2010). SS: fiber moorings, recent experiences and research: moorings with polyester ropes in Petrobras: experience and the evolution of life cycle management. In Offshore Technology Conference Houston: OTC. http://doi.org/10.4043/20845-MS
8 Davies, P., Bouquet, P., Conte, M., & Deuff, A. (2006). Tension/torsion behavior of deepwater synthetic mooring lines. In Offshore Technology Conference. Houston: OTC. http://doi.org/10.4043/17872-MS
9 Haach, L. F., Bastos, M. B., & Poitevin, D. T. (2010). Prospects of synthetic fibers for deepwater mooring. In Proceedings of the Rio Oil and Gas Expo and Conference Rio de Janeiro: Instituto Brasileiro de Petróleo, Gás e Biocombustíveis
10 Bastos, M. B., & Silva, A. L. N. (2020). Evaluating offshore rope fibers: impact on mooring systems integrity and performance. In Offshore Technology Conference Houston: OTC. http://doi.org/10.4043/30830-MS
11 Bastos, M. B. (2013). Improved high tenacity/high modulus polyester for stiffer mooring ropes. In 2013 MTS/IEEE OCEANS-Bergen Bergen: Institute of Electrical and Electronics Engineers http://doi.org/10.1109/OCEANS-Bergen.2013.6607949
12 Silva, T. N., Sousa, A. M. F., Silva, A. L. N., Passos, A. A., & Pacheco, E. B. A. V. (2025). Yarn production from the offshore industry mooring rope waste: a circular textile economy opportunity. Journal of Polymers and the Environment, 33(1), 197-209. http://doi.org/10.1007/s10924-024-03414-2.
13 Huang, W. (2026). Research directions in synthetic fiber ropes applied as mooring lines for floating offshore wind turbines. Renewable & Sustainable Energy Reviews, 225, 116183 http://doi.org/10.1016/j.rser.2025.116183
14 El Nemr, A. (2012). From natural to synthetic fibers. In A. El Nemr (Ed.), Textiles: types, uses and production methods (pp. 1-152). New York: Nova Science Publishers
15 Weller, S. D., Johanning, L., Davies, P., & Banfield, S. J. (2015). Synthetic mooring ropes for marine renewable energy applications. Renewable Energy, 83, 1268-1278 http://doi.org/10.1016/j.renene.2015.03.058
16 Da Cruz, D. M., Zangalli, L. B., Barreto, M. A., Silva, A. L. N., & Bastos, I. N. (2024). Offshore mooring challenges for FOWT systems and MRE devices: synthetic fiber solutions for mooring ropes. In ROG.e 2024 Rio de Janeiro: Instituto Brasileiro de Petróleo e Gás http://doi.org/10.48072/25257579.roge.2024.3210
17 Chevillotte, Y., Marco, Y., Bles, G., Devos, K., Keryer, M., Arhant, M., & Davies, P. (2020). Fatigue of improved polyamide mooring ropes for floating wind turbines. Ocean Engineering, 199, 107011 http://doi.org/10.1016/j.oceaneng.2020.107011
18 Sørum, S. H., Fonseca, N., Kent, M., & Faria, R. P. (2023). Assessment of nylon versus polyester ropes for mooring of floating wind turbines. Ocean Engineering, 278, 114339 http://doi.org/10.1016/j.oceaneng.2023.114339
19. Kamizawa, K., Yoshimoto, H., & Chujo, T. (2024). The Field Test of a Shallow-Water Mooring System for FOWT Using Nylon Synthetic Fiber Ropes. In International Conference on Offshore Mechanics and Arctic Engineering. Singapore: The American Society of Mechanical Engineers http://doi.org/10.1115/ OMAE2024-126265
UV exposure analysis on mechanical resistance of rope yarns for offshore mooring
20 Hearle, J. W. S. (Ed.) (2001). High-performance fibres Amsterdam: Elsevier
21 Chi, C.-H., Lundhild, E. M., Veselis, T., & Huntley, M. (2009). Enabling ultra-deepwater mooring with aramid fiber rope technology. In Offshore Technology Conference Houston: OTC http://doi.org/10.4043/20074-MS
22 García, J. M., García, F. C., Serna, F., & de la Peña, J. L. (2010). High-performance aromatic polyamides. Progress in Polymer Science, 35(5), 623-686 http://doi.org/10.1016/j.progpolymsci.2009.09.002
23 Vlasblom, M., Boesten, J., Leite, S., & Davies, P. (2012). Creep and stiffness of HMPE fiber for permanent deepwater offshore mooring. In 2012 Oceans-Yeosu Yeosu: Institute of Electrical and Electronics Engineers http://doi.org/10.1109/ OCEANS-Yeosu.2012.6263399.
24 Ja’e, I. A., Ali, M. O. A., Yenduri, A., Nizamani, Z., & Nakayama, A (2022). Effect of various mooring materials on hydrodynamic responses of turret-moored FPSO with emphasis on intact and damaged conditions. Journal of Marine Science and Engineering, 10(4), 453 http://doi.org/10.3390/jmse10040453
25. Lian, Y., Zhang, B., Ji, J., Pan, Z., Jiang, T., Zheng, J., Ma, G., Zhu, Z., Zhu, Z., & Chen, W. (2023). Experimental investigation on service safety and reliability of full-scale HMPE fiber slings for offshore lifting operations. Ocean Engineering, 285(Part 2), 115447 http://doi.org/10.1016/j.oceaneng.2023.115447
26 Pasternak, J., Fronzaglia, B., Garrity, R., Gilmore, J., & Heyl, C. (2024). Deployment and Testing of HMPE Rope for Long-Term Moorings. In Offshore Technology Conference Houston: OTC http://doi.org/10.4043/35375-MS
27 Bosman, R., Zhang, Q., Leao, A., & Godreau, C. (2020). First class certification on HMPE fiber ropes for permanent floating wind turbine mooring system. In Offshore Technology Conference. Houston: OTC. http://doi.org/10.4043/30475-MS
28 Da Cruz, D. M., Barreto, M. A., Zangalli, L. B., Popiolek, T. L. Jr., & Guilherme, C. E. M. (2023). Experimental study of creep behavior at high temperature in different HMPE fibers used for offshore mooring. In Offshore Technology Conference Brasil Rio de Janeiro: OTC http://doi.org/10.4043/32760-MS
29 Liu, H., Huang, W., Lian, Y., & Li, L. (2014). An experimental investigation on nonlinear behaviors of synthetic fiber ropes for deepwater moorings under cyclic loading. Applied Ocean Research, 45, 22-32. http://doi.org/10.1016/j.apor.2013.12.003.
30 Weller, S. D., Davies, P., Vickers, A. W., & Johanning, L. (2015). Synthetic rope responses in the context of load history: the influence of aging. Ocean Engineering, 96, 192-204 http://doi.org/10.1016/j. oceaneng.2014.12.013
31 Mackay, T., & Ridge, I. M. (2022). Abrasion testing of fibre rope on impermeable fabrics for wave energy converter systems. Renewable Energy, 201(Part 1), 993-1009 http://doi.org/10.1016/j. renene.2022.11.052
32 Li, W., Liu, X., Li, G., Lin, S., Li, H., & Ge, Y. (2023). Temperature and humidity effects on the dynamic stiffness of a polyester mooring rope. Journal of Marine Science and Engineering, 11(1), 91 http://doi.org/10.3390/jmse11010091
33 Da Cruz, D. M., Melito, I., Cruz, A. J. Jr., Bastos, I. N., Silva, A. L. N., Vassoler, J. M., Clain, F. M., & Guilherme, C. E. M. (2024). Assessment of mechanical degradation in polyester fibers for offshore mooring through hydrolysis processes in seawater. Macromolecular Symposia, 413(6), 2400097 http://doi.org/10.1002/masy.202400097
34 Vaseghi, R. (2004). A new method of termination for heavy-duty synthetic rope fibres (Doctoral dissertation). Bournemouth University, Bournemouth
35 Bao, J., Hu, W., Gao, Y., & Lu, Z. (2024). Review of rope coating research: mechanism, application, and future directions. Textile Research Journal, 95(11-12), 1468-1485 http://doi.org/10.1177/00405175241289567
36 Davies, P., Lacotte, N., Fourestier, G., & Petton, I. (2025). Mechanical performance after service of hybrid synthetic mooring lines for weather buoys. Applied Ocean Research, 154, 104366 http://doi.org/10.1016/j.apor.2024.104366
37 Said, M. A., Dingwall, B., Gupta, A., Seyam, A. M., Mock, G., & Theyson, T. (2006). Investigation of ultra violet (UV) resistance for high strength fibers. Advances in Space Research, 37(11), 2052-2058 http://doi.org/10.1016/j.asr.2005.04.098
38. Flory, J. F., & Banfield, S. J. (2011). Fiber rope myths. In OCEANS’11 MTS/IEEE KONA Waikoloa: Institute of Electrical and Electronics Engineers http://doi.org/10.23919/ OCEANS.2011.6106929
39 Sørensen, L., Groven, A. S., Hovsbakken, I. A., Del Puerto, O., Krause, D. F., Sarno, A., & Booth, A. M. (2021). UV degradation of natural and synthetic microfibers causes fragmentation and release of polymer degradation products and chemical additives. The Science of the Total Environment, 755(Pt 2), 143170 http://doi.org/10.1016/j.scitotenv.2020.143170 PMid:33158534.
40 Da Cruz, D. M., Stumpf, F. T., Vassoler, J. M., & Guilherme, C. E. M. (2024). Assessment of the effects of UV-A exposure on the mechanical strength of offshore mooring multifilaments. Acta Polytechnica, 64(6), 487-500 http://doi.org/10.14311/ AP.2024.64.0487
41 Del Vecchio, C., Yan, H., Rieth, D., Gabrielsen, Ø., Menezes, F , Jegannathan, M., Oliveira, A. C., & Gomes, J. (2024). Advances towards replacing top chain with fiber rope for offshore moorings: a Deepstar study. In Offshore Technology Conference Houston: OTC. http://doi.org/10.4043/35339-MS
42 Da Cruz, D. M., Penaquioni, A., Zangalli, L. B., Bastos, M. B., Bastos, I. N., & Silva, A. L. N. (2023). Non-destructive testing of high-tenacity polyester sub-ropes for mooring systems. Applied Ocean Research, 134, 103513 http://doi.org/10.1016/j. apor.2023.103513
43. Belloni, E. S., Clain, F. M., & Guilherme, C. E. M. (2021). Post-impact mechanical characterization of HMPE yarns. Acta Polytechnica, 61(3), 406-414 http://doi.org/10.14311/ AP.2021.61.0406
44 Da Cruz, D. M., Clain, F. M., & Guilherme, C. E. M. (2022). Experimental study of the torsional effect for yarn break load test of polymeric multifilaments. Acta Polytechnica, 62(5), 538-548. http://doi.org/10.14311/AP.2022.62.0538.
45 International Organization for Standardization – ISO. (2020). ISO 18692-3:2020: Fibre ropes for offshore stationkeeping — Part 3: High modulus polyethylene (HMPE). Geneva: ISO. Retrieved in 2025, May 31, from https://www.iso.org/standard/77487.html
46 International Organization for Standardization – ISO. (2019). ISO 18692-2:2019: Fibre ropes for offshore stationkeepingPart 2: Polyester Geneva: ISO. Retrieved in 2025, May 31, from https://www.iso.org/standard/70290.html
47. Q-Lab Corporation. (2006). Technical bulletin LU-8160. Cleveland: Q-Lab Corporation. Retrieved in 2025, May 31, from http://www.q-lab-corporation.ru/doc/QUV-LU-8160_web.pdf
48. International Organization for Standardization – ISO. (2009). ISO 2062:2009: Textiles — Yarns from packages — Determination of single-end breaking force and elongation at break using constant rate of extension (CRE) tester. Geneva: ISO. Retrieved in 2025, May 31, from https://www.iso.org/standard/45642.html
49 American Society for Testing and Materials – ASTM (2018). ASTM D1577-07:2018: standard test methods for linear density of textile fibers. West Conshohocken: ASTM. http://doi.org/10.1520/D1577-07R18
50 International Organization for Standardization – ISO. (2005). ISO 139:2005: Textiles — Standard atmospheres for conditioning and testing. Geneva: ISO. Retrieved in 2025, May 31, from https://www.iso.org/standard/35179.html
Da Cruz, D. M., Barreto, M. A., Zangalli, L. B., Stumpf, F. T., Guilherme, C. E. M., Bastos, I. N., & Silva, A. L. N.
51 John, P. W. M. (1990). Statistical methods in engineering and quality assurance. Hoboken: John Wiley & Sons, Inc. http://doi.org/10.1002/9780470316825
52 Peng, Z., Wang, X., & Wu, Z. (2024). Statistical modeling and reliability analysis of large-scale multi-tendon fiber-reinforced polymer cables. Engineering Structures , 300 , 117226 http://doi.org/10.1016/j.engstruct.2023.117226
53. Boiko, Y. M., Marikhin, V. A., & Myasnikova, L. P. (2023). Tensile strength statistics of high-performance mono-and multifilament polymeric materials: on the validity of normality. Polymers, 15(11), 2529 http://doi.org/10.3390/polym15112529 PMid:37299329.
54 Orange. (2025). Orange: Data mining toolbox in Python. Ljubljana : Orange . Retrieved in 2025, May 31, from https://orangedatamining.com/
55 Da Cruz, D. M., Melito, I., Cruz Júnior, A. J., Sales, M. W. R., Popiolek Júnior, T. L., & Guilherme, C. E. M. (2024). Desenvolvimento de código aberto em Octave para ajustes de funções através de linearização e MMQ. Engineering and Science, 13(1), 1-14 http://doi.org/10.18607/ES20241316896
56. Melito, I., Da Cruz, D. M., Belloni, E. S., Clain, F. M., & Guilherme, C. E. M. (2023). The effects of mechanical degradation on the quasi static and dynamic stiffness of polyester yarns. Engineering Solid Mechanics, 11(3), 243-252 http://doi.org/10.5267/j.esm.2023.4.001
57 Iacopi, F., Travaly, Y., Eyckens, B., Waldfried, C., Abell, T., Guyer, E. P., Gage, D. M., Dauskardt, R. H., Sajavaara, T., Houthoofd, K., Grobet, P., Jacobs, P., & Maex, K. (2006). Short-ranged structural rearrangement and enhancement of mechanical properties of organosilicate glasses induced by ultraviolet radiation. Journal of Applied Physics, 99(5), 053511 http://doi.org/10.1063/1.2178393
58 Scott, T. F., Draughon, R. B., & Bowman, C. N. (2006). Actuation in crosslinked polymers via photoinduced stress relaxation. Advanced Materials, 18(16), 2128-2132 http://doi.org/10.1002/ adma.200600379
59. Ramachandran , D. , & Urban , M. W. ( 2011 ). Sensing macromolecular rearrangements in polymer networks by stimuli-responsive crosslinkers. Journal of Materials Chemistry, 21(23), 8300-8308 http://doi.org/10.1039/c0jm03722b
60 Decker, C. (1998). The use of UV irradiation in polymerization. Polymer International, 45(2), 133-141 http://doi.org/10.1002/ (SICI)1097-0126(199802)45:2<133::AID-PI969>3.0.CO;2-F
61 Yin, P., Chen, C., Ma, H., Gan, H., Guo, B., & Li, P. (2020). Surface cross-linked thermoplastic starch with different UV wavelengths: mechanical, wettability, hygroscopic and degradation properties. RSC Advances, 10(73), 44815-44823 http://doi.org/10.1039/D0RA07549C PMid:35516245.
62 Verma, N., Pathak, H., Keshri, A. K., Prasad, A., & Zafar, S. (2022). Influence of UV exposure on mechanical behavior and cellular compatibility of nano-hydroxyapatite reinforced ultra-high molecular weight polyethylene. Materials Today. Communications , 31 , 103542 . http://doi.org/10.1016/j. mtcomm.2022.103542
63 Dong, T., Niu, F., Qiang, Z., Wang, X., Guo, J., Wang, Y., & He, Y. (2024). Thermal aging behavior and heat resistance mechanism of ultraviolet crosslinked ultra‐high molecular weight polyethylene fiber. Journal of Applied Polymer Science, 141(28), e55648 http://doi.org/10.1002/app.55648
64 Ainali, N. M., Bikiaris, D. N., & Lambropoulou, D. A. (2021). Aging effects on low-and high-density polyethylene, polypropylene and polystyrene under UV irradiation: an insight into decomposition mechanism by Py-GC/MS for microplastic analysis. Journal of Analytical and Applied Pyrolysis, 158, 105207 http://doi.org/10.1016/j.jaap.2021.105207
65. Da Cruz, D. M., Popiolek Júnior, T. L., Barreto, M. A., Souza, S. P., Zangalli, L. B., Cruz Júnior, A. J., Martins, T. C., Silva, A. L. N., Bastos, I. N., & Guilherme, C. E. M. (2024). Numerical simulation with hyperelastic constitutive model for high-performance multifilaments used in offshore mooring ropes. The Journal of Engineering and Exact Sciences, 10(2), 17255. http://doi.org/10.18540/jcecvl10iss2pp17255.
Received: May 31, 2025
Revised: Aug. 12, 2025
Accepted: Aug. 20, 2025
Editor-in-Chief: Sebastião V. Canevarolo
Luiz Paulo Soares Pereira1 , Marina de Souza Melchiors1 , Thayne Yasmin Vieira1 , Tamara Agner1 , Bruno Augusto Mattar Carciofi2 , Pedro Henrique Hermes de Araújo1 , Débora de Oliveira1 and Claudia Sayer1*
1Departamento de Engenharia Química e Engenharia de Alimentos, Universidade Federal de Santa Catarina, Florianópolis, SC, Brasil
2Department of Biological and Agricultural Engineering, University of California, Davis, CA, United States of America
*claudia.sayer@ufsc.br
Obstract
Limonene, a renewable material derived from citrus fruit peels, can be used as monomer in thiol-ene polymerization with dithiols and tetrathiols to form linear or crosslinked polymers, respectively. The effect of using a thermal- or photoinitiator on polymer properties was evaluated, with the photoinitiator significantly increasing the conversion of the internal unsaturation of limonene with 1,4-butanedithiol (>90%), resulting in higher molecular weights (9,000 g/mol). With pentaerythritiol tetrakis(3-mercaptopropionate), the gel content remained below 15% in thermally initiated reactions (28,000 g/mol) but increased to above 90% in photoinitiated ones. Finally, combining both thiols resulted in an intermediate molecular weight (~13,000 g/mol) for thermal initiation, and a gel content of about 85% for the photoinitiated ones. Thus, thiol-ene reactions stand out as an effective approach for the synthesis of polymers from limonene, with molecular weight and gel content being fine-tuned by the type/ amount of initiator, and by the combination of di- and tetrathiol.
Keywords: green chemistry, photopolymerization, renewable monomers, thiol-ene polymerization.
Data Ovailability: All data supporting the findings of this study are available from the corresponding author upon request.
How to cite: Pereira, L. P. S., Melchiors, M. S., Vieira, T. Y., Agner, T., Carciofi, B. A. M., Araújo, P. H. H., Oliveira, D., & Sayer, C. (2025). Modulating molecular weight and crosslinking in thiol-ene polymerization of renewable monomer limonene. Polímeros: Ciência e Tecnologia, 35(4), e20250044. https://doi.org/10.1590/0104-1428.20250043
1. Introduction
(R)-(+)-Limonene is one of the most common natural terpenes[1] found in citrus peels, with orange peel containing 85–95% of it in its essential oil[2]. Brazil, the world’s largest orange producer with around 17 million tons (primarily for juice), leads global production, followed by China, India, and the United States of America[3]. This terpene is an abundant, inexpensive, and versatile chemical feedstock used as a solvent and in the production of fragrances, pharmaceuticals, and flavors. The extraction and use of limonene from orange peels aligns with Goal 12 (Ensure Sustainable Consumption and Production Patterns) of the 2030 Agenda for Sustainable Development of the United Nations[4]. With two double bonds (an internal – endocyclic, and a terminal – exocyclic), it becomes a well-suited monomer for polymerization. However, due to the sterically hindered ene structure of terpenes, they are primarily ineffective in traditional chain-growth homopolymerization[5]. To overcome this limitation, free-radical-mediated thiol-ene reactions were explored and demonstrated to be a successful alternative[5,6].
Thiol-ene chemistry, although already known for over 100 years[7], studies involving thiol-ene polymerizations of
terpenes remain scarce. It proceeds via a free radical chain mechanism and primarily yields anti-Markovnikov products[8] Figure 1 illustrates this mechanism, where limonene reacts with 1,4-butanedithiol. The polymerization occurs according to the following steps. Initiation (1): A hydrogen atom is abstracted from a thiol group, forming a thiyl radical. This step can be induced by either a thermal initiator or a photoinitiator[9]. Propagation (2): The thiyl radical attacks the terpene double bond forming an intermediate carbon-centered radical. This C–S bond formation is a reversible reaction that also depends on the structure of the olefin. Thus, the addition of thiols to terminal olefins, monosubstituted alkynes, and olefins leading to resonance-stabilized radical intermediates is less reversible than the addition to internal olefins[8]. Therefore, terminal double bonds are generally more reactive than internal ones[10]. This intermediate radical, in turn, easily captures an electron-poor hydrogen from another thiol group, thus characterizing the chain transfer step (3). Finally, the termination step (4) occurs by the combination of two radicals[10,11]
L. P. S., Melchiors, M. S., Vieira, T. Y., Agner, T., Carciofi, B. A. M., Araújo, P. H. H., Oliveira, D., & Sayer, C.

Thiol-ene polymerizations are used in UV-curable coatings[12], flame-retardant polymers[13], crosslinking[14], and polymerization of monomers derived from renewable sources[6,11,15-19], among others. The thiol-ene addition of limonene was used to synthesize alcohol and/or ester-functionalized monomers[8], as well as diamine monomers, for the production of polyamides and polyurethanes[15] Additionally, sunlight-triggered thiol-ene reactions of D-limonene with poly[(mercaptopropyl)methylsiloxane] were used to produce luminescent films[20], while high Tg networks of poly(limonene carbonates) were prepared by thiol-ene reactions using a multifunctional thiol[21]. Beyond these applications, thiol-ene photopolymerization (TEP) has been employed to synthesize photocured organogels for artwork cleaning, utilizing bio-based monomers functionalized with thiol or allyl groups, particularly limonene[22]. Claudino et al.[10] studied the kinetics of thiol-ene reactions between D-limonene and mono-or tri-functional thiol monomers and observed that the coupling at the external double bond occurred about seven times faster than at the internal ones, with reaction rates unaffected by thiol functionality. In a subsequent study, Claudino et al.[6] synthesized limonene-terminated precursors using tri- and tetra-functional thiols for later UV-curing. However, studies involving thiol-ene polymerization of limonene remain scarce.
In light of the scarce findings reported in the literature and the growing demand for bio-based polymers with specific characteristics, the modulation of molecular weight and gel content in the thiol-ene polymerization of (R)-(+)-limonene was investigated by the combination of a dithiol and a tetrathiol, as well as by using different concentrations and types of initiators (photoinitiator or thermal initiator).
2.1
(R)-(+)-Limonene (97%, CAS: 5989-27-5), 1,4-butanedithiol (dithiol) (≥97%, CAS: 1191-08-8) and pentaerythritol tetrakis(3-mercaptopropionate) (tetrathiol) (>95%, CAS: 7575-23-7) were purchased from Sigma-Aldrich. The thermal initiator α, α′-azobisisobutyronitrile (AIBN) (98%, CAS: 78-67-1) was purchased from Sigma-Aldrich, and the photoinitiator 2,2-dimethoxy-2-phenylacetophenone (DMPA) (CAS: 24650-42-8) was kindly donated by IGM Resins (Brazil). All reagents were used as received, except for AIBN, which was recrystallized from methanol.
2.2 Experimental procedure
Reactions were carried out in batch in a 10 mL glass reactor. Limonene and the initiator were stirred at room temperature for 10 min to complete initiator solubilization. Immediately afterward, the thiol (dithiol, tetrathiol, or both) was added, and the reaction medium was purged with nitrogen for 5 min. Limonene is miscible with dithiol; therefore, when the dithiol is used, the reactions occur in a homogeneous medium. In contrast, it is immiscible with tetrathiol, resulting in a heterogeneous system. However, in the presence of both thiols, dithiol acts as a miscibility-enhancing compound, and the system becomes homogeneous.
When the thermal initiator AIBN was used, the polymerizations were carried out for 4 h at 80 °C under magnetic stirring, as the half-life of AIBN at this temperature is approximately 80 min[23]. The polymerizations with the photoinitiator DMPA were performed in a UV chamber with two 26 W fluorescent black light lamps. These reactions were conducted for 2 h at 40 °C without stirring, with a
Modulating molecular weight and crosslinking in thiol-ene polymerization of renewable monomer limonene
distance of 4 cm between the reaction medium and one of the UV lamps, which corresponds to an average light intensity of 3.83 mW/cm2 (measured using a Solar Light radiometer PMA2100, equipped with a digital UVA+B sensor PMA2107).
Table 1 presents the formulations for all reactions. The ratio of functional groups (thiol:double bond) was kept at 1:1, and all reactions were performed in duplicate.
The conversions of the double bonds of limonene were calculated based on Nuclear Magnetic Resonance (1H NMR) analyses. The 1H NMR analyses were performed in deuterated chloroform (CDCl3, CAS: 865-49-6, 99.8 atom% D) using a BRUKER AC 200 spectrometer operated at 200 MHz. Chemical shifts (δ) were reported in parts per million (ppm), related to tetramethylsilane (TMS, δ = 0.00 ppm). The conversions were calculated based on the concentration of TMS in the deuterated chloroform (0.05% v/v). 1H NMR (200 MHz, CDCl3, δ): 0.00 ppm (TMS, 12H, 4x-CH3), 4.70 ppm (external unsaturation, 2H, C=CH2), 5.41 ppm (internal unsaturation, 1H, C=CH). The yield was determined by gravimetric analysis at 90 °C under reduced pressure until a constant mass was achieved.
The gel content was determined after solubilization in tetrahydrofuran (THF) for 48 h and filtration using a syringe filter (0.45 µm). The bottle and the filter, which retained the insoluble polymer, were dried in a forced convection oven at 60 °C for 48 h and weighed to determine gel content by comparing the final dry mass to the original sample mass.
The molecular weight distributions and the corresponding weight average (M W ) and number average (M N ) molecular weights of the soluble polymer fractions were measured by gel permeation chromatography using a high-performance liquid chromatograph (HPLC, model LC 20-A, Shimadzu) equipped with a PL gel MiniMIX pre-column (5 µm, 50 × 4 mm),
two MiniMIX PL gel columns (5 µm, 250 × 4.6 mm) in series, and a RID-10A refractive index detector. THF was used as the eluent with a flow rate of 0.3 mL/min flow rate at 40 °C. Polystyrene standards with molecular weights ranging from 580 to 9.835 × 106 g/mol were used for the calibration curve.
Thermal degradation was studied by thermogravimetric analysis (TGA, STA 449 F3 Jupiter, NETZSCH). Approximately 10 mg of the sample was weighed into an alumina pan and heated from 30 to 700 °C at a heating rate of 10 °C/min under a nitrogen flow rate of 60 ml/min.
3.1 Thiol-ene polymerizations using a bifunctional thiol
Limonene has an asymmetric structure, and its double bonds exhibit different reactivities[10]. The conversions of the double bonds with 1,4-butanedithiol were determined by 1H NMR and are presented in Table 2. All polymerizations performed with dithiol at 80 °C (R1, R2, and R3) showed yields above 85% after 4 h of reaction, even R1, which was performed without initiator.
The external double bond of limonene showed a near-complete conversion when AIBN was used (R2 and R3). In contrast, the reaction without AIBN (R1) achieved a conversion of 80%, corroborating the yield determined by gravimetry.
The conversion of the internal double bond was notably lower than that of the external ones, increasing with the amount of initiator and reaching 65% with 4% of AIBN. This difference in the conversion of double bonds was described by Claudino et al.[10], who noted that the external unsaturation reacts about seven times faster than the internal one. Low chain growth was observed for all concentrations of AIBN, resulting in the formation of oligomers with a molecular weight of about 2,000 g/mol (R1, R2, and R3).
Table 1. Formulations of thiol-ene polymerizations of limonene (Lim) with 1,4-butanedithiol (Di) and/or pentaerythritiol tetrakis (3-mercaptopropionate) (Tetra), using AIBN or DMPA as initiator†
†In relation to limonene.
Pereira, L. P. S., Melchiors, M. S., Vieira, T. Y., Agner, T., Carciofi, B. A. M., Araújo, P. H. H., Oliveira, D., & Sayer, C.
Limonene:Dithiol:Tetrathiol (1:0.5:0.25)
†Results of R7 and R10 are not shown in this table due to sample heterogeneity that did not allow the determination of representative results.
‡In relation to limonene. §Molecular weights were not presented due to the large amount of oligomers (out of the calibration curve).
¥The reactions took place in a heterogeneous medium. Standard deviation refers to duplicate reactions.

Figure 2. 1H NMR spectra of polymers obtained by thiol-ene photopolymerization (reactions R4 and R6), along with the spectra of limonene and dithiol (at the same concentration as in the initial reaction medium).
To increase the conversion of the internal unsaturation and, thus, the growth of the polymer chain, photopolymerizations were performed with DMPA as a photoinitiator. Yields above 90% were reached for all evaluated DMPA concentrations (R5 and R6), even for R4, which was performed without photoinitiator. It was previously reported that thiol monomers are also photopolymerizable with a wide variety of vinyl monomers in the absence of photoinitiator[24] and that thiol oxidation by air may significantly contribute to the self-initiation of thiol-ene polymerizations performed in the absence of an initiator, but also mentioned that
the formation of thiyl radicals by the molecule-assisted homolysis of thiols may not be ruled out[25]. Using the radical photoinitiator 1-[4-(2-hydroxyethoxy)-phenyl]-2-hydroxy2-methyl-1-propane-1-one (I2959, 3 wt% with respect to the terpene–dithiol mixture), Tarablsi et al.[5] related limiting ene conversions of 90% in the bulk photopolymerization of limonene with ethylene glycol dithiol.
Figure 2 shows the 1H NMR spectra of limonene, dithiol, and the polymers resulting from thiol-ene photopolymerization (R4 and R6).
Polímeros, 35(4), e20250044, 2025
Modulating molecular weight and crosslinking in thiol-ene polymerization of renewable monomer limonene
The absence of the chemical shift of the external double bond of limonene (‘b’) indicates its complete consumption, even in the reaction performed without DMPA (R4). Regarding the internal double bond of limonene (chemical shift ‘a’), the photoinitiated reactions at 40 °C (R4, R5, and R6) showed considerably higher conversions than the respective reactions at 80 °C with AIBN (R1, R2, and R3), due to the significantly higher radical generation rate of the photoinitiator, even at lower temperatures. The conversion of internal double bond increased from 57% in R4 to over 90% in R5 and R6 with DMPA. In addition, the consumption of dithiol (chemical shift ‘c’) was observed, along with the appearance of peaks ‘d’ and ‘e’ corresponding to the formed polymer. Regarding the growth of the polymer chain, the reactions initiated with DMPA (R5 and R6), which showed high conversions of the internal unsaturation of limonene (above 90%), presented a considerable increase in molecular weight compared to those initiated with AIBN at the same concentration, even though the reaction was conducted at higher temperatures (80 °C). Increases of about 90% in M N and 150% in M W were obtained for reaction R5 compared to R2. These higher molecular weights achieved in the photoinitiated reactions are related to the higher conversions of the internal double bond. Furthermore, the increased concentration of the photoinitiator (R6) influenced the growth of the polymer chain, leading to a higher molecular weight (M W = 9.0 × 103 g/mol). This positive correlation between molecular weight and initiator concentration would be unexpected for a free radical chain growth polymerization. However, it is reasonable for free radical-mediated thiol-ene polymerization that follows a step-growth polymerization mechanism. In step-growth polymerizations, higher molecular weights are only reached when the conversions of the functional groups are very high, which, in the absence of solvents, may be hampered by diffusional limitations. Thus, in these thiol-ene polymerizations, higher initiator concentrations result in a greater concentration of thiyl radicals, which favors their reaction with the remaining double bonds and leads to higher molecular weights. When the photoinitiator replaces the thermal initiator, and when the concentration of the latter is increased, the molecular weight distribution (Figure 3) not only shifts towards higher molecular weights but also becomes broader while remaining unimodal. The effect of the initiator concentration is much more intense for the photoinitiator.
The thermal behavior of the polymer obtained under R6 photopolymerization conditions, which showed a broader molecular weight distribution, was evaluated by thermogravimetric analysis (Figure 4). This polymer presents thermal stability up to approximately 150 °C. After that, a mass loss (<5% at 350 °C) is observed, reaching complete decomposition at about 378 °C. Therefore, the thermal decomposition temperature of the polymer R6 is between 350 and 378 °C (applying a heating rate of 10 °C/min). Compared with the reaction carried out with AIBN (R2), no significant difference was observed in the thermal decomposition temperature of the polymer (Figure S1 in the Supplementary Information).
A tetrathiol was used to evaluate the growth of the polymer chain and the formation of a gel (insoluble fraction), as the presence of four functionalities in the tetrathiol could lead to the formation of a polymer network with limonene. In these polymerizations the reaction medium was not completely homogeneous. Figure 5 shows the possible chemical structure of the crosslinked polymer, considering that all the symmetric thiol groups can eventually react with the double bonds of limonene. The products of reactions R11 and R12, using a limonene:tetrathiol molar ratio equal to 1:0.5, were solid. In contrast, a previous study involving the solution polymerization of limonene and tetrathiol with a molar ratio of 1:0.25 reported the obtention of a highly viscous liquid[22] .
For reactions performed at 80 °C (R8 and R9) with AIBN, the yield increased with the amount of initiator used, from 75% for 1 mol% to 95% for 4 mol% initiator concentration (Table 2). Figure 6 shows the 1H NMR spectra of limonene, tetrathiol, and the polymer resulting from the thiol-ene photopolymerization (R8 and R9). An increase in the amount of initiator increases the consumption of the external double bond, reaching virtually 100% conversion in R9 (with almost complete absence of the chemical shift ‘b’).

Figure 3. The molecular weight distribution of limonene polymerizations with 1,4-butanedithiol (R2 – 1% AIBN, R3 – 4% AIBN, R5 – 1% DMPA, and R6 – 4% DMPA) using different types and amounts of an initiator.

Figure 4. Thermogravimetric analysis (TG) and derivative thermogravimetric (DTG) curves of the polymer obtained from limonene polymerization with 1,4-butanedithiol (R6 – 4% DMPA).
Pereira, L. P. S., Melchiors, M. S., Vieira, T. Y., Agner, T., Carciofi, B. A. M., Araújo, P. H. H., Oliveira, D., & Sayer, C.

Figure 5. Possible chemical structure of the crosslinked polymer obtained from the reaction between limonene and pentaerythritiol tetrakis(3-mercaptopropionate).

Figure 6. 1H NMR spectra of polymers obtained by thiol-ene photopolymerization (reactions R8 and R9), along with the spectra of limonene and tetrathiol (at the same concentration as in the initial reaction medium).
Polímeros, 35(4), e20250044, 2025
Modulating molecular weight and crosslinking in thiol-ene polymerization of renewable monomer limonene

Figure 7. Thermogravimetric analysis (TG) and derivative thermogravimetric (DTG) curves of the polymer obtained from limonene polymerization with pentaerythritol tetrakis (3-mercaptopropionate) (R8 – 1% AIBN).
The reduction in the chemical shift ‘a’, referring to the internal double bond of limonene, indicates conversions of up to 72% (R9). It was not possible to identify the consumption of thiol (chemical shift ‘c’) due to its overlaps with the protons of the terminal methyl groups in limonene (1.6–1.8 ppm); however, the peaks ‘d’ and ‘e’ associated with the formed polymers, were observed.
Neither of these reactions, R8 nor R9, presented a considerable amount of gel content (< 15%), indicating the lower effectiveness of the thermal initiator AIBN, which resulted in branched rather than highly crosslinked polymers. Regarding the average molecular weight of the fraction of soluble polymer (>85%), a very expressive increase is observed with the increase in the amount of initiator used (from R8 to R9), reaching 28 × 103 g/mol. The reaction at 80 °C without an initiator (R7 in Table 1) yielded a heterogeneous material, and its characterization was not representative.
Given the positive effect of the photoinitiator DMPA on the conversion of the internal double bond of limonene and, consequently, on the molecular weight, photopolymerizations were also performed with the tetrathiol. For different DMPA concentrations (R11 and R12), yields and gel contents above 90% were obtained, indicating the formation of covalently crosslinked networks. Due to these high gel contents, GPC and 1H NMR analyses were not performed. The high gel content in these reactions is due to the use of tetrathiol combined with high conversions of both double bonds of limonene, compared to the incomplete conversions observed in reactions R8 and R9 with the thermal initiator. Again, the reaction without DMPA (R10 in Table 1) resulted in heterogeneous samples.
Thermogravimetric analysis of the polymers obtained from photopolymerizations R8 and R12 showed two stages of thermal decomposition, as shown in Figure 7 and Figure S2 of the Supplementary Information. Thermal stability is also observed up to around 150 °C, with a mass loss of less than 3% before the first stage of decomposition begins, which occurs from 330 to 390 °C approximately, resulting in a mass loss of nearly 60%. The second stage of thermal degradation ranges from 425 to 475 °C, with a residual of almost 8%. Thus, the thermal decomposition temperature for reactions with tetrathiol has a broader range, divided into two stages, ranging from 330 to 475 °C.
3.3 Thiol-ene polymerizations using a bifunctional and a tetrafunctional thiol
The reactions between limonene and tetrathiol performed with DMPA as a photoinitiator (R11 and R12) showed a substantial increase in the gel content compared to reactions performed at 80 °C with AIBN, from <15% to up to above 90%. To modulate the formation of gel (insoluble fraction) and to evaluate the possibility of increasing the molecular weight without the formation of gel or with low gel content, reactions R13, R14, and R15 were performed, replacing part of the tetrathiol with dithiol (see Table 1).
Using AIBN at 80 °C (R13 and R14), the yield increases with the initiator amount, reaching 92%. These reactions also led to high external double bond conversion (≥95%) and a slight increase in internal double bond conversion, reaching up to 63% with 4% of AIBN (R14). The gel content for both reactions (R13 and R14) was lower than 15%. Regarding the molecular weight of the soluble polymer fraction (>85%), an important increase was observed again with the increase in initiator amount from 1% to 4% (R13 to R14) in these free radical-mediated thiol-ene polymerizations, which follow a step-growth mechanism. However, comparing the MW from reactions R9 and R14, which used the same amount of initiator but in R14 partially replaced the tetrathiol with dithiol, the MW decreased from 28.1 × 103 g/mol (R9) to 12.7 × 103 g/mol (R14). It is important to note that reactions with a higher tetrathiol concentration formed more branched polymers, thereby achieving higher molecular weights.
The results of reactions R13 and R14 showed that the yield, conversion of both double bonds of limonene, and molecular weight increased as the concentration of AIBN increased. The yield increased from 78% to 92%, the external double bond of limonene from 95% to 100% while the internal from 47% to 63%, and the molecular weight from 2.2 × 103 to 12.7 × 103 g/mol when the AIBN concentration increased from 1% to 4%. This behavior was similar to the reactions between limonene and tetrathiol (R8 and R9). The simultaneous use of both thiols allowed to reach an intermediate molecular weight (12.7 × 103 g/mol, R14) compared to reactions with either the dithiol (2.3 × 103 g/mol, R3) or the tetrathiol (28.1 × 103 g/mol, R9) with the same concentration of AIBN. Thermogravimetric analysis of the polymer produced during photopolymerization R13 (Figure S3 in the Supplementary Information) exhibited a behavior similar to that observed for the polymers synthesized in reactions R8 and R12.
Photopolymerization R15, performed with 1% DMPA as photoinitiator, presented yield and gel content above 95% and 85%, respectively, as shown in Table 2. The highly effective limonene thiol-ene photopolymerization yielded exceptionally high gel contents, even with 1% of initiator (DMPA) and a 2:1 dithiol:tetrathiol molar ratio.
Thiol-ene polymerizations of (R)-(+)-limonene have been successfully carried out with dithiol and/or tetrathiol. Increasing the initiator concentration and replacing the thermal initiator AIBN with the photoinitiator DMPA resulted in a higher conversion of the internal double bond
Pereira, L. P. S., Melchiors, M. S., Vieira, T. Y., Agner, T., Carciofi, B. A. M., Araújo, P. H. H., Oliveira, D., & Sayer, C.
of limonene, above 90%, leading to a higher molecular weight. Likewise, replacing the dithiol with tetrathiol increased the molecular weight, while the gel content remained relatively low (<15%) when AIBN was used. In contrast, the use of the photoinitiator DMPA resulted in high gel contents (above 90%). The degradation temperature of the obtained polymers ranged from 330 to 475 °C, being higher in the crosslinked polymers. Thus, polymerizing both thiols with limonene enabled the modulation of the polymer properties in terms of gel content, molecular weight, and thermal degradation, showing the versatility of limonene thiol-ene polymerization. These materials are considered promising for drug delivery systems; however, cytotoxicity and biocompatibility studies are essential for their safe implementation in biomedical applications.
• Conceptualization – Claudia Sayer; Pedro Henrique Hermes de Araújo; Débora de Oliveira; Bruno Augusto Mattar Carciofi.
• Data curation – Luiz Paulo Soares Pereira; Tamara Agner.
• Formal analysis – Débora de Oliveira; Marina de Souza Melchiors; Pedro Henrique Hermes de Araújo; Tamara Agner.
• Funding acquisition – Bruno Augusto Mattar Carciofi; Claudia Sayer.
• Investigation – Luiz Paulo Soares Pereira; Thayne Yasmin Vieira.
• Methodology – Luiz Paulo Soares Pereira; Marina de Souza Melchiors; Thayne Yasmin Vieira; Pedro Henrique Hermes de Araújo.
• Project administration – Bruno Augusto Mattar Carciofi.
• Resources – Claudia Sayer; Pedro Henrique Hermes de Araújo; Bruno Augusto Mattar Carciofi.
• Software – NA.
• Supervision – Claudia Sayer; Pedro Henrique Hermes de Araújo.
• Validation – Marina de Souza Melchiors.
• Visualization – Luiz Paulo Soares Pereira; Tamara Agner.
• Writing – original draft – Luiz Paulo Soares Pereira; Marina de Souza Melchiors.
• Writing – review & editing – Claudia Sayer; Tamara Agner; Pedro Henrique Hermes de Araújo; Bruno Augusto Mattar Carciofi; Débora de Oliveira.
The authors thank the financial support from Conselho Nacional de Desenvolvimento Científico e Tecnológico (CNPq), Coordenação de Aperfeiçoamento de Pessoal de Nível Superior (CAPES), especially to the CAPES-PRINT Program (Project number 88887.310560/2018-00), INCT Circularidade em materiais poliméricos, and the group IGM Resins for the donation of the photoinitiator 2,2-dimethoxy2-phenylacetophenone.
1 Sun, J. (2007). D-Limonene: safety and clinical applications. Alternative Medicine Review, 12(3), 259-264 PMid:18072821.
2 Espina, L., Somolinos, M., Lorán, S., Conchello, P., García, D., & Pagán, R. (2011). Chemical composition of commercial citrus fruit essential oils and evaluation of their antimicrobial activity acting alone or in combined processes. Food Control, 22(6), 896-902 http://doi.org/10.1016/j.foodcont.2010.11.021
3 Food and Agriculture Organization of the United Nations. (2021). Citrus Fruit Statistical Compendium 2020. Retrieved in 2025, June 3, from https://www.fao.org/3/cb6492en/cb6492en.pdf
4 United Nations Department of Economic and Social Affairs, Sustainable Development. (2024, September 19). The 17 Goals. Retrieved in 2025, June 3, from https://sdgs.un.org/goals
5 Tarablsi, B., Jasinski, F., Lobry, E., Chemtob, A., Le Nouen, D , & Criqui, A. (2015). Semi-renewable latex via step-photopolymerization of dithiol and dienic terpenes. Green Materials, 3(3), 93-101 http://doi.org/10.1680/jgrma.15.00015
6 Claudino, M., Mathevet, J.-M., Jonsson, M., & Johansson, M. (2014). Bringing D-limonene to the scene of bio-based thermoset coatings via free-radical thiol-ene chemistry: macromonomer synthesis, UV-curing and thermo-mechanical characterization. Polymer Chemistry, 5(9), 3245-3260 http://doi.org/10.1039/ C3PY01302B
7 Hoyle, C. E., Lee, T. Y., & Roper, T. (2004). Thiol-enes: chemistry of the past with promise for the future. Journal of Polymer Science. Part A, Polymer Chemistry, 42(21), 5301-5338 http://doi.org/10.1002/pola.20366
8 Firdaus, M., Espinosa, L. M., & Meier, M. A. R. (2011). Terpene-based renewable monomers and polymers via thiol-ene additions. Macromolecules, 44(18), 7253-7262 http://doi.org/10.1021/ma201544e
9. Claudino, M., Johansson, M., & Jonsson, M. (2010). Thiol-ene coupling of 1,2-disubstituted alkene monomers: the kinetic effect of cis/trans-isomer structures. European Polymer Journal, 46(12), 2321-2332 http://doi.org/10.1016/j.eurpolymj.2010.10.001
10 Claudino, M., Jonsson, M., & Johansson, M. (2013). Thiol-ene coupling kinetics of D-limonene: a versatile ‘non-click’ free-radical reaction involving a natural terpene. RSC Advances, 3(27), 11021-11034. http://doi.org/10.1039/c3ra40696b.
11 Machado , T. O. , Sayer, C. , & Araujo , P. H. H. (2017 ). Thiol-ene polymerisation: a promising technique to obtain novel biomaterials. European Polymer Journal, 86, 200-215. http://doi.org/10.1016/j.eurpolymj.2016.02.025
12 Li, T., Zhang, Z. P., Rong, M. Z., & Zhang, M. Q. (2019). Self-healable and thiol–ene UV-curable waterborne polyurethane for anticorrosion coating. Journal of Applied Polymer Science, 136(26), 47700 http://doi.org/10.1002/app.47700
13 Çakmakçı, E. (2023). Recent advances in flame retardant polymers via thiol-ene click chemistry. Journal of Macromolecular Science, 60(12), 817-840 http://doi.org/10.1080/10601325.2023.2280237
14 Stewart, S. A., Coulson, M. B., Zhou, C., Burke, N. A. D., & Stöver, H. D. H. (2018). Synthetic hydrogels formed by thiol-ene crosslinking of vinyl sulfone-functional poly (methyl vinyl ether-alt-maleic acid) with α,ω-dithio-polyethyleneglycol. Soft Matter , 14 (41), 8317-8324 http://doi.org/10.1039/ C8SM01066H PMid:30288534.
15 Firdaus, M., & Meier, M. A. R. (2013). Renewable polyamides and polyurethanes derived from limonene. Green Chemistry, 15(2), 370-380. http://doi.org/10.1039/C2GC36557J.
16 Cardoso, P. B., Machado, T. O., Feuser, P. E., Sayer, C., Meier, M. A. R., & Araújo, P. H. H. (2017). Biocompatible polymeric nanoparticles from castor oil derivatives via thiol-ene miniemulsion polymerization. European Journal of Lipid Science and Technology, 120(1), 1700212 http://doi.org/10.1002/ejlt.201700212
Modulating molecular weight and crosslinking in thiol-ene polymerization of renewable monomer limonene
17 Ciriminna , R. , Lomeli-Rodriguez , M. , Carà , P. D. , Lopez-Sanchez, J. A , & Pagliaro, M. (2014). Limonene: a versatile chemical of the bioeconomy. Chemical Communications, 50(97), 15288-15296 http://doi.org/10.1039/C4CC06147K PMid:25341412.
18 Romera, C. O., Oliveira, D., Araújo, P. H. H., & Sayer, C. (2019). Biobased ester 2-(10-undecenoyloxy)ethyl methacrylate as an asymmetrical diene monomer in thiol-ene polymerization. Industrial & Engineering Chemistry Research , 58 (46 ), 21044-21055 http://doi.org/10.1021/acs.iecr.9b02386
19 Prebihalo, E. A., Johnson, M., & Reineke, T. M. (2024). Bio-based thiol–ene network thermosets from isosorbide and terpenes. ACS Macro Letters, 13(5), 586-591. http://doi.org/10.1021/ acsmacrolett.4c00078 PMid:38666714.
20 Zuo, Y., Cao, J., & Feng, S. (2015). Sunlight-induced crosslinked luminescent films based on polysiloxanes and D-limonene via thiol-ene “click” chemistry. Advanced Functional Materials, 25(18), 2754-2762 http://doi.org/10.1002/adfm.201500187
21 Li, C., Johansson, M., Sablong, R. J., & Koning, C. E. (2017). High performance thiol-ene thermosets based on fully bio-based poly(limonene carbonate)s. European Polymer Journal, 96, 337-349 http://doi.org/10.1016/j.eurpolymj.2017.09.034
22 Çakmak, Y., Çakmakçi, E., Apohan, N. K., & Karadag, R. (2022). Isosorbide, pyrogallol, and limonene-containing
thiol-ene photocured bio-based organogels for the cleaning of artworks. Journal of Cultural Heritage, 55, 391-398 http://doi.org/10.1016/j.culher.2022.04.013.
23 Perrier, S., Takolpuckdee, P., & Mars, C. A. (2005). Reversible addition-fragmentation chain transfer polymerization: end group modification for functionalized polymers and chain transfer agent recovery. Macromolecules, 38(6), 2033-2036 http://doi.org/10.1021/ma047611m
24 Cramer, N. B. , Scott , J. P. , & Bowman , C. N. ( 2002 ). Photopolymerizations of thiol-ene polymers without photoinitiators. Macromolecules, 35(14), 5361-5365 http://doi.org/10.1021/ ma0200672.
25 Le, C. M. Q., Morlet-Savary, F., & Chemtob, A. (2021). Role of thiol oxidation by air in the mechanism of the self-initiated thermal thiol-ene polymerization. Polymer Chemistry, 12(45), 6594-6605. http://doi.org/10.1039/D1PY01301G.
Received: Jun. 03, 2025
Revised: Aug. 19, 2025
Accepted: Aug. 27, 2025
Associate Editor: Artur J. M. Valente
Supplementary material accompanies this paper.
Figure S1. Thermogravimetric analysis (TG) and derivative thermogravimetric (DTG) curves of the polymer obtained from limonene polymerization with 1,4-butanedithiol (R2 – 1% AIBN).
Figure S2. Thermogravimetric analysis (TG) and derivative thermogravimetric (DTG) curves of the polymer obtained from limonene polymerization with pentaerythritol tetrakis(3-mercaptopropionate) (R12 – 4% DMPA).
Figure S3. Thermogravimetric analysis (TG) and derivative thermogravimetric (DTG) curves of the polymer obtained from limonene polymerization with 1,4-butanedithiol and pentaerythritol tetrakis(3-mercaptopropionate) (R13 – 1% AIBN).
This material is available as part of the online article from https://doi.org/10.1590/0104-1428.20250043
Pereira, L. P. S., Melchiors, M. S., Vieira, T. Y., Agner, T., Carciofi, B. A. M., Araújo, P. H. H., Oliveira, D., & Sayer, C. Polímeros, 35(4), e20250044, 2025
Pâmela Barcelar Ferreira Gomes da Silva de Luna1* , Karina Carvalho de Souza1 , Rhodivam Lucas Mendes Feitosa1 , Daniella Stepheny Carvalho Andrade1 , Dayanna Kelly Marques de Oliveira1 , Fernanda Sobreira Silva2 , Alexciana Pereira de Melo2 and Glória Maria Vinhas1,2
1Programa de Ciência de Materiais, Universidade Federal de Pernambuco - UFPE, Recife, PE, Brasil 2Departamento de Engenharia Química, Universidade Federal de Pernambuco - UFPE, Recife, PE, Brasil *pamelabarcelar@gmail.com
*This paper has been partially presented at the 17th Brazilian Polymer Congress, held in Joinville, SC, 29/Oct - 02/Nov/2023.
Obstract
In this work, kombucha residue (bacterial cellulose) was obtained after fermentation of six herbal infusions. Culture medium was prepared with 5g/L of plants infusion and sweetened with 50g/L of sucrose. Higher film production was 32,33 g.L-1 after 21 days from culture medium formed by 50% of green tea and 50% of Pereskia aculeate. All pellicles showed antimicrobial activity against S.aureus and SEM of pellicles showed a heterogeneous and dense surface. XDR analysis evidenced cellulose type I properties in pellicles and degree of crystallinity decreased in the pellicles obtained from culture medium with 100% herbal infusions. Thermal properties revealed better thermal stability than kombucha pellicle standard. This research is innovative because it used plants from northeast of Brazil for production of an alternative, low cost and biodegradable material to replace traditional plastics using residues and active agents in addition to reducing pollution.
Keywords: bacterial cellulose; kombucha; herbal infusions.
Data Ovailability: Research data is available upon request from the corresponding author.
How to cite: Luna, P. B. F. G. S., Souza, K. C., Feitosa, R. L. M., Andrade, D. S. C., Oliveira, D. K. M., Silva, F. S., Melo, A. P., & Vinhas, G. M. (2025). Production and reuse of kombucha waste for cellulose production from different plants. Polímeros: Ciência e Tecnologia, 35(4), e20250045. https://doi.org/10.1590/0104-1428.20250033
1. Introduction
Kombucha, an ancient tea of Asian origin, is currently consumed for its beneficial health properties, produced from green tea, traditionally from the Camellia sinensis species, sweetened and fermented by a symbiotic culture of bacteria and yeasts[1]. As a result of fermentation, in addition to the production of a sweet, slightly acidic and carbonated beverage, a by-product known as SCOBY (symbiotic culture of bacteria and yeasts) is formed, which is a bacterial cellulose (BC) film synthesized from the metabolism of bacteria mainly of the genus Komagataeibacter[2 3]. This biofilm, which consists of pure cellulose nanofibrils, high water retention capacity, thermostability and high crystallinity, can be used, after the purification stage, as dressings, biodegradable packaging, clothing, bags, etc[4,5]. In Brazil, a drink to be recognized as kombucha, according to Normative Instruction Nº 41 of 17 September 2019 of the Ministry of Agriculture, Livestock and Supply (MAPA), it must contain drinking water, Camellia sinensis infusion, sugars and SCOBY. Other plant extracts can be used, but these are optional[6]
The SCOBY produced is considered waste and is discarded and disposed of in the environment after the
kombucha production process. In recent decades, bacterial cellulose has been widely researched and proposed as an alternative to replace polluting materials that are difficult to degrade in the environment, due to its various properties such as biodegradability, biocompatibility, low toxicity, high water absorption capacity, among others[7-9]. It is mainly a component of plants cell wall, but can be synthesized by other organisms such as fungi, algae and especially by the bacteria Komagataeibacter hansenii [10 11]. Some natural plants extracts can be added to the polymer matrix to improve certain desirable properties such as antimicrobial and antioxidant activity due to the presence of active compounds[12]
In this sense, northeast Brazil is a region with a great biodiversity of plants and vegetables that have biological activity due to the presence of secondary metabolites in their composition. These plants, as well as their waste, can be used to obtain bacterial cellulose after kombucha fermentation, boost the polymeric matrix with antioxidant and antimicrobial properties and reduce the cost process of production[13]. Some active compounds such as alkaloids, terpenoids and saponins are present in Centella asiatica[14] ,
Luna, P. B. F. G. S., Souza, K. C., Feitosa, R. L. M., Andrade, D. S. C., Oliveira, D. K. M., Silva, F. S., Melo, A. P., & Vinhas, G. M.
caffeine, theobromine, phenolic compounds, flavonoids in Ilex guayusa[15], phenolic acids in Pereskia aculeate[16] , flavonoids, steroids, alkaloids in Duguetia lanceolata[17,18] and steroids, flavonoids, catechins, tannins and terpenes in Pterodon emarginatus[19]
Several works develop BC pellicles from different culture medium, using HS or alternative medium, but none of them use kombucha and beverage- like kombucha to produce BC with Brazilian regional herbs. This work aimed to obtain and characterize BC from plant extracts from northeastern Brazilian plants such as ora-pro-nóbis (Pereskia aculeata), coronha (Dioclea violacea), misteriosa (Duguetia lanceolata), sucupira (Pterodon emarginatus) to enhance regional sources and compared with other plants such as centelha (Centella asiatica) and guayusa (Ilex guayusa). Their properties and antimicrobial activity against Gram positive and Gram-negative bacteria were evaluated in order to propose a unique material to apply as biodegradable and antimicrobial packaging.
2.1
Leaves of Camelia sinensis, Centella asiatica (CA), Ilex guayusa (IG), Pereskia aculeata (PA), Dioclea violacea (DV), Duguetia lanceolata (DL) e Pterodon emarginatus(PE) were purchased in a local market. Sucrose brand olho d’água batch 03A4881 and kombucha from Real kombucha used as starter.
2.2 Pellicle production
Infusions were prepared with 5g.L-1 of corresponding plant (nitrogen source) and sweetered with 50g.L-1 sucrose (carbon source). After the infusion reached room temperature, 24g of SCOBY and 10% of kombucha tea were introduced and remained for 21 days for fermentation at static condition and 25°C. Two culture media of each plant were prepared as follows: 1) 50% of Camelia sinensis infusion and 50% of herbal infusion and 2) 100% of herbal infusion as described on Table 1.
2.3 Purification of pellicles
Pellicles were washed with distilled water and then autoclaved for 15 minutes to remove residual microorganisms. They were dried at 50°C in an oven for 3 days and kept in a desiccator with silica gel at room temperature.
2.4 Pellicle characterization
2.4.1 Mid-infrared absorption spectroscopy
The samples were scanned with SPECTRUM 400 spectrometer (Perkin Elmer) with a attenuated total reflectance on following conditions: scanning range was 4000 to 400 cm-1, resolution of 4 cm-1 and 16 scans.
2.4.2 Antimicrobial activity analysis of the pellicles
The disc diffusion method was used to verify the antimicrobial activities against E. coli and S. aureus, according to Bauer et al.[20]. Microorganisms were added to sterile water until turbidity was set to 0.5 (McFarland scale), corresponding to 108 CFU/mL to prepare inoculum. Petri dishes with agar
(Müeller-Hinton) were inoculated with 0.1 mL of inoculum and spread on a drigalski spatula. Pellicles samples were added over the agar. So, Petri dishes were incubated in an oven at 35 °C for 24 h. Finally, the diameters of the halos were read with a micrometer.
2.4.3 Thermogravimetric analysis (TGA)
Approximately 4,0 mg of samples were scanned using analyzer Mettler Toledo brand, model TGA/DSC 2 STAR in the following conditions: temperature from 30°C to 600°C, heating rate 10°C.min-1 under a nitrogen atmosphere of flow rate 50mL/min.
2.4.4 X-ray diffractometry (XRD)
XRD pattern was measured with a Rigaku diffractometer model SmartLab with a copper tube, voltage of 40kVe and current of 20mA, on the 2θ scale, with a range of 10° to 70° and scanning speed of 0,5 min-1. Crystallinity index (CI) was calculated according to Segal et al.[21]:
(1) where cp is crystalline phase and ap amorphous phase.
2.4.5 Scanning electron microscopy (SEM)
SEM was performed with TESCAN MIRA microscopy model MIRA 3 operating at 5kV and magnification of 5kx. Samples were coated with a carbon layer
3.1 Produced pellicles
The pellicles began to form from day 4 of fermentation as a thin layer at the air-liquid interface and the thickness increased with fermentation time and are shown in Figure 1 after 21 days of fermentation.
Table 1. Description of culture medium.
Duguetia lanceolata 3.03
50% Camelia sinensis tea
Production and reuse of kombucha waste for cellulose production from different plants
The pellicles, after fermentation, were homogeneous in appearance, with a gelatinous aspect and translucent and some with a brownish color due to the culture medium in which they were produced. Table 2 shows the wet yield of the films after 21 days. Cellulose production ranged from 5.33 to 32.33 g. L-1, and the highest cellulose yields were in the PA50 and DV100 media with 32.33 ± 2,21 g.L-1 and 30.82 ± 2,29 g.L-1 respectively.
Table 2 shows that the infusions of the different plants and their active compounds in different concentrations interfered with the yield of BC. The highest yield came from the PA50 medium, suggesting that the association of the Pereskia aculeata infusion with Camellia sinensis was promising for BC production and that the medium had the right nutrients. These results showed that the plants used in this research can be used as an alternative for low-cost bacterial cellulose production.
About yield, Nascimento et al.[22], produced BC films using HS medium and added grape residues extract in situ and ex situ in order to obtain an antioxidant material and after 7 days of fermentation, the highest yield was 134.45 ± 1.92 g. L.-1 for hydrated BC incorporated with 25% wt of grape residue extract in situ and lowest one was 84.45 ± 2.35 g.L.-1 for membrane produced with 100% wt of grape residue extract. They concluded that percentage of HS medium influences directly the yield obtained, higher amount of HS medium, higher the yield. Nóvak et al.[23], produced BC pellicles with different cultive media and analysed the possible interference of these methods on characteristics of the BC and results showed that the highest production of BC (wet mass), after 12 days, was produced by microbial consortium produced in black tea (28.49 ± 13.75 g.L-1). They related the result obtained to the carbon source used in each culture medium and new material presented the
Table 2. Yield of wet pellicle in the different culture media. Medium
± 1.06
± 2.21
± 2.29
± 2.37
± 0.87
same properties as those produced by the pure strain in a synthetic culture medium. Barros et al. (2025)[24], developed BC using an alternative culture media with mandacaru fruit in different concentration and the highest wet mass was 394.20 ± 17.96g, with 80% wt of fruit, after 15 days of fermentation. They proposal a new and low-cost culture media to replace HS media for BC production.
Several factors may have contributed to the results shown in Table 2; for example, certain xanthines such as theaflavin, thearubigin and caffeine can stimulate the production of cellulose by bacteria. Bacterial cells are also stimulated by vitamins and other nutrients that are released because of the autolysis of yeast cells[25]. In other cases, extracts with antimicrobial compounds and infusions produced with leaves that exceed 6,0 g/L can restrict the growth of acetic acid bacteria and decrease cellulose synthesis[26,27]
P. B. F.
S., Souza, K. C., Feitosa, R. L. M., Andrade, D. S. C., Oliveira, D. K. M., Silva, F. S., Melo, A. P., & Vinhas, G. M.
The diffusion of the antimicrobial agent forms a halo of inhibition against the exposed microorganisms, and this method allows the sample to be classified as susceptible (diameters above 18 mm); intermediate (diameters between 9 and 18 mm) or resistant to the antimicrobial (diameters less than 9 mm)[28]
Kombucha and its residues are known to have antimicrobial activity against Gram-positive and Gram-negative microorganisms due to the presence of active components that facilitate permeation of the cell pellicle, interfere in the synthesis of nucleic acid and essential metabolites, causing damage to the cytoplasmic pellicle, leading to cell death [7,29,30]. Higher resistance to Gram-negative microorganisms is due to their structure being more complex than that of Gram-positive microorganisms, due to the presence of an additional cell layer of peptidoglycan reinforced by another polysaccharide wall, making it difficult for active agents to attack them[31]. Figure 2 show the results of the analysis of the pellicles produced with the various plant extracts against the microorganisms evaluated after 24 hours and Table 3 shows the inhibition halos of the films.
Excepting DV100 sample, other samples showed the ability to inhibit microbial growth against E.coli and were classified as intermediate (CA100, CA50, IG100, PA100, DV50 ,DI100,DI50 and PE50) and susceptible (IG50, PA50 and PE100). This result is according to other studies that have tested Dioclea violacea extract against E.coli and found bacterial growth. The weak antimicrobial activity observed for the DV100 sample (produced with 100% Dioclea violacea infusion) may be attributed to multiple factors. Although Dioclea violacea contains bioactive compounds such as lectins and phenolics, some studies have shown that its lectin alone is not effective in inhibiting
bacterial growth, especially against E. coli, unless used in combination with conventional antibiotics. For example, Santos et al.[32] evaluated the antimicrobial activity of lectin from Dioclea violacea against S. aureus, E. coli and P. aeroginosa and found growth of the bacteria tested at the highest concentration used (1024 μg/mL), indicating that the protein doesn’t have antibacterial activity when tested alone. Although microorganisms possess various carbohydrates that interact with plant lectins, preventing initial adhesion and the formation of bacterial biofilms, DV lectin alone wasn’t effective, but enhance the action of antibiotics when combined, suggesting a more effective use in conjunction with antimicrobial agents.
Additionally, it is possible that at the tested concentration and under the diffusion conditions of the disc assay, the active compounds did not diffuse efficiently through the agar medium, particularly if they have low polarity or high molecular weight, which limits their availability to act on microbial cells[33]
Production and reuse of kombucha waste for cellulose production from different plants
Microorganisms inhibition growth depends on the minimum inhibitory concentration of the active agent present in the extract and the absence of an inhibition halo doesn´t mean that the extract is not active against the microorganisms analyzed, but that diffusion has not been completed, as occurs with low-polar compounds where diffusion takes place slowly[34 35]
The largest inhibition halos against E. coli were seen in the PE50 samples, which is explained by the additive interactions between the active agents of Camellia sinensis and Pterodon emarginatus. In addition to antimicrobial activity, Pterodon emarginatus has antioxidant, anti-inflammatory and antibiotic activity[16,36]
Regarding inhibition against S. aureus, all samples were susceptible to inhibition of microbial growth and the largest halo found were in samples DL100 and DL50, both with antimicrobial activity. According to Sousa et al.[37] the essential oil of D. lanceolata bark can inhibit the growth of S. pyogenes, E. coli and C. albicans with a MIC in the range of 20 to 125µg/mL and S. aureus at a concentration of 5 to 10 mg.
The spectra of the BC pellicles and the main characteristic bands are shown in Figure 3 in accordance with the literature[7,38]
According to Figure 3, for the BC pellicle, there is a peak at 3346 cm-1 which is associated with the vibrational stretching of the hydroxyl group (-OH) of water and polysaccharides. Another peak at 2927 cm-1 is related to the symmetrical and asymmetrical vibrations of the methyl -CH3 and methylene -CH2 groups associated with the cellulose matrix[26,39]. The absorption band at 1632 cm-1 corresponds to the deformation vibrations of the -OH groups of the water bond. The bands in the 1000 to 1200 cm-1 region refer to the C-O-C deformation and C-O vibrations, for example, at 1113 cm-1 the peak is attributed to the stretching of the C-O bond and at 1054 cm-1 the highest absorbance was found due to the vibrations of the carbohydrate rings and the secondary groups (C-O-C; C-OH), confirming the presence of vibrations of the β-1,4 bonds in the polymer matrix[22,38,39]
The FTIR spectra of the pellicles obtained from different fermentation media did not show significant differences in terms of band position. All samples exhibited the characteristic absorption bands of bacterial cellulose, and no distinct peaks attributable to specific plant extracts were clearly identified. Minor variations in signal intensity were observed; however, these differences may be attributed to experimental factors such as sample contact with the ATR crystal or inherent variability in the measurements. The results suggest that, despite the use of different plant infusions, the chemical structure of the pellicles remains essentially the same, with bacterial cellulose as the predominant component[22,24,39].
The SEM micrographs of the BC membranes obtained from different kombucha culture media are shown in Figure 4. Overall, the samples exhibit heterogeneous surface morphologies, depending on the type of plant infusion used in the culture medium.
In several samples, notably BC (Figure 4a) and CA50 (Figure 4c), the surface shows a relatively smooth and compact structure, with regions suggesting continuous film-like formation. These characteristics may reflect a dense cellulose layer formed under static fermentation conditions[22]
In contrast, samples such as IG100 and IG50 (Figures 4d and 4e) display dispersed particulates on the surface, likely corresponding to residual plant components retained during BC formation. The presence of these residues confirms the interaction of plant material with the cellulose matrix during biosynthesis.
In PA50 and DV100 (Figures 4f and 4h), surface irregularities and granular features can be observed, possibly resulting from the incorporation of bioactive compounds or metabolites from the plant infusions[7]. Some films, particularly DL100 and DL50 (Figures 4j and 4k), exhibit a more homogeneous surface but with visible texture, indicating partial aggregation or rearrangement of the polymer network during drying.
Samples PE100 and PE50 (Figures 4l and 4m) show a denser and more compact morphology, with reduced surface features, suggesting that the plant extract components may have contributed to film compaction or limited the typical fibrillar formation during bacterial cellulose synthesis[22,26]. While high-resolution nanofibrils are not distinguishable at the current magnification, morphological differences between the samples are evident, supporting the influence of the plant extracts on membrane surface characteristics[40,41].
Thermal stability of produced films with different culture media was checked by TGA. The thermal decomposition profiles obtained by the analysis are shown in Figure 5, the first derivative curves of mass variation with time (DTG) are shown in Figure 6 and the results for initial degradation temperature (Tonset), final temperature (Tendset) and maximum degradation temperature (Tmax) of the pellicles are shown in Table 4.
BC pellicles from kombucha showed two stages of thermal decomposition. All BC films of standard kombucha showed a mass loss due to water evaporation (31.72°C to 86.62°C)

Luna, P. B. F. G. S., Souza, K. C., Feitosa, R. L. M., Andrade, D. S. C., Oliveira, D. K.
M.,
Silva, F. S., Melo, A. P., & Vinhas, G. M.
and the 2nd stage was in the range of 290.17°C to 357.35°C due to cellulose degradation including depolymerization, dehydration, glucose decomposition and later residue formation[9,10,26]. BC films obtained from the fermentation various teas presented a loss of volatile compounds, mainly water and the degradation of low molecular weight molecules from the extracts (29.44 - 155.47°C); a decomposition of micro and macro compounds present in the extracts such as tannins, phenolic compounds, nucleic acids and phospholipids[26] (109.67 - 283.78°C) and a degradation of non-degradable residues, mainly mineral residues in addition to cellulose degradation itself[25,40] (265.29 - 387.05 °C).

Sample
30.93
Production and reuse of kombucha waste for cellulose production from different plants



According to Table 4, samples from the different plant extracts have greater thermal stability, except for
IG50 pellicle, due to the onset temperatures (Tonset) of the cellulose degradation stage in the pellicles produced from the different teas were higher than those of the standard kombucha pellicles.
The diffractograms of produced pellicles are shown in Figure 7 and the analysis was performed to verify if the plant extracts interfered with the crystallinity of the pellicles. All samples showed 2 diffraction peaks, one around 14,6° and another more intense one around 22,79°, corresponding to the (110) and (200) crystal planes respectively. In some samples, a peak can be seen around 16,61° corresponding to the (010) crystalline plane, which is also found in bacterial cellulose samples [22][25]. These results show a typical structure of type I cellulose[7,22,42]
Samples obtained from the various teas showed less intense peaks than the kombucha pellicle (BC), with a reduction in the crystallinity of the pellicles. This reduction in intensity may be related to how phenolics interact during cellulose production[7]. Based on these results, it was possible to obtain crystallinity index to assess the crystalline and amorphous structure of the pellicles, which are shown in Table 5
According to Table 5, produced pellicles with different teas have lower crystallinity than kombucha pellicles crystallinity. In situ addition can interfere with the crystallinity of the pellicles, modifying the structure and properties of the produced pellicles due to the interaction of plant components in the polymer chain [22].
Bacterial cellulose pellicles were obtained from kombucha and plant extracts from north-eastern Brazil. Thermal analysis showed a reduction in the crystallinity of the pellicles and the appearance of a third stage of degradation. The FTIR showed bands characteristic of bacterial cellulose. In the antimicrobial analysis, all the films showed a halo of inhibition against S. aureus. The plant extracts were efficient in producing BC and it could be promising for use in food packaging, given that plant extracts are rich in phenolic compounds that have antimicrobial activity.
• Conceptualization – Glória Maria Vinhas.
• Data curation – NA.
• Formal analysis – Pâmela Barcelar Ferreira Gomes da Silva de Luna; Karina Carvalho de Souza; Daniella Stepheny Carvalho Andrade; Rhodivam Lucas Mendes Feitosa; Glória Maria Vinhas.
• Funding acquisition - Glória Maria Vinhas.
• Investigation – Pâmela Barcelar Ferreira Gomes da Silva de Luna; Karina Carvalho de Souza.
• Methodology – Pâmela Barcelar Ferreira Gomes da Silva de Luna; Karina Carvalho de Souza; Rhodivam Lucas Mendes Feitosa; Daniella Stepheny Carvalho Andrade; Dayanna Kelly Marques de Oliveira; Fernanda Sobreira Silva; Alexciana Pereira de Melo.
• Project administration – Glória Maria Vinhas.
• Resources – Glória Maria Vinhas.
• Software – NA.
• Supervision – Glória Maria Vinhas.
• Validation – Glória Maria Vinhas.
• Visualization – Pâmela Barcelar Ferreira Gomes da Silva de Luna; Karina Carvalho de Souza; Glória Maria Vinhas.
• Writing – original draft – Pâmela Barcelar Ferreira Gomes da Silva de Luna; Karina Carvalho de Souza; Rhodivam Lucas Mendes Feitosa; Daniella Stepheny Carvalho Andrade; Glória Maria Vinhas.
• Writing – review & editing – Pâmela Barcelar Ferreira Gomes da Silva de Luna; Karina Carvalho de Souza; Dayanna Kelly Marques de Oliveira; Fernanda Sobreira Silva; Alexciana Pereira de Melo; Glória Maria Vinhas.
6. Acknowledgements
Financial support Foundation for the support of Science and Technology of State of Pernambuco (FACEPE).
7. References
1 Fonteles, T. V., Santos, A. Y. S., Linhares, M. F. D., Miguel, T. B. A. R., Rodrigues, E. C. M., & Rodrigues, S. (2024). Metabolic responses of kombucha consortium fermentation upon ultrasound-processing. Food Chemistry Advances, 4, 100646
2 Jayabalan, R., Malbaš, R. V., Lončar, E. S., Vitas, J. S., & Sathishkumar, M. (2014). A review on kombucha tea-microbiology, composition, fermentation, beneficial effects, toxicity, and tea fungus. Comprehensive Reviews in Food Science and Food Safety, 13(4), 538-550 http://doi.org/10.1111/1541-4337.12073 PMid:33412713.
3 Semjonovs, P., Ruklisha, M., Paegle, L., Saka, M., Treimane, R , Skute, M., Rozenberga, L., Vikele, L., Sabovics, M., & Cleenwerck, I (2017). Cellulose synthesis by Komagataeibacter rhaeticus strain P 1463 isolated from kombucha. Applied Microbiology and Biotechnology, 101(3), 1003-1012 http://doi.org/10.1007/ s00253-016-7761-8 PMid:27678116.
4 Cavicchia, L. O. A., & Almeida, M. E. F. (2022). Health benefits of kombucha: drink and its biocellulose production. Brazilian Journal of Pharmaceutical Sciences, 58, e20766 http://doi.org/10.1590/s2175-97902022e20766
5 Laavanya, D., Shirkole, S., & Balasubramanian, P. (2021). Current challenges, applications and future perspectives of SCOBY cellulose of kombucha fermentation. Journal of Cleaner Production, 295, 126454 http://doi.org/10.1016/j.jclepro.2021.126454
6 Brasil Instrução normativa n° 41, de 17 de setembro de 2019 (2019, 18 de September). Estabelece o padrão de identidade e qualidade da kombucha em todo o território nacional. Diário Oficial da República Federativa do Brasil, Brasília, Seção 1 Retrieved in 2025, May 1, from https://pesquisa.in.gov.br/ imprensa/jsp/visualiza/index.jsp?data=18/09/2019&jornal= 515&pagina=13&totalArquivos=76
7 Fernandes, I. A. A., Maciel, G. M., Ribeiro, I. S., Pedro, A. C , Bortolini, D. G., Ribeiro, V. R., Barros, L., & Haminiuk, C. W. I. (2023). Biosorption of bioactive compounds in bacterial nanocellulose: mechanisms and physical-chemical properties. International Journal of Biological Macromolecules, 240, 124349 http://doi.org/10.1016/j.ijbiomac.2023.124349 PMid:37054855.
8 Emiljanowicz, K. E., & Malinowska-Panczyk, E. (2019). Kombucha from alternative raw materials–The review. Critical Reviews in Food Science and Nutrition, 60(19), 3185-3194 http://doi.org/10.1080/10408398.2019.1679714 PMid:31657623.
9 Oliveira, R. V., Kumineck, S. R., Jr., Garcia, M. C. F., Apati, G. P., Leitzke, T. C. G., Schneider, A. L. S., & Pezzin, A. P. T. (2022). Biocompósito biodegradável hidrofóbico à base de amido de banana verde associado à celulose bacteriana. Matéria (Rio de Janeiro), 27(1), e202149059 http://doi. org/10.1590/1517-7076-rmat-2021-49059
10 Neves, E. Z., Kumineck, S. R., Jr., Katrucha, G. P., Silveira, V. F., Silveira, M. L. L., Pezzin, A. P. T., Schneider, A. L. S , Garcia, M. C. F., & Apati, G. P. (2022). Development of Bacterial Cellulose Membranes Incorporated with Plant Extracts. Macromolecular Symposia, 406(1), 2200031 http://doi.org/10.1002/masy.202200031
11 Abhilash, M., & Thomas, D. (2017). Biopolymers for biocomposites and chemical sensor applications. In K. K. Sadasivuni, J. Kim, & M. A. AlMaadeed (Eds.), Biopolymer Composites in Electronics (pp. 405-435). Cham: Elsevier Inc. http://doi.org/10.1016/ B978-0-12-809261-3.00015-2
12 Melo, E. A., Maciel, M. I. S., Lima, V. L. A. G., & Nascimento, R. J. (2008). Capacidade antioxidante de frutas. Brazilian Journal of Pharmaceutical Sciences, 44(2), 193-201
13 Leonarski, E., Cesca, K., Zanella, E., Stambuk, B. U., Oliveira, D., & Poletto, P. (2021). Production of kombucha-like beverage and bacterial cellulose by acerola byproduct as raw material. Lebensmittel-Wissenschaft + Technologie , 135, 110075 http://doi.org/10.1016/j.lwt.2020.110075
14 Chandrasekara, A., & Shahidi, F. (2018). Herbal beverages: bioactive compounds and their role in disease risk reduction - A review. Journal of Traditional and Complementary Medicine, 8(4), 451-458 http://doi.org/10.1016/j.jtcme.2017.08.006 PMid:30302325.
15. Radice, M., Scalvenzi, L., & Sablón Cossio, N. (2016). Ilex guayusa: a systematic review of its traditional uses, chemical constituents, biological activities and biotrade opportunities In MOL2NET’16, Conference on Molecular, Biomedical, and Computational Sciences and Engineering Basel, Switzerland
16 Moraes, T. V., Souza, M. R. A., Simão, J. L. S., Rocha, C. B., & Moreira, R. F. A. (2019). Potencial antioxidante da espécie Pereskia aculeata miller: uma análise bibliométrica. Brazilian Journal of Surgery and Clinical Research, 29(1), 79-85 Retrieved in 2025, May 1, from https://www.mastereditora. com.br/periodico/20191208_113831.pdf
17 Santos, A. C., Nogueira, M. L., Oliveira, F. P., Costa, E. V., & Bezerra, D. P. (2022). Essential oils of Duguetia species A. St. Hill (Annonaceae): chemical diversity and pharmacological potential. Biomolecules, 12(5), 615 http://doi.org/10.3390/ biom12050615 PMid:35625543.
Production and reuse of kombucha waste for cellulose production from different plants
18 Gonçalves, G. L. P., Domingues, V. C., Ribeiro, L. P., Fernandes, J. B , Fernandes, M. F. G., Forim, M. R., & Vendramim, J. D. (2017). Compounds from Duguetia lanceolata St.-Hil. (Annonaceae) bioactive against Zabrotes subfasciatus (Boheman) (Coleoptera: Chrysomelidae: Bruchinae). Industrial Crops and Products, 97, 360-367 http://doi.org/10.1016/j.indcrop.2016.12.032
19. Di Miceli, J. F. F., Andrade, M. E. R., Carvalho, P. L. A., Santos, E. A , Oliveira, A. E. M. F. M., Fernandes, C. P., Cruz, R. A. S., Garrett, R., Mosqueira, V. C. F., Cassali, G. D., D’Haese, C., Nysten, B., Leite, J. I. A., Cardoso, V. N., & Araújo, R. S (2022). Lecithin-based nanocapsule loading sucupira (Pterodon emarginatus) oil effects in experimental mucositis. Toxicology Reports, 9, 1537-1547 http://doi.org/10.1016/j. toxrep.2022.07.006 PMid:36518414.
20. Bauer, A. W., Kirby, W. M. M., Sherris, J. C., & Turck, M. (1966). Antibiotic susceptibility testing by a standardized single disk method. American Journal of Clinical Pathology, 45(4), 493-496 http://doi.org/10.1093/ajcp/45.4_ts.493 PMid:5325707.
21 Segal, L., Creely, J. J., Martin, A. E., Jr., & Conrad, C. M (1959). An empirical method for estimating the degree of crystallinity of native cellulose using the X-ray diffractometer. Textile Research Journal, 29(10), 786-794 http://doi.org/10.1177/004051755902901003
22 Nascimento, H. A., Amorim, J. D. P., Moraes, L. E. P. T., Fo., Costa, A. F. S., Sarubbo, L. A., Napoleão, D. C., & Vinhas, G. M. (2022). Production of bacterial cellulose with antioxidant additive from grape residue with promising cosmetic applications. Polymer Engineering and Science, 62(9), 2826-2839 http://doi.org/10.1002/pen.26065
23 Nóvak, I. C., Segat, B., Garcia, M. C. F., Pezzin, A. P. T., & Schneider, A. L. S. (2024). Alternative production of bacterial cellulose by Komagataeibacter hansenii and microbial consortium. Polímeros: Ciência e Tecnologia, 34(2), e20240021
24 Barros, A. C. O. D. B., Silva, I. D. L., Simões, A. N., Pereira, J. F. Q., Brito, A. M. S. S., & Vinhas, G. M. (2025). Production and characterization of bacterial cellulose by Komagataeibacter hansenii UCP1619 using the fruit of Cereus jamacaru DC as an alternative medium. Journal of the Brazilian Chemical Society, 36(11), e-20250120
25 Chakravorty, S., Bhattacharya, S., Chatzinotas, A., Chakraborty, W., Bhattacharya, D., & Gachhui, R. (2016). Kombucha tea fermentation: microbial and biochemical dynamics. International Journal of Food Microbiology, 220, 63-72 http://doi.org/10.1016/j. ijfoodmicro.2015.12.015. PMid:26796581.
26 Tapias, Y. A. R., Di Monte, M. V., Peltzer, M. A., & Salvay, A. G. (2022). Bacterial cellulose films production by kombucha symbiotic community cultured on different herbal. Food Chemistry, 372, 131346. http://doi.org/10.1016/j.foodchem.2021.131346. PMid:34818748.
27 Gaggìa, F., Baffoni, L., Galiano, M., Nielsen, D. S., Jakobsen, R. R., Castro-Mejía, J. L., Bosi, S., Truzzi, F., Musumeci, F., Dinelli, G., & Di Gioia, D. (2019). Kombucha beverage from green, black and rooibos teas: a comparative study looking at microbiology, chemistry and antioxidant activity. Nutrients, 11(1), 1 http://doi.org/10.3390/nu11010001 PMid:30577416.
28. Sejas, L. M., Silbert, S., Reis, A. O., & Sader, H. S. (2003). Avaliação da qualidade dos discos com antimicrobianos para testes de disco-difusão disponíveis comercialmente no Brasil. Jornal Brasileiro de Patologia e Medicina Laboratorial, 39(1), 27-35. http://doi.org/10.1590/S1676-24442003000100006.
29 Battikh, H., Chaieb, K., Bakhrouf, A., & Ammar, E. (2013). Antibacterial and antifungal activities of black and green kombucha teas. Journal of Food Biochemistry, 37(2), 231-236 http://doi.org/10.1111/j.1745-4514.2011.00629.x.
30 Morais , M. G. C. , Menezes , M. S. , Bordulis , C. B. T. , Santos, P. A., Costa, M. R. S., & Lima, T. P. (2022). Nutritional
and biotechnological potential of SCOBY produced in green tea fermentation. Research Social Development, 11(11), e575111134064.
31 Valeriano, C., Piccoli, R. H., Cardoso, M. G., & Alves, E. (2012). Atividade antimicrobiana de óleos essenciais em bactérias patogênicas de origem alimentar. Revista Brasileira de Plantas Medicinais, 14(1), 57-67 http://doi.org/10.1590/ S1516-05722012000100009.
32 Santos, V. F., Araújo, A. C. J., Silva, A. L. F., Almeida, D. V., Freitas, P. R., Santos, A. L. E., Rocha, B. A. M., Garcia, W., Leme, A. M., Bondan, E., Borges, F. T., Cutrim, B. S., Silva, L. C. N., Coutinho, H. D. M., & Teixeira, C. S. (2020). Dioclea violacea lectin modulates the gentamicin activity against multiresistant strains and induces nefroprotection during antibiotic exposure. International Journal of Biological Macromolecules, 146, 841-852 http://doi.org/10.1016/j. ijbiomac.2019.09.207 PMid:31726163.
33 Pereira, M. S. V., Ribeiro, A. D., Figueirêdo Júnior, E. C., Freire, J. C. P., Costa, M. M. A., & Pereira, J. V. (2022). Estudo sobre métodos utilizados para a determinação da atividade antimicrobiana de extratos de plantas medicinais: elucidações e limitações das técnicas. Brazilian Journal of Development, 8(4), 26085-26104 http://doi.org/10.34117/ bjdv8n4-222
34 Moreno, S., Scheyer, T., Romano, C. S., & Vojnov, A. A. (2006). Antioxidant and antimicrobial activities of rosemary extracts linked to their polyphenol composition. Free Radical Research, 40(2), 223-231 http://doi.org/10.1080/10715760500473834 PMid:16390832.
35 Figueira, L. W., Oliveira, J. R., Sper, F. L., Meccatti, V. M., Oliveira, L., & Oliveira, L. D. (2017). Extrato de chá verde ( Camellia sinensis) promove ação antimicrobiana sobre Staphylococcus aureus Revista Univap, 22(40), 245
36 Hoscheid, J., & Cardoso, M. L. (2015). Sucupira as a potential plant for arthritis treatment and other diseases. Arthritis (Egypt), 2015(1), 379459 http://doi.org/10.1155/2015/379459 PMid:26613051.
37 Sousa, O. V., Del-Vechio-Vieira, G., Alves, M. S., Araújo, A. A. L , Pinto, M. A. O., Amaral, M. P. H., Rodarte, M. P., & Kaplan, M. A. C (2012). Chemical composition and biological activities of the essential oils from Duguetia lanceolata St. Hil. barks. Molecules (Basel, Switzerland), 17(9), 11056-11066 http://doi.org/10.3390/ molecules170911056 PMid:22976469.
38 Atykyan, N., Revin, V., & Shutova, V. (2020). Raman and FT-IR spectroscopy investigation of cellulose structural differences from bacteria Gluconacetobacter sucrofermentans during the different regimes of cultivation on a molasses media. AMB Express, 10(1), 84 http://doi.org/10.1186/s13568-020-01020-8 PMid:32363535.
39 Sharma, C., & Bhardwaj, N. K. (2020). Fabrication of natural-origin antibacterial nanocellulose films using bio-extracts for potential use in biomedical industry. International Journal of Biological Macromolecules, 145, 914-925 http://doi.org/10.1016/j. ijbiomac.2019.09.182. PMid:31669468.
40 Cazón, P., Puertas, G., & Vázquez, M. (2024). Characterization of multilayer bacterial cellulose-chitosan films loaded with grape bagasse antioxidant extract: insights into spectral and water properties, microstructure, and antioxidant activity. International Journal of Biological Macromolecules, 268(P2), 131774 http://doi.org/10.1016/j.ijbiomac.2024.131774 PMid:38663700.
41 Molin, M. L., Segat, B., Garcia, M. C. F., Pezzin, A. P. T., Silveira, M. L. L., & Schneider, A. L. S. (2023). Development and characterization of bacterial cellulose pellicle incorporated with witch hazel extract. Matéria (Rio de Janeiro), 28(2), e20230008 http://doi.org/10.1590/1517-7076-rmat-2023-0008
Luna, P. B. F. G. S., Souza, K. C., Feitosa, R. L. M., Andrade, D. S. C., Oliveira, D. K. M., Silva, F. S., Melo, A. P., & Vinhas, G. M.
42 Li, J., Chen, G., Zhang, R., Wu, H., Zeng, W., & Liang, Z. (2019). Production of high crystallinity type-I cellulose from Komagataeibacter hansenii JR-02 isolated from kombucha tea. Biotechnology and Applied Biochemistry, 66(1), 108-118 http://doi.org/10.1002/bab.1703 PMid:30359481.
Received: May 01, 2025
Revised: Aug. 14, 2025
Accepted: Aug. 27, 2025
Associate Editor: Artur J. M. Valente
Polímeros, 35(4), e20250045, 2025
Arthur Henrique Theiss1 and Diego Alves de Miranda1*
1Departamento de Engenharia Mecânica, Universidade da Região de Joinville – UNIVILLE, 89288-385, São Bento do Sul, SC, Brasil *diegoalves_klx@hotmail.com
Obstract
Several numerical simulation strategies for polymer melt flow have been used to optimize simulation time and reduce numerical errors. It is known that in this type of flow, the emergence of numerical diffusion in the cavity walls is common due to the high stresses caused by highly viscous fluids. In order to avoid uniformly refining the entire mesh and increasing simulation time, a common strategy is to use a localized refinement on the cavity walls. In this context, this study presents a standardization in the smoothing of the mesh on the cavity walls for simulations of transient nonisothermal flow of polymer melts. The main results showed that this type of application is highly efficient and contributes to reducing the time and computational effort of simulations of complex cavities with good accuracy
Keywords: injection molds, numerical methodology, molten polymers, smooth mesh refining.
Data Ovailability: Research data is available upon request from the corresponding author.
How to cite: Theiss, A. H., & Miranda, D. A. (2025). Analysis of wall-smoothed mesh refinement in polymer melt transient flow. Polímeros: Ciência e Tecnologia, 35(4), e20250046. https://doi.org/10.1590/0104-1428.20250010
The study of the transient flow of molten polymers is crucial to understanding and optimizing industrial processes, such as extrusion and injection, used in the production of plastic materials[1]. This increase in demand for numerical simulations is due to the fact that through their application it is possible to analyze the behavior of fluids during processes and thus carry out the development of new products and manufacturing improvements without the need for excessive expenses on prototypes or even high demand for project time[2]. Added to the recent technological development and increase in computing capacity, its application has become widespread, having high demand in the current engineering market[3]. However, numerical simulation of these processes presents challenges due to the complexity of the nonNewtonian behavior of polymers and the temporal and spatial scales involved[4]. In this context, mesh refinement is a fundamental step to ensure the accuracy and efficiency of simulations[5]. Mesh quality can significantly affect the stability and convergence of results, especially in transient problems[6]
Numerous experimental and theoretical studies have sought to understand the fundamental aspects behind the rheological responses of polymer melts[7-9]. Guerrier et al. [10] state that numerical simulations are widely applied because they allow tests and analyses to be carried out without the need for test specimens or prototypes, reducing study costs. Herrera and Vieira[11] show that it is crucial to understand the structural and dynamic behaviors of molten polymer molecules in order to manufacture high-
quality products. Zhang et al.[12] analyzed adaptive mesh refinement for multiphysics applications through the AMReX software framework, highlighting its possible applications. Sanjaya et al.[13] analyzed the results of simulations with different mesh sizes for wheel rims using the finite element method and compared the accuracy of the results obtained.
Therefore, this study performed the analysis of smoothed mesh refinement in transient polymer melt flow simulations. Innovative and efficient approaches to improve accuracy and reduce computational time are discussed, contributing to significant advances in the modeling and simulation of polymer transformation processes. This study aims to help reduce the computational time spent on simulations and consequently increase the productivity of thermoplastic processing industries. The software used was Ansys Fluent® 2023.R2 and the thermophysical data and rheological properties for verification were taken from the studies carried out by Hétu et al.[14] and Miranda et al.[15]
2.1 Overview
This study proposes a fully numerical approach to verify the accuracy of smoothed mesh refinement in transient laminar flow of polymer melts. The simulation conditions are shown below.
The governing equations use the generalized Newtonian formulation (GNF) using Ansys Fluent® 2023.R2, which incorporates the diffusive and convective terms in its original formulation, in addition to resolving these terms in a twodimensional formulation. Thus, the conservation equations are solved for conservation of mass, momentum and energy, in a fully coupled manner, these differential equations are respectively written as Zdanski and Vaz[16] .
IfFforapointinsidethepolymerdomain IfFInterfacebetweenthephasespresent IfFforapointinsideairdomain (7)
Since the density and dynamic viscosity of the air phase are much lower than those of the same polymer properties, it is assumed that interfacial tension has no relevant effects on the flow. Therefore, in the numerical analysis, the air is replaced by a pseudo-fluid, which has physical properties greater than the real ones.
Currently, several rheological models have been developed for applications in simulations of polymers of the most different types of fluid flows. In the study of Miranda et al.[18], several models were tested and compared in relation to obtaining a flow front closer to an experimental result. Based on this study, the authors found that the Modified Cross II (MC – II) model yields good results, and for this reason, this rheological model will be chosen to describe the viscosity of the polymer flow during flow. The modified Cross model assumes a pseudoplastic regime and incorporates the temporal relaxation factor of the fluid, being widely applied to model complex systems. The model depends on the deformation rate and temperature, and the equation to be solved is[18]:
where ( ) , T ηγ is the apparent viscosity and the term γ represents the equivalent deformation rate, which is written as:
The term F is the volume fraction and is determined by the Volume of Fluid (VOF) method.
2.2.1 Volume of fluid (VOF)
The momentum conservation equation is intrinsically associated with the viscosity constitutive relation. The VOF method considers some linear correlations to estimate the viscosity and specific mass at the interface between the molten polymer and the air presented[17]:
In Equations 6, aρ and aµ are the specific mass and dynamic viscosity of the air, while pρ and pµ are the specific mass and dynamic viscosity of the polymer, where ( ) , p T µηγ = , is the property that comes from the rheological model. The function of the volume fraction phase F is defined by the following transport equation[17]:
The polymer chosen for this study was Thermoplastic Olefin (TPO), as it has already been used by other authors and obtained all its known thermophysical properties. The rheological properties of TPO for MC – II are summarized in Table 1[18]
For coupling pressure into the velocity equations in the generalized newtonian fluid (GNF) model, the PISO (Pressure-Implicit with Splitting of Operators) method was used[19]
In order to validate the results obtained, the geometry and boundary conditions used by Hétu et al. [14] and Miranda et al.[15] were taken as standard, as represented in Figure 1.
Analysis of wall-smoothed mesh refinement in polymer melt transient flow
The dimensions are respectively 0 100 Lmm = and 0 10 Hmm = , in addition a flow front in laminar flow and boundary conditions without slip for the cavity walls were defined. The flow front velocity along the geometry can be defined through Equation 10, applied in the validation to ensure an initial condition of the flow front closer to the real one considering the interactions between the fluid and the cavity walls and their respective stresses[20]
In some initial tests, it was determined that the mesh size in x would be constant, in which 40 divisions ( 0 /40 xL∆= ) proved to be a mesh size with good results. Therefore, the mesh 2.50 xmm∆= was maintained. The Courant number is a local scalar quantity of the fluid domain that represents the advective flow in each control volume.
In its initial condition, the mold cavity is completely filled with air and the initial temperature of the walls, thus all thermophysical properties of the fluids applied in the multiphase validations[18] are represented in Table 2
Mesh convergence analysis is extremely fundamental for numerical simulations of transient flow of molten materials[21]. Marin et al.[22] compared the effect of mesh density in the injection pressure, reaching highest precision in a dual-domain mesh with sizes between 2.0 and 4.0 mm. It is worthy to note that the aforementioned mesh sizes are associated with the part or product sizes and shape, especially thickness variations and the presence of free-form shapes. Therefore, one must observe the relative mesh size in order to avoid defining over or under refined meshes.
To maintain the consistency of the transient solutions, considering an initial maximum velocity at the center of the cavity i uU = , a 0.125 ts∆= was initially found. Therefore, all simulations initially have the Courant number 0.50 σ = , which can be considered a value that generates good results for the simulations[15]
To perform the validations of the proposed models, the simulation was applied based on the generation of 5 different types of meshes with an increasing refinement rate Bias Factor (BF) in the cells close to the boundary walls, that is, only in y , as shown in Figure 2
This type of refinement should increase the accuracy of calculations in regions close to the walls of the geometry, avoiding problems such as numerical diffusion. However, the number of nodes and elements will not be changed when applied. Therefore, for all generated meshes, the number of nodes will remain at 861 and the number of elements at 800. The Bias factor, applied to the y –axis and responsible for refining the mesh near the walls of the geometry, doubled for each mesh generated, ranging from 1 to 16, as shown in Table 3

This implies that BFh = , ou seja 1 1.0 h = , 2 2.0 h = , 3 4.0 h = , 4 8.0 h = and 5 16.0 h = . Richardson[23] estimation requires meshes with equal refinement ratio, where r is the refinement ratio:
Thus defining a refinement rate 2.0 r = for the Richardson extrapolation method, subsequently applied to measure the degree and order of the discretization error in the calculations performed and evaluate the effect of this refinement on the results obtained. Figure 3 demonstrates the compilation of the generated meshes.
In order to qualitatively validate the results obtained in the simulations and after applying the Richardson
extrapolation method, the following dimensionless variables were adopted[18]:
In addition, five lines were plotted along the geometry, from which the values for speed and temperature were generated and analyzed at different time intervals in the validations. Figure 4 represents the geometry and the lines defined for the analysis.
Following the applied dimensionless modeling, the positions of the lines were defined as: * 1.0 x = ; * 2.5 x = ; * 5.0 x = ; * 7.5 x = and * 10.0 x = . Furthermore, the time




where
This section will address the results of the numerical approaches applied and their respective discussions.
To visually verify the effect of numerical diffusion, the flow through the injection channel of Hétu et al.[14] was simulated in all meshes (Figure 5).
Initially, a qualitative analysis of the results generated by the simulations of different meshes can be made. It can be seen that as the Bias Factor increases, the effects of numerical diffusion reflected on the cavity walls become smaller. These numerical diffusion bubbles become worse as the simulation time increases, i.e., the time variable will increase the numerical error of simulations that obtain coarser meshes.
By applying the Bias Factor it was possible to verify the effects of the smoothed mesh refinement on the accuracy of the results obtained in the simulations. The following Tables 4 to 8 summarize all the results obtained for * u and * T throughout the 5 numerical simulations applied.
To verify the accuracy of the simulations and the order of the mesh errors in the flow of molten TPO in the smoothed mesh discretization channel, the Richardson extrapolation method was implemented[23]. The method assumes that the exact solution for exact velocities and temperatures can be estimated at any given point 3 i xR ∈ as:
From the Tables, it is possible to demonstrate that the application of the smoothed mesh refinement throughout the simulations resulted in different values for the same positions and time intervals during the simulated flow. Evidencing that as the mesh refinement rate increased, the precision of the results obtained for the properties under analysis also increased. It is also noted that the relevance of the differences in decimal places obtained in the results is greater for the velocity values when compared with the respective temperatures.
Based on the previous resulting values, the Richardson error extrapolation method was applied in order to optimize the results obtained. The method was applied for * 0.01 x =
A. H., & Miranda, D. A.
Table 5. Velocity and temperature values at * 0.5 y = with 2.0 BF =
Table 6. Velocity and temperature values
Table 7. Velocity and temperature values
, in which it is possible to obtain values for all defined time intervals ( * 2.5 t = to * 20.0 t = ). Table 9 presents the final results obtained after applying the method:
Thus, after applying extrapolation, it became possible to obtain instantaneous values of greater precision for velocities and temperatures over the defined time intervals. In addition, the degree of error in each of the results obtained was defined. Therefore, it is reiterated that the application of the method allows
optimizing the precision of results in numerical approaches without the demand for greater computational capacity and that it proved to be functional for the present study.
From the values obtained in the simulation of the highest refinement rate with 16 BF = .0 and at e * 0.5 x = , the velocity and temperature curves of the exact values were generated and compared with the results obtained by Hétu et al.[14] and Miranda et al.[15] (Figures 6 and 7).
Analysis of wall-smoothed mesh refinement in polymer melt transient flow
Table 8. Velocity and temperature values at * 0.5 y = with 16.0 BF = .
Table 9. Richardson error extrapolation results for * 0.01

6. Transient verification of the fountain flow for the velocity profiles at

7. Transient verification of the fountain flow for the temperature profiles
A. H., & Miranda, D. A.
Analyzing the velocity profiles, there are higher velocity values in the works of Hétu et al.[14] and Miranda et al.[15] because they used a constant velocity at the inlet ( 0 i UU = ), which causes the polymer to advance faster over time. However, this sudden velocity increase causes the polymer to lose more heat and the temperature profiles to drop consequently, while when the inlet velocity is parabolic, it ends up holding the heat for longer. Although the conditions show very divergent results, in real flow conditions, the polymers usually enter in the gates with a parabolic manner, which confirms that the velocity and temperature curves of this study are more appropriate, and that the verification was successful.
Accurate numerical simulations of transient flow of polymer melts are essential to obtain products with desired characteristics, avoiding defects and ensuring process efficiency. This paper presents a numerical approach to smooth mesh refinement in the walls of thermoplastic injection molds and a mesh convergence study using Ansys Fluent® 2023.R2 simulation software. The following points highlight the discussions:
• Initially, the initial velocity equation with parabolic profile proved to be effective in capturing the flow accurately, minimizing the effects of the boundary layer;
• Through the results obtained and validated compared with previous studies, it becomes possible to identify that the application of the smoothed mesh refinement on the walls of the geometry defined for the flow resulted in a significant improvement in the accuracy of the results obtained for the velocity and temperature properties in the applied numerical simulations;
• Furthermore, it was reiterated that through the application of the Richardson error extrapolation method, it was possible to guarantee an improvement in the accuracy of values for certain regions of interest without requiring greater computational resources to obtain them, a fundamental result given the demand for computational resources for simulations in transient regimes;
• Although this study used simple geometry, the qualitative and quantitative results will help engineers reduce the computational time of numerical simulations and consequently increase the productivity of injection mold development with greater efficiency and accuracy.
Furthermore, it is worth highlighting the possibility of future studies using the same method in different types of geometries, such as abrupt expansions, in addition to new analyses for the resulting properties in each of the lines plotted for post-processing of the problem under study and possibly the analysis of other rheological properties of interest.
• Conceptualization – Arthur Henrique Theiss.
• Data curation – Arthur Henrique Theiss; Diego Alves de Miranda.
• Formal analysis – Arthur Henrique Theiss; Diego Alves de Miranda.
• Funding acquisition - NA.
• Investigation – Arthur Henrique Theiss; Diego Alves de Miranda.
• Methodology – Arthur Henrique Theiss; Diego Alves de Miranda.
• Project administration – Diego Alves de Miranda.
• Resources – NA.
• Software – Arthur Henrique Theiss.
• Supervision –Diego Alves de Miranda.
• Validation – Arthur Henrique Theiss; Diego Alves de Miranda.
• Visualization – Arthur Henrique Theiss; Diego Alves de Miranda.
• Writing – original draft – Arthur Henrique Theiss.
• Writing – review and editing – Arthur Henrique Theiss; Diego Alves de Miranda.
The authors gratefully acknowledge CAPES (Coordination for the Improvement of Higher Education Personnel, Brazil) for the financial support.
1 Zhuang, X., Ouyang, J., Jiang, C., & Liu, Q. (2016). New approach to develop a 3D non-isothermal computational framework for injection molding process based on level set method. Chinese Journal of Chemical Engineering, 24(7), 832-842 https://doi.org/10.1016/j.cjche.2016.04.014
2 Gruber, P. A. , & Miranda , D. A. (2020 ). Heat transfer simulation for decision making in plastic injection mold design. Polímeros: Ciência e Tecnologia, 30(1), e2020005 https://doi.org/10.1590/0104-1428.08319
3 Krantz, J., Nieduzak, Z., Kazmer, E., Licata, J., Ferki, O., Gao, P., Sobkowicz, M. J., & Masato, D. (2023). Investigation of pressure-controlled injection molding on the mechanical properties and embodied energy of recycled high-density polyethylene. Sustainable Materials and Technologies, 36, e00651 https://doi.org/10.1016/j.susmat.2023.e00651
4 Miranda, D. A., Rauber, W. K., Vaz, M., Jr., & Zdanski, P. S. B. (2024). A methodology for determination the inlet velocity in injection molding simulations. Polímeros: Ciência e Tecnologia, 34(1), e20240011 https://doi.org/10.1590/0104-1428.20230099
5 Marin, F., Souza, A. F., Ahrens, C. H., & Lacalle, L. N. L. (2021). A new hybrid process combining machining and selective laser melting to manufacture an advanced concept of conformal cooling channels for plastic injection molds. International Journal of Advanced Manufacturing Technology, 113(5-6), 1561-1576 https://doi.org/10.1007/s00170-021-06720-4
6 Perig, A. V., & Golodenko, N. N. (2016). CFD 2D description of local flow of polymer workpiece through a modified U-shaped die during equal channel multiple angular extrusion. Materials
Analysis of wall-smoothed mesh refinement in polymer melt transient flow
Research, 19(3), 602-610 https://doi.org/10.1590/1980-5373MR-2016-0013
7 Zhang, L., Zhao, G., Wang, G., Dong, G., & Wu, H. (2017). Investigation on bubble morphological evolution and plastic part surface quality of microcellular injection molding process based on a multiphase-solid coupled heat transfer model. International Journal of Heat and Mass Transfer, 104, 12461258 https://doi.org/10.1016/j.ijheatmasstransfer.2016.09.043
8 Miranda, D. A., & Nogueira, A. L. (2019). Simulation of an injection process using a CAE tool: assessment of operational conditions and mold design on the process efficiency. Materials Research, 22(2), e20180564 https://doi.org/10.1590/19805373-mr-2018-0564
9 Chen, S.-C., Chien, R.-D., Lin, S.-H., Lin, M.-C., & Chang, J.-A. (2009). Feasibility evaluation of gas-assisted heating for mold surface temperature control during injection molding process. International Communications in Heat and Mass Transfer, 36(8), 806-812 https://doi.org/10.1016/j. icheatmasstransfer.2009.06.007.
10 Guerrier, P., Tosello, G., & Hattel, J. H. (2017). Flow visualization and simulation of the filling process during injection molding. CIRP Journal of Manufacturing Science and Technology, 16, 12-20. https://doi.org/10.1016/j.cirpj.2016.08.002.
11 Herrera, F. Z. F., & Vieira, R. P. (2019). Numerical simulation of atom-transfer radical polymerization of tert-butyl methacrylate. Materials Research, 22(4), e20190333 https:// doi.org/10.1590/1980-5373-mr-2019-0333
12 Zhang, W., Myers, A., Gott, K., Almgren, A., & Bell, J. (2021). AMReX: block-structured adaptive mesh refinement for multiphysics applications. International Journal of High Performance Computing Applications, 35(6), 508-526 https:// doi.org/10.1177/10943420211022811
13 Sanjaya, Y., Prabowo, A. R., Imaduddin, F., & Nordin, N. A. B. (2021). Design and analysis of mesh size subjected to wheel rim convergence using finite element method. Procedia Structural Integrity, 33(1), 51-58 https://doi.org/10.1016/j. prostr.2021.10.008
14. Hétu, J.-F., Gao, D. M., Garcia-Rejon, A., & Salloum, G. (1998). 3D finite element method for the simulation of the filling stage in injection molding. Polymer Engineering and Science, 38(2), 223-236 https://doi.org/10.1002/pen.10183
15. Miranda, D. A., Rauber, W. K., Vaz, M., Jr., Alves, M. V. C., Lafratta, F. H., Nogueira, A. L., & Zdanski, P. S. (2023). Analysis of numerical modeling strategies to improve the accuracy of polymer injection molding simulations. Journal
of Non-Newtonian Fluid Mechanics, 315, 105033 https://doi. org/10.1016/j.jnnfm.2023.105033
16 Zdanski, P. S. B., & Vaz, M., Jr. (2006). Polymer melt flow in plane channels: effects of the viscous dissipation and axial heat conduction. Numerical Heat Transfer Part A, 49(2), 159-174 https://doi.org/10.1080/10407780500302059
17. Tutar, M., & Karakus, A. (2009). Injection molding simulation of a compressible polymer. Journal of Polymer Engineering, 29(6), 355-384 https://doi.org/10.1515/POLYENG.2009.29.6.355
18 Miranda, D. A., Rauber, W. K., Vaz, M., Jr., Nogueira, A. L., Bom, R. P., & Zdanski, P. S. B. (2023). Evaluation of the predictive capacity of viscosity models in polymer melt filling simulations. Journal of Materials Engineering and Performance, 32(4), 1707-1720 https://doi.org/10.1007/ s11665-022-07200-w
19 Issa, R. I. (1986). Solution of the implicitly discretised fluid flow equations by operatorsplitting. Journal of Computational Physics, 62(1), 40-65 https://doi.org/10.1016/0021-9991(86)90099-9
20 Mu, Y., Zhao, G., Chen, A., & Wu, X. (2013). Modeling and simulation of polymer melts flow in the extrusion process of plastic profile with metal insert. International Journal of Advanced Manufacturing Technology, 67(1-4), 629-646. https:// doi.org/10.1007/s00170-012-4511-7
21 Rasool, W. I., & Taha, Z. A. (2024). Modelling and numerical simulation during selective laser melting of stainless steel 316L via particle by particle approach. Materials Research, 27, e20230437 https://doi.org/10.1590/1980-5373-mr-2023-0437
22 Marin, F., Souza, A. F., Pabst, R. G., & Ahrens, C. H. (2019). Influences of the mesh in the CAE simulation for plastic injection molding. Polímeros: Ciência e Tecnologia, 29(3), e2019043 https://doi.org/10.1590/0104-1428.05019
23 Richardson, L. F. (1911). The approximate arithmetical solution by finite differences of physical problems involving differential equations with an application to the stresses in a masonary dam. Philosophical Transactions of the Royal Society of London. Series A, Containing Papers of a Mathematical or Physical Character, 210(459-470), 307-357. https://doi. org/10.1098/rsta.1911.0009
Received: Feb. 26, 2025
Revised: Sept. 03, 2025 Accepted: Sept. 16, 2025
Associate Editor: José A. C. G. Covas
Cuong Huynh Le Huy 1* , An Truong Thanh2 and Hao Nguyen Nhat3
1Faculty of Chemical Engineering, Ho Chi Minh City University of Industry and Trade – HUIT, Ho Chi Minh City, Vietnam
2Center for Experimental Practice, Ho Chi Minh City University of Industry and Trade – HUIT, Ho Chi Minh City, Vietnam
3Duy Tan Recycling, Ho Chi Minh City, Vietnam
*cuonghlh@huit.edu.vn
Obstract
Boric acid (BA) and nano silica (NS) were used to improve the properties of composite materials based on epoxy resin. The structural and thermal characteristics of materials were evaluated by using Scanning Electron Microscopy (SEM), Transmission Electron Microscopy (TEM), Thermogravimetric Analysis (TG), Derivative Thermogravimetry (dTG), and Differential Calorimetry (DSC). The mechanical properties of polymer films were evaluated through the parameters of impact strength, flexibility, adhesion, and hardness. The results showed that the content of 4.0 wt% BA increased the impact strength of the epoxy polymer film (increased by 38%) and increased the thermal properties of epoxy composite materials (increased by 14%). Combining 4.0 wt% BA and 1.0 wt% NS, the thermal properties of the epoxy composite polymer material increased by 18.5%. The epoxy coating was reinforced with 4.0 wt% BA and 1.0 wt% NS achived high thermal stability with the strongest decomposition temperature at 494 °C.
Keywords: boric acid, nano silica, thermal properties, mechanical properties, epoxy coatings.
Data Ovailability: Research data is available upon request from the corresponding author.
How to cite: Le Huy, C. H., Thanh, A. T., & Nhat, H. N. (2025). Properties of epoxy polymer materials reinforced with boric acid and nano silica. Polímeros: Ciência e Tecnologia, 35(4), e20250047. https://doi.org/10.1590/0104-1428.20250032
Epoxy resins have been widely used in coatings, composites, adhesives, and molding materials due to their excellent chemical resistance, strong adhesion, and anti-corrosion properties. However, owing to the presence of many aromatic rings in their chemical structure, epoxy resins are typically hard and brittle. Various approaches have been developed to enhance the mechanical and thermal properties of epoxy resins, including the incorporation of nanoparticles and thermally stable compounds. Heat-resistant and environmentally friendly additives, such as antimony oxides, borate compounds, and phosphorus-based compounds have been widely applied in polymer materials[1-7]. In study[1], zinc borate was incorporated into an ethylene-vinyl acetate (EVA) copolymer, showing its role as a smoke suppressant and combustion-rate reducer. In another study[2], the addition of 1.0 wt% zinc borate to polypropylene resulted in the formation of a protective char layer during combustion, thereby improving its flame retardancy.
Study[3] reported that a combination of aluminum powder and boric acid enhanced both the thermal stability and mechanical properties of epoxy polymer materials. Similarly, study[4] found that the incorporation of 5.0 wt% zinc borate and 1.0 wt% nano silica significantly improved
the mechanical properties and increased the thermal stability of epoxy composites by 4.7%. In study[5], polypropylene was reinforced with varying amounts of boric acid (1.25 wt%, 2.5 wt%, 3.75 wt%, and 5.0 wt%), in combination with 2.0 wt% montmorillonite (MMT) nano clay, ammonium polyphosphate (APP), and pentaerythritol (PER). The composition containing 2.5 wt% boric acid exhibited the most effective fire resistance performance.
To improve the thermal stability and flame retardancy of polymer materials, halogen-based and phosphorus-based flame retardants have been commonly used. However, the application of halogen-based compounds is increasingly restricted due to the release of toxic by-products during combustion[6-8]. In contrast, phosphorus-based flame retardants offer both high fire resistance and environmental friendliness[8-21]
Numerous studies have also explored the use of nanocomposite materials reinforced with silica and clay. These studies have shown that the incorporation of appropriate amounts of nano silica or nano clay can enhance the physical and mechanical properties of polymer materials, as well as improve other performance characteristics[21-29]
Despite the extensive literature on the reinforcement of polymer materials, no published studies to date have examined the combined effects of boric acid and nano silica on the properties of epoxy composite materials.
In this study, the effects of boric acid and nano silica on the mechanical properties and thermal resistance of polymer materials and coatings based on Epotec YD011X75 epoxy resin and G5022 hardener were investigated.
2.1 Materials
The epoxy resin used in this study was Epotec YD011X75 (Aditya Birla Chemicals, Thailand), with an epoxy equivalent weight (EEW) ranging from 460 to 490 g/eq. The corresponding hardener was a polyamide-based curing agent, G5022 (Korea). Nano silica was used in the form of fumed silica (S5505, Sigma-Aldrich). Xylene (China) was used as the solvent.
Boric acid was used as a flame-retardant additive, is a fine white powder with a density of 1.435 g/cm3 and a melting point of 170.9 °C. Additional materials included iron oxide (China), zinc phosphate (France), and talc filler powder (Talc 1250, Taiwan). BYK-110 (USA) was used as a wetting and dispersing additive, while Bentone SD1 (Belgium) was incorporated as a rheological modifier.
2.2 Preparation of samples
2.2.1 Dispersing boric acid (BA) into epoxy resin
A total of 100.0 g of Epotec YD011X75 epoxy resin was weighed into a 250 mL beaker, followed by the addition of 10.0 g of xylene as a solvent. The mixture was stirred at a speed of 500 rpm for 10 minutes to reduce the resin viscosity. Subsequently, 2.0 g of boric acid (BA) was added to the resin solution. The stirring speed was then increased to 2000 rpm and maintained for 60 minutes. The resulting resin mixture was subjected to ultrasonic treatment at a frequency of 50 kHz for 45 minutes. The BA content varied at 2.0 wt%, 4.0 wt%, and 6.0 wt% relative to the weight of the Epotec YD011X75 epoxy resin.
2.2.2 Disperse boric acid (BA) and nano silica into epoxy resin
A total of 100.0 g of epoxy resin and 1.0 g of nano silica were weighed into a 250 mL beaker. Subsequently, 10.0 g of xylene was added as a solvent. The mixture was stirred at 500 rpm for 15 minutes, then the stirring speed gradually increased to 2000 rpm and maintained for 60 minutes. Ultrasonic treatment was then applied at a frequency of 50 kHz for 45 minutes.
Following this, 4.0 g of boric acid (BA) was added to the mixture, which was stirred at 500 rpm for 10 minutes. The stirring speed was then gradually increased to 2000 rpm and maintained for an additional 60 minutes, followed by ultrasonic vibration at a frequency of 50 kHz for 30 minutes.
2.3 Devices and analysis methods for polymer composite materials
The dispersion process was carried out using mechanical stirrers (IKA RW-20, Germany) and an ultrasonic device (Vibram Cell, model CV334, USA). Surface morphology was
examined using a Scanning Electron Microscope (SEM, JEOL JSM-IT200, Japan). The thermal properties of the polymer composite materials were analyzed using Thermogravimetric Analysis and Differential Scanning Calorimetry (TG-DSCDTG) on a Setaram Labsys Evo system (TG-DSC 1600 °C).
The properties of epoxy paints and coatings were evaluated following the TCVN 9014:2011 standard[33] Mechanical properties of the coating films were assessed based on relevant ISO, ASTM, and JIS standards. Specifically, the flexibility of the films was tested according to ISO 1519:2002 using an Erichsen tester (model 266). Impact strength was evaluated following ISO 6272:2002 (Erichsen, model 304). Adhesion was measured following the ASTM D3359-93 standard (Erichsen, model 295). Pencil hardness was assessed according to the JIS K5400-90 standard. The dry film thickness was measured using a MiniTest 3100 device in compliance with TCVN 9406:2012.
3.1 Effects of boric acid on the mechanical properties of epoxy composite materials
The Epotec YD011X75 epoxy resin was cured using the G5022 curing agent at a mass ratio of 100:33 (wt/wt) (epoxy resin:curing agent), as reported in study[30]. The curing process occurs through a chemical reaction between the epoxy groups of the resin and the amine groups of the curing agent, resulting in a crosslinked thermosetting network.
The curing degree was evaluated by determining the gel content, following the method described in study[30]. In this method[30], 100 parts by mass of Epotec YD011X75 epoxy resin were mixed with 33 parts by mass of G5022 curing agent. The gel content is the insoluble fraction of the cured material after extraction with acetone solvent and shows the extent of crosslinking. The gel content determination was performed in a manner consistent with that described in study[29]
After curing, the samples were stabilized at room temperature for 72 hours prior to characterization.
Boric acid (BA) was incorporated into the epoxy resin at a concentration of 2.0 wt% (as described in Section 2.2) using mechanical stirring followed by ultrasonic dispersion. The effectiveness of BA dispersion within the epoxy matrix was evaluated through Scanning Electron Microscopy (SEM). The SEM micrograph of the Epotec YD011X75/G5022/2.0 wt% BA epoxy composite is presented in Figure 1
The SEM image in Figure 1 shows that boric acid (BA) was uniformly dispersed within the Epotec YD011X75/ G5022 epoxy polymer matrix.
The effects of varying BA content on the mechanical properties of the Epotec YD011X75/G5022 epoxy coating film were evaluated through measurements of impact strength, adhesion, pencil hardness, and flexibility. The corresponding results are summarized in Table 1
According to ISO 1519:2002 (Erichsen, model 266), the flexibility of polymer coating films is determined by bending the films over cylindrical metal shafts with diameters ranging from 2 mm to 20 mm. The flexibility is expressed as the smallest shaft diameter over which the coating film can be bent without sustaining visible damage.

The impact strength of the coating films was evaluated following ISO 6272:2002 (Erichsen, model 304), which measures the resistance of the film to mechanical impact. The value is reported in kg.cm, representing the maximum height (in centimeters) from which a 1.0 kg weight can freely fall onto the coated specimen without causing damage. For example, an impact strength of 45 kg.cm indicates that the coating can withstand the free fall of a 1.0 kg mass from a height of 45 cm without failure.
Adhesion was assessed according to ASTM D3359-93 (Erichsen, model 295) by making a grid of 1 mm × 1 mm cut on the coating surface, applying adhesive tape, and then evaluating the percentage of coating removed upon tape detachment.
Pencil hardness was measured following JIS K5400-90, which determines the hardest pencil capable of scratching the surface of the film, thereby indicating its surface hardness.
Dry film thickness was measured according to ASTM D1005 or TCVN 9406:2012 (MiniTest 3100) using an electronic thickness gauge with a magnetic induction probe, suitable for magnetic metal substrates such as iron and steel. Prior to measurement, the instrument was calibrated using a standard reference film. The probe was gently pressed against the surface until the reading stabilized (approximately 2-3 seconds).
The results summarized in Table 1 show that the unmodified Epotec YD011X75/G5022 epoxy coating film (sample BA0) exhibited excellent adhesion (5B), high pencil hardness (6H), and acceptable flexibility (bending diameter
of 4 mm). However, its impact strength was relatively low at 32.5 kg.cm. This is attributed to the inherent brittleness of epoxy resins, which, due to their highly crosslinked structure and high aromatic content, possess limited flexibility[26-30]
To enhance the mechanical performance, boric acid (BA) was introduced as a reinforcing filler. Its effect on the mechanical properties was clearly observed. The sample containing 4.0 wt% BA (BA4) showed a significant increase in impact strength, rising from 32.5 kg.cm to 45 kg.cm (an improvement of 38%). This enhancement is attributed to the ability of BA to act as a reinforcing agent, contributing to the formation of additional physical interactions between the epoxy matrix and the curing agent[29,30]. The presence of an optimal BA content improved the interfacial bonding and dispersion, thereby enhancing the mechanical strength (as seen in BA2 and BA4 samples). However, when the BA content was increased to 6.0 wt% (BA6), the mechanical performance deteriorated. This reduction is likely due to the excess BA disrupting the network structure of the epoxy resin, resulting in regions lacking sufficient resin to form effective bonds, which led to decreased cohesion and poorer mechanical integrity.
Based on the results in Table 1, the optimal boric acid content was determined to be 4.0 wt% (BA4), which significantly enhanced the mechanical properties of the Epotec YD011X75/G5022 epoxy coating. Therefore, the BA4 sample was selected for further investigation into the thermal properties of the epoxy composite and was compared to the
sample (BA0).
3.2 Effects of boric acid on the thermal properties of the Epotec YD011X75/G5022 epoxy material
3.2.1 Thermal properties of the Epotec YD011X75/G5022 epoxy material
The thermal properties of the Epotec YD011X75/G5022 epoxy material were evaluated using thermogravimetric and derivative thermogravimetric (TG-dTG) analysis. Thermogravimetric analysis (TG, %) measures the change in sample mass as a function of increasing temperature, thereby indicating the material’s thermal stability and decomposition behavior. Derivative thermogravimetry (dTG, %/min) quantifies the rate of mass loss over time, allowing for more precise identification of decomposition stages.
The results of the TG-dTG analysis are presented in Figure 2
The results presented in Figure 2 indicate that the BA0 sample (epoxy composite without boric acid) began to decompose at approximately 100 °C, corresponding to the evaporation of residual solvent. The onset of significant thermal degradation, defined by a 5.0 wt% mass loss, occurred within the temperature range of 180-210 °C. The temperature at which the sample reached 50 wt% mass loss was 341 °C. The maximum rate of decomposition, recorded at 9.11 %/min, occurred at 377 °C.
The thermal resistance of epoxy resins originates from their crosslinked thermosetting structure, which is formed through the reaction between epoxy groups and amine groups in the curing agent. The high aromatic ring content in the epoxy backbone contributes significantly to the material’s thermal stability[4,26-29]
In comparison, a previous study[4] reported that epoxy composite materials based on DER 671X75 resin and T31 curing agent began to decompose between 150 °C and 158 °C due to solvent evaporation, and showed a maximum decomposition temperature of 339.96 °C. This comparison highlights the superior thermal stability of the Epotec YD011X75/G5022 epoxy system used in this study.
Thermal properties are a critical parameter reflecting the thermal stability and degradation behavior of thermosetting polymers, which is of great significance for applications in high-temperature and extreme environments. Thermoset epoxy resins are characterized by a chemically cross-linked network structure, along with a high content of aromatic rings, both of which contribute to their excellent thermal stability.
The results obtained from TG and dTG analyses in this study are in good agreement with those reported in the literature, including study[4] and previous works[26-29], thereby confirming the reliability of the thermal behavior observed for the Epotec YD011X75/G5022 epoxy system.
of the Epotec YD011X75/G5022/4.0 wt% BA epoxy material
The incorporation of 4.0 wt% boric acid (BA) was found to enhance the mechanical properties of the Epotec YD011X75/G5022 epoxy coating film, as previously demonstrated in Table 1. To further evaluate its thermal behavior, TG-dTG analysis was performed on the BA4 sample (Epotec YD011X75/G5022/4.0 wt% BA epoxy polymer), and the results are presented in Figure 3
Chemical structure of acid boric was shown in Figure 4.
As shown in Figure 3, the BA4 sample began to decompose at approximately 100 °C, corresponding to the evaporation of residual solvent. The onset of 5.0 wt% mass loss occurred at 142 °C. Additionally, the decomposition of boric acid was observed to begin at approximately 170 °C, a temperature at which boric acid (H3BO3) undergoes dehydration to form metaboric acid (HBO2)[31,32]
The dTG curve revealed that the peak decomposition rate occurred at 430 °C, with a maximum mass loss rate of 10.2%/min. This shows an enhancement in thermal resistance compared to the unmodified epoxy system (BA0), suggesting that the incorporation of BA contributes to improved thermal stability, likely due to its flame-retardant and reinforcing characteristics.

Properties of epoxy polymer materials reinforced with boric acid and nano silica

The thermal stability of boric acid can be attributed to its flame-retardant mechanism, which primarily acts in the gas phase[31,32]. When the temperature reaches approximately at 170 °C, boric acid (H3BO3) undergoes thermal decomposition to form metaboric acid (HBO2) and water, according to the following reaction:
3322 HBOHBOHO →+ (1)
The released water plays a critical role in suppressing combustion by diluting flammable gases and reducing the temperature in the combustion zone. As the temperature continues to rise above 300 °C, metaboric acid further decomposes to form tetraboric acid (also known as pyroboric acid, H2B4O7), while releasing more water:
22472 4 HBOHBOHO →+ (2)
At even higher temperatures, H2B4O7 decomposes into boron trioxide (B2O3) and water:
247232 2 HBOBOHO →+ (3)
Boron trioxide is a thermally stable, non-flammable compound that can form a glass layer on the material surface, effectively acting as a barrier to heat and oxygen. Additionally, the release of water and the reduction of available oxygen at the combustion interface contribute to the inhibition of flame propagation[31 32]
As a result of this flame-retardant mechanism, the incorporation of 4.0 wt% boric acid (BA) significantly enhanced the thermal stability of the Epotec YD011X75/ G5022 epoxy composite. The maximum decomposition temperature increased from 377 °C for the unmodified sample (BA0) to 430 °C for the BA4 sample, representing an improvement of approximately 14%.

3.3 Effects of nano silica on the mechanical and thermal properties of the Epotec YD011X75/G5022 epoxy material
Nano silica was incorporated into the Epotec YD011X75 epoxy resin using a combination of mechanical stirring and ultrasonic dispersion. Specifically, the mixture was initially stirred at 500 rpm for 15 minutes, followed by an increase in stirring speed to 2000 rpm for 60 minutes. The dispersion process was then enhanced by ultrasonic treatment for 45 minutes at a frequency of 50 kHz. This method was adapted from several previously published studies[4,26,28,29]
The dispersion quality of nano silica within the epoxy matrix was confirmed by transmission electron microscopy (TEM). The TEM image showing the distribution of 1.5 wt% nano silica in the Epotec YD011X75 epoxy resin is presented in Figure 5.
The TEM image in Figure 5 shows that nano silica particles were well dispersed within the Epotec YD011X75 epoxy resin matrix at the nanoscale, forming a uniform nanocomposite structure. The combination of mechanical stirring and ultrasonic vibration proved to be highly effective for dispersing nano silica into the epoxy resin. These findings are consistent with those reported in previous studies[4,26-30]

Following ultrasonic dispersion, the samples were stored under stable conditions for at least 72 hours before TEM imaging. The image confirms the absence of aggregation, showing that the nano silica particles remained uniformly distributed within the epoxy matrix.
The incorporation of silica nanoparticles significantly influenced the properties of the epoxy composite materials. Maintaining the nanoscale dispersion of silica was essential to achieving the desired enhancements in mechanical performance, which is a key feature of epoxy-based nanocomposites[4,26-30]. The epoxy resin acts as the continuous phase (matrix), effectively encapsulated and bonding with the dispersed nano silica particles, thereby improving the overall mechanical and physical properties of the resulting nanocomposite.
In this study, nano silica was added at various concentrations of 0.5 wt%, 1.0 wt%, 1.5 wt%, and 2.0 wt%, corresponding to the sample codes BA0_Si0.5, BA0_Si1.0, BA0_Si1.5, and BA0_Si2.0, respectively.
The mechanical properties of the Epotec YD011X75/ G5022/nano silica epoxy nanocomposite coating films are summarized in Table 2
The results of the mechanical property evaluation presented in Table 2 indicate that the incorporation of nano silica significantly enhanced the performance of the epoxy films. The nano silica-reinforced samples (BA0_Si0.5,
BA0_Si1.0, BA0_Si1.5, and BA0_Si2.0) exhibited improved mechanical properties compared to the unreinforced BA0 sample. Among these, the BA0_Si1.0 sample, containing 1.0 wt% nano silica, demonstrated the most superior mechanical performance. Specifically, its impact strength increased from 32.5 kg.cm to 50 kg.cm, representing a 54% enhancement.
Moreover, the incorporation of 1.0 wt% nano silica also improved the flexibility of the Epotec YD011X75/ G5022 epoxy film. These findings are in strong agreement with previous studies[4,26-30], which have reported similar reinforcing effects of nano silica in polymer matrices. Nano silica acts as a reinforcing filler by dispersing within the epoxy matrix and mitigating stress concentrations under load.
However, when the nano silica content was increased to 1.5 wt% and 2.0 wt%, a decline in mechanical performance was observed. This deterioration is attributed to the insufficient amount of epoxy resin to effectively encapsulate the increased quantity of silica nanoparticles. Furthermore, the high surface activity associated with the Si–O bonds promote the agglomeration of adjacent nanoparticles, leading to the formation of larger silica clusters. These agglomerated regions, which lack sufficient resin to ensure proper dispersion and bonding, result in localized stress points and. So, a reduction in impact strength[4,26-30]
Properties of epoxy polymer materials reinforced with boric acid and nano silica
3.4 Effects of boric acid and nano silica on the mechanical and thermal properties of the Epotec YD011X75/G5022/BA/ nano silica epoxy composite material
The results from previous sections demonstrated that both boric acid (BA) and nano silica individually enhanced the mechanical and thermal properties of the Epotec YD011X75/G5022 epoxy system. When used in combination, boric acid and nano silica exhibited a synergistic effect, further improving the overall performance of the composite material.
To evaluate this combined effect, a composite formulation reinforced with 4.0 wt% boric acid and 1.0 wt% nano silica was prepared. The mechanical properties of the resulting epoxy coating film were determined and are summarized in Table 3
The results presented in Table 3 indicate that the BA4_Si1.0 sample exhibited the most enhanced mechanical performance among all tested formulations. Specifically, the Epotec YD011X75/G5022 epoxy film reinforced with 4.0 wt% boric acid and 1.0 wt% nano silica achieved an impact strength of 52.5 kg.cm, a flexibility value of 2 mm, a pencil hardness of 4H, and adhesion rated at 5B.
All measured mechanical properties of the BA4_Si1.0 epoxy coating film meet or exceed the requirements specified in TCVN 9014:2011 for protective coatings. Notably, these values are higher than those observed for the BA0_Si1.0 and
BA0 formulations, confirming the synergistic reinforcing effect of combining boric acid and nano silica.
Boric acid and nano silica individually act as effective reinforcing fillers and, when dispersed uniformly and properly bonded within the epoxy matrix, they contribute to significant improvements in mechanical strength and integrity. In the BA4_Si1.0 formulation, the appropriate ratio between the epoxy resin, boric acid, and nano silica facilitated the formation of a well-integrated network structure, enhancing the filler-matrix interaction. This optimized microstructure played a critical role in improving the overall mechanical properties of the epoxy coating film[4 26-30]
3.4.1 Thermal properties of the Epotec YD011X75/G5022/4.0 wt% BA/1.0 wt% nano silica epoxy polymer material
The thermal behavior of the Epotec YD011X75/G5022 epoxy polymer reinforced with 4.0 wt% boric acid and 1.0 wt% nano silica (BA4_Si1.0 sample) was evaluated through thermogravimetric analysis. The TG-dTG results are presented in Figure 6
The results presented in Figure 6 show that the BA4_Si1.0 sample began to decompose at approximately 100 °C, which corresponds to the evaporation of residual solvent. The dTG curve revealed a decomposition stage occurring in the 140-180 °C range, consistent with the thermal decomposition of boric acid observed previously in Figure 3

Table 4. The thermal properties of the Epotec YD011X75/G5022 epoxy polymer composite.
The maximum decomposition rate was observed at 447 °C, with a peak mass loss rate of 10.1%/min, indicating an improvement in thermal stability compared to the BA0 and BA4 samples.
A summary of the thermal analysis results for all epoxy material samples is provided in Table 4
The results presented in Table 4 indicate that the thermal stability of the Epotec YD011X75/G5022 epoxy materials progressively increased with the incorporation of 4.0 wt% boric acid (BA) and 1.0 wt% nano silica. Specifically, the temperature corresponding to the maximum decomposition rate increased from 377 °C for the unmodified epoxy (BA0 sample), to 430 °C for the BA4 sample (an improvement of 14%), and further to 447 °C for the BA4_Si1.0 sample (an improvement of 18.5%).
The improvement in thermal resistance due to nano silica can be attributed to its barrier and insulation mechanism. Nano silica forms a protective layer on the surface of the material, which hinders the diffusion of oxygen needed for combustion. Additionally, it keeps heat within the structure and restricts the release of volatile compounds during pyrolysis, thereby enhancing thermal stability[4,26-30]
Meanwhile, the flame-retardant effect of boric acid primarily occurs in the gas phase, as explained by its stepwise decomposition reactions. These include the release of water vapor and the formation of thermally stable boron oxides, which inhibit combustion through heat absorption and oxygen dilution[31 32]
The combination of 4.0 wt% boric acid and 1.0 wt% nano silica showed a synergistic effect, significantly improving the thermal stability of the Epotec YD011X75/ G5022 epoxy polymer composite by 18.5%, compared to the unmodified system.
3.5 Mechanical and thermal properties of the Epotec YD011X75/G5022/4.0 wt% BA/1.0 wt% nano silica epoxy paint
The epoxy paint formulation was prepared using the grinding method. The composition of the Epotec YD011X75/ G5022/4.0 wt% BA/1.0 wt% nano silica epoxy paint (denoted as the PBA4_Si sample) is detailed in Table 5.
The resin phase consisted of the Epotec YD011X75 epoxy resin, boric acid (BA), nano silica, talc powder (Talc 1250), iron oxide, zinc phosphate, xylene solvent, dispersing and wetting additives (BYK 110), and rheological additives (Bentone SD1). The curing agent used in the formulation was G5022, a polyamide-based hardener.
The PBA4_Si epoxy paint shows excellent corrosion resistance and thermal stability. To achieve these properties,
Table 5. The composition of the PBA4_Si epoxy paint. Ingredient Content
Epotec YD 011X75 epoxy resin 100
Boric acid (BA) 4
Nano silica (S5505) 1
Talc powder (Talc 1250) 20
G5022 33
the paint formulation incorporates a variety of functional components aimed at enhancing both corrosion protection and heat resistance.
The epoxy resin (Epotec YD011X75), which forms the base of the system, has inherent chemical resistance and strong adhesion to substrates, contributing significantly to the paint’s protective capabilities. Additionally, iron oxide and zinc phosphate pigments are included to improve corrosion resistance by forming a passive barrier and inhibiting rust formation. Talc fillers (Talc 1250) provide enhanced shielding and contribute to the mechanical integrity and protective barrier of the coating. Crucially, boric acid (BA) and nano silica are incorporated as multifunctional additives. These components not only reinforce the physical and mechanical properties of the epoxy coating but also play a critical role in improving thermal resistance and flame retardancy.
Other supporting components include rheological additives such as Bentone SD1, which control viscosity and thixotropy during production and application, and wetting and dispersing agents (BYK 110), which ensure uniform pigment distribution and prevent sedimentation during storage. The xylene solvent serves as a viscosity modifier, facilitating optimal application performance[26-30]
The mechanical properties of the epoxy coating and the surface of the coating are presented in Table 6 and Figure 7.
The results presented in Table 6 and Figure 7 indicate that the epoxy paint film satisfies the required performance criteria outlined in the Vietnamese national standard TCVN 9014:2011 for epoxy coatings[33].
3.5.1 Thermal properties of the PBA4_Si epoxy coating film
The thermal behavior of the PBA4_Si epoxy coating film was evaluated using TG-DSC thermal analysis, and the results are presented in Figure 8
Properties of epoxy polymer materials reinforced with boric acid and nano silica


As shown in Figure 8, the DSC curve displays distinct endothermic peaks characteristic of the material’s thermal decomposition. The decomposition of the PBA4_Si sample began at approximately 100 °C, corresponding to the evaporation of residual solvent. A notable endothermic peak was observed at 137 °C, extending to 180 °C, which aligns with the thermal decomposition of boric acid, as previously seen in Figure 3 and Figure 4
The maximum decomposition temperature was recorded at 494 °C, showing a significant improvement in thermal stability. This enhancement can be attributed to the presence of 4.0 wt% boric acid and 1.0 wt% nano silica, which reinforce the epoxy matrix and contribute to improved resistance to thermal degradation. In addition to the functional fillers and pigments, these additives play a key role in enhancing the heat resistance of the epoxy paint system.
The effects of boric acid and nano silica reinforcement on the Epotec YD011X75/G5022 epoxy polymer composite were evaluated through the analysis of both mechanical and thermal properties. The incorporation of 4.0 wt% boric acid resulted in a 32% improvement in impact strength and a 14% increase in thermal resistance. When the composite was reinforced with 4.0 wt% boric acid and 1.0 wt% nano silica, the thermal stability was further enhanced, reaching an 18.5% increase compared to the unmodified epoxy system. Furthermore, the epoxy paint formulated from Epotec YD011X75/G5022 resin, reinforced with 4.0 wt% boric acid and 1.0 wt% nano silica, satisfied all mechanical property requirements for protective coatings and exhibited a strongest decomposition temperature of 494 °C, indicating high thermal stability and suitability for use in harsh or high-temperature environments.
5. Author’s Contribution
• Conceptualization – Cuong Huynh Le Huy; Hao Nguyen Nhat; An Truong Thanh
• Data curation – Cuong Huynh Le Huy; Hao Nguyen Nhat; An Truong Thanh
• Formal analysis – Cuong Huynh Le Huy
• Funding acquisition – NA.
• Investigation – NA.
• Methodology – Cuong Huynh Le Huy; Hao Nguyen Nhat; An Truong Thanh
• Project administration – Cuong Huynh Le Huy
• Resources – Cuong Huynh Le Huy; Hao Nguyen Nhat; An Truong Thanh
• Software – NA.
• Supervision – Cuong Huynh Le Huy
• Validation – Cuong Huynh Le Huy
• Visualization – Cuong Huynh Le Huy
• Writing – original draft – Cuong Huynh Le Huy
• Writing – review & editing – Cuong Huynh Le Huy
Acknowledgements
This work was supported by Ho Chi Minh City University of Industry and Trade (HUIT).
References
1 Ramadhoni, B., Ujianto, O., & Nadapdap, M. (2017). Rigid polyurethane nanocomposites prepared by direct incorporation: effects of nanoclay, carbon nanotubes and mixing speed on physical and morphological properties. Progress in Polymer Science, 319, 012041 https://doi.org/10.1088/1757-899X/319/1/012041
2 Shen, K. K., & O’Connor, R. (1998). Flame retardants: borates. In G. Pritchard (Ed.), Plastics additives: an A-Z reference (pp. 268-276). Dordrecht: Springer https://doi. org/10.1007/978-94-011-5862-6_30
3. Kiliaris, P., & Papaspyrides, C. D. (2010). Polymer/layered silicate (clay) nanocomposites: an overview of flame retardancy. Progress in Polymer Science, 35(7), 902-958 https://doi. org/10.1016/j.progpolymsci.2010.03.001
4 Cuong, H. L. H., & Thanh, A. T. (2022). Characteristics of mechanical properties and thermal behavior of epoxy nanocomposites and coatings by zinc borate, nano silica, and hardener. ACS Omega, 7(43), 38299-38310 https://doi. org/10.1021/acsomega.2c02462 PMid:36340107.
5. Demirhan, Y., Yurtseven, R., & Usta, N. (2021). The effect of boric acid on flame retardancy of intumescent flame-retardant polypropylene composites including nano clay. Journal of Thermoplastic Composite Materials, 36(3), 1187-1214 https://doi.org/10.1177/08927057211052327.
6 Hoang, D., Kim, J., & Jang, B. N. (2008). Synthesis and performance of cyclic phosphorus-containing flame retardants. Polymer Degradation & Stability, 93 (11 ), 2042 -2047 https://doi.org/10.1016/j.polymdegradstab.2008.02.017
7 Levchik, S., Bocchini, S., & Camino, G. (2010). Halogencontaining flame retardants. In C. A. Wilkie, & A. B. Morgan (Eds.), Fire retardancy of polymeric materials (pp. 58-80). Boca Raton: CRC Press https://doi.org/10.1201/9781003380689-4
8 van der Veen, I., & de Boer, J. (2012). Phosphorus flame retardants: properties, production, environmental occurrence, toxicity and analysis. Chemosphere , 88 (10), 1119-1153 https://doi.org/10.1016/j.chemosphere.2012.03.067 PMid:22537891.
9. Hörold, S. (1999). Phosphorus flame retardants in thermoset resins. Polymer Degradation & Stability, 64(3), 427-431 https://doi.org/10.1016/S0141-3910(98)00163-3
10 Camino, G., Costa, L., & di Cortemiglia, M. P. L. (1991). Overview of fire retardant mechanisms. Polymer Degradation & Stability, 33(2), 131-154 https://doi.org/10.1016/01413910(91)90014-I
11. Wu, Q., Lü, J., & Qu, B. (2003). Preparation and characterization of micro capsulated red phosphorus and its flame-retardant mechanism in halogen-free flame retardant polyolefins. Polymer International, 52(8), 1326-1331 https://doi.org/10.1002/ pi.1115.
12 Liu , Y. , & Wang , Q. ( 2006 ). Melamine cyanuratemicroencapsulated red phosphorus flame retardant unreinforced and glass fiber reinforced polyamide 66. Polymer Degradation & Stability, 91(12), 3103-3109 https://doi.org/10.1016/j. polymdegradstab.2006.07.026
13 Qiu, S., Ma, C., Wang, X., Zhou, X., Feng, X., Yuen, K. K. R., & Hu, Y. (2018). Melamine-containing polyphosphazene wrapped ammonium polyphosphate: A novel multifunctional organic-inorganic hybrid flame retardant. Journal of Hazardous Materials, 344, 839-848 https://doi.org/10.1016/j. jhazmat.2017.11.018. PMid:29190581.
14 Xi , W. , Qian , L. , Huang , Z. , Cao , Y. , & Li , L. (2016 ). Continuous flame retardant actions of two phosphate esters with expandable graphite in rigid polyurethane foams. Polymer Degradation & Stability, 130, 97-102 https://doi.org/10.1016/j. polymdegradstab.2016.06.003
15 Rao, W.-H., Xu, H.-X., Xu, Y.-J., Qi, M., Liao, W., Xu, S., & Wang, Y.-Z. (2018). Persistently flame retardant flexible polyurethane foams by a novel phosphorus-containing polyol. Chemical Engineering Journal, 343, 198-206 https://doi. org/10.1016/j.cej.2018.03.013
16 Jin, S., Qian, L., Qiu, Y., Chen, Y., & Xin, F. (2019). Highefficiency flame retardant behavior of bi-DOPO compound with hydroxyl group on epoxy resin. Polymer Degradation & Stability , 166 , 344 - 352 https://doi.org/10.1016/j. polymdegradstab.2019.06.024
17 Xie, C., Du, J., Dong, Z., Sun, S., Zhao, L., & Dai, L. (2016). Improving thermal and flame-retardant properties of epoxy resins by a new imine linkage phosphorous-containing curing agent. Polymer Engineering and Science, 56(4), 441-447 https://doi.org/10.1002/pen.24270
Properties of epoxy polymer materials reinforced with boric acid and nano silica
18 Zhu, Z.-M., Wang, L.-X., & Dong, L.-P. (2019). Influence of a novel P/N-containing oligomer on flame retardancy and thermal degradation of intumescent flame-retardant epoxy resin. Polymer Degradation & Stability, 162, 129-137 https://doi.org/10.1016/j.polymdegradstab.2019.02.021.
19 Levchik, S. V., & Weil, E. D. (2006). A review of recent progress in phosphorus-based flame retardants. Journal of Fire Sciences, 24(5), 345-364 https://doi.org/10.1177/0734904106068426
20 Carja, I.-D., Serbezeanu, D., Vlad-Bubulac, T., Hamciuc, C., Coroaba, A., Lisa, G., López, C. G., Soriano, M. F., Pérez, V. F., & Romero Sánchez, M. D. (2014). A straightforward, eco-friendly and cost-effective approach towards flame retardant epoxy resins. Journal of Materials Chemistry. A, Materials for Energy and Sustainability, 2(38), 16230-16241 https://doi.org/10.1039/C4TA03197K
21 Mir, M. A. N., Mohammad, R. K., Amir, B., & Moslem, H. (2012). Nanosilica reinforced epoxy floor coating composites: preparation and thermophysical characterization. Current Chemistry Letters, 1(1), 13-20. Retrieved in 2025, May 12, from https://www. growingscience.com/ccl/Vol1/ccl_2012_2.pdf
22. Chozhan, C. K., Chandramohan, A., & Alagar, M. (2018). Surface modified clay reinforced silicon incorporated epoxy hybrid nanocomposites: thermal, mechanical and morphological properties. Sage Journals , 9 ( 1 ), 1 - 22 https://doi.org/10.1177/204124791800900101
23. Pellegrin, P., Nguyen, T., Mermet, L., Shapiro, A., Gu, X., & Chin, J. (2009). Degradation and nanoparticle release of epoxy/ silica composites exposed to UV radiation (Vol. 1, pp. 90-93). Punjab: Nano Science and Technology Institute. Retrieved in 2025, May 12, from https://tsapps.nist.gov/publication/get_pdf. cfm?pub_id=902990
24 Woldemariam, M. H., Belingardi, G., Koricho, E. G., & Reda, D. T. (2019). Effects of nanomaterials and particles on mechanical properties and fracture toughness of composite materials: a short review. AIMS Materials Science, 6(6), 1191-1212 https://doi.org/10.3934/matersci.2019.6.1191
25. Liu, X., Dang, L., Nai, X., Dong, Y., & Li, W. (2018). Design and preparation of high-aspect-ratio zinc borate whiskers and their effects on mechanical properties of PP nanocomposite. Research on Chemical Intermediates, 44(10), 5697-5709 https://doi.org/10.1007/s11164-018-3450-9
26 Cuong, H. L. H., Dieu, T. V., Thanh, N. D., & Oanh, D. T. Y. (2017). Study the effects of nanosilica on mechanical properties of polymer coating film based on epoxy resin DER 671X75. Vietnam Journal of Chemistry, 55(1), 12
27 Nguyen, T. A., Nguyen, T. H., Nguyen, T. V., Thai, H., & Shi, X. (2016). Effect of nanoparticles on the thermal and mechanical properties of epoxy coatings. Journal of Nanoscience and Nanotechnology, 16(9), 9874-9881 https://doi.org/10.1166/ jnn.2016.12162
28 Gu, H., Guo, J., He, Q., Tadakamalla, S., Zhang, X., Yan, X., Huang, Y., Colorado, H. A., Wei, S., & Guo, Z. (2013). Flame-retardant epoxy resin nanocomposites reinforced with polyaniline-stabilized silica nanoparticles. Industrial & Engineering Chemistry Research, 52(23), 7718-7728 https:// doi.org/10.1021/ie400275n
29. Cuong, H. L. H., Thanh, A. T., & Bao, L. H. (2021). Effects of triphenyl phosphate (TPP) and nanosilica on the mechanical properties, thermal degradation of polymer nanocomposite materials, and coating based on epoxy resin. Materials Research Express, 8(9), 095301 https://doi.org/10.1088/2053-1591/ac2098
30 Cuong, H. L. H., & Thanh, A. T. (2023). Study on fabricating epoxy coatings reinforced with iron oxide flakes and nano silica. Journal of Reinforced Plastics and Composites, 42 (13-14), 724-740 https://doi.org/10.1177/07316844231162562
31 Dogan, M., Dogan, S. D., Atabek Savas, L., Ozcelik, G., & Tayfun, U. (2021). Flame retardant effect of boron compounds in polymeic materials. Composites. Part B, Engineering, 222, 109088 https://doi.org/10.1016/j.compositesb.2021.109088
32 Bourbigot, S., Le Bras, M., Leeuwendal, R., Shen, K. K., & Schubert, D. (1999). Recent advances in the use of zinc borates in flame retardancy of EVA. Polymer Degradation & Stability, 64(3), 419-425 https://doi.org/10.1016/S0141-3910(98)00130-X
33. Vietnamese National Standard. (2011). Epoxy paint standard (TCVN 9014:2011). Vietnam
Received: May 12, 2025
Revised: July 18, 2025
Accepted: Sept. 24, 2025
Editor-in-Chief: Sebastião V. Canevarolo
Bruno Mello de Freitas1,2* , Carlos do Amaral Razzino3 and Paulo Noronha Lisboa Filho2
1Departamento de Engenharia de Materiais, Laboratório de Materiais – LabMat, Universidade do Estado do Amazonas – UEA, Manaus, AM, Brasil
2Departamento de Física e Meteorologia, Faculdade de Ciências, Universidade Estadual Paulista –UNESP, Bauru, SP, Brasil
3Departamento de Engenharia de Produção, Faculdade de Engenharia, Universidade Estadual Paulista –UNESP, Bauru, SP, Brasil
*bm.freitas@unesp.br
Obstract
This study developed PBAT (poly[butylene adipate-co-terephthalate]) biocomposites with 10 wt% and 20 wt% Brazil nut urchin particles by extrusion and injection. TGA showed thermal stability up to 275°C (10 wt%) and 250°C (20 wt%), with degradation peaks near 400°C. XRD indicated maintained crystallinity, with the 10 wt% composite having the highest peak intensity (5254 a.u.). FTIR confirmed molecular interactions through characteristic OH (3442 cm−1) and C=O (1710-1720 cm−1) peaks. SEM revealed better surface integrity at 10 wt%, while 20 wt% showed porosity and poor adhesion. Tensile strength decreased from 9.36 MPa (PBAT) to 7.08 MPa (10 wt%) and 6.7 MPa (20 wt%). Elongation reduced, whereas Young’s modulus increased to 210 MPa (10 wt%) and 316 MPa (20 wt%). Shore D hardness improved by over 40%, but impact resistance dropped by up to 88%. These biocomposites show potential for applications requiring higher stiffness and hardness, contributing to sustainable plastic alternatives.
Keywords: composite materials, forest residues, biopolymers, PBAT, Brazil nut urchin.
Data Ovailability: Research data is available upon request from the corresponding author.
How to cite: Freitas, B. M., Razzino, C. A., & Lisboa Filho, P. N. (2025). Characterization of PBAT bioplastic with Brazil nut urchin particles. Polímeros: Ciência e Tecnologia, 35(4), e20250048. https://doi.org/10.1590/0104-1428.20250013
As production processes improve, waste reduction methods are also advancing, focusing on better resource use, recycling, energy efficiency, and lowering environmental impact[1]. In recent years, polymer materials have progressed significantly due to concerns about environmental damage from the exacerbated consumption of oil reserves[2,3]. While petroleum-based plastics are widely used in packaging and construction[4 5], they pose serious environmental challenges because of the non-degradable waste they produce[6].
Plastics play an important role in sustainability by being lightweight, improving fuel efficiency in vehicles, and extending food shelf life to reduce waste. However, environmental concerns about plastic waste and greenhouse gas emissions are accelerating the shift towards a circular plastics economy. In this model, the use of non-renewable resources and waste generation is minimized, with focus on reuse and recycling throughout the material life cycle[7]
Most commercial plastics are made from fossil resources, but they can also be produced from renewable sources, known as bioplastics[7]. Bioplastics are defined as plastics that are biobased, biodegradable, produced through biological processes, or a combination of these. Some biodegradable plastics made from fossil fuels are also considered bioplastics[8]
PBAT (Poly [Butylene Adipate Co-Terephthalate]) is a widely used and promising biodegradable polymer that can replace non-biodegradable plastics[9]. It consists of terephthalic acid, adipic acid, and 1,4-butanediol, with biodegradability attributed to the butylene adipate group[10] and can replace polyethylene (PE), which is not biodegradable. PBAT has similar flexibility to PET and is suitable for industrial applications thanks to its high elongation and good processability[11]. Similarly, increasing terephthalate content or molecular weight boosts stiffness and tensile strength but reduces elongation[9]. However, the use of PBAT remains commercially limited, although it could be enhanced by adding Brazil nut urchin residue.
The Brazil nut urchin (Berthollethia excelsa H&B Lecythidaceae) is a lignocellulosic organic agricultural waste and also a source of carbon, especially for the production of “green” composite materials. The accumulation of this waste leads to an increase in environmental pollution, and the accidental deposition of this waste in landfills can affect the permeability of rainwater in the soil. However, although material waste is inevitable, agro-industrial waste in the form of fibers, husks, shells, powders, particles, etc., can be recycled and reused in innovative ways in various sectors[12]
B. M., Razzino, C. A., & Lisboa Filho, P. N.
Thus, these materials form cheap “new or secondary resources”, which make them more valuable and more widely usable.
Major efforts around the world are seeking to address the problem of single-use plastics and the ecological damage they cause[13]. It is estimated that 4.8-12.7 million tons of plastic can enter marine ecosystems every year[14]. However, to date, few studies have been reported on how Brazil nut urchin particles can improve the performance of PBAT biopolymer through extrusion and injection processing. Therefore, this work analyzed the effects on the mechanical and thermal properties of PBAT biopolymer after the addition of Brazil nut urchin waste particles in the proportion of 10 wt% and 20 wt% through the extrusion and injection process as a sustainable and ecological alternative.
2.1 Materials
After the Brazil nut seeds were removed, the Brazil nut urchins were harvested at the Aruanã farm, linked to the company ECONUT - a pioneering company in Brazil nut plantations, in Itacoatiara, a municipality located 270 km from the capital Manaus, in the state of Amazonas, Brazil. The urchins were stored in a rain-protected warehouse for about a week after they were harvested, ensuring that they didn’t get damp.
The polymer matrix in the form of pellets and of the PBAT type with a maximum thickness of 0.061 mm was purchased from the company Tiken LTDA. The main characteristics of PBAT are: density of 1.21 g/cm3; melting point of 116 ~ 122°C; vicat A/50 ≥ 80°C; tensile strength ≥ 25 MPa; Elongation ≥ 400%; and moisture ≤ 0.06%.
2.2 Methods
The Brazil nut urchin was broken by hammering, resulting in smaller, irregular pieces. After breaking, they were washed with running water to remove impurities from the forest. Finally, the pieces were dried in a QUIMIS model Q317M-72 oven at a temperature of 70 ± 2°C for 12 hours. The urchins were then ground in a MARCONI knife mill and classified by sieve size in a PROSUTEST vibrator for approximately 25 minutes. The particles that passed through the 40 mesh sieve, equivalent to an opening of 0.35 mm, were selected and dried together with the PBAT pellets in a QUIMIS oven at a temperature of 70 ± 2°C for 12 hours. After drying, the urchin particles and PBAT were aggregated in a plastic bag by manual stirring in proportions of 10 wt% and 20 wt% of the urchin.
The selection of 10% and 20% wt ratios was based on commonly used ranges for natural fiber biocomposites (5–30% wt), allowing evaluation of mechanical, thermal, and morphological effects without compromising extrusion or causing excessive agglomeration. These intermediate ratios are thus suitable for exploratory and comparative studies.
With the mixture aggregated, the extrusion process was carried out using a hopper fed by a single-screw extruder with a useful screw length / external screw diameter = 40, model ZGH 28950. The temperature used was 138°C to 149°C between the 4 stages of operation. The extruded
biocomposites were then cooled in a water bath, pelletized in a BGM grinder, model BGM.2, series 0002.25, and dried in an oven at a temperature of 70 ± 2°C for 12 hours to remove the moisture and make the plastic injection samples.
Plastic injection of the test specimens was carried out in a HAITIAN injection molding, model HTF60W-II, with a feed temperature of 189 ± 2°C and a homogenization temperature of 215 ± 5°C. The standard used was ASTM D412 for the tensile, impact and hardness tests.
In order to perform a brittle fracture on the biocomposites after the injection process, a sample of each material was immersed in a Styrofoam container with liquid nitrogen for 10 seconds, then removed and gently fractured with tweezers so that there was as little effort as possible. This technique was used to evaluate the interaction between PBAT and the nut urchin using scanning electron microscopy (SEM). The equipment used for SEM was a Carl Zeiss model EVO-LS15. The samples were fixed to stubs with carbon tape, used in high vacuum mode at an accelerating voltage of 5 kV and coated twice with gold. The behavior of the biocomposites after extrusion was also analyzed in SEM.
To determine the thermal stability and degradation temperatures of the constituents, the TGA and DTG techniques were used a Jupiter STA 449 F3 thermal analyzer (NETZSCH) on 30 mg of the samples using a 150 µL open α-alumina crucible. The temperature conditions ranged from 30 to 700°C with a heating rate of 10°C.min-1, in a dynamic dry air flow atmosphere with a flow rate of 50 mL min-1 The MiniFlex 6th generation RIGAKU X-ray diffractometer (XRD) was used to analyze the crystal structure of the materials with a Cu Kα radiation source (λ= 1.5418 Å), 40 kV, 15 mA, continuous flow, divergence slit: 1/4°, scan mode: 2θ, Range: 10° to 90°, step size: 0.04° time per step: 3.00 s and ω: 1.5°. FTIR analysis, used to effectively study the molecular interactions that occur during reactive extrusion, was carried out on a BRUKER spectrophotometer with the attenuated total reflection (ATR). The absorption spectra were obtained from 32 scans per sample with a resolution of 4 cm-1. The frequency performed was between 400 and 4000 cm-1.
The mechanical properties of all the samples were determined by tensile, impact and shore D hardness tests, with 5 samples (CP’s) in each test. The tensile test was carried out on an EMC universal testing machine with a 30 kN load cell and a test speed of 5 mm/min. The tensile test followed the ASTM D638 standard, type III with specimen length of 165 mm, reduced section of 57 mm, gauge width of 13 mm, overall width of 19 mm and thickness of 3 mm. The impact resistance test was carried out in accordance with ASTM D256 on a TINIUS OLSEN model 892, with the thickness and width of the samples being approximately 3 and 14 mm, respectively. The Shore D hardness test was carried out on a portable digital INSTRUTHERM device, model DP-400.
3.1 Thermogravimetry (TG / DTG)
Figure 1 shows the analysis of the TG tests and their DTG derivative for all the samples. Although the Brazil
nut urchin sample was dried, there is an obvious loss of mass up to 100°C, due to the elimination of water and the urchin’s hydrophilic characteristics, and for PBAT and the biocomposites this does not occur to such an extent. For the urchin there is an exothermic loss of mass between 210 and 345°C (from 90 to 40%) which can be attributed to the decomposition of hemicellulose and cellulose, with maximum degradation temperatures at 285 and 325°C, respectively. Lignin degradation occurs between 350 and 540°C[15] Table 1 lists the results of the TG analysis in detail for the biomasses found in the Brazil nut urchin.
The thermal degradation (TG) results show that PBAT and the 10 wt% biocomposite remain stable up to 275°C, while the 20 wt% biocomposite degrades from 250°C. The degradation of PBAT and biocomposites began at approximately 300°C and ended at 520°C, with the peak degradation occurring near 400°C. The first degradation stage (340–400°C) is likely due to the decomposition of aliphatic copolyester components (adipic acid and 1,4-butanediol), while the second stage (~600°C) corresponds to the decomposition of the aromatic terephthalic copolyester[16]. This increase in thermal resistance can be attributed to the hydrophobic characteristics of the PBAT present in the composite.
The DTG analysis shows three degradation stages. The urchin partially degrades with peaks at 280°C and 320°C, while the main degradation peaks occur at 395°C for PBAT, 405°C for the 10 wt% biocomposite, and 400°C for the 20 wt% biocomposite. At 535°C there is ash residue for the biocomposites and PBAT, and in the urchin this temperature increased to 555°C, due to the presence of lignin[17]. The PBAT visibly inhibited the degradation of the hemicellulose and cellulose of the urchin between 210 and 345°C.
The natural fibers of the Brazil nut urchin consist mainly of cellulose (both amorphous and crystalline), along with hemicellulose and lignin (amorphous)[2,18]. Since PBAT is semi-crystalline[3], adding urchin fibers is expected to modify the composite’s crystallinity. Table 2[19] compares PBAT’s crystallographic planes with research results, showing similarities.
XRD shows that the crystallinity of PBAT was not compromised by the addition of urchin particles (Figure 2). The 10 wt% biocomposite had the highest peak intensity (5254 a.u. at 22.88°), followed by the 20 wt% biocomposite (3428 a.u. at 23.12°) and the urchin (3207 a.u. at 22.32°).

Source: [19]adapted by the author.


Lower lignin contents acted as nucleating agents, increasing crystallinity, but high contents restricted the organization of the PBAT polymer chains, resulting in a reduction in total crystallinity[17]. The peak height was not directly proportional to the addition of urchin.
FTIR analysis helps study molecular interactions during reactive extrusion[20] and identifies fiber functional groups[21]. Key absorption peaks are expected at 2900–3600 cm-1 for cellulose (-OH/CH), 1700–1770 cm-1 for hemicellulose (C=O), and 1200–1600 cm -1 for lignin (methoxy-O-CH3/C-O-C/C=C)[22]
Figure 3 shows a weak absorbance peak at 3511 cm−1 in biocomposites, attributed to OH stretching[23]. The peak at 3442 cm-1, characteristic of PBAT, corresponds to a
weak OH stretching band associated with the vibrations of the hydroxyl linked to the hydrogen (-OH) in the starch chains[24], also appears in biocomposites but with lower intensity. Spectral changes indicate interactions between PBAT and urchin particles. FTIR spectra show peaks at 2925-2952 cm-1 from CH2 aliphatic C-H stretching[16]. The FTIR spectra also show the presence of lignin in the PBAT matrix due to the appearance of the CH stretching vibration peak. A sharp peak, between 1710 and 1720 cm-1, represents the carbonyl groups of carboxylic, p-coumaric, ferulic and uronic acid, which are the main constituents of extractives and hemicellulose[25], and another peak at 1708 cm-1 attributed to the ester carbonyl stretch (C=O) of the ester group, which was originally present in the PBAT structure[16,26] A reduction in the C=O peak signals polymer degradation[16] Biocomposites show C=C phenylene stretching peaks at 1456 and 1508 cm-1, while PBAT has them at 1409 and 1454 cm-1[18]
Polímeros, 35(4), e20250048,
The peaks between 1236 and 1267 cm-1 are attributed to C-H deformation (asymmetric), representing the crystalline nature and vibration of CH2 in cellulose[27], and for PBAT it is attributed to C-O stretching of the ester bonds[16]. The peaks at 1037-1162 cm-1 correspond to C-O-C stretching in cellulose glycosidic bonds[28-30]. The sharp peak at 727 cm-1 is linked to -CH2- vibrations in the PBAT structure[16]
Table 3 shows that peak frequencies remain similar despite adding urchin to the bioplastic. If a compatibilizer had been used, a greater intensity of these peaks would have been evident[20]. According to the harmonic oscillator model, peak frequency decreases with stronger molecular interactions, where hydrogen bonds play a key role[31].
As the Brazil nut urchin content increased, the surfaces of the biocomposites became rougher (Figure 4). The biocomposite with 10 wt% by weight of urchin showed better structural integrity and a smoother, denser appearance (Figure 4b), while the 20 wt% biocomposite was more
irregular, with ripples, depressions, and pores (Figure 4d). These findings align with Pan et al.[19] who observed increased surface irregularity with higher fiber content. These results highlight the importance of mechanical and barrier properties in nanocomposite films[20], indicating weak interfacial adhesion with the matrix, corroborating the FTIR results. The urchin was homogeneously dispersed in the polymer matrix and present across the biocomposite surface, though some pores were observed (Figure 4d). This differences in dispersion were likely due to extrusion processing, which is more effective than gravity and press processing, but still resulted in irregular fractures and visible cracks (Figure 4).
Figure 5 highlights poor compatibility between the polymer matrix and the urchin surface. This may be due to the different surface energies, which prevent the formation of a stable and well-adhered interface, causing defects and porosity. This lack of interfacial adhesion can negatively impact the composite’s mechanical properties[32]. Chemical treatment removes surface impurities from the fiber, enhancing mechanical interlocking with the matrix and improving the composite’s mechanical properties[33] Figure 5 also shows
Sample
PBAT 3500 2952 1708 1454 / 1409
Urchin 3442 2925 1720 - 1236 1037 -
Bio 10 wt% 3442 2925 1716 1456 / 1508 1245 1161 727
Bio 20 wt% 3442 2925 1710 1456 / 1508 1245 1162 727


poor distribution and orientation of urchin fibers in the polymer matrix, likely due to the extrusion process, though better than gravity and pressing methods, however the surface showed irregular and visible fractures or cracks, which indicates the typical fragility of lignocellulosic materials[20] The inadequate distribution, fiber agglomeration and gaps suggest processing issues related to temperature, pressure, and cooling rate. Reprocessing the biocomposite through extrusion could help mitigate these problems.
3.5 Mechanical tests
3.5.1 Tensile test
The addition of urchin reduced the tensile stress (σ) of PBAT from 9.36 MPa to 7.08 MPa (10 wt% urchin) and 6.7 MPa (20 wt% urchin). This aligns with previous studies showing reduced PBAT tensile strength when reinforced with materials like starch[20], cellulose nanocrystals[34], cellulose acetate[35], ground coffee[36], organomontmorillonite[37] and wheat straw[38]. The 10 wt% biocomposite had stress comparable to low-density polyethylene (LDPE, 6.9-16 MPa) but significantly lower than polyesteramide (PEA, 17 MPa), polypropylene (PP, 35 MPa), and linear LDPE, which are commonly used in packaging and agriculture[39]
Figure 6b shows that adding urchin significantly reduced elongation: from 24.23% in pure PBAT to 10.85% with 10 wt% urchin, and 5.89% with 20 wt%, indicating a decrease in the material’s plastic deformation under tension. Figure 6c shows that the elastic modulus (Young’s modulus) increased with urchin content - from 131 MPa in pure PBAT to 210 MPa (10 wt%) and 316 MPa (20 wt%). This rise is
likely due to phase transition[20] good lignin dispersion, and strong PBAT-lignin interactions[40]. In addition, there are also hydrogen bonds and π-π interactions[41], as lignin has a rigid aromatic structure and a high Young’s modulus[42]
3.5.2 Izod impact test
The highest impact resistance was observed in pure PBAT (206.44 J/m), while the addition of 10 wt% and 20 wt% urchin reduced it to 47.37 J/m and 32.67 J/m, respectively - an 88.38% decrease (Figure 7). This indicates that urchin makes the biocomposite more fragile, consistent with tensile test results showing increased stiffness and reduced plastic deformation.
Composite materials are highly sensitive to impact, which can cause severe internal damage like delamination and cracking[43]. Composites with a polypropylene (PP) matrix and long natural fibers show the highest impact resistance, likely due to better interfacial stress transfer. It was also found that the treatment of the fibers with a coupling agent (maleic anhydride) reduces the loss of impact resistance[44].
Literature reports a Charpy impact energy of 115 kJ/m2 for flax fiber PP composites manufactured by the pultrusion process[45], and for a compression molded an Izod impact of 751 J/m for needle-punched flax blankets[46], a value 14x higher than that found in the biocomposite with 10 wt% of nut urchin. For bioplastics, PLA reinforced with 30 wt% Cordenka fiber achieved the highest biodegradable composite impact strength at 72 kJ/m2[47]. Additionally, PLA composites with 30 wt% abaca and synthetic cellulose fibers showed significant improvements in Charpy impact strength and tensile strength (5.7 to 7.9 kJ/m2)[48]
Characterization of PBAT bioplastic with Brazil nut urchin particles

The surface hardness (Shore D) of PBAT biocomposites increased with the addition of Brazil nut urchin particles, possibly due to the greater stiffness and hardness of the fibers compared to the PBAT matrix. At the proportion of 20 wt% the biocomposite showed over 30% higher average surface hardness, with an increase of more than 40% from 28.3 (PBAT) to 39.7 Shore D ( Figure 8). Another aspect analyzed in the interquartile range was that a higher amount of urchin particles allowed for more efficient load distribution, resulting in a surface more resistant to penetration and, consequently, increased surface hardness (Figure 8).
Despite some compatibility limitations observed under microscopy, the fiber presence still enhanced hardness. With 10 wt% urchin, the hardness was lower compared to 20 wt%, but it still led to a higher hardness than pure PBAT, resulting in an intermediate value of 35 Shore D. The lower fiber content also added strength to PBAT, which showed a lower surface hardness (29 Shore D) due to its natural

flexibility and reduced stiffness compared to reinforced materials (Figure 8).

nut urchin.
4.
After processing, all biocomposite samples showed good surface homogeneity and were classified as particulate polymer biocomposites. While biocomposites begin degrading around 300°C, urchin particles degrade from 210°C, slightly lowering the ash degradation onset for PBAT with 20 wt% urchin to 493°C. XRD analysis showed no significant change in crystallinity after extrusion. However, SEM revealed poor interfacial adhesion between PBAT and natural fibers, weakening the composite’s mechanical properties. The mechanical properties results suggest that the urchin acted as a filler rather than a reinforcement, due to the decrease in PBAT’s tensile strength, toughness and ductility, making them more brittle than pure PBAT, mainly due to weak particle-matrix bonding and morphological pores. On the other hand, higher fiber content improved surface hardness due to the rigidity of the urchin fibers, making the material more suitable for high-hardness applications. Because natural fiber composites are lighter than those with synthetic fibers, they offer energy savings in sectors like automotive. Thus, PBAT/urchin composites show advantages for industrial applications, helping reduce plastic use, environmental impact, and supporting the circular economy.
● Conceptualization – Bruno Mello de Freitas; Paulo Noronha Lisboa Filho.
● Data curation – Bruno Mello de Freitas.
● Formal analysis – Bruno Mello de Freitas.
● Funding acquisition - Carlos do Amaral Razzino; Paulo Noronha Lisboa Filho.
● Investigation – Bruno Mello de Freitas.
● Methodology – Bruno Mello de Freitas; Paulo Noronha Lisboa Filho.
● Project administration – Bruno Mello de Freitas; Paulo Noronha Lisboa Filho.
● Resources – Paulo Noronha Lisboa Filho.
● Software – NA.
● Supervision – Bruno Mello de Freitas; Paulo Noronha Lisboa Filho.
● Validation – Bruno Mello de Freitas; Carlos do Amaral Razzino; Paulo Noronha Lisboa Filho.
● Visualization – Bruno Mello de Freitas.
● Writing – original draft – Bruno Mello de Freitas.
● Writing – review & editing – Carlos do Amaral Razzino; Paulo Noronha Lisboa Filho.
The authors acknowledge the Fundação de Amparo à Pesquisa do Estado do Amazonas-FAPEAM, Universidade Estadual Paulista “Júlio de Mesquita Filho”-UNESP, Universidade do Estado do Amazonas-UEA, Laboratório de Materiais-LabMat and Grupo de Física Aplicada à Medicina e Nanotecnologia-GFAMN, Avanplas Polímeros da Amazônia, ECONUT, Brasil.
1 Nandy, S., Fortunato, E., & Martins, R. (2022). Green economy and waste management: an inevitable plan for materials science. Progress in Natural Science, 32(1), 1-9 https://doi. org/10.1016/j.pnsc.2022.01.001.
2 Chen, J., Long, Z., Wang, S., Meng, Y., Zhang, G., & Nie, S. (2019). Biodegradable blends of graphene quantum dots and thermoplastic starch with solid-state photoluminescent and conductive properties. International Journal of Biological Macromolecules, 139, 367-376 https://doi.org/10.1016/j. ijbiomac.2019.07.211. PMid:31377295.
3 Wu, Z., Huang, Y., Xiao, L., Lin, D., Yang, Y., Wang, H., Yang, Y., Wu, D., Chen, H., Zhang, Q., Qin, W., & Pu, S. (2019). Physical properties and structural characterization of starch/ polyvinyl alcohol/graphene oxide composite films. International Journal of Biological Macromolecules, 123, 569-575 https:// doi.org/10.1016/j.ijbiomac.2018.11.071 PMid:30439436.
4 Tian, H., Wang, K., Liu, D., Yan, J., Xiang, A., & Rajulu, A. V. (2017). Enhanced mechanical and thermal properties of poly (vinyl alcohol)/corn starch blends by nanoclay intercalation. International Journal of Biological Macromolecules , 101, 314-320 https://doi.org/10.1016/j.ijbiomac.2017.03.111 PMid:28341175.
5 Wang, S., Ren, J., Li, W., Sun, R., & Liu, S. (2014). Properties of polyvinyl alcohol/xylan composite films with citric acid. Carbohydrate Polymers, 103, 94-99 https://doi.org/10.1016/j. carbpol.2013.12.030. PMid:24528705.
6 Ferreira, F. V., Pinheiro, I. F., Gouveia, R. F., Thim, G. P., & Lona, L. M. F. (2018). Functionalized cellulose nanocrystals as reinforcement in biodegradable polymer nanocomposites. Polymer Composites, 39(S1), E9-E29 https://doi.org/10.1002/ pc.24583
7. Rosenboom , J.-G. , Langer, R. , & Traverso , G. (2022 ). Bioplastics for a circular economy. Nature Reviews. Materials, 7(2), 117-137 https://doi.org/10.1038/s41578-021-00407-8 PMid:35075395.
8 Karan, H., Funk, C., Grabert, M., Oey, M., & Hankamer, B. (2019). Green bioplastics as part of a circular bioeconomy. Trends in Plant Science, 24(3), 237-249. https://doi.org/10.1016/j. tplants.2018.11.010 PMid:30612789.
9 Kanwal, A., Zhang, M., Sharaf, F., & Li, C. (2022). Polymer pollution and its solutions with special emphasis on Poly (butylene adipate terephthalate (PBAT)). Polymer Bulletin, 79(11), 9303-9330 https://doi.org/10.1007/s00289-021-04065-2
10 Elvers, D., Song, C. H., Steinbüchel, A., & Leker, J. (2016). Technology trends in biodegradable polymers: evidence from patent analysis. Polymer Reviews (Philadelphia, Pa.), 56(4), 584-606 https://doi.org/10.1080/15583724.2015.1125918
11 De Hoe, G. X., Zumstein, M. T., Getzinger, G. J., Rüegsegger, I., Kohler, H.-P. E., Maurer-Jones, M. A., Sander, M., Hillmyer, M. A., & McNeill, K. (2019). Photochemical transformation of poly (butylene adipate-co-terephthalate) and its effects on enzymatic hydrolyzability. Environmental Science & Technology, 53(5), 2472-2481 https://doi.org/10.1021/acs.est.8b06458 PMid:30726677.
12 Das, O., Babu, K., Shanmugam, V., Sykam, K., Tebyetekerwa, M., Neisiany, R. E., Försth, M., Sas, G., Gonzalez-Libreros, J., Capezza, A. J., Hedenqvist, M. S., Berto, F., & Ramakrishna, S. (2022). Natural and industrial wastes for sustainable and renewable polymer composites. Renewable & Sustainable Energy Reviews, 158, 112054 https://doi.org/10.1016/j. rser.2021.112054
13. Miller, S. A. (2020). Five misperceptions surrounding the environmental impacts of single-use plastic. Environmental Science & Technology, 54(22), 14143-14151 https://doi. org/10.1021/acs.est.0c05295 PMid:33103887.
14. Jambeck, J. R., Geyer, R., Wilcox, C., Siegler, T. R., Perryman, M., Andrady, A., Narayan, R., & Law, K. L. (2015). Plastic waste inputs from land into the ocean. Science, 347(6223), 768-771 https://doi.org/10.1126/science.1260352 PMid:25678662.
15. Apaydın Varol, E., & Mutlu, Ü. (2023). TGA-FTIR analysis of biomass samples based on the thermal decomposition behavior of hemicellulose, cellulose, and lignin. Energies, 16(9), 3674 https://doi.org/10.3390/en16093674
16. Zehetmeyer, G., Meira, S. M. M., Scheibel, J. M., Oliveira, R. V. B., Brandelli, A., & Soares, R. M. D. (2016). Influence of melt processing on biodegradable nisin‐PBAT films intended for active food packaging applications. Journal of Applied Polymer Science, 133(13), 43212 https://doi.org/10.1002/app.43212
17 Kargarzadeh, H., Galeski, A., & Pawlak, A. (2020). PBAT green composites: effects of kraft lignin particles on the morphological, thermal, crystalline, macro and micromechanical properties. Polymer, 203, 122748 https://doi.org/10.1016/j. polymer.2020.122748
18 Tavares, L. B., Ito, N. M., Salvadori, M. C., Santos, D. J., & Rosa, D. S. (2018). PBAT/kraft lignin blend in flexible laminated food packaging: peeling resistance and thermal degradability. Polymer Testing, 67, 169-176 https://doi. org/10.1016/j.polymertesting.2018.03.004
19 Pan, H., Ju, D., Zhao, Y., Wang, Z., Yang, H., Zhang, H., & Dong, L. (2016). Mechanical properties, hydrophobic properties and thermal stability of the biodegradable poly (butylene adipate-co-terephthalate)/maleated thermoplastic starch blown films. Fibers and Polymers, 17(10), 1540-1549 https://doi.org/10.1007/s12221-016-6379-x
20 Zhai, X., Wang, W., Zhang, H., Dai, Y., Dong, H., & Hou, H. (2020). Effects of high starch content on the physicochemical properties of starch/PBAT nanocomposite films prepared by extrusion blowing. Carbohydrate Polymers, 239, 116231 https:// doi.org/10.1016/j.carbpol.2020.116231. PMid:32414453.
21 Caban, R. (2022). FTIR-ATR spectroscopic, thermal and microstructural studies on polypropylene-glass fiber composites. Journal of Molecular Structure, 1264, 133181 https://doi. org/10.1016/j.molstruc.2022.133181
22 Kamarudin, S. H., Rayung, M., Abu, F., Ahmad, S., Fadil, F., Abdul Karim, A., Norizan, M. N., Sarifuddin, N., Mat Desa, M. S. Z., Mohd Basri, M. S., Samsudin, H., & Abdullah, L. C. (2022). A review on antimicrobial packaging from biodegradable polymer composites. Polymers, 14(1), 174 https://doi.org/10.3390/polym14010174 PMid:35012197.
23 Katakojwala, R., & Mohan, S. V. (2020). Microcrystalline cellulose production from sugarcane bagasse: sustainable process development and life cycle assessment. Journal of Cleaner Production, 249, 119342 https://doi.org/10.1016/j. jclepro.2019.119342
24. Zuo, Y., Gu, J., Yang, L., Qiao, Z., Tan, H., & Zhang, Y. (2013). Synthesis and characterization of maleic anhydride esterified corn starch by the dry method. International Journal of Biological Macromolecules, 62, 241-247 https:// doi.org/10.1016/j.ijbiomac.2013.08.032. PMid:23999015.
25 Sain, M., & Panthapulakkal, S. (2006). Bioprocess preparation of wheat straw fibers and their characterization. Industrial Crops and Products, 23(1), 1-8 https://doi.org/10.1016/j. indcrop.2005.01.006
26 Wei, D., Wang, H., Xiao, H., Zheng, A., & Yang, Y. (2015). Morphology and mechanical properties of poly (butylene adipate-co-terephthalate)/potato starch blends in the presence of synthesized reactive compatibilizer or modified poly (butylene adipate-co-terephthalate). Carbohydrate Polymers, 123, 275-282 https://doi.org/10.1016/j.carbpol.2015.01.058 PMid:25843859.
27 Huang, M.-F., Yu, J.-G., & Ma, X.-F. (2004). Studies on the properties of montmorillonite-reinforced thermoplastic starch composites. Polymer, 45(20), 7017-7023 https://doi. org/10.1016/j.polymer.2004.07.068
28 Sun, X. F., Xu, F. Q., Sun, R. C., Geng, Z. C., Fowler, P., & Baird, M. S. (2005). Characteristics of degraded hemicellulosic polymers obtained from steam exploded wheat straw. Carbohydrate Polymers, 60(1), 15-26. https://doi.org/10.1016/j.carbpol.2004.11.012.
29 Garcia, P. S., Grossmann, M. V. E., Shirai, M. A., Lazaretti, M. M., Yamashita, F., Muller, C. M. O., & Mali, S. (2014). Improving action of citric acid as compatibiliser in starch/ polyester blown films. Industrial Crops and Products, 52, 305-312 https://doi.org/10.1016/j.indcrop.2013.11.001
30 Pawlak, A., & Mucha, M. (2003). Thermogravimetric and FTIR studies of chitosan blends. Thermochimica Acta, 396(1-2), 153-166 https://doi.org/10.1016/S0040-6031(02)00523-3
31 Wang, F., Sun, X., Zan, J., Li, M., Liu, Y., & Chen, J. (2022). Terahertz spectra and weak intermolecular interactions of nucleosides or nucleoside drugs. Spectrochimica Acta. Part A, Molecular and Biomolecular Spectroscopy, 265, 120344 https://doi.org/10.1016/j.saa.2021.120344 PMid:34481145.
32. Wang, H., Liu, X., Liu, J., Wu, M., & Huang, Y. (2022). Tailoring interfacial adhesion between PBAT matrix and PTFE-modified microcrystalline cellulose additive for advanced composites. Polymers, 14(10), 1973 https://doi.org/10.3390/ polym14101973. PMid:35631855.
33 Verma, D., & Goh, K. L. (2021). Effect of mercerization/alkali surface treatment of natural fibres and their utilization in polymer composites: mechanical and morphological studies. Journal of Composites Science, 5(7), 175 https://doi.org/10.3390/jcs5070175
34 Pinheiro, I. F., Ferreira, F. V., Souza, D. H. S., Gouveia, R. F., Lona, L. M. F., Morales, A. R., & Mei, L. H. I. (2017). Mechanical, rheological and degradation properties of PBAT nanocomposites reinforced by functionalized cellulose nanocrystals. European Polymer Journal, 97, 356-365 https:// doi.org/10.1016/j.eurpolymj.2017.10.026
35 Wu, C.-S. (2012). Characterization of cellulose acetate-reinforced aliphatic–aromatic copolyester composites. Carbohydrate Polymers , 87 (2 ), 1249 -1256 https://doi.org/10.1016/j. carbpol.2011.09.009 PMid:23399153.
36 Moustafa, H., Guizani, C., Dupont, C., Martin, V., Jeguirim, M., & Dufresne, A. (2017). Utilization of torrefied coffee grounds as reinforcing agent to produce high-quality biodegradable PBAT composites for food packaging applications. ACS Sustainable Chemistry & Engineering, 5(2), 1906-1916 https:// doi.org/10.1021/acssuschemeng.6b02633
Freitas, B. M., Razzino, C. A., & Lisboa Filho, P. N.
37 Li, J., Lai, L., Wu, L., Severtson, S. J., & Wang, W.-J. (2018). Enhancement of water vapor barrier properties of biodegradable poly (butylene adipate-co-terephthalate) films with highly oriented organomontmorillonite. ACS Sustainable Chemistry & Engineering, 6(5), 6654-6662. https://doi.org/10.1021/acssuschemeng.8b00430.
38 Le Digabel, F., & Avérous, L. (2006). Effects of lignin content on the properties of lignocellulose-based biocomposites. Carbohydrate Polymers, 66(4), 537-545 https://doi.org/10.1016/j. carbpol.2006.04.023
39. Guimarães, M., Jr., Botaro, V. R., Novack, K. M., Teixeira, F. G., & Tonoli, G. H. D. (2015). High moisture strength of cassava starch/polyvinyl alcohol-compatible blends for the packaging and agricultural sectors. Journal of Polymer Research, 22(10), 192 https://doi.org/10.1007/s10965-015-0834-z
40 Sugano-Segura, A. T. R., Tavares, L. B., Rizzi, J. G. F., Rosa, D. S., Salvadori, M. C., & Santos, D. J. (2017). Mechanical and thermal properties of electron beam-irradiated polypropylene reinforced with Kraft lignin. Radiation Physics and Chemistry, 139, 5-10 https://doi.org/10.1016/j.radphyschem.2017.05.016
41 Morelli, C. L., Belgacem, M. N., Branciforti, M. C., Bretas, R. E. S., Crisci, A., & Bras, J. (2016). Supramolecular aromatic interactions to enhance biodegradable film properties through incorporation of functionalized cellulose nanocrystals. Composites. Part A, Applied Science and Manufacturing, 83, 80-88 https://doi.org/10.1016/j.compositesa.2015.10.038
42. Elder, T. (2007). Quantum Chemical Determination of Young’s Modulus of Lignin. Calculations on a β− O-4 ‘Model Compound. Biomacromolecules, 8(11), 3619-3627 https://doi.org/10.1021/ bm700663y. PMid:17927244.
43 Shah, S. Z. H., Karuppanan, S., Megat-Yusoff, P. S. M., & Sajid, Z. (2019). Impact resistance and damage tolerance of fiber
reinforced composites: A review. Composite Structures, 217, 100-121 https://doi.org/10.1016/j.compstruct.2019.03.021
44 Pickering, K. L., Efendy, M. A., & Le, T. M. (2016). A review of recent developments in natural fibre composites and their mechanical performance. Composites. Part A, Applied Science and Manufacturing, 83, 98-112. https://doi.org/10.1016/j. compositesa.2015.08.038.
45 Angelov, I., Wiedmer, S., Evstatiev, M., Friedrich, K., & Mennig, G. (2007). Pultrusion of a flax/polypropylene yarn. Composites. Part A, Applied Science and Manufacturing, 38(5), 1431-1438 https://doi.org/10.1016/j.compositesa.2006.01.024
46 Oksman, K. (2000). Mechanical properties of natural fibre mat reinforced thermoplastic. Applied Composite Materials, 7(5), 403-414 https://doi.org/10.1023/A:1026546426764
47 Bax, B., & Müssig, J. (2008). Impact and tensile properties of PLA/Cordenka and PLA/flax composites. Composites Science and Technology, 68(7-8), 1601-1607. https://doi.org/10.1016/j. compscitech.2008.01.004.
48. Bledzki, A. K., Jaszkiewicz, A., & Scherzer, D. (2009). Mechanical properties of PLA composites with man-made cellulose and abaca fibres. Composites. Part A, Applied Science and Manufacturing, 40(4), 404-412 https://doi.org/10.1016/j. compositesa.2009.01.002
Received: May 10, 2025
Revised: Aug. 13, 2025
Accepted: Sep. 24, 2025
Associate Editor: José A. C. G. Covas

São Paulo 994 St. São Carlos, SP, Brazil, 13560-340
Phone: +55 16 3374-3949
Email: abpol@abpol.org.br
2021